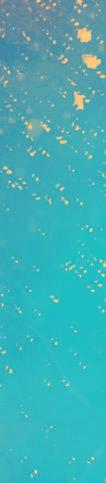
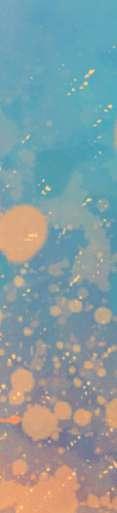

Dados Internacionais de Catalogação na Publicação (CIP) de acordo com ISBD
N897
Nossos bairros, nossa Fortaleza: mapeamento estatístico e afetivo da cidade / organizado por Amanda Araújo, Paula Lima ; ilustrado por Carlus Campos. - Fortaleza, CE : Fundação Demócrito Rocha, 2022.
400 p. : il. ; 20,5cm x 27,5cm.
Inclui índice.
ISBN: 978-65-5383-040-0
2022-3675
Elaborado por Odilio Hilario Moreira Junior - CRB-8/9949
Índice para catálogo sistemático:
História: Fortaleza 981.31
História: Fortaleza 94(813.1)
CDD 981.31
CDU 94(813.1)
1. História – Fortaleza. 2. Bairros. 3. Histórias. 4. Mapeamento. 5. Cidade. I. Araújo, Amanda. II. Lima, Paula. III. Campos, Carlus. IV. Título.








REALIZAÇÃO PARCERIA
Copyright © 2022 by Fundação Demócrito Rocha
FUNDAÇÃO DEMÓCRITO ROCHA (FDR)
Luciana Dummar
Presidente
André Avelino de Azevedo
Diretor Administrativo-Financeiro
Marcos Tardin
Gerente Geral
Raymundo Netto
Gerente Editorial e de Projetos
Deglaucy Jorge
Gerente Educacional
Chico Marinho
Gerente de Audiovisual
Andrea Araujo
Gerente de Marketing & Design
Aurelino Freitas e Fabrícia Góis
Analistas de Projetos
Narcez Bessa
Analista de Contas
NOSSOS BAIRROS, NOSSA FORTALEZA: MAPEAMENTO ESTATÍSTICO E AFETIVO DA CIDADE DE FORTALEZA
Concepção e Coordenadora Geral: Valéria Xavier
Coordenadora de Conteúdo: Paula Lima
Editoras: Amanda Araújo e Paula Lima
Editora de Design e Projeto Gráfico: Andrea Araujo
Designers: Mariana Araujo e Miqueias Mesquita
Ilustrador: Carlus Campos
Textos: Ana Beatriz Caldas, Carol Kossling, Cristina Brito, Lennon Costa, Paula Lima e Samuel Pimentel
Editor de Fotografia: Francisco Fontenele
Fotos: Aurélio Alves, Francisco Fontenele, Fernanda Barros, Júlio Caesar e Thaís Mesquita
Analista de Projetos: Beth Lopes
Estratégia e Relacionamento: Adryana Joca e Dayvison Alvares
Arquivo: OPOVOdoc
Esta publicação é parte integrante do projeto Nossos Bairros, Nossa Fortaleza: Mapeamento Estatístico e Afetivo da Cidade de Fortaleza. Realização da Fundação Demócrito Rocha e Parceria com a Câmara Municipal de Fortaleza (CMF), por meio do Termo de Fomento nº 02/2022 – Etapa II.
“Cada região da terra tem uma alma sua, raio criador que lhe imprime o cunho da originalidade”
José de Alencar


FORTALEZA DESENHADA
O livro Nossos bairros, Nossa Fortaleza é um mapeamento dos 121 bairros divididos nas 12 regionais da Capital. A partir de dados oficiais desenhamos o perfil de cada uma das localidades e apontamos o que as faz um território humano, através das histórias do surgimento das comunidades e de seus equipamentos ou atividades sociais.
Nas 400 páginas, além de elencar dados demográficos, IDH, acesso a cultura, saúde, educação e transporte público, entre outros, propomos olhar a cidade como uma experiência subjetiva, reconhecendo memórias, imaginários e afetos que são diversas vezes muito particulares de cada local.


Para cada bairro, um registro fotográfico inédito. Um retrato que revela a poética do verde, o encanto da praça ou a imensidão das paisagens. Na abertura de cada Regional, destacamos os serviços executivos daquela região, para que a população encontre acesso fácil às secretarias executivas, e, então, as páginas seguem o passeio pelos bairros.
Também lançamos um olhar geral para a cidade de Fortaleza. As angulações que a soma dos 121 bairros revelam estão reunidas no capítulo inicial do livro.
Uma cidade existe na arte de inventar o cotidiano, desenhando redes de conexão nas expressões de identidades pessoais e coletivas, por isso, percorremos o que é Patrimônio Imaterial de Fortaleza e dedicamos um capítulo às expressões tradicionais e culturais registradas pela Secretaria de Cultura de Fortaleza.
Ainda apresentamos os vereadores em exercício em 2022 da Câmara Municipal de Fortaleza, que assina este projeto em parceria com a Fundação Demócrito Rocha.
Sejam bem-vindos e bem-vindas a essa Fortaleza plural e encantadora em cada cantinho das regionais.
Paula Lima jornalista




É SEMPRE UM PRAZER, FORTALEZA
Conhecer Fortaleza, para além de seus cartões postais, demanda bem mais do que uma experiência cotidiana. Em constante mudança, nossa cidade é plural, democrática e revolucionária. Nos adaptamos conforme as necessidades. E parte do nosso encanto reside em sermos tão mutáveis, acolhedores, trabalhadores e resilientes.

Enquanto parlamentares, para que possamos acompanhar essas transições, potencializando vocações econômicas, compreendendo e suprindo as necessidades de nossa população, é preciso que conheçamos de perto a realidade de cada um dos 121 bairros da cidade, cuja distribuição, em 2021, passou de 7 para 12 secretarias regionais. Alteração administrativa que tem o viés da proximidade, permitindo um diagnóstico preciso da transformação de rotinas, comportamentos e relações interpessoais, bem como a forma como essas pessoas interagem com os espaços públicos, sobretudo em razão da pandemia. Vale ressaltar que o último Censo Demográfico no Brasil foi realizado há 12 anos.


Precisamos, portanto, compensar essa defasagem com informações atualizadas e qualificadas que orientem políticas públicas eficientes. Essa é uma preocupação de todos os 43 vereadores da Câmara Municipal. Neste cenário, lançamos o projeto “Nossos Bairros, Nossa Fortaleza”, em parceria com a Fundação Demócrito Rocha, promovendo um mapeamento estatístico e afetivo da Capital.
Desta forma, nós, fortalezenses, pudemos redescobrir a Cidade. Conhecemos Fortaleza uma vez mais e nos apaixonamos novamente. Por meio deste livro, caro leitor, oferecemos a você a mesma experiência. Eis a nossa Fortaleza. Boa leitura.
Antônio Henrique Presidente da Câmara Municipal de Fortaleza
SUMÁRIO
46



FORTALEZA


O PAPEL DA CÂMARA
MUNICIPAL DE FORTALEZA 34
PATRIMÔNIO IMATERIAL DE FORTALEZA
14





62 REGIONAL 1 88 REGIONAL 2 118 REGIONAL 3 150 REGIONAL 4 182 REGIONAL 5





308 REGIONAL 10 198 REGIONAL 6 234 REGIONAL 7 264 REGIONAL 8 288 REGIONAL 9







336 REGIONAL 11 368 REGIONAL 12 394 AGRADECIMENTOS 382 ÍNDICE REMISSIVO
FORTALEZA




















Vasto patrimônio histórico e cultural, além de uma enorme rede de ensino e de saúde. Neste guia, você encontra um pouco da Capital cearense, suas unidades de conservação, infraestrutura, finanças públicas e perfil socioeconômico






 Fachada do Theatro José de Alencar no Centro
Fachada do Theatro José de Alencar no Centro



























FORTALEZA
Fortaleza merece um capítulo que a descreva enquanto a soma dos 121 bairros. A capital de 2,7 milhões de habitantes se desdobra em uma série de angulações. Os conteúdos deste capítulo são dados reunidos no Anuário do Ceará 20222023, publicação da Fundação Demócrito Rocha.
DADOS GERAIS
CEP: 60000-001 a 61599-999
Principais vias de acesso: BR-020 / BR-116 / BR-222 / CE-010 / CE-025 / CE-040 / CE-060 / CE-065 / CE-085
Localização: microrregião de Fortaleza
Municípios limítrofes: Aquiraz, Caucaia, Eusébio, Itaitinga e Maracanaú
DADOS COMPLEMENTARES
Estaduais de proteção integral: Parque Estadual do Cocó e Parque Estadual Marinho da Pedra da Risca do Meio
IDM (2017): 68,72 (2º no Ceará)
IDH (2010): 0,754 (1º no Ceará e 467º no Brasil)
HISTÓRIA
Data de aniversário: 13/4
Toponímia: proveniente da Fortaleza de Nossa Senhora da Assunção
Gentílico: fortalezense
GEOGRAFIA
Área: 312,407 km²
Altitude: 16 m
Latitude: 3º 43’ 02’’
Longitude: 38º 32’ 35’’
Clima: tropical quente subúmido, com chuvas de janeiro a maio
Relevo: planície litorânea, sertões e tabuleiros costeiros
Vegetação: cerrado, complexo vegetacional da zona litorânea e floresta perenifólia paludosa marítima
Precipitação pluviométrica (acumulado em 2019): 2.323,4 mm
UNIDADE DE CONSERVAÇÃO
Municipais de uso sustentável: APA da Lagoa da Maraponga
Municipais de proteção integral: Parque Natural Municipal das Dunas da Sabiaguaba
Estaduais de uso sustentável: APA do Estuário do Rio Ceará – Rio Maranguapinho, Arie do Sítio Curió, Arie do Cambeba e APA do Rio Pacoti
DEMOGRAFIA
População (Estimativa 2019): 2.669.342
População (2010): 2.452.185
Total de homens (2010): 1.147.918
Total de mulheres (2010): 1.304.267
População urbana (2010): 2.452.185
16 NOSSOS BAIRROS | NOSSA FORTALEZA
RANKING PIB CE 2010 1º 2011 1º 2012 1º 2013 1º 2014 1º 2015 1º 2016 1º 2017 1º
População rural (2010): –
Densidade demográfica (2010): 7.786,44 hab/km²
INFRAESTRUTURA
Domicílios (Censo 2010): 7710.066
Serviço de água urbano (habitantes – 2019): 2.633.011
Esgoto urbano (habitantes – 2019): 1.666.818
Serviço de água rural (habitantes – 2019): 0 Energia elétrica (clientes – dez – 2019): 1.065.820
Pontos de acesso à internet (mar – 2020): 422.225
Cinturão Digital: sim
ECONOMIA
PIB (2017): R$ 61.579.403.170
Agropecuária (2017): R$ 60.394.180
Indústria (2017): R$ 7.280.244.670
Serviços (2017): R$ 37.048.441.370
Serviços públicos (2017): R$ 8.726.235.480
Impostos, líquidos de subsídios, sobre produtos (2017): R$ 8.464.087.470
PIB per capita (2017): R$ 23.436,66
Benefícios da Previdência Social (2019): R$ 5.770.850.184
Beneficiários da Previdência Social (dez – 2019): 349.300
Bolsa Família (2019): R$ 442.778.902
Beneficiários do Bolsa Família (dez – 2019): 198.132
Instituições financeiras (maio – 2020): Banco do Nordeste (agência e posto de atendimento), Banco do Brasil (agência, posto de atendimento eletrônico e posto de
atendimento), Bradesco (agência, posto de atendimento eletrônico e posto de atendimento), Caixa Econômica (agência, posto de atendimento eletrônico e posto de atendimento), Santander (agência, posto de atendimento eletrônico e posto de atendimento), Sofisa (agência), Citibank (agência), China Construction Bank (agência), Safra (agência), Daycoval (agência), Banco Guanabara (agência), Itaú (agência, posto de atendimento eletrônico e posto de atendimento), BMG (agência), Banco Inter (agência), Poupex (agência), Portocred (posto de atendimento), BV Financeira (agência), Nova Futura (agência), Confidence Câmbio (agência e posto de atendimento), Labor Câmbio (agência), SCB Crédito (agência e posto de atendimento), MS Cred (agência), Lamara (agência), VNK Cred (agência), Sadoc (agência), Topázio (posto de atendimento eletrônico), Boa Viagem (posto de atendimento), Western Union (posto de atendimento), Triângulo (posto de atendimento), Cotação (posto de atendimento), Losango (posto de atendimento), Pan (posto de atendimento), Frente (posto de atendimento), Sicredi Ceará Centro Norte (posto de atendimento), Advanced (posto de atendimento), Conbrav (filial de administradora de consórcio), BR Consórcios (filial de administradora de consórcio), Recon (filial de administradora de consórcio), Embracon (filial de administradora de consórcio) e Canopus (filial de administradora de consórcio)
FINANÇAS PÚBLICAS
Receita Total (2019)*: R$ 5.141.825.409,02
Receita Tributária (2019)*: R$ 1.221.225.877,62
Cota-parte do FPM (2019)*: R$ 610.474.300,08
Transferência do SUS (2019): R$ 1.083.987.281,48
Cota-parte do ICMS (2019)*: R$ 660.614.120,12
Fundeb (estimativa – 2020): R$ 945.241.772,92
Despesa Total (2019)*: R$ 5.234.197.910,44
Despesa de Pessoal (2019)*: R$ 2.839.418.740,90
* Os dados são referentes ao segundo quadrimestre (mai-ago).
17 FORTALEZA
EDUCAÇÃO
Escolas de educação infantil (2019): 863
Escolas de ensino fundamental (2019): 1.019
Escolas de ensino médio (2019): 301Escolas de ensino profissional (2019): 75
Bibliotecas: Biblioteca Pública Estadual Governador Menezes Pimentel; Biblioteca Pública Municipal Cristina Poeta; Biblioteca Pública Municipal Dolor Barreira; Biblioteca Pública Municipal Herbênia Gurgel
Escolas em áreas remanescentes de quilombolas (2019): 3
Instituições de ensino superior presenciais (2020): 52
Matrículas da educação infantil (2019): 100.716
Matrículas do ensino fundamental (2019): 300.132
Matrículas do ensino médio (2019): 99.013
Taxa de abandono (2018)
Anos iniciais (até o 5º ano): 0,3
Anos finais (do 6º ao 9º ano): 1,1
Nota do Ideb (2017)
Anos iniciais (até o 5º ano): 6
Anos finais (do 6º ao 9º ano): 4,7
Ensino Médio: 4
SAÚDE
Transferência SUS hab/ano (2019): R$ 410,1
Cobertura Saúde da Família (dez-2019): 54,56%
Taxa de Mortalidade Infantil (2019)*: 11,4%
* A cada mil nascidos vivos. Segundo informado pela Secretaria da Saúde do Estado, os dados estão sujeitos a revisão.
CULTURA
Arquivos: Arquivo Intermediário e Arquivo Público do Estado do Ceará
Museus: Casa de Cultura Cristiano Câmara; Casa de José de Alencar; Casa de Juvenal Galeno; Centro Cultural Banco do Nordeste; Centro Cultural do Transporte; Centro de Memória da Educação no Ceará; Centro de Memória do Tribunal Regional Eleitoral do Ceará (TRE-CE); Espaço Cultural Correios-Fortaleza; Espaço Cultural Museu do 10º GAC; Instituto Histórico e Cultural da Polícia Militar do Ceará; Memorial da Assembleia Legislativa do Ceará Deputado Pontes Neto; Memorial da Justiça do Trabalho do Ceará; Memorial da Resistência; Memorial da Universidade Federal do Ceará; Memorial do Instituto Federal do Ceará – Raimundo César Gadelha de Alencar Araripe; Memorial do Poder Judiciário do Estado do Ceará; Minimuseu Firmeza; Museu Amalgâmico Solar Sapiranga; Museu Barão de Studart; Museu Cearense da Comunicação (Arquivo Nirez); Museu da Boneca de Pano; Museu da Cultura Cearense; Museu da Escrita Professora Maria Isaurita Gomes Morais; Museu da Imagem e do Som; Museu da Indústria; Museu da Infância e do Brinquedo; Museu da Motocicleta (Moto Museu Século XX); Museu de Arte Contemporânea (MAC); Museu de Arte da Universidade Federal do Ceará (Mauc); Museu de Minerais Doutor Odorico Rodrigues de Albuquerque; Museu do Automóvel; Museu do Ceará; Museu do Futebol; Museu do Humor Cearense; Museu do Parto: um tributo a Galba Araújo; Museu Ferroviário do Ceará; Museu General Sampaio; Museu Natural do Mangue (Projeto Educar Sabiaguaba); Museu Professor Benício Vasconcelos de Tavares; Museu Siará em Miniatura; Parque Ecológico do Rio Cocó; Parque Estadual Marinho da Pedra da Risca do Meio; Planetário Rubens de Azevedo; Seara da Ciência (UFC); Sobrado Doutor José Lourenço
Teatros convencionais: Casa da Comédia Cearense; Cineteatro São Luiz; Teatro Antonieta Noronha; Teatro Arena Aldeota (Colégio Christus); Teatro Caixa Cultural; Teatro Carlos Câmara; Teatro Ceará Show (Fernando Catony); Teatro Celina Queiroz (Unifor); Teatro Chico Anysio; Teatro da Boca Rica (Associação Educativa Cultural Teatro da Boca Rica); Teatro da Seara da Ciência (UFC); Teatro do Centro Cultural do Bom Jardim; Teatro do Centro Dragão do Mar; Teatro do Cuca Barra do Ceará; Teatro do Cuca Mondubim; Teatro do Ibeu (Aldeota); Teatro Marista Cearense; Teatro Morro do Ouro (anexo Theatro José de Alencar); Teatro Nadir Papi Saboya; Teatro Paurillo Barroso (Colégio Christus); Teatro RioMar
18 NOSSOS BAIRROS | NOSSA FORTALEZA
Fortaleza; Teatro São José; Teatro Sesc Emiliano Queiroz; Teatro Sesc Iracema (Porto Iracema); Teatro Universitário Paschoal Carlos Magno; Theatro José de Alencar; Theatro Via Sul
Teatros alternativos: Aldeia Teatral; Amor e Doações; Anfiteatro do Centro Dragão do Mar; Anfiteatro do Parque do Cocó; Anfiteatro Flávio Ponte (Volta da Jurema); Anfiteatro Paço Municipal; Associação Afro-Brasileira de Cultura Alágba; Associação Cultural Afro-Brasileira Bloco Afoxé Camutuê Alaxe (Acabaca); Associação Cultural Imperadores da Parquelândia; Associação Cultural Maracatu Nação Fortaleza; Associação Cultural Solidariedade e Arte (Solar); Associação dos Produtores de Cultura do Ceará; Associação Santo Dias; Associação Vidança (Companhia de Dança do Ceará); Casa Amarela Eusélio Oliveira; Casa AME – Arte, Música e Espetáculo; Casa da Cultura Digital (Citinova); Casa da Esquina; Casa Psicodélica; Cena Casarão (Herê Aquino); Centro Criativo Bom Mix; Centro Cultural Capoeira Água de Beber; Centro Cultural Zé Testinha; Centro de Eventos do Ceará; Cia Palmas Produções Artísticas (Francinice Campos); Conselho Comunitário dos Moradores do Parque Santa Cecília; Espaço Cultural Correios; Espaço Cultural Unifor; Espaço do Grupo Teatro de Caretas; Espaço Geração Cidadã; Fundação Social Raimundo Fagner; Grupo Bailarinos de Cristo; Homeless Centro Cultural; Instituto
do Ceará (Histórico, Geográfico e Antropológico); Movimento de Saúde Comunitária Bom Jardim; Palco da Praça Mestre Pedro Boca Rica (anexo Theatro José de Alencar); Palco do Jardim Burle Max (anexo Theatro José de Alencar); Planetário Rubens de Azevedo; Sala Hugo Bianchi (anexo Theatro José de Alencar); Sala Jacques Klein (anexo Theatro José de Alencar); Sala Nadir Papi Saboya (anexo Theatro José de Alencar); Salão das Ilusões; Sem Título Arte; Teatro da Bela Vista; Teatro da Cia Acontece; Teatro do Humor Cearense (Humoristas); Via de Acesso à Arte e Cultura (Vaac) Centros culturais: Centro Cultural Banco do Nordeste; Centro Cultural Belchior; Centro Cultural Bom Jardim; Centro Cultural Caixa; Centro Cultural do Prodecom; Centro Cultural Dragão do Mar de Arte e Cultura
PATRIMÔNIO HISTÓRICO
Tombamento federal: Assembleia Provincial (Museu do Ceará); Casa natal de José de Alencar; Coleção Arqueológica do Museu da Escola Normal Justiniano de Serpa (sob a guarda do Museu do Ceará); Fortaleza de Nossa Senhora da Assunção; Palacete Carvalho Mota (antigo Museu das Secas e atual arquivo do Dnocs); Passeio Público (antiga Praça dos Mártires); Theatro José de Alencar (TJA)

19 FORTALEZA
FCO FONTENELE
Ponte do Rio Ceará, na Barra do Ceará, foi inaugurada em1997 e liga Fortaleza a Caucaia
Tombamento estadual: Antiga Alfândega; Antiga Escola Normal (sede do Iphan); Banco Frota Gentil; Casa de Detenção ou Antiga Cadeia Pública (Centro de Turismo); Casa de Juvenal Galeno; Casa de Thomaz Pompeu; Cineteatro São Luiz; Colégio Marista de Fortaleza; Conjunto Palácio da Abolição e Mausoléu Castelo Branco (residência oficial do governador); Edifício Residencial Unifamiliar (prédio onde residiu Rodolfo Teófilo); Escola Jesus, Maria e José; Estação Ferroviária Doutor João Felipe; Farol do Mucuripe; Galpões da RFFSA (extensão do Conjunto da Estação João Felipe); Hotel do Norte (Museu da Indústria); Igreja Nossa Senhora do Rosário; Museu da Imagem e do Som do Ceará (MIS-CE); Palacete Ceará (Caixa Econômica Federal da Praça do Ferreira); Palacete Jeremias Arruda (Instituto do Ceará); Palácio da Luz (Academia Cearense de Letras); Praça General Tibúrcio (Praça dos Leões); Secretaria Estadual da Fazenda; Seminário da Prainha; Sobrado Doutor José Lourenço; Solar Fernandes Vieira (Arquivo Público)
Tombamento municipal: Antiga Sede do Sport Club Maguary; Bosque do Pajeú; Capela de Santa Terezinha; Casa do Barão de Camocim; Casa do Português; Casa Rachel de Queiroz; Cineteatro São Luiz; Colégio Cearense do Sagrado Coração (atual Centro Universitário Estácio do Ceará); Colégio Doroteias (atual Uninassau); Comando Geral do Corpo de Bombeiros Militar do Estado do Ceará; Escola Jesus, Maria e José; Espelho de Água da Lagoa de Messejana; Espelho de Água da Lagoa de Parangaba; Estação Ferroviária da Parangaba; Estoril; Farmácia Oswaldo Cruz; Feira de Artesanatos da Beira Mar; Ideal Clube; Igreja de São Pedro dos Pescadores; Instituto Municipal de Desenvolvimento de Recursos Humanos (Imparh); Mercado da Aerolândia; Mercado dos Pinhões; Náutico Atlético Cearense; Palácio João Brígido; Paróquia do Senhor do Bom Jesus dos Aflitos (Igreja da Parangaba); Parque da Liberdade (Cidade da Criança); Passeio Público; Pavimentação da Rua José Avelino; Ponte dos Ingleses; Riacho Papicu e suas margens; Santa Casa da Misericórdia; Teatro São José
Tesouros Vivos: Mestres da Cultura 2005 – Mestra Dona Gerta (†) e Mestre Zé Pio; Mestre da Cultura 2007 – Mestra Dona Nice Firmeza (†); Mestres da Cultura 2018 – Mestre Geraldo Amâncio, Mestra Mãe Zimá, Mestre Zé Renato e Mestre Paulão Ceará; Tesouro Vivo 2018 – Maracatu Az de Ouro; Mestre da Cultura 2019 – Mestre João Pedro do Juazeiro; Tesouro Vivo 2019 – Maracatu Rei de Paus
Padroeira: Nossa Senhora da Assunção
MEIOS DE COMUNICAÇÃO AFILIADOS À ACERT
Emissoras de televisão: TV O POVO, TV Assembleia, TV Diário, TV Jangadeiro e TV Verdes Mares
Emissoras de rádio:
FM: Rádio O POVO CBN 95.5 FM, NovaBrasil FM 106.5, FM Assembleia, FM Cidade, FM 93 Rádio Verdes Mares, Jovem Pan News, Rádio Atlântico Sul, Rádio Dom Bosco 96.1, Rádio Jangadeiro FM, Rádio Jovem Pan, Rádio Tempo FM, Rádio 89.9 FM, Nossa Rádio FM, Tribuna Band News, Universitária FM e 99.9 FM Rede Aleluia
AM: Rádio O POVO CBN AM 1010, Cidade AM, Iracema de Fortaleza, Rádio Assunção, Rádio Clube AM 1200, Rádio Uirapuru, Shalom 690 AM e 810 Verdinha Jornais impressos associados à Associação Nacional de Jornais (ANJ): O POVO e Diário do Nordeste
SEGURANÇA PÚBLICA
Polícia Militar (2020): 10 batalhões operacionais na Capital e 3 na Região Metropolitana
Polícia Civil (2020): 54 delegacias na Capital (sendo 25 distritais e 29 especializadas), 27 na Região Metropolitana (sendo 14 metropolitanas, 10 distritais e 3 especializadas) e 16 delegacias plantonistas (sendo 12 na Capital e 4 na Região Metropolitana)
Efetivo Capital: 1.875 policiais do policiamento especializado na Capital e 532 na Região Metropolitana
Bombeiros (abr – 2020): 18 unidades na Capital
Efetivo (maio – 2020): 880 bombeiros
Guarda Municipal (abr – 2020): 2.300 (201 inspetores, 395 subinspetores e 1.704 guardas municipais)
Agentes da Defesa Civil (abr – 2020): 114
Agentes de Segurança Institucional: 15
Efetivo (abr-2019): 867 bombeiros
Guarda Municipal (2019): 2.050 (218 inspetores, 406 subinspetores e 1.416 guardas municipais)
20 NOSSOS BAIRROS | NOSSA FORTALEZA
Agentes da Defesa Civil (jun-2019): 105
Agentes de Segurança Institucional: 14
JUSTIÇA
Fórum Clóvis Beviláqua
Telefone: (85) 3216 6000
Varas: Cíveis – 39; Família – 18; Sucessões – 5; Fazenda Pública – 15; Execuções Fiscais – 6; Crimes contra a Ordem Tributária – 1; Delitos de Organizações Criminosas – 1; Registros Públicos – 2; Recuperação de Empresas e Falência – 2; Infância e Juventude – 5; Criminais – 18 (observação: a 17ª Vara Criminal foi transformada para Vara única de Audiências de Custódia, atuando somente para este tipo de demanda); Júri – 5; Delitos e Tráfico de Drogas – 4; Execução Penal e Corregedoria dos Presídios – 3; Execuções de Penas e Medidas Alternativas – 1; Juízo Militar – 1; Juizados Especiais Cíveis – 20; Juizados Especiais Criminais – 4; Juizado da Violência
Doméstica e Familiar contra a Mulher – 1
Promotorias: 193 – Fortaleza / 255 – Entrância Final (Fortaleza, Maracanaú, Caucaia, Sobral, Crato e Juazeiro do Norte)
Procuradoria-Geral da Justiça
Telefone: (85) 3452 3701 / 3702 / 3749
Defensoria Pública
Telefone: (85) 3101 3434
Telejustiça
Telefone: (85) 3216 6000
Fórum eleitoral
Telefone: (85) 3211 2675 / 2677 / 2679
POLÍTICA
Eleitores (maio – 2020): 1.825.169
Perfil dos eleitores (maio – 2020):
Masculino: 819.523
Feminino: 1.004.972
Não informado: 674
Deputados federais mais votados (2022): André Fernandes (PL): 229.509 votos, Júnior Mano (PL): 216.531 votos, Célio Studart (PSD): 205.106 votos
Deputados estaduais mais votados (2022): Carmelo Neto (PL): 118.603 votos, Evandro Leitão (PDT): 113.808 votos, Marta Gonçalves (PL): 112.787 votos
Vereadores mais votados (2016): Célio Studart (E) –38.278 votos, Adail Júnior (E) – 15.912 votos, Salmito (E) – 15.551 votos
ADMINISTRAÇÃO PÚBLICA
RANKING ICGM (2018): 1º
Telefone: (85) 3105 1099 / 1165
Prefeito: José Sarto (PDT)
Vereadores: 43
Distritos: Fortaleza, Antônio Bezerra, Messejana, Mondubim e Parangaba
CNPJ: 07.954.605/0001-60
FORTALEZA EM SÍNTESE
A Capital cearense em 2021 mantém sua representatividade demográfica entre as maiores do País, já em termos econômicos os resultados ainda refletem as disparidades regionais e os impactos da pandemia de Covid-19. A cidade de Fortaleza apresenta um desempenho fiscal equilibrado com continuidade de uma política de investimentos arrojada e um setor de Serviços diversificado que atenuou os impactos de choques adversos na arrecadação e autonomia financeira local.
21 FORTALEZA
I - PERFIL
SOCIOECONÔMICO
1 – DEMOGRAFIA, EDUCAÇÃO E SAÚDE
As informações do Instituto Brasileiro de Geografia e Estatística (IBGE) para estimativas populacionais mais recentes, apresentadas no gráfico adiante, qualificam a cidade de Fortaleza como a 5ª em população, com 2,7 milhões de habitantes, atrás apenas de São Paulo, Rio de Janeiro, Brasília e Salvador.
O seu território relativamente pequeno faz dela a primeira cidade em densidade demográfica, com 8,5 mil hab./km², à frente de grandes cidades como São Paulo, que possui 8,1 mil hab./km² na última estimativa disponível.
10 BAIRROS MAIS POPULOSOS
1. Barra do Ceará: 79.346
2. Vila Velha: 67.508
3. Mondubim: 62.264
4. Granja Lisboa: 57.017
5. Passaré: 55.809
6. Jangurussu: 55.306
7. Vicente Pinzón: 49.870
8. Pici: 46.555
9. Aldeota: 46.411
10. Messejana: 45.675
A distribuição da população é equilibrada por gênero e predominantemente adulta, com aproximadamente 60% dela entre 19 e 59 anos. Espacialmente, as maiores concentrações situam-se nos bairros de mais baixa renda em um “cinturão” que vem do Noroeste ao Centro-Sul da Cidade. Dos dez bairros mais populosos, os oito primeiros são classificados como de baixa renda e apenas um, Aldeota, compreende pessoas de renda média ou alta.
Da população de quase 400 mil habitantes até nove anos de idade prevista para 2021, aproximadamente a metade corresponde às matrículas no Ensino Público Fundamental, o qual tem 92,2% de matrículas providas pela Rede Municipal, com 185,7 mil alunos, e outros 15,7 mil na rede estadual.
22 NOSSOS BAIRROS | NOSSA FORTALEZA
POPULAÇÃO RESIDENTE NA CIDADE DE FORTALEZA PARTICIPAÇÃO NO ESTADO DO CEARÁ = 29% 2019 2020 2021 2.669.342 2.686.612 2.703.391 FONTE: elaborado com dados do IBGE 2.710.000,00 2.700.000,00 2.690.000,00 2.680.000,00 2.670.000,00 2.660.000,00 2.650.000,00 FONTE: Prefeitura Municipal de Fortaleza DISTRIBUIÇÃO ETÁRIA – SMS (2020) 60+ 19-59 10-18 0-9 500.000 1.000.000 1.500.000 2.000.000 260.356 1.618.621 428.113 379.517
2 – DESPESA PÚBLICA EM ÁREAS
SOCIAIS E INVESTIMENTOS
Com base nos parâmetros de transparência dos gastos públicos e a consecução das metas fiscais sem comprometer as demandas da população, o município de Fortaleza atendeu devidamente os limites mínimos e respeitou os máximos previstos em lei nas rubricas de Educação, Saúde e Pessoal, conforme se constata no gráfico adiante.
Em 2021, o Município destinou 45,9% de sua Receita Corrente Líquida (RCL) para os Gastos com Pessoal, mesmo nível de 2020 e abaixo dos limites de alerta e prudencial.
Completando este panorama em relação aos indicadores legais, ressalta-se a importância das áreas sociais como Educação e Saúde em termos da atenção requerida pela sociedade. Não por acaso a CF/1988 prevê limites mínimos de 25% e 15% da Receita Líquida de Impostos e Transferências (RLIT) a serem aplicados em cada respectiva área.
Em Fortaleza, o cenário recente comprova que o dispêndio com a Saúde tem superado em 10 p.p. o limite mínimo constitucional e, em 2021, em decorrência da continuidade da pandemia que justificou a manutenção de gastos expressivos nessa área, superou em 11,0 p.p.. Com efeito, a pandemia trouxe incertezas à área da Saúde que justificaram a ampliação dos inves-
timentos e, por conseguinte, dos gastos, principalmente na ampliação de leitos e profissionais que viessem a atender OS pacientes nos períodos de aumento desordenado de casos.
3 – INVESTIMENTOS, ENDIVIDAMENTO E AUTONOMIA FINANCEIRA
Dada a importância dos investimentos, indispensáveis à retomada da economia sem o comprometimento da prestação nem da qualidade dos bens e serviços ofertados à população, em 2021 o Município investiu R$ 938 milhões, conforme destaca o gráfico a seguir. O montante é um pouco inferior ao observado em 2020, quando foram investidos mais de 1 bilhão de reais, o maior investimento da história do município de Fortaleza, mas ainda acima do valor nominal de 2019.
INVESTIMENTOS EM R$ MILHÕES
Diante dos resultados fiscais apresentados, cabe citar o indicador que mensura o nível de endividamento municipal, dado pela razão entre a Dívida Consolida Líquida (DCL) e a Receita Corrente Líquida (RCL) e que não deve ultrapassar 1,2 (ou 120%). De acordo com o gráfico a seguir, a trajetória da dívida vem sendo contínua e sustentável, o que implica uma política fiscal solvente.
23 FORTALEZA MATRÍCULAS NA REDE MUNICIPAL DE ENSINO Educação infantil Ensino Fundamental 54.785 185.659 200.000 180.000 160.000 140.000 120.000 100.000 80.000 60.000 40.000 20.000 0
FONTE: Instituto Nacional de Estudos e Pesquisas Educacionais Anísio Teixeira (Inep) - Censo Escolar
FONTE:
2019 2020 2021 712 1.002 938 1.200,00 1.000,00 800,00 600,00 400,00 200,00 -
Secretaria Municipal das Finanças (Sefin)
Adicionalmente, outro indicador que merece destaque é o de Autonomia Financeira, que mensura o percentual de receita corrente obtido com recursos próprios – impostos, taxas e contribuições -, independente de transferências de outras esferas de governo. Dessa forma, quanto maior for este indicador, maior será a parte das aplicações financiadas por receitas próprias e, consequentemente, menor será o grau de dependência do Município. Ou seja, quanto maior a autonomia, maior a capacidade do Município para fazer face aos seus compromissos financeiros de longo prazo.
O gráfico comprova a manutenção da Autonomia Financeira de Fortaleza em torno de 30,0% entre 2019 e 2021, com o máximo de 33% observado em 2018 e 32% em 2019, mesmo em período de elevada instabilidade política e dos fortes impactos das desonerações fiscais promovidas pela União sobre as finanças locais.

Em 2020, a queda do indicador da Autonomia Financeira foi motivada pela crise econômica provocada pela pandemia de Covid-19, que, pelas medidas de isolamento social, reduziram as receitas próprias, além de exigir do Governo Federal um aumento das transferências correntes para conter os impactos da crise.
Observa-se ainda que a Receita Corrente apresenta crescimento entre 2020 e 2021, mas o crescimento mais que proporcional das transferências mantém relativamente estável o indicador de autonomia, que leva em consideração a razão entre os recursos próprios e os recursos correntes.
24 NOSSOS BAIRROS | NOSSA FORTALEZA FONTE:
Municipal das Finanças (Sefin) INDICADORES FISCAIS SELECIONADOS 2019-2021 (EM %) 26,6 28,7 26,6 46 45,9 25,4 26 26,4 42,3 50% 45% 40% 35% 30% 25% 20% 15% 10% 5% 0% Pessoal Educação Saúde 2019 2020 2021
Secretaria
INDICADOR DE ENDIVIDAMENTO E RECEITA CORRENTE LÍQUIDA (RCL) 2019 2020 2021 6.886,26 7.107,31 7,4% 24,6% 27,4% 7.702,30 7.800,00 7.600,00 7.400,00 7.200,00 7.000,00 6.800,00 6.600,00 6.400,00 30% 25% 20% 15% 10% 5% 0 RCL DCL/RCL FONTE
: Elaborado com dados da Sefin
II - ECONOMIA BASEADA EM UM SETOR DE SERVIÇOS DIVERSIFICADO
da arrecadação do principal imposto advém de segmentos considerados de baixo risco. Trata-se de um setor competitivo, com segmentos que individualmente representam no máximo 12% da arrecadação de ISSQN, e onde 90% não superam os 5% de representatividade na arrecadação.

Utilizando uma classificação da Secretaria das Finanças (Sefin) para os segmentos do setor de Serviços, avalia-se a associação destes com a receita global da Cidade para uma classificação de risco, da qual se obtém que mais da metade
A partir da arrecadação do ISSQN dos 59 segmentos considerados, 53,7% vêm de segmentos correlacionados com as administrações públicas federal, estadual ou municipal ou relacionados a atividades consideradas essenciais e pouco sensíveis às flutuações econômicas. Por outro lado, 23,8% estão associados a segmentos ditos de “bens de luxo” como Turismo e Congêneres, Academias, Hospedagem e Eventos e, como tal, são considerados de alto risco, pela exposição aos choques econômicos.
25 FORTALEZA Avenida Beira Mar, no Meireles, é ponto de encontro, esporte e lazer para toda a população AUTONOMIA FINANCEIRA MUNICIPAL 2019 2020 2021 2.415.092.958 2.349.422.571 2.507.228.210 32,5% 32% 31,5% 31% 30,5% 30% 29,5% 29% 28,5% Receita Própria Autonomia FONTE: Elaborado com dados da Prefeitura de Fortaleza - Lei Orçamentária Anual (LOA) 2022 29,9% 30,2% 32% 2.550.000.000 2.500.000.000 2.450.000.000 2.400.000.000 2.350.000.000 2.300.000.000 2.250.000.000
FCO FONTENELE
Em relação aos demais impostos, observa-se que Fortaleza em 2021 já superou, em termos nominais, os valores arrecadados em 2019 após a queda verificada de 2019 para 2020 por conta da queda no nível de atividade e das medidas de isolamento na pandemia. O Imposto Sobre Serviços (ISS) se aproxima da marca de R$ 1 bilhão por ano, quase o dobro do IPTU, que, em virtude de elevada inadimplência, situa-se abaixo de R$ 600 milhões e do ITBI, que apresentou, inclusive, crescimento mesmo no período da pandemia, e responde por R$ 169 milhões da arrecadação total da Cidade.

26 NOSSOS BAIRROS | NOSSA FORTALEZA
53,7%
8,40%
23,8%
14,2%
FONTE: Relatórios da Sefin
Baixo
Médio
Muito alto
Alto
ISS IPTU ITBI 879,98 837,37 496,5 130,52168,97 566,65 983,81 501,46 122,95 1.000,00 800,00 600,00 400,00 200,00 0,00 2019 2020 2021
ARECADAÇÃO DE IMPOSTOS (2019–2021)
FONTE: Relatórios da Sefin
FCO FONTENELE
Passeio Público no Centro da Cidade
ORÇAMENTO DE FORTALEZA 2022
Fortaleza começou 2022 com previsão de orçamento, de acordo com a Lei Orçamentária Anual (LOA), de R$ 9,9 bilhões. O valor da despesa é o mesmo estimado para a receita do Município. A lei que define as diretrizes do orçamento para 2022 é a Lei nº 11.222, de 27 de dezembro de 2021, suplemento ao Diário Oficial do Município (DOM), nº 17.219, de 27 de dezembro de 2021.
A despesa total fixada foi de R$ 9,9 bilhões divididos em R$ 5,9 bilhões para o Orçamento Fiscal, R$ 4 bilhões para o Orçamento da Seguridade Social e R$ 10 milhões para o Orçamento de Investimentos das Empresas.
VALORES DO ORÇAMENTO 2020-2022
reza (ISSQN), Imposto sobre Transmissão “Inter Vivos” de Bens Imóveis e de Direitos Reais sobre Imóveis (ITBI), entre outros.
De acordo com a previsão da Receita Orçamentária, pode-se perceber que mais da metade das estimativas fixam-se no item Transferências Correntes (R$ 5 bilhões), da mesma forma que em 2021. Esses altos valores evidenciam a dependência financeira do município de Fortaleza em relação aos recursos oriundos de Transferências Constitucionais e Voluntárias.
DESPESAS DO EXECUTIVO
Assim como em 2021, os gastos com pessoal e encargos sociais de 2022 são os que mais pesam aos cofres da Prefeitura, com R$ 4,6 bilhões. Além deste valor, cerca de R$ 3,8 bilhões serão utilizados para outras despesas correntes.
Os recursos previstos pela LOA são aplicados ao longo do ano no pagamento de despesas de vários órgãos. O valor é aplicado, também, em dívidas envolvendo juros e amortização, além de investimentos em obras, recuperação e ampliação de equipamentos. As áreas de saúde, educação, previdência social e urbanismo são as que vão receber o maior volume de recursos. Do Orçamento serão destinados R$ 2,7 bilhões para a Saúde, R$ 2,4 bilhões para a Educação, R$ 1 bilhão para a Previdência Social e R$ 912 milhões para o Urbanismo.
RECEITAS
O valor das receitas correntes para 2022 ficou em R$ 9,2 bilhões e compreende o recolhimento de tributos devidos ao Município como o Imposto sobre a Propriedade Predial e Territorial Urbana (IPTU),Imposto sobre Serviços de Qualquer Natu-
Para o gabinete do vice-prefeito, está prevista a despesa de R$ 3.641.763. A Câmara Municipal de Fortaleza (CMFor) teve aumento de 2,9% no valor da despesa ao somar R$ 210 milhões; em 2021, o valor era de R$ 204 milhões.
DESPESAS APLICADAS NO COMBATE AO NOVO CORONAVÍRUS
De acordo com dados do Portal da Transparência da Prefeitura de Fortaleza, o total de despesas aplicadas no combate ao Covid-19 em 2021, por área de atuação, foi de mais de R$ 8,6 bilhões (R$ 8.629.266.990,12).
Os valores por área de atuação foram para a Saúde, no consolidado de 2021, R$ 2,5 bilhões. Com a Previdência Social foi pago R$ 1 bilhão; com a Administração, R$ 677 milhões; e com a Assistência Social, R$ 134 milhões.
27 FORTALEZA
ANO Valor Variação em relação ao ano anterior (%) 2020 R$ 8.939.401.538 10% 2021 R$ 9.109.978.819 1,9% 2022 R$ 9.949.542.494 9,2%
FAIXAS EXCLUSIVAS
AV.LESTEOESTE
AV.LESTEOESTE
AV.FRANCISCOSÁ
AV.BEZERRADEMENEZES
AV.JOSÉBASTOS
RUAPADRE MORORÓ RUACASTROESILVA
AV.IMPERADOR
AV.CARAPINIMA
AV.TRISTÃO GONÇALVES RUA GENERAL SAMPAIO
AV.DOMINGOSOLÍMPIO
AV.DAUNIVERSIDADE
AV.ABOLIÇÃO
AV.DOMLUÍS
AV.AMÉRICOBARREIRA
RUAGERMANO FRANCK
AV.GENERALOSÓRIODEPAIVA
AV.JOÃOPESSOA
RUACÉSAR ROSAS
AV.PROFESSORGOMESDEMATOS
RUAALMIRANTE RUBIM
AV.ANTÔNIOSALES RUAPADREVALDEVINO AV. AGUANAMBI


AV.SANTOSDUMONT
AV.ENGENHEIROALBERTOSÁ











AV. GODOFREDO MACIEL
AV.PRESIDENTECOSTAESILVA
AV. BERNARDO MANUEL
AV. ALBERTO CRAVEIRO
AV.PRESIDENTE JUSCELINO KUBITSCHEK
AV. PRESIDENTE COSTA E SILVA
LEGENDA
Faixas Exclusivas
Fluxo (Junto à calçada)

Contrafluxo (Junto à calçada)


























BRT (Junto ao canteiro)

30 NOSSOS BAIRROS | NOSSA FORTALEZA
PATRIMÔNIO IMATERIAL
Patrimônio imaterial é todo aquele que é transmitido de geração a geração. É o que desperta o sentimento de identidade de um povo. Nas páginas a seguir, apresentamos as manifestações populares e práticas culturais que para além das estatísticas desenham a cidade de Fortaleza


























































TRADIÇÕES CULTURAIS E RELIGIOSAS DESENHAM A

ALMA DE FORTALEZA
THIAGO MATINE/SECULTFOR
O tríduo que celebra São Pedro dos Pescadores, padroeiro dos pescadores, ocorre nos dias 27, 28 e 29 de junho
Nas cidades vivemos rodeados pela cultura material, muitas vezes tombada para preservação, em suas mais diferentes formas: são obras de arte, igrejas, prédios históricos e muitos outros bens físicos que carregam a memória de um espaço e de seu povo. Mas e o que não pode ser tocado? Como preservar o valor dos festejos em comunidade, dos saberes populares, das práticas religiosas e culturais? Foi buscando respostas para essas perguntas que a Constituição Federal de 1988, através do artigo 216, ampliou o conceito de bem cultural, abrindo espaço para discutir a importância da imaterialidade para a formação do povo brasileiro.
Segundo o Instituto do Patrimônio Histórico e Artístico Nacional (Iphan), patrimônio imaterial é todo aquele que é “transmitido de geração a geração, constantemente recriado pelas comunidades e grupos em função de seu ambiente, de sua interação com a natureza e de sua história, gerando um sentimento de identidade e continuidade, contribuindo para promover o respeito à diversidade cultural e à criatividade humana”.
Em Fortaleza, há cinco manifestações registradas como Patrimônio Imaterial e uma em processo de registro. Na Capital, há duas formas para que um bem cultural seja alçado ao título de patrimônio. Uma é por decreto. Outra é após o pedido formal para concessão do título, solicitação que pode ser realizada por qualquer cidadão. Após esse pedido, é feita uma pesquisa que é enviada para avaliação de órgãos competentes e do Conselho Municipal de Proteção ao Patrimônio Histórico-Cultural (Comphic). Sendo aprovado, o bem passa por um processo de inventário e pode ser inscrito em um ou mais dos cinco livros de registro.
São eles: o livro dos Saberes, que trata do conhecimento e dos modos de fazer de determinadas comunidades; o livro das Celebrações, que reúne rituais e festas que marcam a vivência coletiva do trabalho, religiosidade, entretenimento ou outras práticas da vida social; o livro das Formas de Expressão, que registra manifestações artísticas e lúdicas; o livro dos Lugares, que pode inscrever feiras, mercados, santuários e outros espaços que são o centro de práticas culturais coletivas; e o livro de Patrimônio Vivo, destinados a mestres de conhecimento, práticas ou técnicas que preservam a memória da Capital.
Para se tornar um patrimônio imaterial, alguns pontos são considerados. “O primeiro deles é a relevância histórico-cultural do bem. Outro é o interesse dos que representam a manifestação. Precisa de um motivo para ser importante para a cidade e para a comunidade. E o título precisa ser mais importante para eles que para nós”, resume Graça Martins, gerente da célula de Patrimônio Imaterial da Secretaria Municipal da Cultura de Fortaleza (Secultfor).
CONHECER PARA PRESERVAR
O principal ganho é a garantia de continuidade das manifestações, que podem ter valor cultural, religioso ou social. “O registro é uma forma de reconhecimento, um fortalecimento, uma forma de fazer com que o estado se dedique e fomente aquela manifestação muito mais do que ele já fomenta efetivamente”, explica Graça Martins.
A cada dez anos, os bens passam por um processo de revalidação para continuar com o título de Patrimônio Imaterial. Nesse momento, é feita uma nova pesquisa para entender o contexto de relevância e as mudanças que porventura ocorreram naqueles espaços ou manifestações. Caso o bem patrimonial não se encaixe nos critérios elencados pelo Iphan, ele perde o título de Patrimônio.
VALORIZAÇÃO E COMBATE À INTOLERÂNCIA
Em Fortaleza, dois dos bens materiais se relacionam com religiões de matriz africana: o maracatu e a Festa de Iemanjá. Antes marginalizadas, as manifestações têm se fortalecido na Capital com o apoio do poder público. “Embora a gente tenha um grau de intolerância muito grande, há muitas pessoas - estudantes, brincantes de carnaval - que vão para os maracatus e conhecem os terreiros. A
Festa de Iemanjá hoje é apinhada de gente. Hoje há uma legitimidade e segurança maior, e eu acho que o registro ajudou muito", comenta a gerente.
37 PATRIMÔNIO IMATERIAL
CONHEÇA OS PATRIMÔNIOS IMATERIAIS
DE FORTALEZA:
FESTEJOS E IGREJA DE SÃO PEDRO DOS PESCADORES
Os Festejos de São Pedro dos Pescadores e a igreja de mesmo nome, localizada na avenida Beira Mar, no Mucuripe, são exemplos de casos em que a definição entre patrimônio imaterial e material se confunde, visto que a prática cultural e o local onde ela ocorre têm igual importância para salvaguardar a memória da comunidade. Por isso, desde 10 de dezembro de 2012, ambos estão inscri-
tos como Patrimônio Imaterial de Fortaleza - a festa no livro de registro das Celebrações e a capela, no de Lugares.
A celebração de fé ocorre desde 1930, é a única procissão marítima do Estado e um símbolo da cultura e da ancestralidade dos pescadores. “O mercado imobiliário toma conta de quase tudo, mas eles se mantêm resilientes com essa festa, para celebrar o santo”, afirma Graça Martins, gerente de Patrimônio Imaterial da Seculfor. O evento foi o primeiro bem a constar nos livros de bens imateriais da Capital. “O registro fortalece os caminhos para que essas manifestações aconteçam”, completa Graça.

38 NOSSOS BAIRROS | NOSSA FORTALEZA
Festejos de São Pedro dos Pescadores é a única procissão marítima do Estado e ocorre desde 1930
O tríduo que relembra o padroeiro dos pescadores ocorre nos dias 27, 28 e 29 de junho e reforça a relação dos fiéis com sua religiosidade. Além da missa no Dia de São Pedro, há uma procissão composta por jangadeiros. Apesar do momento principal, são muitas as pequenas ações que compõem esse patrimônio: as velas das jangadas, pintadas pelos pescadores, por exemplo; quermesses, com atrações culturais e gastronômicas; e os encontros entre as famílias da comunidade pesqueira, que se reúnem com foco na fé e no espírito comunitário.
De acordo com Maria Cristina de Sousa Paula, diretora da Colônia Z-8 de Pescadores, o festejo se mantém fiel à tradição inicial dos anos 30. Uma das poucas mudanças registradas foi a redução no número de embarcações na procissão, visto que há novas regras impostas pela Marinha. "Antes, eram mais embarcações e barcos com mais pessoas. Por conta da segurança, hoje só é permitido que
vá a tripulação, e se outras pessoas quiserem participar elas precisam ir numa embarcação apropriada", explica.
Mas é justamente a tradição que torna a festa tão importante para os pescadores e para a história da Cidade. "É um momento de uma importância muito grande, pois é o Dia do Pescador, o dia de celebrar essa classe tão importante para Fortaleza. Sendo patrimônio, ninguém poderá chegar e transformá-la em outra coisa; ninguém vai poder tirar o foco da fé do pescador", completa Maria Cristina.
Já a igreja, que pode não chamar atenção aos olhos pela composição arquitetônica, se torna grandiosa por ser símbolo da resistência dos pescadores e, também, marco histórico da formação da Capital. “O Mucuripe nasceu naquela região, e há quem diga que Fortaleza também”, destaca Graça Martins. “A Festa de São Pedro fala muito sobre nós de um ponto de vista social, conta muito a nossa história”.

39 PATRIMÔNIO IMATERIAL
THIAGO MATINE/SECULTFOR
FARMÁCIA OSWALDO CRUZ
Fundada em 1934, a Drogaria e Farmácia Oswaldo Cruz foi a primeira farmácia de manipulação do Ceará e segue em pleno funcionamento até hoje. Localizada na rua Major Facundo, 576, em frente a Praça do Ferreira, no Centro, ela está inscrita no livro de registros de Lugares da Secultfor desde 21 de dezembro de 2012.

Na Capital, a farmácia é o único Patrimônio Imaterial que não está ligado diretamente a uma manifestação cultural ou religiosa coletiva. Segundo Graça Martins, o espaço, que também é tombado como Patrimônio Histórico de Fortaleza, se tornou também Patrimônio Ima-
terial pelas vivências e práticas de manipulação que ali ocorrem há quase um século, reafirmando seu valor não só arquitetônico, mas cultural.
O registro foi feito via decreto e, por isso, o plano de salvaguarda não foi feito durante o processo, mas a pesquisa para elaborá-lo está em andamento e deve incluir ações junto a escolas, como visitas e palestras, para que as próximas gerações conheçam e entendam o contexto e relevância histórica do local. A ideia é incluir o espaço, já conhecido por muitos fortalezenses, no roteiro turístico da Cidade.
Dentre os destaques da farmácia estão a arquitetura eclética do prédio, que mistura elementos de diferentes escolas arquitetônicas e marca um momento de transição, o piso e o mobiliário antigos que foram preservados e a famosa balança onde os clientes se pesam desde meados do século XX.
40 NOSSOS BAIRROS | NOSSA FORTALEZA
Farmácia Oswaldo Cruz é patrimônio Imaterial pelas vivências e práticas de manipulação que ali ocorrem há quase um século
RODRIGO CARVALHO/SECULTFOR
Maracatu está inscrito nos três livros do patrimônio imaterial: Saberes, Celebrações e Formas de Expressão
MARACATU
O maracatu cearense é o único patrimônio imaterial de Fortaleza que consta em três livros: o dos Saberes, o de Celebrações e o de Forma de Expressão. O registro, feito em 23 de março de 2016, engloba todos os grupos da Capital. Aqui, a manifestação tem suas especificidadesainda que algumas delas se estendam a cidades do interior -, como o negrume (tinta preta utilizada no rosto da maioria dos grupos) e a batida do ferro.

No entanto, não só de aspectos estéticos e sonoros únicos é feito o maracatu de Fortaleza. “Não dizemos que a definição do maracatu é uma cara pintada de negra ou a batida do ferro, porque senão estaríamos reduzindo todo
o contexto social, religioso e cultural que ele tem. São características muito fortes, mas há quem não pinte a cara de preto porque diz que a negritude está no sangue, não na pele. Existem algumas tensões que não se resolvem e não devem ser resolvidas porque fazem parte da manifestação”, ressalta Graça Martins.
De acordo com a gerente de patrimônio, há divergências, inclusive, sobre a origem do maracatu. Alguns dizem que ele chegou a Fortaleza em 1936, quando o maracatuzeiro Raimundo Boca Aberta, vindo de Recife, criou o Az de Ouro, primeiro grupo na Capital. Há registros na literatura, porém, que sugerem a existência dos grupos
FERNANDA SIEBRA/SECULTFOR
em um período ainda mais antigo, caso do livro “Coração de Menino”, de Gustavo Barroso.
A verdade é que a história do maracatu continua sendo escrita, ganhando novos elementos e significados que tornam sua relevância cultural ainda mais rica. A priori, os maracatus não estavam publicamente relacionados às religiões de matriz africana, por exemplo - muito por medo da repressão, destaca Graça, que há muitos anos acompanha e pesquisa sobre os grupos.
“Havia muita cautela com a exposição religiosa e hoje isso não é mais necessário e, diferente de antigamente, todo maracatu tem a ala dos orixás”, lembra. Para ela, parte dessa mudança vem da valorização enquanto Patrimônio Imaterial, título que possibilita maior acesso e redução do preconceito religioso por parte da população, já que o registro é uma garantia de continuidade e força do poder público a investir na manifestação.
“Depois que o maracatu foi registrado, temos, além do Dia do Maracatu (25 de março), a lei que institui que ‘Todo dia 25 é dia de maracatu’. Nesses dias, a secretaria sempre leva um grupo para algum lugar da cidade. Além disso, os grupos ganharam um dia a mais de desfile no carnaval, o que traz mais estrutura e destaque”.
Conheça os grupos de Maracatu de Fortaleza
• Maracatu Axé de Oxóssi
• Maracatu Az de Ouro
• Maracatu Filhos de Iemanjá
• Maracatu Nação Baobab
• Maracatu Nação Fortaleza
• Maracatu Nação Iracema
• Maracatu Nação Palmares
• Maracatu Nação Pici
• Maracatu Leão de Ouro
• Maracatu Obalomi
• Maracatu Rei de Paus
• Maracatu Rei do Congo
• Maracatu Rei Zumbi
• Maracatu Solar

• Maracatu Vozes da África
FESTA DE IEMANJÁ
Desde a década de 60, as praias de Fortaleza recebem, no dia 15 de agosto, a Festa de Iemanjá. De início um festejo “escondido” por receio de represálias, mas desde 2013 o evento se divide entre cerca de 9km da Praia do Futuro e um trecho da Praia de Iracema, onde centenas de umbandistas celebram sua fé e outras dezenas de pesquisadores, fotógrafos, estudantes e transeuntes contemplam a beleza do evento religioso.
Inscrita no livro das Celebrações desde 30 de julho de 2018, a manifestação chegou a Fortaleza do Rio de Janeiro por meio de Mãe Júlia Barbosa Condante, criadora da Federação Cearense Espírita de Umbanda, e é celebrada no mesmo dia de Nossa Senhora da Assunção,
42 NOSSOS BAIRROS | NOSSA FORTALEZA
As Praias de Iracema e do Futuro, em Fortaleza, recebem, no dia 15 de agosto, a Festa de Iemanjá

padroeira da Capital. Além do cortejo e de apresentações culturais de maracatus e afoxés, a festa é marcada principalmente pelo momento das oferendas, quando os filhos da Mãe D’água levam ao mar champanhe, flores e outros presentes.
“Para mim, essa é a hora mais bonita da festa”, comenta Graça Martins. Ela relembra as mudanças que o tempo trouxe à festa: “Antes, as pessoas jogavam muitas joias, pentes, brincos, presilhas. Hoje, nada que não é orgânico é jogado das jangadas, e só ficam no mar as flores, o champanhe, as bebidas - o resto volta nos cascos”, conta.
A fartura e a alegria, aliás, são os pontos altos do festejo. É um momento de afeto, troca, dança e valorização da ancestralidade, de muita comida e bebida e de reverên-
cia à força da mulher. Além disso, a festa é a única celebração religiosa e cultural afro-brasileira realizada em espaço público na cidade, lembra Jean dos Anjos, antropólogo e doutorando em Sociologia.
O pesquisador, que é umbandista e coordenou a pesquisa sobre a Festa de Iemanjá de Fortaleza que a registrou como Patrimônio Cultural Imaterial, destaca que a festa vai muito além de um momento religioso. “É relevante porque demonstra que a população que tem fé em Orixá resistiu e resiste bravamente em Fortaleza, apesar de séculos de escravidão, racismos e violências institucionais. A festa diz que em Fortaleza há população negra e de terreiro. É uma celebração afirmativa da nossa ancestralidade africana”.
THIAGO MATINE/SECULTFOR
FESTA DA COROA DO BOM JESUS DOS AFLITOS
Anteriormente conhecida como Festa dos Caboclos ou Chegada dos Caboclos, a Festa da Coroa do Bom Jesus dos Aflitos* ocorre há mais de três séculos e está em processo de registro como Patrimônio Imaterial pela Secultfor. Evento ritualístico que reúne centenas de pessoas todos os anos, a parte principal da festa gira em torno da coroa de espinhos de Jesus, que é levada pelos fiéis da paroquia Bom Jesus dos Aflitos à Igreja Matriz da Parangaba, para uma peregrinação pelas casas do bairro que dura, em sua totalidade, três meses, de meados de setembro ao início de janeiro.
Segundo Graça Martins, uma das responsáveis pela pesquisa de registro do festejo, a Festa da Coroa começou quando os padres jesuítas levavam a coroa de Cristo até os povos indígenas como parte do processo de catequização, no aldeamento da Porangaba, hoje Parangaba.
“Na época, o Marquês de Pombal queria fazer o que ele chamava de ‘cruzamento’, ou seja, casar índios e brancos. Todo filho que nascia desse ‘cruzamento’ era chamado caboclo, e essa festa era deles. Eles desciam de muito longe, andavam não sei quantos dias para trazer essa coroa para a igreja”, explica.
O padre Antonio Gomes de Pontes Neto, pároco da Paróquia de Bom Jesus dos Aflitos de Parangaba, conta que a principal mudança na festa ocorreu no início da década de 80, quando "a condução da coroa peregrina pelas casas dos fiéis e fora do território da área da Paróquia deixou de ser missão dos caboclos e ficou limitada à passagem pelo espaço territorial determinado pela Arquidiocese de Fortaleza". Desde então, um grupo de membros de pastorais da Paróquia se encarrega da condução da coroa pelas casas e capelas da área paroquial.
Até hoje, a festa cristã da Parangaba segue forte como uma festa ritualística tradicional da região, e mais de 1.500 pessoas participam dos eventos. Atualmente, ela ocorre da seguinte forma: no segundo domingo de setembro, ao fim da missa, o pároco sobe no altar e retira a coroa da imagem de Jesus da Igreja Matriz. Após a descida, ela é guardada dentro de um recipiente especial e faz a peregrinação por casas e paróquias do bairro, onde ocorrem orações e são servidas refeições para a comunidade. No dia 23 de dezembro, a coroa retorna em uma procissão da Igreja Matriz de São José de Vila Pery para o início da novena na Igreja Matriz de Bom Jesus dos Aflitos. Nos dias que se seguem, há um novenário, a celebração do Dia do Senhor Bom Jesus dos Aflitos (1º de janeiro) e o retorno da coroa à imagem no Dia de Reis (6 de janeiro).
Para o padre Antonio Neto, a festa ressalta aspectos cristãos como reconciliação, perdão, cultura de paz, combate à intolerância e à violência e o respeito às diferenças, “uma vez que a peregrinação da coroa no seu início visava garantir um tempo de pacificação dos conflitos entre as diferentes etnias de tribos indígenas existentes”. Por isso, ressalta o pároco, a transformação do evento em patrimônio se faz relevante para a Capital.
“O reconhecimento ajudará na adoção dessa Festa por parte do Estado e do Município como evento dentro do calendário cultural e do turismo religioso, atraindo mais parcerias privadas e do poder público para o desenvolvimento do bairro em meio aos seus desafios”, diz o padre.
*Durante a produção deste livro, a Festa da Coroa estava em processo de inventário para registro como Patrimônio Imaterial. Os dados referentes a esta manifestação e ao status do processo foram coletados em outubro de 2022.
44 NOSSOS BAIRROS | NOSSA FORTALEZA

THIAGO MATINE/SECULTFOR
A Festa de Iemanjá é um momento de afeto, troca, dança e valorização da ancestralidade, além de reverência à força da mulher
CÂMARA MUNICIPAL DE FORTALEZA

Apresentamos a relevância da Câmara Municipal na gestão e desenvolvimento da Capital de Fortaleza. Quem são os vereadores eleitos e de que forma eles atuam na garantia dos interesses da população




























 Prédio da Câmara Municipal de Fortaleza no Luciano Cavalcante
Prédio da Câmara Municipal de Fortaleza no Luciano Cavalcante


























O PAPEL DA CÂMARA
A Câmara Municipal de Fortaleza tem em primeiro plano a função de representar os diversos segmentos e setores da sociedade. “A Câmara deverá produzir as leis e demais normas jurídicas que irão regular a vida em sociedade da população, observando os limites de atuação definidos na Constituição Federal e as normas locais de interesse da comunidade. Dentre essas normas, destaca-se a Lei Orgânica do Município, que assume ares de Constituição municipal, e a Lei Orçamentária Anual (LOA), que tem a função de disciplinar a utilização dos recursos financeiros do município”, conforme registrado no site oficial do órgão.

Para reproduzir a diversidade de interesses, valores e ideologias da população da Cidade, os vereadores são escolhidos pelo povo em votação direta. Em Fortaleza, são eleitos 43 vereadores que têm o poder de ouvir o que os eleitores querem, propor e aprovar esses
pedidos na Câmara Municipal e fiscalizar as ações do Poder Executivo em relação a essas demandas.
Ao vereador cabe elaborar as leis municipais e fiscalizar a atuação do Executivo – o prefeito. São os vereadores que propõem, discutem e aprovam as leis a serem aplicadas no município. Pela LOA, os vereadores acompanham os investimentos a serem feitos pela Prefeitura na cidade durante cada ano e podem fazer adequações a essas leis. Essa fiscalização representa um grande serviço à comunidade, pois, em última instância, significa garantir a correta utilização dos recursos financeiros pertencentes à população — ou seja, zelar e cuidar do patrimônio público.
Além dessas atribuições, as câmaras municipais exercem uma série de ações indispensáveis na interação com a sociedade, muitas delas de forma combinada com as funções legislativa e fiscalizadora.
 Sede da Câmara Municipal de Fortaleza está localizada no bairro Luciano Cavalcante
Sede da Câmara Municipal de Fortaleza está localizada no bairro Luciano Cavalcante
48 NOSSOS BAIRROS | NOSSA FORTALEZA
FERNANDA BARROS
VEREADORES
PRESIDENTE ANTÔNIO HENRIQUE*
Formado em Administração pela Faculdade Integrada do Ceará (FIC), é natural de Martins, no Rio Grande do Norte. Está em seu 4º mandato consecutivo. Foi eleito presidente da Câmara Municipal de Fortaleza em 2019 e foi reconduzido ao cargo em 2021. À frente do Poder Legislativo Municipal, realizou o primeiro concurso público da Casa e implementou os projetos “Infância Protegida” e o Movimento Vidas. Desde 2020, é o representante da Câmara no Comitê Municipal de Enfrentamento ao Coronavírus.

Partido: PDT
Aniversário: 24/7
Mandato: 4º (2009-2024)
Profissão: administrador
Votos na última
eleição: 15.480
Gabinete: presidência
Telefone: (85) 3444.8376
E-mail: vereadorantonio henrique@cmfor.ce.gov.br
Facebook: facebook.com/
antoniohenrique.oficial/
IG: @antoniohenrique.oficial
*Eleito em 2022 para deputado estadual
ADAIL JUNIOR
Natural de Saboeiro (CE), é formado em Ciências Contábeis pela Universidade de Fortaleza (Unifor) e atua no comércio. Ingressou na política em 2008 pelo Partido Republicano Progressista (PRP). Ainda em 2008, foi eleito vereador pela primeira vez e assumiu como 1º vice-presidente da Casa. Para o segundo mandato, em 2012, foi eleito pelo Partido Verde (PV), atuando como 2° vice-presidente da CMFor. Em 2020, foi reeleito (PDT) e, também, reeleito como 1º vice-presidente da Casa para o biênio 2021-2022.

Partido: PDT
Aniversário: 29/1
Mandato: 4º (2009-2024)
Profissões: comerciante e contador
Votos na última
eleição: 14.005
Gabinete: 35
Telefone: (85) 3444 8366 / 34448438
E-mail: adail.junior@ vereador.cmfor.ce.gov.br



Facebook: facebook.com/ adail.junior.73
IG: @vereadoradailjr
ADRIANA NOSSA CARA
Em 2020, a fortalezense
Adriana foi eleita vereadora com a proposta de ‘mandata coletiva’ “Nossa Cara” e declara dividir seu mandato com a artista Lila
M. Salur e a professora Louise Santana. É formada em Serviço Social pela Faculdade Cearense (FaC). Adriana é cofundadora da FavelAfro, cooperativa de mulheres periféricas do Lagamar. Integra o Grupo Jovens em Busca de Deus (JBD), a Frente de Luta por Moradia Digna, o Campo Popular do Plano Diretor e o Fórum Popular de Segurança Pública.

Partido: PSOL
Aniversário: 2/2
Mandato: 1º (2021-2024)
Profissão: assistente social Votos na última
eleição: 9.824
Gabinete: 2
Telefone: (85) 3444 8412
E-mail: nossacara2020
@gmail.com
Facebook: facebook.com/
nossacara2020
IG: @nossacaramandata
Twitter: @nossacarapsol
ANA ARACAPÉ
Natural de Itapajé (CE), Ana Maria é formada em Pedagogia pela Universidade Estadual Vale do Acaraú (UVA). Foi coordenadora educacional, diretora de escola infantil e fundamental e, também, presidente da Associação dos Moradores do Aracapé (ACA). Assumiu o cargo de vereadora como suplente em 2014 e 2019. Em 2020, foi eleita, quando assumiu cadeira na Câmara na 18ª Legislatura. Foi autora do Projeto que sugere a criação do “Programa de Auxílio Psicológico às Mulheres Vítimas de Crimes de Violência Sexual”.
Partido: PL
Aniversário: 12/4
Mandato: 1º (2021-2024)
Profissão: pedagoga
Votos na última
eleição: 5.922
Gabinete: 39
Telefone: (85) 3444 8363
E-mail: vereadoraana aracape@cmfor.ce.gov.br
Facebook: facebook.com/ anamariateixeiramatos.sousa
IG: @anaaracapeoficial
49 VEREADORES
BRUNO MESQUITA
O fortalezense é formado em Jornalismo pela Faculdade Integrada do Ceará (FIC). Na Câmara Municipal de Fortaleza (CMFor) e na Assembleia Legislativa do Estado Ceará (AL-CE) exerceu a função de chefe de gabinete do ex-vereador e ex-deputado estadual Roberto Mesquita. Bruno Mesquita tem forte atuação nas comunidades dos bairros Riacho Doce, Panamericano, Bela Vista, Demócrito Rocha, Couto Fernandes, Rodolfo Teófilo, Parquelândia e Grande Itaperi. No seu mandato pretende fiscalizar e acompanhar a execução do Bolsa Atleta, um projeto muito importante para os jovens em situação de vulnerabilidade social da periferia de Fortaleza.

Partido: PROS
Aniversário: 26/3
Mandato: 1º (2021-2024)
Profissão: jornalista
Votos na última eleição:
6.099
Gabinete: 15
Telefone: (85) 3444-8379
E-mail:
brunofernandesmota@bol. com.br
Facebook: facebook. com/bruno.
fernandesmota.7
IG: @vereadorbruno mesquita
CARMELO NETO*
Carmelo Silveira Carneiro Leão Neto nasceu em Fortaleza em 2001. Estudante de Direito e defensor de pautas conservadoras, integra o Conselho Nacional de Juventude do governo Jair Bolsonaro. Está no primeiro mandato como vereador de Fortaleza, eleito com 8.527 votos.



Partido: REPUBLICANOS
Aniversário: 15/9
Mandato: 1º (2021-2024)
Profissão: estudante
Votos na última eleição:
8.527
Gabinete: 42
Telefone: (85) 3444 8410
E-mail: carmeloleao03@ hotmail.com
Facebook: facebook.com/ carmelonetobr
IG: @carmeloneto
*Eleito em 2022 para deputado estadual
CLAUDIA GOMES
A fortalezense é fisioterapeuta e engenheira civil, ambas as graduações pela Universidade de Fortaleza (Unifor), mestra em Educação em Saúde, também pela Unifor, e professora universitária. Ingressou na vida pública em 2013. Foi reeleita nos pleitos de 2016 e 2020 e está em seu terceiro mandato. Presidiu a Frente Parlamentar em Defesa dos Direitos dos Animais, foi vice-presidente da Comissão de Saúde da Câmara Municipal e membro da Comissão do Meio Ambiente. Atualmente está no PSDB. Defende as causas da acessibilidade, defesa dos animais, meio ambiente, saúde e proteção da mulher.
Partido: PSDB
Aniversário: 10/8
Mandato: 3º (2013-2016, 2017-2020 e 2021-2024)
Profissões: engenheira civil, fisioterapeuta e professora universitária
Votos na última eleição: 8.625
Gabinete: 18
Telefone: (85) 3444 8351
E-mail: reginaclaudiagomes oficial@gmail.com
Facebook: www.facebook. com/Claudia.Gomes. Vereadora
IG: @claudinhagomesver
CÔNSUL DO POVO
Nascido em Pernambuco, reside há mais de 20 anos em Fortaleza. É empresário de transporte e logística e cursa Direito na Faculdade Estácio. Sempre foi atuante em ações sociais, contribuindo com doações e melhorias de infraestrutura tanto para as periferias do entorno de sua residência, no Porto das Dunas, quanto para as comunidades religiosas e os profissionais que atuam na segurança pública. Já atuou em comunidades como Cofeco, Abreulândia, Jardim dos Ventos I e II, Gereberaba, Beco da Bomba, Lagoa da Precabura e Lagoa da Sabiaguaba. No período da pandemia ajudou também as comunidades do Pirambu, Granja Lisboa, Henrique Jorge, Conj. Ceará, Bom Jardim, Curva da Viúva, José Walter, Orgulho do Ceará, entre outros.
Partido: PSDB
Aniversário: 28/1
Mandato: 1º (2021-2024)

Profissão: empresário
Votos na última eleição: 4.028
Gabinete: 4
Telefone: (85) 3444-8408
E-mail:
Facebook: facebook.com/ consul.erivaldoxavier
IG: @consuldopovo
50 NOSSOS BAIRROS | NOSSA FORTALEZA
DANILO LOPES
Nascido em Fortaleza, Danilo é formado em Odontologia pela Universidade Federal do Ceará (UFC) e Educação Física pela Universidade de Fortaleza (Unifor). Tem, ainda, pós-doutorado na Instituição de Ensino CHU-Rouen Hôpital Saint-Julien, na França. É professor e pesquisador de duas Universidades em Fortaleza, onde leciona em dois Programas de Mestrado.
Em 2020, foi eleito pela primeira vez como vereador de Fortaleza. Afirma que sua missão como parlamentar é trabalhar para que a população de Fortaleza tenha acesso à saúde e educação de qualidade, cultura, desenvolvimento econômico e oferta de emprego e renda.
Partido: Avante
Aniversário: 29/6
Mandato: 1º (2021-2024)
Profissões: dentista, profissional de educação física e professor universitário

Votos na última eleição:
3.782
Gabinete: 16
Telefone: (85) 3444-8360
E-mail: lubbos@uol.com.br
Facebook: facebook.com/ danilo.lubbos
IG: @danilo_lopesoficial
DOUTOR ELPÍDIO

Elpídio Nogueira Moreira é natural de Acopiara (CE). Médico formado pela Universidade Federal do Ceará (UFC), cursou Administração Hospitalar e pós-graduação pela Unifor, em Medicina do Trabalho; Gestão Hospitalar, pela UFC; Administração de Recursos Humanos, pela Uece; e Ultrassonografia pela Clínica Diagnosis, em Ribeirão Preto (SP). Seu primeiro mandato ocorreu no ano de 1996 e desde então vem sendo reconduzido a ocupar uma cadeira do Legislativo Municipal. Como médico renomado em Fortaleza na área da ginecologia, Elpídio Nogueira enfatiza a necessidade de priorizar, na área da saúde, os ajustes necessários dos equipamentos já existentes na procura de melhorar o atendimento para a população de Fortaleza.
Partido: PDT
Aniversário: 30 de julho
Mandato: 7º
Profissão: Médico
Votos na última eleição:
9.529 votos
Gabinete: 12
Telefone: (85) 3444 8319
E-mail: enmoreira@



hotmail.com
Facebook: facebook/
drelpidionogueira
IG: @drelpidionogueira
DR. LUCIANO GIRÃO


O fortalezense é formado em Direito pelo Centro Universitário Christus (Unichristus) e é estudante de Ciências Atuariais. Foi vice-prefeito de Maranguape entre os anos de 2013 e 2016, além de secretário municipal de Turismo, Esporte e Cultura da cidade, localizada na Região Metropolitana de Fortaleza (RMF), entre 2017 e 2020. Atuou no bairro Sapiranga prestando assistência jurídica à comunidade. Atualmente, está no primeiro mandato na Câmara Municipal de Fortaleza (CMFor).

Partido: PP
Aniversário: 15/3
Mandato: 1º (2021-2024)
Profissão: advogado
Votos na última eleição:
9.857
Gabinete: 10

Telefone: (85) 3444-8362
E-mail: luciano_girao@ hotmail.com


Facebook: facebook.com/ Dr-Luciano-Girao
IG: @dr.lucianogirao
EMANUEL ACRÍZIO
Emanuel Acrízio de Freitas é natural de Itarema (CE). Aos 10 anos mudou-se para Fortaleza. Ainda jovem, foi eleito presidente do Grêmio Estudantil da Escola José Maria Campos de Oliveira (UV8), no Conjunto Ceará. Atuou como sócio-educador no Centro Educacional Dom Bosco. Foi eleito Conselheiro Tutelar em 2008 e reeleito em 2012. É técnico em contabilidade e formado em Administração. Em 2014, assumiu o cargo de secretário de Esporte do Governo do Ceará. Foi eleito vereador em 2016, pelo Partido Republicano Progressista (PRP). Em 2020, filiou-se ao Partido Progressista (PP), pelo qual foi reeleito vereador.
Partido: Progressistas
Aniversário: 11/8
Mandato: 2º (2017-2020 e 2021-2024)
Profissão: técnico em contabilidade
Votos na última eleição: 11.371
Gabinete: 40
Telefone: (85) 3444 8370
E-mail: ver. emanuelacrizio@gmail. com
Facebook: facebook.com/ VereadorEmanuelAcrizio
IG: @ vereadoremanuelacrizio
51 VEREADORES
ENFERMEIRA ANA PAULA
Ana Paula Brandão da Silva Farias nasceu em Fortaleza. É formada em Enfermagem pelo Centro Universitário Unifametro, com especialização em Gestão Hospitalar. Atuou na gestão de Unidades Básicas de Saúde (UBS). É fundadora da Associação dos Enfermeiros do Ceará (Assec) e, de 2018 a 2020, presidiu o Conselho Regional de Enfermagem do Ceará (Coren-CE). Foi a primeira enfermeira eleita para o cargo de vereadora na Capital. Ana Paula também é presidente licenciada do Conselho Regional de Enfermagem do Ceará e coordenadora de pós-graduações da Faculdade IDE. Compõe a mesa diretora da Câmara Municipal como 2ª vicepresidente.


Partido: PDT
Aniversário: 17/11
Mandato: 1º (2021-2024)
Profissão: enfermeira
Votos na última eleição: 10.097

Gabinete: 9
Telefone: (85) 3444 8305
E-mail: imprensa. enfermeiraanapaula @gmail.com
Facebook: facebook.com/ enfermeiraanapaula
brandao
IG: @enfermeiraanapaula
ESTRELA BARROS
Estrela Barros nasceu em Fortaleza, em 1972. É graduada em Serviço Social pela Universidade Paulista (Unip). Moradora do Grande Pirambu, atuou como técnica na Secretaria Regional Centro, no Centro de Referência e Assistência Social (CRAS) do bairro Bela Vista e em ações sociais voltadas à saúde. Está no primeiro mandato na Câmara Municipal de Fortaleza (CMFor).
Partido: REDE
Aniversário: 6/8
Mandato: 1º (2021-2024)
Profissão: assistente social Votos na última
eleição: 4.928
Gabinete: 14
Telefone: (85) 3444 8370
E-mail: vereadoraestrel
abarros@cmfor.ce.gov.
br / estrelabarros2008@ hotmail.com
Facebook: facebook.com/ estrelavereadora
IG: @estrelabarrosvereadora
EUDES BRINGEL

Francisco Eudes Ferreira Bringel nasceu em Fortaleza, em 1972. É vicepresidente da Federação Cearense de Futebol (FCF). Exerceu a função de assessor parlamentar do deputado estadual e atual presidente da Assembleia Legislativa do Ceará (Alece), Evandro Leitão. Trabalhou também na gestão da Saúde Pública e na Secretaria de Desenvolvimento Social do Ceará (SDS). Está no primeiro mandato na Câmara Municipal de Fortaleza (CMFor), onde ocupa cargo na mesa diretora como 3º vice-presidente.
Partido: PSB
Aniversário: 4/5
Mandato: 1º (2021-2024)
Profissão: estudante universitário
Votos na última
eleição: 5.780
Gabinete: 43
Telefone: (85) 3444 8349
E-mail: eudesbringel@ hotmail.com
Facebook: facebook.com/ eudesbringel
IG: @eudesbringel
FÁBIO RUBENS
Fábio Rubens Marques Ramos nasceu em Fortaleza, em 1973. Atua como liderança comunitária dos bairros José Walter, Planalto Ayrton Senna, Mondubim, Itaperi e Marcos Freire. Antes de entrar para a vida política trabalhou como garçom e no setor de eventos. Foi candidato a vereador de Fortaleza pela primeira vez em 2004. Em 2018, assumiu o mandato por quatro meses como suplente e, em 2020, foi eleito para a Câmara Municipal de Fortaleza (CMFor) pelo Partido Socialista Brasileiro (PSB).
Partido: PSB
Aniversário: 9/4
Mandato: 1º (2021-2024)
Profissão: autônomo
Votos na última
eleição: 6.819

Gabinete: 19
Telefone: (85) 3444 8321
E-mail: fabiorubens
vereador@hotmail.com
Facebook: facebook.com/ fabio.rubens.96
IG: @fabiorubensvereador
52 NOSSOS BAIRROS | NOSSA FORTALEZA
GABRIEL AGUIAR

Gabriel Lima de Aguiar nasceu em Fortaleza. É formado em Biologia e tem mestrado em Ecologia e Recursos Naturais pela Universidade Federal do Ceará (UFC), com pesquisa sobre o Parque Estadual do Cocó. Atua em conselhos gestores de unidades de conservação e integra o Fórum Permanente pela Implantação do Cocó no Ministério Público Federal. Atuou na Câmara de São Gonçalo do Amarante como técnico na Comissão Especial do Meio Ambiente, onde conquistou o prêmio TCE Ceará Sustentável pelo trabalho desenvolvido no Plano de Logística e Sustentabilidade da Câmara. Está no primeiro mandato na CMFor. Integra as comissões de Política Urbana e Meio Ambiente e possui cadeira na Comissão de Cultura, Esporte e Juventude.


Partido: PSOL
Aniversário: 19/3
Mandato: 1º (2021-2024)
Profissão: biólogo
Votos na última
eleição: 9.888
Gabinete: 8
Telefone: (85) 3444 8445
E-mail: gabinetegabriel aguiar@gmail.com
Facebook: facebook.com/
gabriel.l.deaguiar
IG: @gabrielbiologia
GARDEL ROLIM
Graduado em Fisioterapia pela Faculdade Integrada do Ceará (atual Centro Universitário Estácio do Ceará) e pós-graduado em Gestão Hospitalar, trabalhou na área de saúde pública no Instituto Doutor José Frota (IJF), nos Frotinhas e no Instituto de Saúde e Gestão Hospitalar (ISGH). Coordenou a implantação do Hospital Regional Norte (HRN) e a área de apoio da atenção primária de Fortaleza. Integrou a mesa diretora como 3º vice-presidente no biênio 2019-2020. É o atual líder do Governo na Câmara Municipal de Fortaleza. Atuou para a realização do primeiro concurso público exclusivamente para a saúde mental na gestão do prefeito Roberto Cláudio (PDT).
Partido: PDT
Aniversário: 12/5
Mandato: 2º (2017-2020 e 2021-2024)
Profissão: fisioterapeuta Votos na última
eleição: 11.552
Gabinete: 13
Telefone: (85) 3444 8306 / 98974 0042
E-mail: gardelrolim@ gmail.com / comunicacao. gardelrolim@gmail.com
Facebook: facebook.com/ GardelRolimOficial
IG: @gardelrolim
GERMANO HE-MAN
João Germano Medeiros nasceu em Fortaleza em 1985, tem o ensino médio completo e é comerciante. Está em seu primeiro mandato na Câmara Municipal de Fortaleza (CMFor), é filiado ao Partido da Mulher Brasileira (PMB) e foi eleito, no último pleito, com 3.157 votos. Sua atuação é voltada para os bairros Montese, Vila União e na região da Lagoa do Opaia.

Partido: PMB
Aniversário: 12/1
Mandato: 1º (2021-2024)
Profissão: comerciante
Votos na última
eleição: 3.157
Gabinete: 23
Telefone: (85) 3444 8371
E-mail: vereadorgermano heman@cmfor.ce.gov.br Facebook: facebook.com/ germano.heman IG: @germanoheman
GUILHERME SAMPAIO
Guilherme de Figueiredo Sampaio é natural de Fortaleza. Formado em Ciências Contábeis pela Universidade Federal do Ceará (UFC), pós-graduado em Administração de Recursos Humanos pela Universidade de Mogi das Cruzes (UMC) e mestrando em Ciências Políticas na Universidade de Lisboa (ULisboa). Antes de entrar para a vida pública, Guilherme atuava como educador. No fim de 2014, deixou a Câmara Municipal de Fortaleza (CMFor) para assumir a Secretaria da Cultura do Estado, onde permaneceu até fevereiro de 2016.
É o atual presidente do diretório municipal do PT. Atualmente integra a mesa diretora como 2° secretário.
Partido: PT
Aniversário: 16/12
Mandato: 5º (2005-2008, 2009-2012, 2013-2016, 2017-2020 e 2021-2024)
Profissões: educador e empresário
Votos na última
eleição: 5.816
Gabinete: 36
Telefone: (85) 3444 8372
E-mail: contato guilherme


sampaio@gmail.com
Facebook: facebook.com/
GuilhermeSampaio13
IG: @verguilherme
53 VEREADORES
INSPETOR ALBERTO
José Alberto Bastos

Vieira Júnior nasceu em Fortaleza, em 1961. É policial civil aposentado, atuando na área da Segurança Pública por 30 anos. Desempenhou sua função na cidade de Aquiraz e lá concorreu algumas vezes a cargos públicos. Ligado às pautas conservadoras, é apoiador do governo Jair Bolsonaro e está no primeiro mandato na Câmara Municipal de Fortaleza, eleito com 7.301 votos. Quando atuava no serviço público, o vereador fez parte de um projeto dentro da Polícia Civil chamado de unificação das polícias, que possibilita que policiais militares operem em conjunto com os policiais civis nas delegacias.
Partido: PL
Aniversário: 20/1
Mandato: 1º (2021-2024)
Profissão: policial civil aposentado
Votos na última
eleição: 7.301
Gabinete: 41
Telefone: (85) 99284 5652
/ (85) 3444 8302
E-mail: inspetor.alberto@ hotmail.com
Facebook: facebook.com/ alberto.inspetoralberto
IG: @inspetoralberto
JORGE PINHEIRO
Jorge Pinheiro é bacharel em Direito pela Universidade de Fortaleza (Unifor), especialista em Execução Penal e Direito Canônico e membro da Sociedade Brasileira de Canonistas. Foi eleito para o segundo mandato como vereador. Na Câmara Municipal, presidiu a Comissão de Educação, Ciência, Tecnologia e Inovação (2017-2018), e foi membro da Comissão de Constituição e Justiça (CCJ) por dois biênios (2017-2020). É membro consagrado da Comunidade Católica Shalom. É contra a legalização e a prática do aborto. Em 2020, saiu do Democracia Cristã (DC) e foi para o Partido da Social Democracia Brasileira (PSDB).
Partido: PSDB
Aniversário: 1º/5
Mandato: 2º (2017-2020 e 2021-2024)
Profissão: advogado
Votos na última
eleição: 8.319
Gabinete: 6
Telefone: (85) 3444 8361
E-mail: vereadorjorgepinheiro@ cmfor.ce.gov.br / secretariajorgepinheiro@ gmail.com
Facebook: facebook.com/
jorgepinheirooficial
IG: @jorgepinheirooficial
JOSÉ FREIRE
Natural de Quixadá (CE), reside na Capital cearense desde 1968, onde iniciou atividades no comércio e na política. Começou sua trajetória política em 2004, quando se candidatou a vereador, mas não se elegeu. Em 2008, candidatou-se novamente ao cargo e foi eleito pela primeira vez. Em 2012, candidatou-se, porém não foi eleito. Em 2016, candidatou-se mais uma vez e voltou a ser eleito para exercer o mandato atual. Em 2020, deixou o Patriota e migrou para o Partido Social Democrático (PSD). É empresário no setor de transporte de cargas. Na composição da mesa diretora da Câmara Municipal de Fortaleza no biênio 2021-2022, o parlamentar ocupa a função de 2° suplente.



Partido: PSD
Aniversário: 19/11
Mandato: 3º (2009-2012, 2017-2020 e 2021-2024)
Profissão: empresário
Votos na última
eleição: 6.277

Gabinete: 21
Telefone: (85) 3444 8347
E-mail: vereador josefreire@gmail.com
Facebook: facebook.com/ verjose.freire
IG: @vereadorjosefreire
JULIERME SENA
Julierme Lima de Sena é natural de Fortaleza e cresceu no bairro Jacarecanga. É formado em Ciências Contábeis pela Universidade Estadual do Ceará (Uece) e inspetor da Polícia Civil há mais de dez anos. Em 2019, foi eleito vice-presidente do Sindicato dos Policiais Civis do Estado do Ceará. Está no segundo mandato como vereador de Fortaleza, reeleito com 7.145 votos, e atualmente ocupa o cargo de 1° secretário da Mesa Diretora da Câmara Municipal de Fortaleza.
Partido: Pros
Aniversário: 2/12
Mandato: 2º (2017-2020 e 2021-2024)
Profissão: policial civil Votos na última
eleição: 7.145
Gabinete: 26
Telefone: (85) 3444 8374
E-mail: julierme comunicacao@gmail.com
Facebook: facebook.com/ juliermesenaoficial
IG: @juliermesena
54 NOSSOS BAIRROS | NOSSA FORTALEZA
JULIO BRIZZI
Júlio Brizzi Neto nasceu em Fortaleza, em 1982. Advogado, formado pela Universidade Federal do Ceará (UFC), integrou o Diretório Central dos Estudantes (DCE) e coordenou a Associação dos Jovens Empresários de Fortaleza (AJE). Foi Secretário-Executivo do Esporte do Ceará, Secretário-Adjunto da Secretaria do Trabalho e Desenvolvimento Social do Ceará (STDS) e Coordenador de Políticas Públicas de Juventude da Prefeitura de Fortaleza (CEPPJ). Está no primeiro mandato na Câmara Municipal, eleito com 16.424 votos.
Partido: PDT
Aniversário: 15/12
Mandato: 1º (2021-2024)
Profissão: advogado Votos na última eleição: 16.424
Gabinete: 12
Telefone: (85) 98650 3901
E-mail: contato@ juliobrizzi.com.br
IG: @juliobrizzi
KÁTIA RODRIGUES
Katia Maria Rodrigues de Sousa nasceu em Fortaleza, em 1964. Formada em Serviço Social pela Universidade Paulista (Unip), atuou como chefe de ações programáticas da Regional VI, foi coordenadora do Posto de Saúde João


Hipólito de Azevedo e Sá, no Dias Macedo, além de chefe de serviços urbanos da Regional II, articuladora da Célula de Participação Social (CEPS) na Regional III e conselheira tutelar por dois mandatos. Assumiu vaga na Câmara Municipal como suplente em 2020, ano em que foi eleita pela primeira vez como vereadora de Fortaleza com 3.711 votos. Atualmente é a 3° secretária da Câmara Municipal.
Partido: CIDADANIA
Aniversário: 10/11
Mandato: 1º (2021-2024)
Profissão: assistente social
Votos na última eleição: 3.711
Gabinete: 29
Telefone: (85) 3444 8354
E-mail: krodriguesdesousa326@ gmail.com
Facebook: facebook.com/ katia.rodrigues.3745496
Instagram: @ katiarodriguesvereadora
Twitter: twitter.com/ KatiaVereadora
LARISSA GASPAR*
É advogada, servidora pública municipal, capoeirista, definese como militante feminista e defensora dos direitos humanos. Foi Coordenadora da Casa Abrigo Margarida Alves, que acolhe mulheres em iminente risco de morte, e Coordenadora de Políticas para as Mulheres da Prefeitura de Fortaleza. Em seu primeiro mandato como vereadora de Fortaleza, presidiu a Comissão de Direitos Humanos por dois biênios e as Frentes Parlamentares em Defesa da Cidadania das Pessoas em Situação de Rua e da População LGBTQIA+. Tem ainda atuação na defesa da moradia, meio ambiente e transporte coletivo.
Partido: PT
Aniversário: 29/8
Mandato: 2º (2017-2020 e 2021-2024)
Profissão: fiscal de controle urbano
Votos na última
eleição: 8.555
Gabinete: 20
Telefone: (85) 3444 8309
E-mail: contato@ larissagaspar.com.br
Facebook: bit.ly/
larissagaspar
IG: @larissagaspar_oficial
*Eleita em 2022 para deputada estadual
LÉO COUTO
Leonardo Sales Couto Bezerra nasceu em Fortaleza, em 1981. É formado em Administração e empresário do ramo imobiliário. Em 2016, foi assessor na Prefeitura de São Gonçalo do Amarante (CE) e, em 2018, atuou na Casa Civil do Governo do Ceará, ao lado do governador Camilo Santana (PT). Atualmente, exerce a função de Presidente Municipal do PSB e está em seu primeiro mandato como vereador de Fortaleza.


Partido: PSB
Aniversário: 10/1
Mandato: 1º (2021-2024)

Profissão: empresário
Votos na última
eleição: 9.426
Gabinete: 11

Telefone: (85) 3444 8301
E-mail: vereador leocouto@gmail.com
Facebook: facebook.com/ leocoutooficial
IG: @leocoutobezerra
55 VEREADORES
LÚCIO BRUNO
Lúcio Albuquerque Bruno Figueiredo nasceu em Fortaleza, em 1970. É formado em Administração pela Estácio/FIC e pósgraduado em Gestão Pública na mesma Instituição. Atuou como analista de crédito do Profitec, na Regional VI, e foi chefe do núcleo de Geração de Emprego e Renda na Secretaria de Desenvolvimento Econômico (SDE). Foi assessor técnico na Prefeitura de Fortaleza e coordenador da Defesa Civil. Na última gestão do prefeito Roberto Cláudio (PDT), foi coordenadorespecial de Articulação Politica. Está no primeiro mandato como vereador de Fortaleza.
Partido: PDT
Aniversário: 15/12
Mandato: 1º (2021-2024)
Profissão: administrador
Votos na última
eleição: 23.936
Gabinete: 24
Telefone: (85) 3444 8373
E-mail: luciobruno @gmail.com
Facebook: facebook.com/ lucio.bruno.50
IG: @luciobrunooficial
MARCELO LEMOS
Graduado em Gestão Pública pela Universidade Metodista de São Paulo (Umesp) e em Administração pela Faculdade Kurios (Fak). Trabalhou como assessor parlamentar na Assembleia Legislativa, articulador político na Prefeitura de Caucaia (CE) e chefe de gabinete na Câmara Municipal de Fortaleza (CMFor). Foi secretárioexecutivo da Regional V e está em seu segundo mandato como vereador.


Partido: PSL
Aniversário: 3/2
Mandato: 2º (2017-2020 e 2021-2024)
Profissão: administrador
Votos na última
eleição: 5.831
Gabinete: 38
Telefone: (85) 3444 8327
E-mail: marcelolemos vereador@gmail.com
Facebook: facebook.com/ VereadorMarceloLemos
IG: @marcelolemospsl
MÁRCIO MARTINS


Vice-líder do Partido Republicano da Ordem Social (Pros) e líder da bancada de oposição na Câmara, é vicepresidente da Federação das Quadrilhas Juninas do Ceará (Fequajuce) e vice-presidente da União Nordestina de Entidades Juninas (Unej). Criou a Lei do Dia do Torcedor e das Torcidas Organizadas, como também o Dia do Quadrilheiro Junino em Fortaleza. Fundou a Associação de Moradores e Amigos do Jardim América (AAJA) e defende os trabalhadores das categorias de motoristas de transportes por aplicativos, trenzinhos da alegria e som automotivo.
Partido: Pros
Aniversário: 10/2
Mandato: 2º (2017-2020 e 2021-2024)
Profissão: produtor cultural
Votos na última
eleição: 6.944

Gabinete: 17
Telefone: (85) 3444 8359
E-mail: vereador marciomartins@gmail.com Facebook: facebook.com/ vereadormarciomartins
IG: @vereador marciomartins
MICHEL LINS
Michel Lins Cavalcante de Almeida é formado em Publicidade e Propaganda, em Artes Cênicas (Cefet) e é técnico em Cinema de Animação. Esteve à frente da Organização Não Governamental (ONG) Restaurart e foi criador e diretor do Instituto Viva Bairros. Fundou também o projeto Stúdio de Música Popular (SMUP). É presidente municipal do partido Cidadania e foi vice-líder do Governo na Câmara. Na eleição de 2016 foi eleito pelo PPS com 5.275 votos. Foi secretárioexecutivo do projeto Novo Centro da Prefeitura de Fortaleza e conselheiro do Fortur. Atualmente, Michel Lins foi convidado pelo prefeito José Sarto para assumir o cargo de Secretário da Regional III.
Partido: CIDADANIA
Aniversário: 16 de Junho
Mandato:
Profissão: Publicitário
Votos na última
eleição: 5.932 votos
Gabinete: 27
Telefone: (85) 3444 8312
E-mail: vereador
michellins@cmfor.ce.gov.br
Facebook: facebook/ michellinsvereador
IG: @michellinsvereador
56 NOSSOS BAIRROS | NOSSA FORTALEZA
PAULO MARTINS
Paulo Victor Araújo

Martins é bacharel em Direito pela Universidade de Fortaleza (Unifor) e servidor público estadual. Paulo Martins é filho do ex-vereador de Fortaleza por seis mandatos, Adelmo Martins. Em 2016, foi eleito para uma cadeira na Câmara. Integrava o Partido Renovador Trabalhista Brasileiro (PRTB), mas em 2020 foi para o Partido Democrático Trabalhista (PDT). Nas eleições do mesmo ano, concorreu à reeleição garantindo participação como vereador de Fortaleza até 2024. O vereador defende pautas em prol da juventude e cidadania, da saúde e segurança públicas, mobilidade urbana, proteção animal e geração de emprego.
Partido: PDT
Aniversário: 2/6
Mandato: 2º (2017-2020 e 2021-2024)
Profissão: escrivo da Polícia Civil
Votos na última
eleição: 10.591
Gabinete: 3
Telefone: (85) 3444 8365
E-mail: ver.paulomartins
@gmail.com
Facebook: facebook.com/ paulomartinsoficial
IG: @vereadorpaulomartins
Twitter: paulomvereador
PP CELL
Pedro Ferreira Mesquita Filho é original de Santa Quitéria. Nascido em 11 de abril de 1983, cursou mas não concluiu Direito. É empresário e empreendedor social, já tendo sido camelô no Centro de Fortaleza, vendendo assessórios para celular. Em 2018 se candidatou a deputado estadual e recebeu 25.875 votos. Em 2020, foi eleito vereador de Fortaleza, tendo recebido 7.330 votos. O parlamentar defende a causa dos camelôs e busca propor a redução de taxas e criar um restaurante popular. Ainda defende outras bandeiras sociais. Através do projeto social da Associação Mãos Dadas, de sua autoria, crianças e adolescentes têm oportunidade de ficar longe das drogas e da criminalidade.
Partido: PSD
Aniversário: 11/4
Mandato: 1º (2021-2024)
Profissão: empresário
Votos na última
eleição: 7.330
Gabinete: 22
Telefone: (85) 3444.8355
E-mail: vereadorppcell@ cmfor.ce.gov.br
Facebook: facebook.com/
OficialPpcell
IG: @vereadorppcell
PRISCILA COSTA
Priscila Bezerra da Costa nasceu em 12 de setembro de 1984. Possui carreira profissional com atuação no rádio, TV e assessoria de comunicação. Assumiu o primeiro mandato como vereadora de Fortaleza em 2016, após receber 5.491 votos pelo PRTB. Em 2018, disputou vaga de deputada federal pelo Ceará e ficou na suplência após receber 48 mil votos. Em 2020, foi reeleita para a Câmara Municipal de Fortaleza. A parlamentar declara ser a voz do conservadorismo feminino e tem como principais pautas a defesa da vida e da família, além de ser crítica à “doutrinação ideológica” nas escolas.

Partido: PL
Aniversário: 12/9
Mandato: 2º (2017-2020 e 2021-2024)
Profissão: jornalista
Votos na última eleição: 14.654 votos
Gabinete: 32
Telefone: (85) 3444 8367
E-mail: vereadorapriscila costa@cmfor.ce.gov.br
Facebook: facebook.com/ priscilacostaoficial IG: @priscilacosta
Twitter: @priscilabcosta_
PROFESSOR ENILSON

Francisco Enilson de Souza Soares nasceu no dia 20 de setembro de 1978. Nascido e criado no bairro Bom Jardim, formou-se em Filosofia e História pela Universidade Federal do Ceará (UFC) e em Fisioterapia pela Estácio FIC. Atualmente cursa Odontologia na UFC. É servidor público estadual, atuando como professor na área de Ciências Humanas e Saúde. Também desenvolve trabalho social no Grande Bom Jardim e lidera o Instituto Confia Brasil. Em 2020 foi eleito para o seu primeiro mandato como vereador de Fortaleza com 3.788 votos.
Partido: CIDADANIA
Aniversário: 20/9
Mandato: 1º (2021-2024)
Profissão: professor Votos na última
eleição: 3.788
Gabinete: 31
Telefone: (85) 3444 8300
E-mail: vereadorprofessor enilson@cmfor.ce.gov.br



Facebook: facebook.com/ professorenilson
IG: @professorenilson
57 VEREADORES
RAIMUNDO FILHO
Raimundo Cunha Filho, nascido em Uruoca, é graduado em Psicologia e especialista em Prevenção da Dependência Química, ambas pela Universidade de Fortaleza (Unifor). É servidor público federal do quadro específico da Agência Nacional de Vigilância Sanitária (Anvisa) desde sua criação e exerce suas funções no Aeroporto Internacional de Fortaleza. Eleito para seu segundo mandato consecutivo, propõe melhorias para as comunidades mais carentes de Fortaleza. Na área da saúde defende a atenção especial com a classe dos Agentes de Saúde e Endemias do Município com o objetivo de trazer melhorias para a categoria. Outra bandeira apoiada, por ele, é a defesa e a preservação do meio ambiente.
Partido: PDT
Aniversário: 8 de setembro
Mandato: 2º
Profissão: servidor público Votos na última
eleição: 8.739 votos
Gabinete: 33
Telefone: (85) 3444 8375
E-mail: raimundofilhocmf@ gmail.com
Facebook: facebook/
VereadorRaimundoFilho
IG: @vereador raimundofilho
RENAN COLARES
Renan Ehrich Colares nasceu em 28 de setembro de1984. É formado em Sistemas de Informação pelo Centro Universitário Estácio do Ceará e especialista em Gerenciamento de Projetos pela Fundação Getúlio Vargas (FGV). A atuação na vida pública iniciou em 2012, quando concorreu pela primeira vez à Câmara Municipal de Fortaleza, ficando na suplência pelo PSDB. Em 2013, assumiu o cargo de secretárioexecutivo do Planejamento, Orçamento e Gestão da Prefeitura Municipal de Fortaleza. Com forte atuação na Grande Messejana, foi eleito em 2016 com 11.525 votos, sendo o sexto mais votado. Em 2020, foi reeleito com 9.523 votos, defendendo as bandeiras das áreas da Saúde e Educação.
Partido: PDT
Aniversário: 28/9
Mandato: 2º (2017-2020 e 2021-2024)
Profissão: gerente de projetos
Votos na última
eleição: 9.523

Gabinete: 34
Telefone: (85) 3444 8336
E-mail: ren_colares@ hotmail.com
Facebook: facebook.com/ RenanEColares
IG: @renan_colares
RONALDO MARTINS
Ronaldo Martins é jornalista, radialista, músico. Ingressou na vida política em 2001, quando exerceu o mandato de vereador pelo município de Caucaia-CE (2001-2002).
Em seguida, foi candidato a deputado estadual do Ceará, no qual exerceu a função por três legislaturas consecutivas (2003-2007, 2007-2011 e 2011-2015).




Atualmente, Ronaldo é o atual presidente estadual do Republicanos Ceará. Em 2020, Ronaldo lançou sua candidatura para vereador de Fortaleza, obtendo 31.840 votos. Além de ter sido o mais votado, foi o único que atingiu o quociente eleitoral.
Partido: REPUBLICANOS
Aniversário: 21 de janeiro
Mandato: 2º (2015-2019 e 2019-2023)
Profissão: Jornalista
Votos na última eleição: 31.840 votos
Gabinete: 07
Telefone: (85) 3444 8346
E-mail: vereadorronaldo martins@cmfor.ce.gov.br
Facebook:
facebook/10Ronaldo
Martins
IG: @10ronaldomartins
RONIVALDO
Ronivaldo Maia nasceu em 3 de junho de 1970, em Tabuleiro do Norte. Professor de História, é formado pela Universidade Estadual do Ceará (Uece). Aos 17 anos, foi presidente da União Municipal dos Estudantes Secundaristas de Fortaleza, em 1988. Como universitário, foi coordenador geral do Diretório Central dos Estudantes da Universidade Estadual do Ceará (Uece). No governo de Luizianne Lins (PT) na Prefeitura de Fortaleza, foi presidente da Empresa Municipal de Limpeza e Urbanização (Emlurb). Também ocupou cargos no Conselho de Gestão da Empresa de Transporte Urbano de Fortaleza (Etufor). Em 2009 foi eleito pela primeira vez vereador de Fortaleza. Em 2020 foi eleito para o quarto mandato como vereador.
Partido: PT
Aniversário: 3/6
Mandato: 4º (2020-2024)
Profissão: professor de História
Votos na última
eleição: 4.981
Gabinete: 05
Telefone: 3444 8377
E-mail: ronivaldom13
@gmail.com
Facebook: facebook/ ronivaldomaia
IG: @ronivaldo_maia
58 NOSSOS BAIRROS | NOSSA FORTALEZA
SARGENTO REGINAURO*
Reginauro Sousa Nascimento nasceu no dia 2 de abril de 1973. Sargento do Corpo de Bombeiros do Ceará, é graduado em Educação Física e mestre em Educação pela Universidade Federal do Ceará (UFC). Em 2016 disputou pela primeira vez eleição para a Câmara Municipal, ficando na suplência. Assumiu em 2019, quando o vereador Soldado Noélio assumiu o cargo de deputado estadual do Ceará. Em 2020 foi reeleito e integra atualmente a bancada de oposição. Dentre as pautas que são bandeiras para o parlamentar, estão em destaque segurança pública, acessibilidade, meio ambiente e direito das mulheres.
Partido: UNIÃO
Aniversário: 2/4
Mandato: 2º (2020-2024)
Profissão: sargento do Corpo de Bombeiros
Votos na última
eleição: 5.242
Gabinete: 37
Telefone: 3444 8311
E-mail: sargentoreginauro
@sargentoreginauro.com.br
Facebook: facebook/ reginaurosousaoficial
IG: @ReginauroSousa
*Eleito em 2022 para deputado estadual


TIA FRANCISCA
Francisca das Chagas Silva de Souza nasceu em 4 de outubro de 1957 no município de ParnaíbaPI. Em 1975 iniciou um trabalho social no Parque São José, com a fundação da Escolinha de Assistência ao Menor Carente. Em 1988, tornou-se líder comunitária, fundando a Associação do Bem Estar Social do Ceará (Abemce), que atua na alfabetização de crianças e adolescentes, impactando positivamente mais de quatro mil crianças e jovens. Em 2020, Tia Francisca foi eleita pelo Partido Liberal (PL) para o seu primeiro mandato na Câmara Municipal de Fortaleza, sendo a 1ª suplente da mesa diretora (2021-2022).

Partido: PL
Aniversário: 4/10
Mandato: 1º (2021-2024)
Profissão: estudante universitária
Votos na última
eleição: 5.793
Gabinete: 28
Telefone: (85) 3444 8353
E-mail: tiafranciscaoficial @gmail.com
Facebook: facebook.com/ tiafranciscasouza
IG: @tiafranciscaoficial
WELLINGTON SABÓIA
Bacharel em Teologia, Francisco Wellington Sabóia Vitorino é vereador de Fortaleza de segundo mandato. Em 2008, ficou na suplência. Pelo Partido da Mulher Brasileira (PMB), disputou as eleições de 2020 e recebeu 4.915 votos. Tem atuação política nos bairros Jardim Iracema e Padre Andrade. Sabóia já trabalhou no serviço público como diretor da Etufor (2009/2012), secretário da Regional IV (2016) e foi coordenador do Programa Nacional de Apoio à Gestão Administrativa e Fiscal dos Municípios Brasileiros –PNAFM (2017). Dentre os projetos defendidos pelo vereador, estão a instituição da Política Municipal de Formação e Capacitação Continuada de Mulheres para o mercado de trabalho e o que institui o auxílio no valor de R$ 300 mensais às mães solteiras.
Partido: PMB
Aniversário: 18/10
Mandato: 1º (2021-2024)
Profissão: autônomo
Votos na última
eleição: 4.915
Gabinete: 35
Telefone: (85) 3444 8352
E-mail: wellingtonsaboia2 @icloud.com


Facebook: facebook.com/ WellingtonSaboia35000
IG: @wellington_saboia_
SUPLENTES
- Carlos Mesquita (PDT)
- Didi Mangueira (PDT)
- Pedro França (CIDADANIA)
- Veríssimo Freitas (REPUBLICANOS)
59 VEREADORES
12 REGIONAIS 121 BAIRROS



























Começa aqui um passeio por toda a Capital de Fortaleza. Os bairros de cada Regional estão elencados em ordem alfabética e os serviços das secretarias executivas são apresentados no início de cada capítulo. Os dados foram levantados com a Prefeitura de Fortaleza, IBGE, O POVO, entrevistas e registros de memória das comunidades
 Ponte sobre o Rio Maranguapinho, na Barra do Ceará
Ponte sobre o Rio Maranguapinho, na Barra do Ceará




























REGIONAL 1






















Com 10 bairros, a Regional 1 abrange lugares que remetem à formação histórica de Fortaleza, como a Barra do Ceará, berço histórico do Estado. Mas é também aqui que fica um polo econômico que atrai comerciantes e consumidores de fora: o Centro Fashion, no bairro Jacarecanga










 Ponte sobre o Rio Ceará na Barra do Ceará
Ponte sobre o Rio Ceará na Barra do Ceará





























GUIA DA REGIONAL 1
BAIRROS
Álvaro Weyne
Barra do Ceará
Carlito Pamplona
Cristo Redentor

Floresta
Jacarecanga
Jardim Guanabara
Jardim Iracema
Pirambu
Vila Velha

64 NOSSOS BAIRROS | NOSSA FORTALEZA
FCO FONTENELE
Ponte sobre o Rio Ceará na Barra do Ceará é ponto turístico da Cidade
SECRETARIA REGIONAL 1
Endereço: Rua Jangada, 740 – Barra do Ceará –CEP 60331-290 – Fortaleza – CE
Telefone: (85) 98513-5290
Secretária Kamyla Castro de Oliveira

E-mail: kamyla.oliveira@sr1.fortaleza.ce.gov.br
Perfil
É bacharel em Direito pela Estácio FIC (2015-2020), possui pós-graduação em Direito Público e especialização em Teoria Política e Gestão Pública pela Universidade Miguel de Cervantes - Santiago do Chile (2006), é graduada em Analista de Sistemas pela FGF. Foi coordenadora de políticas públicas voltadas para juventude na Secretaria de Esporte e Juventude (Sejuv) do Governo do Estado do Ceará (2003-2007), assessora política da Prefeitura Municipal de Piquet Carneiro (2008-2015) e assessora do Senado Federal (2015-2022).
CONTATOS IMPORTANTES
GABINETE DA SECRETÁRIA
Telefone: (85) 3433.6813
CENTRAL DE ACOLHIMENTO
Informação e solicitação de serviços
Telefone: (85) 3105.3737
WhatsApp: (85) 9 8513.5290
E-mail: centraldeacolhimentosr1@gmail.com
OUVIDORIA
Telefone: 156
E-mail: ouvidoria.ser1@sr1.fortaleza.ce.gov.br

ASSISTÊNCIA SOCIAL
Cadastro Único e Bolsa Família
Telefone: (85) 3488.9894
INFRAESTRUTURA
Informação sobre obras e manutenção em espaços públicos
Telefone: (85) 3433.6811
COORDENADORIA DE SAÚDE
Telefone: (85) 3433.6859
CONSERVAÇÃO E SERVIÇOS PÚBLICOS
Informação e solicitação de limpeza pública, requalificação de pontos de lixo, pavimentação, tapa-buraco, galerias e bocas de lobo
Telefone: (85) 3105.3407
ORDENAMENTO DE TERRITÓRIO
Informação e cadastramento de vendedores ambulantes, ordenamento de feiras e espaços públicos
Telefone: (85) 3433.6824
AGEFIS
Telefone: 156 / (85) 3433-6858
E-mail: gerefis1@agefis.fortaleza.ce.gov.br
65 REGIONAL 1
ÁLVARO WEYNE
Aos 70 anos, o bairro Álvaro Weyne está localizado na região Oeste da Capital. Faz divisa com os bairros da sua própria Regional 1 - Pirambu, Carlito Pamplona, Cristo Redentor, Barra do Ceará e Floresta, além do bairro Vila Ellery e Presidente Kennedy, da Regional 3.
No seu território está localizado o Grêmio Recreativo dos Ferroviários, a Biblioteca Comunitária CL Prof. Leônidas Magalhães e várias praças, entre elas a Assis Bezerra, Carlito Pamplona e, ainda, o Calçadão Hugo Rocha e o Polo de Lazer Álvaro Weyne.
Seu nome foi inspirado no ex-prefeito de Fortaleza Álvaro Weyne, com mandato entre 1928 e 1930 e, depois, entre 1934 e 1936. Relatos históricos dizem que Álvaro Weyne era conhecido como “o prefeito das flores”, pois preocupava-se com a arborização e fazia das praças públicas verdadeiros jardins floridos.
Álvaro Nunes Weyne, que nasceu em 11 de novembro de 1881, presidiu o Rotary Club de Fortaleza, dirigiu a Santa Casa da Misericórdia e foi secretário do Estado dos Negócios da Fazenda.
Também foi o responsável pela aquisição de um importante equipamento da Cidade, a Casa de José de Alencar.
DADOS GERAIS
Localização
Regional: SR 1
Território: 6
Bairros limítrofes: Barra do Ceará; Floresta, Cristo Redetor, Pirambu, Carlito Pamplona, Vila Ellery, Presidente Kennedy
População estimada: 23.690

População Feminina: 12.856
População Masculina: 10.834
Densidade (hab/km²): 16.659,63
Área (km²): 1,42
Perímetro (km): 5.254,73
Avenidas principais: Avenida Leste oeste; Avenida Pasteur; Avenida Tenente Lisboa
Feiras livres: Feira do Álvaro Weyne (quinta-feira)/ Avenida Teodomiro de Castro, bairro Álvaro Weyne
Ecopontos:
Álvaro Weyne - Rua José Acioli, esquina com a Avenida Tenente Lisboa
IDH: 0,365
GRÊMIO RECREATIVO DOS FERROVIÁRIOS
Fundado pelos ferroviários da Rede Ferroviária Federal S/A (RFFSA), o Grêmio Recreativo dos Ferroviários já foi a casa de um antigo engenheiro.
Atualmente, é usado para atividades esportivas e festas particulares. A RFFSA foi criada em 1957 durante o governo de Juscelino Kubitschek com o intuito de administrar e manter em tráfego as estradas de ferro brasileiras.
ATIVIDADE SOCIAL
Associação União dos Moradores de Luta do Álvaro Weyne; Associação Nossa Casa; A. A. Grupo Liberal27;Grupo Escoteiro Padre Caetano - 45/CE;
IGREJAS
Paróquia Nossa Senhora de Fátima; Igreja São Judas Tadeu; Igreja de São Francisco
SAÚDE
Posto de Saúde Floresta - Rua Ten. José Barreira, 251
PRAÇAS
Calçadão Hugo Rocha; Polo de Lazer Álvaro WeyneFloresta; Praça Assis Bezerra; Carlito Pamplona;Pra-
66 NOSSOS BAIRROS | NOSSA FORTALEZA
ça da Igreja do Carlito Pamplona;Praça Teodomiro de Castro; Praça Valentim Monteiro
EDUCAÇÃO
Escolas: Aldeídes Régis; Maria Roseli Lima Mesquita ; Nossa Senhora Do Perpétuo Socorro; Patativa Do Assaré; Vovó Iolete; Vovô Tonico
CULTURA
Bibliotecas: Biblioteca Comunitária CL Prof. Leônidas

Magalhães
Centros culturais: Grêmio Recreativo dos Ferroviários

SEGURANÇA
AIS: 4
TRANSPORTE PÚBLICO
Cuca Barra/Papicu; Av. Borges de Melo/ Papicu I; Av. Borges de Melo/ Papicu II; Corujão/Av. Paranjana I; Corujão/Av. Paranjana II; Antônio Bezerra/Francisco Sá/Papicu; Gran-
de Circular I; Grande Circular II; Corujão/Grande Circular I; Corujão/Grande Circular II; Corujão/Jardim Iracema; Parquelândia/Parangaba; Cuca Barra/Parangaba; Francisco Sá/Parangaba; Antônio Bezerra/Papicu/Praia de Iracema; Beira Rio/Centro; Floresta/Centro; Vila do Mar/Centro; Jardim Iracema; Álvaro Weyne/Centro; Cj Nova Assunção/ Francisco Sá; Jardim Guanabara/Centro; Antônio Bezerra/ Álvaro Weyne; Av. Leste Oeste/Centro; Barra do Ceará/Antônio Bezerra; Barra do Ceará/Cais do Porto; Cidade 2000/ Sargento Hermínio; Granja Lisboa/Goiabeiras
ÁREA EDIFICADA (M2)
Inscrições Residenciais: 5.577
Inscrições Comerciais: 940
Inscrições de Prestação de Serviços: 29
Inscrições Industriais: 5
Assentamentos precários: Conjunto Habitacional; Socorro Abreu
Favela: Reino Unido II ou Reino Encantado; Rua Dona Mendinha II;Rua Osmar Paiva; Rua Dr Hugo Rocha (Floresta); Travessa Olímpio Paiva
Mutirão: Rua Mendinha I
67 REGIONAL 1
AURÉLIO ALVES
Fachada da empresa Transnordestina Logistica S/A, no Alvaro Weyne, fundada em 1997
Vista aérea da ponte da Barra do Ceará
BARRA DO CEARÁ
Com uma grande população estimada em mais de 72 mil pessoas, a Barra do Ceará é o bairro mais antigo da cidade de Fortaleza. Sua importância vai muito além da Capital, sendo berço histórico do estado do Ceará.

Foi nesse território que o Capitão-mor Pero Coelho iniciou a colonização construindo o Fortim de São Tiago, em 1604. Anos depois, Martim Soares Moreno veio ao Ceará e ergueu, em 20 de janeiro de 1612, o Fortim de São Sebastião. Após ocupação estrangeira e problemas com os índios locais, os fortes foram desabilitados depois de alguns anos.

A Barra do Ceará possui duas praias ao longo de sua parte costeira com largas faixas de areia que reúnem dezenas de pescadores. Uma delas é chamada de praia das Goiabeiras e a outra de Praia da Barra ou Praia do Araújo, e ela vai ao encontro do Rio Ceará, onde pode-se admirar um belíssimo pôr do sol.
O Rio Ceará nasce da junção dos riachos Jandaíra e Bom Princípio, na Serra de Maranguape, e recebe as águas do Rio Maranguapinho, na aldeia dos índios tapebas, em Bom Princípio e Caucaia.
Até hoje, o bairro realiza os festejos de São Sebastião, que fazem parte da formação religiosa e histórica dos moradores locais. As manifestações deixam transparente a relação de gratidão e pertencimento da comunidade que lá vive.
O bairro tem grande destaque para práticas esportivas, como surf e kitesurf, e artística, por ter o primeiro Centro Urbano de Cultura, Arte, Ciência e Esporte de Fortaleza, Cuca Barra do Ceará, criado em 2009.
Além disso, é sede, na rua Dona Filó, 650, do Ferroviário Atlético Clube, um dos mais tradicionais times do futebol cearense. Uma outra curiosidade do bairro é ter sido o primeiro a ter um hidroporto na década de 1930,
68 NOSSOS BAIRROS | NOSSA FORTALEZA
FOTOS FCO FONTENELE
quando a cidade não tinha nenhuma pista de pouso. Na época, as companhias de aviação alemã Panair e Condor transportavam passageiros utilizando os hidroaviões Junkers, que aterrissavam no braço de mar das águas do Rio Ceará.
Entre os passageiros famosos desembarcados na Barra, está o escritor francês Antoine de Saint Exupéry, autor da obra “O Pequeno Príncipe”. O fato aconteceu de forma ocasional, entre 1931/1932, pois o destino do autor era a Bahia.
Hoje, a Barra do Ceará é conhecida por ser um bairro populoso e contar com diferentes organizações sociais de desenvolvimento humano em busca de minimizar as desigualdades sociais da região.
DADOS GERAIS
Localização
Regional: SR 1
Território: 3
Bairros limítrofes: Vila Velha; Jardim Iracema; Floresta; Álvaro Weyne; Cristo Redentor
População estimada: 72.423

População Feminina: 37.765
População Masculina: 34.658
Densidade (hab/km²): 16.913,36
Área (km²): 4,28
Perímetro (km): 9.842,65
Avenidas principais: Avenida 13 Rockdale, Avenida 20 de Janeiro, Avenida Coronel Carvalho, Avenida
Francisco Sá, Avenida Hildebrando de Melo, Avenida
José Moreira Rebouças, Avenida Presidente Castelo
Branco, Avenida Radialista José Lima Verde.
Feiras livres: Feira das Goiabeiras (sábado)/ Avenida
Senador Roberto Kennedy, bairro Barra do Ceará
Mercados públicos: Mercado dos Peixes Vila do MarR. José Roberto Sales, 582 - Barra do Ceará
Ecopontos:
Barra do Ceará - Rua Graça Aranha, esquina com Rua
Wicar Bastos Cavalcante
Vila do Mar I - Rua Lídia Petri Gonçalves, em frente ao número 1140
Barra do Ceará II - Avenida Francisco Sá, esquina com a Rua Helenice Paiva Menezes.
MERCADO DOS PEIXES DA VILA DO MAR
Construído pela Prefeitura de Fortaleza, o equipamento Mercado dos Peixes da Vila do Mar, na Barra do Ceará, é um ponto de empreendedorismo local e uma boa opção para se comprar peixe fresco na região.
Por meio dele, muitas famílias da região e adjacências têm o seu sustento e a sua fonte de renda. Antes da construção do Mercado, os pescadores locais atuavam no calçadão da orla, sem estrutura e saneamento.
IDH: 0,216
ESPORTES
Areninhas: Areninha Barra do Ceará
ATIVIDADE SOCIAL
Centro de Referência de Assistência Social; Associação dos Amigos no Combate à Exclusão Social; Associação dos Moradores do Conjunto Popular; Associação Capoeira Cultura Brasileira; Associação Pequeno Cidadão; Clube dos Subtenentes e Sargentos PM/BM; Associação Sonho Meu; Associação Dos Moradores Periféricos De Fortaleza; Associação Cultural Afro Brasileira Pai Luiz De Aruanda; Centro de Profissionalização Inclusiva para a Pessoa com Deficiência; A. A. Grupo Beira Rio - 27; ARCA; MISMEC - Projeto 4 Varas; Centro de Convivência Maria Mãe da Vida; Centro Comunitário Cristo Redentor.
IGREJAS
Paróquia São Pedro (Rua Larga, 32); Igreja de Nossa Senhora de Fátima (R. Encanto da Barra, 44-110); Capela São José - Paróquia São Pedro (Rua padre Bernardo, 170-198); Igreja de Nossa Senhora do Perpétuo Socorro (Rua Tulipa, 687).
69 REGIONAL 1
SAÚDE
Postos de Saúde:
Casemiro Filho (Av. Francisco Sá, 6449); Chico da Silva (Avenida Castelo Branco, 4707); Lineu Jucá (Rua Vila Velha, 101)
PRAÇAS
Praça 13 de Rochdale - Praça 28 de Agosto (Av. Coronel Carvalho x Av. 13 de Rochdale; Praça 7 Prédios ( Rua José de Vasconcelos x Rua Cândido Castelo Branco Praça da Colônia); Barra do Ceará (Rua 20 de Janeiro x Rua César Correia Praça da Rua Astrogildo Fontoura/ Rua Astrogildo Fontoura x Rua A); Praça Graça Aranha (Rua Graça Aranha x Rua Wilcar Bastos Cavalcante);
Praça Hermes Pereira (Rua 01 x Rua 5); Praça Jaciara (Rua Araken x Rua C); Praça Jd. Iracema - Praça da Galera (Rua Lara x Rua Amor Perfeito); Praça José
Lima Verde (Av. José Lima Verde x Rua Interna); Praça
São Pedro (Rua Larga x Rua Graças Alcançadas); Praça das Mangueiras (Rua Amor Perfeito x Rua Três Cdo Resadori); Prestes de Queiroz (Av. Coronel Carvalho x Av. Florêncio de Alencar); Praça Padre Santana (Rua Amor Perfeito x Rua Álvaro Garrido); Praça Percide Benicio Rodrigues (Av. Coronel Carvalho x Rua 3)
MEIO AMBIENTE
Parques: Microparque Seu Zequinha - Barra do Ceará / Av. Francisco Sá x Rua Helenice Paiva Menezes.
Rios ou lagoas: Rio Ceará; Rio Levada.
EDUCAÇÃO
Escolas: Agostinho Moreira e Silva (Rua Peri, 20)
Arpoador (Rua Grito De Alerta, 136)
Casimiro José De Lima Filho (Av. Francisco Sá, 6449)
Dois De Dezembro (Rua Araquém, 860)
Dom Antônio Batista De Fragoso (Av. Francisco Sá, 7945)
Francisco Das Chagas De Farias (Rua Des. Hermes Paraíba, 135)
Francisco Domingos Da Silva (Av. Presidente Castelo
Branco, 4707)
Maria Aglaê Gonçalves Monteiro (Rua C Ndido Castelo Branco, S/n)
Rachel De Queiroz (Trav. Aurélio Lavôr, 99)
Jader De Figueiredo Correia (Rua Tocandira, 61)
Vila Do Mar (Rua Dr. José Roberto Sales, S/n)
Pequeno Polegar (Rua Moacir, 45)
Aldemir Martins (Av. Francisco Sá, 7460)
Reitor Pedro Teixeira Barroso (Av. Florêncio De Alencar, 900)
CULTURA
Patrimônio histórico: Restaurante Albertu’s, Praça Alberto de Souza e o Píer da Barra do Ceará (Av. Radialista José Lima Verde, 746)
Cucas: Cuca Barra (Av. Presidente Castelo Branco, 6417)
SEGURANÇA
Delegacias: Delegacia de Polícia Civil | 33° Distrito Policial;
AIS: 8
TRANSPORTE PÚBLICO
Cuca Barra/Papicu; Corujão/Av. Paranjana I; Corujão/Av. Paranjana II ; Antônio Bezerra/Francisco Sá/ Papicu; Grande Circular I; Grande Circular II; Corujão/ Grande Circular I ; Corujão/Grande Circular II; Corujão/Jardim Iracema; Parquelândia/Parangaba; -Cuca Barra/Parangaba; Francisco Sá/Parangaba; Antônio Bezerra/Papicu/Praia de Iracema; Beira Rio/Centro; Vila do Mar/Centro ; ardim Iracema ; Álvaro Weyne/ Centro ; Cj Nova Assunção/Francisco Sá; Jardim Guanabara/Centro; Vila do Mar/Náutico/Antônio Bezerra I; Antônio Bezerra/Álvaro Weyne; Av. Leste Oeste/ Centro; Barra do Ceará/Antônio Bezerra; Barra do Ceará/Cais do Porto; Granja Lisboa/Goiabeiras
ÁREA EDIFICADA (M2)
Inscrições Residenciais: 6.665

70 NOSSOS BAIRROS | NOSSA FORTALEZA
Inscrições Comerciais: 1.260

Inscrições de Prestação de Serviços: 52
Inscrições Industriais: 23
Assentamentos precários: Conjunto habitacional; Conjunto Anita Garibaldi; Seis Companheiros/Costa Oeste; Conjunto Popular; Parque Ibiapava/Sete Prédios; Conjunto Tropical; Planalto das Goiabeiras
Favela: Rua graça de aranha; Vila Márcia; Francisco Sá; Av. 20 de Janeiro; Buraco da Gia; Rua Poty; Vila Ivone; Rua Francisco calaça; Sete Prédios; Santo Amaro; Travessa Olical; Santa Inês/Pirambu; Tapajós; Comunidade Seis; Companheiros/Maria Gorete; Sítio Aratanha/Grafissa; Vilagg; Comunidade Goiabeiras; Jardim Petrópolis; Morro do Santiago; Brisa da Praia; Sonho
Meu; Boa Esperanã/ Colibri; 20 de Janeiro; Beco Francisco Sá; Lutar e Vencer; Comunidade Riacho Doce/ Jardim Iracema; Comunidade Novo Lar; Cimpelco; Terra prometida; Quatro varas; Travessa José Vilar/ contorno Presidente Castelo Branco; Damas II/ Goiabeiras; Mutirão; Seis Companheiros; Jaciara; Santa Maria Gorete I; Planalto Barra; Conjunto Goiabeiras/ Entrada das Goiabeiras/ Vila Nova; Dunas I; Zenaide Magalhães; Ceci; UMJIR/ José Maria Vasconcelos
PONTE DO RIO CEARÁ
Com 25 anos, a Ponte do Rio Ceará leva o nome de José Martins Rodrigues, cearense defensor dos direitos humanos. É uma referência para o bairro e se tornou ponto turístico. O equipamento faz, também, a integração física entre o litoral de Fortaleza e Caucaia.

71 REGIONAL 1
Ponte do Rio Ceará proporciona belas imagens aos visitantes pela vista privilegiada do encontro do rio com o mar
Mercado público do Carlito Pamplona existe desde 1963 e também atende os bairros do entorno
CARLITO PAMPLONA
O bairro Carlito Pamplona, pertencente à Regional 1 de Fortaleza, é conhecido como o primeiro bairro operário da Cidade. Em virtude da proximidade que tinha da ferrovia e da zona fabril na época, alavancou a expansão e o crescimento da população na região.
Seu nome foi uma homenagem ao fortalezense que se destacou como diretor do setor de compra e venda de matéria-prima da fábrica de óleo Brasil Oiticica, que teve sede no local.
Homem dinâmico e com visão empresarial, Carlito Narbal Pamplona conquistou e fez crescer o mercado de óleo e de castanha de caju. Foi ele quem fechou o primeiro negócio no setor e estimulou o plantio e a compra de castanha, especialmente, nos centros da área marítima.
Atualmente, os moradores contam com o Mercado Público Carlito Pamplona. E, para lazer, as praças Carlito Pamplona; Igreja do Carlito Pamplona; da Rua Álvaro de Alencar e do Ironte.
DADOS GERAIS
Localização
Regional: SR 1
Território: 5
Bairros limítrofes: Álvaro Weyne; Pirambu; Vila Ellery; Jacarecanga, Monte Castelo
População estimada: 29.076
População Feminina: 15.480
População Masculina: 13.596
Densidade (hab/km²): 21.490,02
Área (km²): 1,35

Perímetro (km): 5.140,22
Avenidas principais: Avenida Francisco Sá
Mercados públicos: Mercado Público Carlito Pamplo-

72 NOSSOS BAIRROS | NOSSA FORTALEZA
FERNANDA BARROS
na - Rua Ana Facó, 68
Ecopontos: Carlito Pamplona - Avenida Francisco Sá, esquina com Rua Dom Hélio Campos
IDH: 0,300
MERCADO PÚBLICO
CARLITO PAMPLONA
Aberto diariamente, o Mercado Público Carlito Pamplona serve como mais uma opção de comércio para o bairro e os territórios adjacentes. Ele foi fundado em 1963 quando houve a reforma provisória para um “mercado de lona”. Em 1971, havia poucos permissionários. O número aumentou com a desativação do mercado Duque de Caxias.
ATIVIDADE SOCIAL
Fundação Ana Lima - Projeto Ilhas;Projeto São Pivete; Associação Dos Moradores Do Conjunto Habitacional Vila Ellery;
IGREJAS
Paróquia Nossa Senhora do Perpétuo Socorro (Rua Cônsul Gouvêia, 44); Capela de Santa Teresinha (R. Santa Rosa, 579);
PRAÇAS
Praça Carlito Pamplona - Álvaro Weyne / Av. Pasteur x Av. Francisco Sá
Praça da Igreja do Carlito Pamplona - Álvaro Weyne / Av. Francisco Sá x Av. Pasteur
Praça da Rua Álvaro de Alencar - Carlito Pamplona / Av. Presidente Castelo Branco x Rua Álvaro de Alencar
Praça Ironte - Carlito Pamplona / Rua Pedro Clemente
Fernandes x Rua Monsenhor Dantas
EDUCAÇÃO
Escolas: Hilberto Silva; Tertuliano Cambraia
CULTURA
Bibliotecas: Biblioteca Comunitária Marighellas Literários

SEGURANÇA
AIS: 4
TRANSPORTE PÚBLICO
Cuca Barra/Papicu; Av. Borges de Melo/Papicu I; Av. Borges de Melo/Papicu II; Corujão/Av. Paranjana I; Corujão/Av. Paranjana II; Antônio Bezerra/Francisco Sá/ Papicu; Grande Circular I; Grande Circular II; Corujão/ Grande Circular I; Corujão/Grande Circular II; Corujão/Jardim Iracema; Cuca Barra/Parangaba; Antônio Bezerra/Unifor; Antônio Bezerra/Papicu/Praia de Iracema; Beira Rio/Centro; Vila Santo Antônio/Nossa Senhora Graças/Centro; Floresta/Centro; Santa Maria/Bairro Ellery/Centro; Vila do Mar/Centro; Jardim Iracema; Álvaro Weyne/Centro; Cj Nova Assunção/ Francisco Sá; Jardim Guanabara/Centro; Vila do Mar/ Náutico/Antônio Bezerra I; Av. Leste Oeste/Centro; Barra do Ceará/Cais do Porto; Cidade 2000/Sargento Hermínio; Granja Lisboa/Goiabeiras
ÁREA EDIFICADA (M2)
Inscrições Residenciais: 6.546
Inscrições Comerciais: 934
Inscrições de Prestação de Serviços: 27
Inscrições Industriais: 6
Assentamentos precários:
Conjunto Habitacional; Conjunto Terra da União; Dom Helder Câmara
Favela
Vila Caminha; Olavo Andrade; Travessa Olímpio Paiva; Rua Lucas; Machado Araújo; Comunidade do Tirol; Mutirã; Novo tempo I; Nossa Voz
73 REGIONAL 1
CRISTO REDENTOR
Padre Caetano Minette de Tillesse é considerado o fundador do bairro Cristo Redentor, localizado na Regional 1, na região Oeste de Fortaleza. O bairro, que faz divisa com Barra do Ceará, Floresta, Álvaro Weyne, Pirambu e Carlito Pamplona, fica no Grande Pirambu.

Região escolhida pelo padre Caetano para passar um tempo da sua vida na década de 1960. Combatente da Segunda Guerra e de origem belga, o padre é descendente da família real.
Tornou-se monge, viveu por 22 anos em silêncio e depois de estudos em Roma decidiu morar em um dos lugares mais pobres da América Latina, à época: a favela do Grande Pirambu.
Ele foi o precursor da Renovação Carismática Católica trazida para o Ceará, além de realizar inúmeros trabalhos sociais como religioso. Ajudou na criação de 100 crianças, sendo 46 registradas em cartório com o seu sobrenome.
Ainda hoje o bairro se destaca pela quantidade de projetos sociais no território que buscam melhorar a desigualdade social da população local.
DADOS GERAIS
Localização
Regional: SR 1
Território: 4
Bairros limítrofes: Barra do Ceará; Floresta; Álvaro Weyne; Pirambu; Carlito Pamplona
População estimada: 26.717
População Feminina: 14.078
População Masculina: 12.639
Densidade (hab/km²): 22.470,14
Área (km²): 1,19

Perímetro (km): 6.781,45
Avenidas principais: Avenida Presidente Castelo Branco; Avenida Francisco Sá; Av. Monsenhor Hélio Campos
Feiras: Feira do Carlito Pamplona (segunda-feira)/
74 NOSSOS BAIRROS | NOSSA FORTALEZA
Igreja do Cristo Redentor foi criada em 1969 e é um dos marcos do bairro
THAIS MESQUITA
Rua Irineu de Sousa, bairro Cristo Redentor
Ecopontos:
Cristo Redentor - Avenida Presidente Castelo Branco (Leste-Oeste), em frente ao nº 3833
Vila do Mar II - Rua Francisco Calaça, esquina com a Rua Santa Elisa – Cristo Redentor
IDH: 0,254
ATIVIDADE SOCIAL
Movimento Emaus Amor e Justiça; Associação Crer; CCDH - Centro de Cidadania e Direitos Humanos - Gov. Virgílio Tavora; Complexo Mais Infância Cristo Redentor; Associação Anjos de Deus; Associação Crer; Salão das Pastorais Sociais do Cristo Redentor; Conselho Comunitário Arpoador; Casa do Acolher - Comunidade Hóstia Santa.
IGREJAS
RELIGIÃO: Paróquia Cristo Redentor (Rua Nossa Senhora das Graças, 1430);
PARÓQUIA DO CRISTO REDENTOR
A Paróquia Cristo Redentor foi criada em 25 de janeiro de 1969, dia da Conversão de São Paulo, por Dom José de Medeiros Delgado, Arcebispo da Arquidiocese de Fortaleza, no território do Pirambu, Nossa Senhora das Graças, compreendendo as comunidades de Japão, Arpoadores, Casas Novas e João XXIII.
A Igreja Matriz ficou na comunidade do Japão. No início a matriz provisória funcionava no Ginásio Monsenhor Hélio Campos e, em fevereiro de 1972, teve início a campanha para erguer a Igreja Matriz, que foi construída no período de 1972 a 1974. Com o crescimento da Paróquia foram criadas mais três comunidades: Vila Santo Antônio, Colônia e Jardim Petrópolis.
SAÚDE
UPAs: UPA Cristo Redentor - Av. Presidente Castelo Branco com a Rua Alves de Lima
PRAÇAS
Praça Alves de Lima; Carlinhos Santana; ; Coronel Melquíades; Cura D’ars (Santa Elisa); Lagoa do Mel (Praça Luiza França); Major Wilson; Nossa Senhora da Conceição; Odete Saraiva; Santa Elisa; Tomás Gonzaga
EDUCAÇÃO
Escolas: Aldeídes Régis; Antônio Mendes; Cristo Redentor; Virgílio Távora; Santa Tereza; São Cura D’ars; Sebastiana Aldigueri
SEGURANÇA
AIS: 8
TRANSPORTE PÚBLICO
Cuca Barra/Papicu; Corujão/Av. Paranjana I; Corujão/ Av. Paranjana II; Antônio Bezerra/Francisco Sá/Papicu; Grande Circular I; Grande Circular II; Corujão/Grande Circular I; Corujão/Grande Circular II; Corujão/Jardim Iracema; Cuca Barra/Parangaba; Francisco Sá/Parangaba; Antônio Bezerra/Papicu/Praia de Iracema; Beira Rio/Centro; Vila Santo Antônio/Nossa Senhora Graças/ Centro; Floresta/Centro; Vila do Mar/Centro; Jardim Iracema; Cj Nova Assunção/Francisco Sá; Jardim Guanabara/Centro; Vila do Mar/Náutico/Antônio Bezerra I; Av. Leste Oeste/Centro; Barra do Ceará/Antônio Bezerra; Barra do Ceará/Cais do Porto; Granja Lisboa/Goiabeiras
ÁREA EDIFICADA (M2)
Inscrições Residenciais: 4.608
Inscrições Comerciais: 628

Inscrições de Prestação de Serviços: 8
Inscrições Industriais: 13
Assentamentos precários: Conjunto habitacional; Conjunto Alves de Lima/ Costa oeste; Seis Companheiros/ Costa Oeste
Favela: Rua Dona Mendinha II; Rua Francisco Calaça; Colônia Lagoa do mel; Alves de Lima; Santa Inês/Pirambu; Quatro varas; Comunidade Arpoador; Santa Elisa/ Pirambu
75 REGIONAL 1
FLORESTA
Apesar de muitas vezes ter seu território confundido com o vizinho Álvaro Weyne, o Floresta é um bairro reconhecido oficialmente.
Segundo relatos históricos, o bairro surgiu por meio de ocupações e, hoje, tem seus limites já definidos pelas ruas José Acioly, Rocha Pombo, Dona Mendinha,Teodomiro de Castro, Francisco Calaça e avenida Francisco Sá.
Outras que também são conhecidas no bairro são as ruas: Tulipa, Teodomiro de Castro, Alberto de Oliveira, Conselheiro Lafayette e Rio Tocantins.
Hoje, o local é repleto de praças, como a Praça Carnaubal, a Praça Chico da Silva, Praça de Jesus e a Praça dos Estressados, entre outras. O local também abriga o Polo de Lazer Álvaro Weyne e a Lagoa do Urubu, além da Areninha Lagoa do Urubu.
DADOS GERAIS
Localização
Regional: SR 1
Território: 6
Bairros limítrofes: Barra do Ceará; Jardim Iracema; Cristo Redentor; Álvaro Weyne; Padre Andrade; Presidente Kennedy
População estimada: 28.896
População Feminina: 15.219
População Masculina: 13.677
Densidade (hab/km²): 16.848,98
Área (km²): 1,72

Perímetro (km): 6.485,31
Avenidas principais: Avenida Francisco Sá
Feiras livres: Feira do Conjunto Polar (terça-feira)/ Rua Menezes de Oliveira
Ecopontos: Floresta- Rua General Mário Hermes, esquina com a Rua Adolfo Bezerra de Menezes
Lagoa do Urubu I - Rua Maria Souza, esquina com a
Rua Valmir
IDH: 0,224
ESPORTE
Areninhas: Areninha Lagoa do Urubu
ARENINHA LAGOA DO URUBU
Para urbanizar e requalificar os campos de futebol da Cidade, o projeto Areninhas tem proporcionado uma nova estrutura aos locais, especialmente em bairros que ofereçam alto índice de vulnerabilidade social.
Em 2020, foi a vez do Floresta receber o novo equipamento esportivo para que a comunidade possa ter um espaço seguro de convivência e lazer para a prática esportiva.
ATIVIDADE SOCIAL
Projeto Criança Feliz; Projeto Só Risos;
PRAÇAS
Polo de Lazer Álvaro Weyne; Praça Carnaubal; Praça
Chico da Silva; Praça de Jesus; Praça dos Estressados (Praça dos Estourados); Praça José Valdo Ramos; Praça Lagoa do Urubu; Praça Luciano Candido (Praça do Padre Andrade)
MEIO AMBIENTE
Rios ou lagoas: Lagoa do Urubu
EDUCAÇÃO
Escolas:
Dom Helder Câmara- Rua Frei Odilon, 623
João Marçal Mesquita - Rua Rocha Pombo, S/n
Maria Roseli Lima Mesquita - Rua Luiz Guimarães, 261
76 NOSSOS BAIRROS | NOSSA FORTALEZA
Francisco Silva Cavalcante - Av. Conselheiro Lafayette, 205
Sonho Infantil 2 - Rua Rincão, 79

Nossa Senhora De Fátima - Rua Silvio Romero, 370
CULTURA
Centros culturais: Ass. Cult. e Edu. Afro-Bras. Maracatu Nação Iracema
SEGURANÇA
AIS: 8
TRANSPORTE PÚBLICO
Corujão/Av. Paranjana I; Corujão/Av. Paranjana II; Antônio Bezerra/Francisco Sá/Papicu; Corujão/Jardim Iracema; Parquelândia/Parangaba; Cuca Barra/Parangaba; Francisco Sá/Parangaba; Floresta/Centro; Jardim Iracema; Álvaro Weyne/Centro; Cj Nova Assunção/ Francisco Sá; Jardim Guanabara/Centro; Antônio Bezerra/Álvaro Weyne; Padre Andrade/Antônio Bezerra
ÁREA EDIFICADA (M2)
Inscrições Residenciais: 4.080
Inscrições Comerciais: 480

Inscrições de Prestação de Serviços: 11
Inscrições Industriais: 16
Assentamentos precários: Conjunto habitacional; Floresta II; Santo Antônio da Floresta
Favela: Rua Conselheiro Lafaiete; Vila Santa Inês; Madeira; Solimões; Parque Santo Antônio ( TV. São Tomé); Rua São Bernardo; Santo Amaro; Status/Vila Antônio Rola; Rua Rio Madeira; Pontilândia; Comunidade Lagoa do Urubu/Ocupação Floresta; Coelho Neto; Lutar e Vencer
Mutirão: Conjunto Santa Maria Gorette II; Conjunto Pantanal/ Lingua de Cobra; Novo tempo III; Rua Dona Mendinha I
77 REGIONAL 1
THAIS MESQUITA
Areninha Lagoa do Urubu foi inaugurada em 2020 no Floresta
JACARECANGA
Para acolher famílias ricas da Capital cearense que desejavam se afastar do Centro, o Jacarecanga surgiu na década de 1920, na zona Oeste. Nas imediações do riacho homônimo, concentraram-se sobrados da elite comercial e agrária.
Por mais de duas décadas se destacou como o lugar mais aristocrático da Cidade, com belas arquiteturas nos casarões e bangalôs espalhados pelo seu território, como a casa de três andares de Pedro Sampaio e o palacete Thomaz Pompeu Sobrinho.
A instalação da ferrovia que corta a zona Oeste de Fortaleza, da oficina Rede Viação de Fortaleza e das fábricas no bairro ao longo da avenida Francisco Sá foram mudando o perfil local, assim como a migração agrária do Estado.
Já no início do século, em 1908, a Escola de Aprendizes Marinheiros do Ceará foi transferida para o Jacarecanga, onde o prédio é mantido até hoje. Casas e prédios ocupam as demais áreas do bairro, que oferece feira livre, praças e o Centro Fashion.
DADOS GERAIS
Localização
Regional: SR 1
Território: 5
Bairros limítrofes: Arraial Moura Brasil; Cebtro; Monte Castelo; Carlito Pamplona; Pirambu
População estimada: 14.204
População Feminina: 7.732
População Masculina: 6.472
Densidade (hab/km²): 11.246,24
Área (km²): 1,26

Perímetro (km): 6.468,28
Avenidas principais: Avenida Francisco Sá; Avenida Castelo Branco; Avenida Filomeno Gomes;
Feiras livres: Feira do Conjunto Polar (terça-feira)/
Rua Menezes de Oliveira
Ecopontos: Jacarecanga - Av. José Jatahy, esquina com a Av. Sargento Hermínio
IDH: 0,448
ATIVIDADE SOCIAL
A. A. Grupo Beira Mar - 27; Associação Cultural E Esportiva Do Pirambu E Adjacências
IGREJAS
Paróquia São Francisco de Assis (Av. Filomeno Gomes, 315); Igreja do Bom Pastor (Av. Filomeno Gomes, 110);
SAÚDE
Postos de Saúde: Carlos Ribeiro - Rua Jacinto Matos, 944
PRAÇAS
Praça Carlos Jereissati; Praça Morro do Ouro; Praça São Francisco ; Praça Vila São José
MEIO AMBIENTE
Rios ou lagoas: Riacho Jacarecangua
EDUCAÇÃO
Escolas: Secretário Paulo Petrola; Amadeu Barros Leal
CULTURA
Centros culturais: Escola de Artes e Ofício Thomaz Pompeu Sobrinho (Av. Francisco Sá, 1801).
SEGURANÇA
Bombeiros: COMALP - Corpo de bombeiros militar do Ceará
AIS: 8
78 NOSSOS BAIRROS | NOSSA FORTALEZA
TRANSPORTE PÚBLICO
Circular I/Centro; Circular II/Centro; Cuca Barra/Papicu; Av. Borges de Melo/Papicu I; Av. Borges de Melo/Papicu II; Corujão/Av. Paranjana I; Corujão/Av. Paranjana II; Antônio Bezerra/Francisco Sá/Papicu; Grande Circular I; Grande Circular II; Corujão/Grande Circular I; Corujão/ Grande Circular II; Corujão/Jardim Iracema; Cuca Barra/ Parangaba; Antônio Bezerra/Unifor; Antônio Bezerra/ Papicu/Praia de Iracema; Expresso/Cj Ceará/Papicu; Beira Rio/Centro; Vila Santo Antônio/Nossa Senhora Graças/Centro; Floresta/Centro; Santa Maria/Bairro Ellery/Centro; Vila do Mar/Centro; Jardim Iracema; Álvaro Weyne/Centro; Cj Nova Assunção/Francisco Sá; Jardim Guanabara/Centro; Vila do Mar/Náutico/Antônio Bezerra I; Av. Leste Oeste/Centro; Av. Sargento Hermínio; Barra do Ceará/Cais do Porto; Parque Santa Maria/Centro Fashion; Caça e Pesca/Centro; Cidade 2000/Sargento Hermínio; Granja Lisboa/Goiabeiras
ÁREA EDIFICADA (M2)
Inscrições Residenciais: 4.349
Inscrições Comerciais: 1.052

Inscrições de Prestação de Serviços: 15
Inscrições Industriais: 7
Assentamentos precários:
Favela: Mercado Velho; Morro do Ouro; Comunidade da rua Larga; Santa Elisa/Pirambu; Comunidade do Tirol; Arraial Moura Brasil
Mutirão: Stª Edwirges
CENTRO FASHION
O comércio popular de moda em Fortaleza ganhou um local para reunir milhares de boxes num mesmo espaço, o Centro Fashion. Localizado na Avenida Filomeno Gomes, 430, ele atrai de lojistas a consumidores finais do Ceará e outros estados.
Além das opções de compra para os públicos feminino, masculino, teen e infantil, o local possui caixas eletrônicos e vestiários em todos os andares, acessibilidade com rampas e elevadores, estacionamento e carregadores para ajudar a colocar ou tirar as coisas no carro e, ainda, praça de alimentação e hotel.

79 REGIONAL 1
Centro Fashion é um dos mais famosos pontos de compra e venda de vestuário no Ceará
FERNANDA BARROS
Instituo Perifa é uma ONG que desenvolve projetos e ações culturais no bairro

JARDIM GUANABARA
Localizado na Regional 1, o bairro Jardim Guanabara possui uma população estimada de quase 15 mil habitantes. Ele faz divisa com os bairros Jardim Iracema, Vila Velha e Floresta, da mesma regional, e com o Quintino Cunha, que pertence à Regional 3.
DADOS GERAIS
Localização
Regional: SR 1
Território: 2
Bairros limítrofes: Jardim Iracema; Vila Velha; Floresta, Quintino Cunha
População estimada: 14.919
População Feminina: 7.982

População Masculina: 6.937
Densidade (hab/km²): 20.325,61
Área (km²): 0,73
Perímetro (km): 3.636,24
Avenidas principais: Avenida Major Assis; Avenida Coronel Carvalho; Avenida Major Assis; Av. Hildebrando de Melo; Avenida da Independência.
IDH: 0,325
80 NOSSOS BAIRROS | NOSSA FORTALEZA
THAIS MESQUITA
ATIVIDADE SOCIAL
Conselho Comunitário Jardim Guanabara; Associação Cristã Céus Abertos;A. A. Grupo Criança Carente - 27; Instituto Perifa.
INSTITUTO PERIFA
Criado em 1987, o Instituto Perifa de Arte, Cultura e Cidadania do Ceará (IPAC-CE) é uma organização da sociedade civil sem fins lucrativos (ONG) com atuação no bairro Jardim Guanabara e adjacências.
Ele é responsável por desenvolver projetos e ações na área da cultura, assistência social e educação para mulheres vítimas de violência; crianças, adolescentes e jovens em situação de vulnerabilidade social; idosos e toda a comunidade.

IGREJA
Paróquia São Pedro e São Paulo (Rua Padre Teodoro, 996)
PRAÇA
Praça da Rua Palmácia
EDUCAÇÃO
Escolas: Professor José Rebouças Macambira - Rua Cariús, 200
Lorhan Marques Medeiros - Rua Creuza Rocha, 255
Manoel Rodrigues - Rua Maria Clara, 1237
Professor José Parsifal Barroso - Rua Major Assis, 1076
Professor José Rebouças Macambira - Rua Cidade De Cariús, 200
Quintino Cunha - Rua Maria Clara, 1263
SEGURANÇA
AIS: 8
TRANSPORTE PÚBLICO
Corujão/Av. Paranjana I; Corujão/Av. Paranjana II; Antônio Bezerra/Francisco Sá/Papicu; Grande Circular I; Grande Circular II; Corujão/Grande Circular I; Corujão/ Grande Circular II; Corujão/Jardim Iracema; Corujão/ Jardim Guanabara/N Assunção II; Antônio Bezerra/ Papicu/Praia de Iracema; Jardim Guanabara/Centro; Vila do Mar/Náutico/Antônio Bezerra I; Antônio Bezerra/Álvaro Weyne; Quintino Cunha/Antônio Bezerra; Jardim Guanabara/Cj Nova Assunção I; Jardim Guanabara/Cj Nova Assunção II; Barra do Ceará/Antônio Bezerra; Barra do Ceará/Cais do Porto
ÁREA EDIFICADA (M2)
Inscrições Residenciais: 3.039
Inscrições Comerciais: 541

Inscrições de Prestação de Serviços: 21
Inscrições Industriais: 3
Assentamentos precários: -
81 REGIONAL 1
JARDIM IRACEMA
Com 64 anos de criação, o bairro Jardim Iracema fica na região Oeste da Cidade. O território faz divisa apenas com outros bairros da sua regional: Barra do Ceará, Vila Velha, Jardim Guanabara e Floresta.

Com cerca de 23 mil habitantes, o bairro abriga a Areninha com nome homônimo, que serve de ponto de lazer para a comunidade local, e a Feira da Major Assis que ocorre às terças-feiras.
Na parte cultural o bairro dispõe do funcionamento de três bibliotecas: Biblioteca Comunitária Mundo Jovem; Biblioteca Comunitária Criança Feliz; e Biblioteca Comunitária Jardim Literário.
DADOS GERAIS
Regional: SR 1
Território: 5
Bairros limítrofes: Barra do Ceará; Vila Velha; Jardim Guanabara; Floresta
População estimada: 23.184
População Feminina: 12.216
População Masculina: 10.968
Densidade (hab/km²): 21.019,04

82 NOSSOS BAIRROS | NOSSA FORTALEZA
Paróquia Santo Antônio de Pádua foi estabelecida por meio de decreto assinado por Dom José Antônio Tosi Marques
FERNANDA BARROS
Área (km²): 1,10
Perímetro (km): 5.177,53
Avenidas principais: Avenida Coronel Carvalho; Avenida Major Assis; Avenida Tenente Lisboa
Feiras livres: Feira da Major Assis (terça-feira)/ Avenida Major Assis, bairro Jardim Iracema
Ecopontos: Vila Velha (Rua Jasmim, 0 - Por trás do Liceu Vila Velha)
IDH: 0,290
ESPORTE
Areninhas: Areninha do bairro Jardim Iracema
ATIVIDADE SOCIAL
União Dos Moradores Do Jardim Iracema- Umjir;
IGREJAS
Paróquia Santo Antônio de Pádua (Rua Alberto Ferreira, 230); Igreja de Nossa Senhora de Fátima (Av. Ten. Lisboa, 980);
Paróquia Santo Antônio de Pádua
É um desmembramento da Paróquia de São Pedro e São Paulo do Bairro Quintino Cunha para atender a comunidade que se encontra no perímetro entre outras igrejas dos bairros vizinhos. Seu decreto é o Nº 008/2002, assinado por Dom José Antônio Aparecido Tosi Marques.
SAÚDE
Postos de Saúde: Airton Monte - Rua Alberto Oliveira, s/n
Fernando Façanha - Rua Rio Tocantins, s/n
EDUCAÇÃO
Escolas: 11 De Agosto - Av. Coronel Carvalho, 3121
Jesus Cristo - Rua Alberto Ferreira, 564
José De Alencar - Rua Alberto Ferreira, 248
Maria Dalva Severino Marreiro - Rua Rio Paraguai, 782
Raimundo De Sousa Mangueira - Rua Alberto Ferreira, 624
Construindo O Futuro - Rua Otávio Paranhos, 35
CULTURA
Bibliotecas: Biblioteca Comunitária Mundo Jovem; Biblioteca Comunitária Criança Feliz; Biblioteca Comunitária Jardim Literário;

Centros culturais: Luciano Nunes Dance Company
SEGURANÇA
Delegacias: 20° Batalhão da Polícia Militar do Ceará (20°BPM/PMCE)
AIS: 8
TRANSPORTE PÚBLICO
Corujão/Av. Paranjana I; Corujão/Av. Paranjana II; Antônio Bezerra/Francisco Sá/Papicu; Grande Circular I; Grande Circular II; Corujão/Grande Circular I; Corujão/Grande Circular II; Corujão/Jardim Iracema; Corujão/Jardim Guanabara/N Assunção II; Parquelândia/Parangaba; Antônio Bezerra/Papicu/Praia de Iracema; Jardim Iracema; Álvaro Weyne/Centro; Jardim Guanabara/Centro; Vila do Mar/ Náutico/Antônio Bezerra I; Antônio Bezerra/Álvaro Weyne; Quintino Cunha/Antônio Bezerra; Vila Velha/Antônio Bezerra; Jardim Guanabara/Cj Nova Assunção I; Jardim Guanabara/Cj Nova Assunção II; Barra do Ceará/Antônio Bezerra; Barra do Ceará/Cais do Porto
ÁREA EDIFICADA (M2)
Inscrições Residenciais: 4.777
Inscrições Comerciais: 759
Inscrições de Prestação de Serviços: 36
Inscrições Industriais: 4
Assentamentos precários:
Favela: Rua Jandira; Do Corrente (Riacho da Soja); Vila São José; Santo Amaro; Rua Rosinha Sampaio; Rua Guilherme Mendes; Av. Coronel Cori; Lutar e Vencer
Mutirão: UMJIR/José Maria Vasconcelos
83 REGIONAL 1
PIRAMBU
O território do Pirambu começou a ser ocupado a partir de migrações causadas pela seca, na década de 1930, o que colocou o bairro entre um dos principais do País a ter favela. Na época era conhecido como Campo do Pirambu ou Polo.
O nome vem do peixe comum na área. Na década de 1960, o espaço contava com a ajuda da Igreja Católica e outras entidades para dar mais dignidade à comunidade local. Um grande nome foi o Padre Hélio Campos. Com a ajuda dele, aconteceu em 1º de janeiro de 1962, a Marcha do Pirambu, para reivindicar a desapropriação das terras obtidas com o Decreto Lei nº1058 de 25 de maio de 1962. O encontro reuniu 20 mil pessoas no seu percurso até o Centro.
As terras passaram a pertencer à União e a igreja administrava, porém os moradores entraram em conflito e Padre Hélio Campos foi transferido para o Maranhão.
Assim, o Grande Pirambu foi dividido após a construção de duas paróquias, originando dois novos bairros com seus respectivos nomes, a paróquia da Nossa Senhora das Graças e a do Cristo Redentor.
Em 1973, após a construção da avenida Presidente Humberto de Alencar Castello Branco (Leste-Oeste), o Pirambu recebeu nova delimitação, sendo seu território somente a parte do lado do mar. Neste período a praia da Leste-Oeste se tornou um lazer popular.
DADOS GERAIS
Localização
Regional: SR 1
Território: 4
Bairros limítrofes: Cristo Redentor; Álvaro Weyne; Carlito Pamplona; Jacarecanga
População estimada: 17.775
População Feminina: 9.345
População Masculina: 8.430
Densidade (hab/km²): 31.349,21
Área (km²): 0,57

Perímetro (km): 4.618,41
Avenidas principais: Avenida Castelo Braco; Avenida Leste e Oeste; Avenida Pasteur; Avenida Dr. Theberge
Feiras livres: Feira do Conjunto Polar (terça-feira)/ Rua Menezes de Oliveira
Ecopontos: Pirambu I - Rua Costa Matos, esquina com Rua Jacinto de Matos (ao lado do Posto de Saúde Guiomar Arruda)
Pirambu II - Rua Santa Rosa, esquina com Rua Nossa Senhora das Graças
IDH: 0,230
ESPORTES
Areninhas: Areninha Pirambu
ATIVIDADE SOCIAL
Associação Santo Antônio Casa da Vovó Marieta; FEMOCOPI - LIGA ESPORTIVA DO PIRAMBU; Associação Comunitária de Ajuda Mútua do Pirambu; Projeto Pirambu Junior; Instituto Cai Cai Balão; Casa de Vovó Dedé
CASA DE VOVÓ DEDÉ
Fundada em 1993, a Escola de Artes Casa de Vovó Dedé é uma entidade civil sem fins lucrativos, criada por Mansueto Barbosa e que atua a partir do princípio de que a arte é instrumento de afetividade, pertencimento e mudança social. Atualmente é gerida por Wagner Barbosa, que segue o legado do pai.
Localizada na Rua Jerônimo de Albuquerque, 445, o espaço atende cerca de 1.400 pessoas, entre 6 e 29 anos. Desde 2012 passou a ter curso profissionalizante técnico de audiovisual.
IGREJA
Paróquia Nossa Senhora das Graças
84 NOSSOS BAIRROS | NOSSA FORTALEZA
SAÚDE
Postos de Saúde: Guiomar Arruda - Rua Gal Costa Matos, 06
PRAÇAS
Praça Capitão Mor; Praça do Abel; Praça Gpm
CULTURA
Centros culturais: Espaço Cultural Grapel; Centro Cultural Chico da Silva
SEGURANÇA
Delegacias: Delegacia de Polícia Civil | 7º Distrito Policial;
AIS: 8
TRANSPORTE PÚBLICO
Cuca Barra/Papicu; Grande Circular I; Grande Circular II; Corujão/Grande Circular I; Corujão/Grande Circular II;
Corujão/Jardim Iracema; Antônio Bezerra/Papicu/Praia de Iracema; Beira Rio/Centro; Vila Santo Antônio/Nossa Senhora Graças/Centro; Vila do Mar/Centro; Vila do Mar/ Náutico/Antônio Bezerra I; Av. Leste Oeste/Centro; Barra do Ceará/Cais do Porto; Granja Lisboa/Goiabeiras
ÁREA EDIFICADA (M2)
Inscrições Residenciais: 3.343
Inscrições Comerciais: 337

Inscrições de Prestação de Serviços: 7
Inscrições Industriais: 0
Assentamentos precários:
Conjunto Habitacional; Conjunto Terra da União
Favela: Comunidade Areia Grossa; Olavo Andrade; Comunidade Beco do Biscoito; Comunidade Álvaro de Alencar; Comunidade Rio Nilo; Santa Elisa/Pirambu; Comunidade Cacimba dos Pombos; Comunidade do Tiro

85 REGIONAL 1
AURÉLIO ALVES
Casa de Vovó Dedé oferece de forma gratuita a crianças e jovens da periferia atividades artísticas e culturais
VILA VELHA
Localizado na parte Oeste da Capital cearense, o bairro Vila Velha está na margem do Rio Ceará. Quatro conjuntos habitacionais, Vila Velha I, II, III e IV, formam algumas comunidades do bairro.
Como equipamentos, possui a Areninha que leva o nome do bairro, a Feira do Conjunto Polar e muitas praças como a Canal da Palmácia, do Contorno, do Liceu, Nova Lisboa, entre outras.
DADOS GERAIS
Localização
Regional: SR 1
Território: 2
Bairros limítrofes: Barra do Ceará; Jardim Iracema; Jardim Guanabara; Quintino Cunha
População estimada: 61.617
População Feminina: 32.509
População Masculina: 29.108
Densidade (hab/km²): 8.618,97
Área (km²): 7,15

Perímetro (km): 12.420,77
Avenidas principais: Av. Mozart Pinheiro de Lucena; Avenida L; Av. Major Assis; Avenida J; Avenida Ambientalita Ary Thiers; Avenida José Moreira Rebouças.
Feiras livres: Feira do Conjunto Polar (terça-feira)/ Rua Menezes de Oliveira.
Ecopontos: Vila Velha - Rua Jasmim, 0; Vila Velha IIAvenida Major Assis, esquina com a Rua Santa Cecília
IDH: 0,272
ESPORTES
Areninhas: Areninha Vila Velha

86 NOSSOS BAIRROS | NOSSA FORTALEZA
Praça do Polar tem equipamentos de atividade física para toda a comunidade
THAIS MESQUITA
ATIVIDADE SOCIAL
ONG Consciência e Cidadania; CIS Vilha Velha; Movimento Emaús Vila Velha.
IGREJA
Área Pastoral São Francisco de Assis; Santuário Nossa Senhora da Assunção
SAÚDE
Postos de Saúde: João Madeiros - Av. I, 982
Maria Aparecida - Av. K, 915
Hospitais: Hospital Distrital Gonzaga Mota Barra do Ceará (Gonzaguinha Barra Do Ceará)
UPAs: UPA Vila Velha
PRAÇA
Praça Canal da Palmácia; Praça da Av. L Prox UPA; Praça do Contorno; Praça do Liceu; Praça dos Bancários (Beira-Rio); Herondina Cavalcante; Major Assis; Menezes de Serpa; Praça Nova Lisboa; Nsa. Sra. da Assunção; Praça Tancredo Neves; Vila Nova; Valdir Campos Vasconcelos (Praça Polar); Vila Velh; Nossa Sra da Assunção; Praça Polar na Avenida Mozart Lucena
MEIO AMBIENTE
Rios ou lagoas: Rio Ceará
EDUCAÇÃO
Escolas: Antônio Correia Lima; Castelo De Castro; Maria Mariza Mendes De Carvalho; Mário Quintana; Maristela Da Frota Cavalcante; Francisco Edilson Pinheiro; Herondina Lima Cavalcante; Maria Mariza Mendes De Carvalho; Olhar Do Saber - Vó Francy; Deputado
Roberto Mesquita
SEGURANÇA
Delegacias: Delegacia de Polícia Civil | 17° Distrito
Policial
Juizados: 15ª Unidade do Juizado Especial Cível e Criminal
AIS: 8
TRANSPORTE PÚBLICO
Ciclofaixa
Ônibus: Cuca Barra/Papicu; Corujão/Av. Paranjana I; Corujão/Av. Paranjana II; Antônio Bezerra/Francisco
Sá/Papicu; Grande Circular I; Grande Circular II; Corujão/Grande Circular I; Corujão/Grande Circular II; Corujão/Jardim Guanabara/N Assunção II; Parquelândia/Parangaba; Cuca Barra/Parangaba; Francisco Sá/Parangaba; Antônio Bezerra/Papicu/Praia de Iracema; Beira Rio/Centro; Cj Nova Assunção/Francisco Sá; Jardim Guanabara/Centro; Vila do Mar/ Náutico/Antônio Bezerra I; Antônio Bezerra/Álvaro Weyne; Quintino Cunha/Antônio Bezerra; Vila Velha/ Antônio Bezerra; Jardim Guanabara/Cj Nova Assunção I; Jardim Guanabara/Cj Nova Assunção II; Barra do Ceará/Antônio Bezerra; Barra do Ceará/Cais do Porto; Vila Velha/Centro
ÁREA EDIFICADA (M2)
Inscrições Residenciais: 8.068
Inscrições Comerciais: 1.628

Inscrições de Prestação de Serviços: 41
Inscrições Industriais: 6
Assentamentos precários:
Conjunto habitacional
Conjunto Ilha Dourada
Favela
Ilha Dourada; Inferninho/ Vila Nova; Ilha Dourada; Ocupação Vila Velha II; Vila Velha IV; Dos Canteiros; Rua Ministro Antônio Coelho; Comunidade Vila Velha
Mutirão
Cacimba dos Pontos/ Costa Oeste; Desabrigados de Língua de Cobra; Rua Beta; Rua K; Rua São Braz; Vila Velha I, II e III/ Conjunto Alamed
87 REGIONAL 1
REGIONAL 2






Equipamentos turísticos como o Mirante do Vicente Pinzón, shoppings, restaurantes, lojas e até patrimônio tombado. Na
Regional 2 estão os bairros considerados mais nobres da Cidade (Meireles, Aldeota e Papicu) e também o Titanzinho, ponto de encontros dos surfistas de Fortaleza


























 Antigo Farol do Mucuripe no Cais do Porto
Antigo Farol do Mucuripe no Cais do Porto































GUIA DA REGIONAL 2
Avenida Beira Mar, no Meireles, é um dos principais cartões postais da Cidade

BAIRROS
Aldeota
Cais do Porto
De Lourdes
Dionísio Torres
Joaquim Távora
Meireles
Mucuripe

Papicu
São João do Tauape
Varjota
Vicente Pinzon
90 NOSSOS BAIRROS | NOSSA FORTALEZA
FCO FONTENELE
SECRETARIA REGIONAL 2
Endereço: Rua Tavares Coutinho, 2225 - Varjota, Fortaleza - CE, 60160-130
Telefone: (85) 3241-4802
Secretário: Rennys Frota
E-mail: rennys.frota@sr2.fortaleza.ce.gov.br
Rennys Frota é advogado, graduado pela Universidade de Fortaleza (Unifor), e tem pós-graduação, também pela Unifor, em Gerenciamento de Projetos.
Foi secretário da Regional I de Fortaleza, diretor de Gestão Corporativa e de Inovação da Financiadora de Estudos e Projetos (FINEP), empresa vinculada ao Ministério da Ciência, Tecnologia e Inovação. Assumiu a presidência da Empresa de Transporte Urbano de Fortaleza (Etufor) e foi assessor especial da Vice Governadoria do Estado do Ceará.

Rennys foi secretário executivo da Secretaria de Saúde do Estado do Ceará (Sesa), titular da Secretaria de Recursos Hídricos do Estado do Ceará (SRH), presidente da Companhia de Gestão dos Recursos Hídricos (Cogerh) e diretor de Desenvolvimento Tecnológico e Produção do Departamento Nacional de Obras Contra as Secas (Dnocs).
GABINETE DO SECRETÁRIO
Telefone: (85) 3241.4755
ACOLHIMENTO
Informações e solicitações de serviços realizados pela Regional 2
Telefone: (85) 3241.4839
E-mail: centraldeacolhimentoregional2@gmail.com
OUVIDORIA
Telefone:
E-mail: raylson.rodrigues@sr2.fortaleza.ce.gov.br

ASSISTÊNCIA SOCIAL
Informações e solicitações de cadastro único e encaminhamentos
Telefone: (85) 3278.5595
CONSERVAÇÃO E SERVIÇOS PÚBLICOS
Informações e solicitações de limpeza pública, requalificação de pontos de lixo, pavimentação, tapa buraco, galerias e bocas de lobo
Telefone: (85) 3241.4755
E-mail: conservacaoregional@gmail.com
ORDENAMENTO E TERRITÓRIO
Informações e cadastramento de vendedores ambulantes, ordenamento de feiras e espaços públicos
Telefone: (85) 9 8970.2069 (celular)
E-mail: coterregional2@gmail.com
COORDENADORIA DE INFRAESTRUTURA
Informações sobre obras de reforma e manutenção de praças e espaços públicos
Telefone: (85) 3241.4755
E-mail: guto.azevedo@sr2.fortaleza.de.gov.br
VIGILÂNCIA SANITÁRIA
Telefone: (85) 3241-4764
E-mail: gerefis2@agefis.fortaleza.ce.gov.br
COORDENADORIA DE SAÚDE
Telefone: (85) 3241-4759
AGEFIS
Telefone: 156 / (85) 3241-4764
E-mail: gerefis2@agefis.fortaleza.ce.gov.br
91 REGIONAL 2
ALDEOTA
Charmoso, dinâmico e pulsante, o bairro Aldeota é um dos mais tradicionais de Fortaleza e tem grande fama dentro e fora do Ceará. Ao lado do Meireles e da Varjota, a Aldeota é conhecida como área nobre.
De acordo com relatos históricos, Aldeota é uma referência à aglomeração de índios saídos das margens do Rio Ceará que se dirigiram para a fonte do Riacho Pajeú. Um marco histórico do bairro é a criação do Colégio Militar de Fortaleza, em 1919.
É difícil imaginar, mas até a década de 1980 o território era estritamente residencial e hoje abriga shoppings como o Aldeota, o Avenida, o Center Um, o Del Paseo e o Jardins Open Mall.
Outros equipamentos que atraem a população são as praças Luíza Távora, que é espaço de aulas de capoeira, a Central de Artesanato do Ceará (CeArt) e a Praça das Flores, que oferece um comércio a céu aberto de plantas e flores.
DADOS GERAIS
Localização
Regional: SR 2
Território: 7

Bairros limítrofes: Meireles, Varjota, Centro, Joaquim Távora, Dionísio Torres, Cocó
População estimada: 42.361
População Feminina: 24.381
População Masculina: 17.980
Densidade (hab/km²): 10.923,41
Área (km²): 3,88
Perímetro (km): 8.836, 36
Avenidas principais: Avenida Barão de Studart, Avenida Antônio Sales, Avenida Desembargador Moreira, Avenida Dom Luis, Avenida Santos Dumont
IDH: 0,867
ATIVIDADE SOCIAL
Grupo Pavilhão da Magnólia;Companhia de Teatro Trupe do Riso;Instituto Mirante de Cultura e Arte; Associação Beneficente Parque do Coco; Instituto Vida Cidadã; Organização das Cooperativas do Est do Ceará-OCEC;Associação Cearense de Terapia Familiar - ACTF;Associação Elos De Vida;Associação de Basquete Cearense - ABC;Acalanto Fortaleza; Cearah periferia; Fundação Projeto Diferente;Movimento em Favor da Vida (Movida);
IGREJAS
Paróquia Cristo Rei; Paróquia Nossa Senhora da Paz
SAÚDE
Postos de Saúde: Miriam Porto Mota (Rua Cel. Jucá, 1636)
Hospitais: Hospital Aldeota; Hospital Estadual Leonardo Da Vinci; Hospital São Raimundo; Hospital Gastroclínica; Hospital de Olhos Leiria de Andrade; Hospital Prontocardio
PRAÇAS
Dr. Carlos Alberto Studart Gomes; Gin. Paulo Sarasate; Praça Luiza Távora (Estado); Marechal Rondon; Maria Tomásia; Praça Medianeira;
Praça Portugal - Inaugurada em 6 de abril de 1968, é conhecida por todos em Fortaleza. O espaço que recebe o cruzamento da Avenida Dom Luis e da Avenida Desembargador Moreira é passagem para territórios vizinhos.
Atualmente, é rodeada por shoppings, como o Aldeota, o Avenida e o Jardins Open Mall, restaurantes e prédios. Serve de palco para manifestações, feiras e atividades de lazer. O nome é uma homenagem aos colonizadores do Brasil.
EDUCAÇÃO
Escolas: José Dias Macêdo (Rua Jaguaribe, 77); São Vicente De Paulo (Trav. Do Rosário, 24); Colégio Militar de
92 NOSSOS BAIRROS | NOSSA FORTALEZA
Fortaleza (CMF) (Av. Santos Dumont, 485)

CULTURA
Cinemas: Arcoplex Del paseo
Teatros: Teatro Arena Aldeota
Centros culturais: Espaço Cultural Prof Itamar Filgueiras
PATRIMÔNIO HISTÓRICO
Igreja do Cristo Rei (Rua Nogueira Acioli, 805)
SEGURANÇA
Delegacias: Delegacia Ministério da Fazenda
Delegacia de Administração do Ministério da Fazenda no Ceará
7ª Delegacia do Serviço Militar da 25ª C S M
Juizados:
Tribunal de Justiça
Justiça Federal no Ceará
Fórum das Turmas Recursais Dolor Barreira
AIS: 1
TRANSPORTE PÚBLICO
Antônio Bezerra/Papicu; Parangaba/Papicu; Antônio Bezerra/Francisco Sá/Papicu; Bezerra De Menezes/ Santos Dumont; Expresso/Parangaba/Papicu; Santos Dumont/Perimetral
Ciclofaixa
Ciclovia
Estação Bicicletar Unimed
Estação Vamo
ÁREA EDIFICADA (M2)
Inscrições Residenciais: 18.167
Inscrições Comerciais: 16.852
Inscrições de Prestação de Serviços: 2.124
Inscrições Industriais: 6

Assentamentos precários:
Favela: Favela do Trilho; Campo do américa; Favela do Trilho ou Trecho São Vicente de Paula; Comunidade do Trilho; Quadras; Mutirão; Conjunto Santa Cecília
93 REGIONAL 2
AURÉLIO ALVES
A Praça Portugal é uma das mais emblemáticas do bairro Aldeota
CAIS DO PORTO
Localizado em um dos extremos da Cidade, entre o Norte e o Leste, o bairro Cais do Porto, também conhecido como Serviluz, é rodeado pelo mar.
O território teve início na década de 1940 com a mudança de pescadores e estivadores que moravam na Praia Mansa e tiveram que deixar o local para construção do Porto do Mucuripe. Está situado entre a Beira Mar e a Praia do Futuro.
O apelido Serviluz surgiu dez anos mais tarde pela instalação da Companhia de Serviço de Força e Luz de Fortaleza (Serviluz) na década de 1950. Pela vocação náutica atrai muitas pessoas, desde turistas a fortalezenses, especialmente da comunidade local Titanzinho. De lá, já saíram grandes nomes do surf cearense, como Tita Tavares e Fábio Silva.
Outro atrativo é o patrimônio histórico do Farol do Mucuripe, que está estampado no Brasão do Ceará e é cantado pelos cearenses Ednardo e Belchior. Há registros de que o farol é a segunda construção mais antiga da Cidade.
Com estrutura de alvenaria, madeira e ferro, sua construção é datada do período entre 1840 e 1846. Na época, seu aspecto físico e relevância econômica chamavam atenção, e o local era referência para embarcações que aportavam em Fortaleza. Foi desativado em 1957.
Além de fazer parte da história e da memória da Cidade, o espaço é uma opção de lazer para crianças e adolescentes que vão ao local. Na rua eles brincam e jogam bola, jovens dançam e demais moradores observam o mar.
DADOS GERAIS
Localização
Regional: SR 2
Território: 9

Bairros limítrofes: Mucuripe e Vicente Pinzon
População Masculina: 10.867
Densidade (hab/km²): 8.186,54
Área (km²): 2,73
Perímetro (km): 13.258,21
Avenidas principais: Av. Zezé Diogo; Av. José Saboia, Av César Cals, Av. Vicente de Castro; Avenida Leite Barbosa
Feiras livres: Feira do Cais do Porto (Rua Eliezér Levi)
Funcionamento - Terça-Feira
IDH: 0,224
ATIVIDADE SOCIAL
Centro comunitário Dona Luiza Távora, farol; União de Jovens do Vicente Pinzón; Instituto Metamorfose; CEU Escola de Gastronomia Social Ivens Dias Branco
SAÚDE
Postos de Saúde: Célio Brasil Girão (Rua Henrique Firmeza, 82); Odorico de Morais (Rua Esperantina, s/n)
PRAÇAS
Pracinha das Docas, Praça Amigos da Marinha - Rua H - Avenida Vicente De Castro; Praça Castelo EncantadoRua Francisco Alves Pereira e Rua 7 De Abril; Praça Morro Santa Terezinha - Av. Vicente De Castro; Praça São Francisco - Avenida Zezé Diogo e Rua Ernesto Gurgel
EDUCAÇÃO
Escolas: Eleazar De Carvalho; Godofredo De Castro
Filho ; Maria Felício Lopes; São Vicente De Paulo; Professor Álvaro Costa
PATRIMÔNIO HISTÓRICO
População estimada: 22.382
População Feminina: 11.515
Farol do Mucuripe (Av. Vicente de Castro, S/N)
94 NOSSOS BAIRROS | NOSSA FORTALEZA
SEGURANÇA
Uniseg 1 (Av. Zezé Diogo, 162)
Defensoria Pública (Av. Vicente de Castro, s/n ); Defensoria Pública - Núcleo Mucuripe (Av. Vicente de Castro, 5740)
Bombeiros: Corpo de Bombeiros Militar do Ceará (Av. Vicente de Castro, 1473); Posto Do Corpo De Bombeiros (Av. José Sabóia, 102-310)
AIS: 1
TRANSPORTE PÚBLICO
711-Barra do Ceará/Cais do Porto
Ciclovia
Ciclofaixa
Estação de Metrô / Superfície Bairro: Cais do Porto/
Linha: VLT: Iate Avenida Vicente de Castro, 80
ÁREA EDIFICADA (M2)
Inscrições Residenciais: 2.800
Inscrições Comerciais: 695
Inscrições de Prestação de Serviços: 16
Inscrições Industriais: 11

Assentamentos precários: Conjunto habitacional; Santa Terezinha; Favela; Travessa Dioguinho; Delmar; Morro do Teixeira; Comunidade Serviluz/Titanzinho; Comunidade Aristide Barcelos; Morro da Vitória/ Farol Novo; Morro do Mirante; Ipecea/Estivas; Casa do Samba
Mutirão: Castelo Encantado
SURFISTAS NO TITANZINHO
A comunidade Titanzinho é o destino certo para os surfistas, pois tem ondas o ano todo. Existe no local um paredão no porto e um espigão que fazem a junção de ondas frequentes.
A região também é conhecida por abrigar escolinhas de surf para crianças e adultos. Moradores locais mais antigos revelam que o nome da comunidade surgiu das máquinas que trabalhavam na construção do paredão no Porto do Mucuripe, chamadas Titan.

95 REGIONAL 2
FCO FONTENELE
A história do Titanzinho é entrelaçada a de grandes nomes do surf cearense, como Tita Tavares e Fábio Silva
DE LOURDES
Dentre os bairros da Regional 2, está uma área conhecida por De Lourdes que abriga pouco mais de 3,3 mil residentes. Vizinho dos bairros Dunas e Manuel Dias Branco, ele passa despercebido por muitos fortalezenses que o consideram pertencentes a esses locais mais próximos.
O local, até os anos 2000, era pouco habitado e passou a se expandir demograficamente após a inauguração do marco zero, com a Cruz do Cruzeiro. Até 2005, o território pertencia ao bairro Papicu e à Praia do Futuro, quando tornou-se um bairro por meio da aprovação da lei municipal 8945/05. Assim, passou a ter o nome da paróquia local, Nossa Senhora de Lourdes.
Desde 31 de dezembro de 2020, após o decreto municipal N° 14.899, que criou novas subprefeituras e as subdividiu em territórios, o bairro passou a fazer parte do Território 8 da Regional 2.
Seu posicionamento geográfico nas dunas da Capital e sua altitude oferecem aos visitantes e moradores belíssimas paisagens tanto do mar, nas proximidades da Praia do Futuro, quanto da Cidade.

O bairro destaca-se também pela concentração de casas e condomínios de luxo e alto padrão, o que torna o valor do metro quadrado (m²) um dos mais elevados.
DADOS GERAIS
Localização
Regional: SR 2
Território: 8
Bairros limítrofes: Papicu, Vicente Pinzón, Praia do Futuro I, Manoel Dias Branco

96 NOSSOS BAIRROS | NOSSA FORTALEZA
Templo de Fortaleza da Igreja de Jesus Cristo dos Santos dos Últimos Dias
AURÉLIO ALVES
População estimada: 3.370
População Feminina: 1.809
População Masculina: 1.561
Densidade (hab/km²): 2.467,06
Área (km²): 1,37
Perímetro (km): 5.489,09
Avenidas principais: Avenida Padre Joaquim Colaço

Dourado;Avenida Dolor Barreira; Avenida Engenheiro
Luiz Vieira; Avenida Trajano de Medeiros
IDH: 0,642
ATIVIDADE SOCIAL
Associação Comunitária Vila Mar (R. Flávio Marcílio)
IGREJA
Paróquia Nossa Senhora de Lourdes; Igreja de Jesus Cristo dos Santos dos Últimos Dias no Ceará; Templo da Igreja de Jesus Cristo dos Santos dos Últimos dias - O bairro De Lourdes abriga o primeiro templo da Igreja de Jesus Cristo dos Santos dos Últimos Dias no Ceará e o segundo da região Nordeste, localizado na Avenida Santos Dumont, 7771.
O Templo de Fortaleza é o de número 164 em funcionamento no mundo. Ele atende membros das igrejas do Ceará, Piauí, Maranhão, Pará e da região de Mossoró, no Rio Grande do Norte.
Os visitantes podem observar que seus vitrais iluminam a parte interna da igreja, o que proporciona uma aparência de cálida luz natural ao longo do dia.
PRAÇAS
Mirante da Cruz; Praça Estrigas e Nice; Praça de Lourdes; Praça de Lourdes I; Praça de Lourdes
SEGURANÇA
AIS: 10
TRANSPORTE PÚBLICO
Ônibus: Vila do Mar/ Centro; Guajeru I; Praia do Futuro/Papicu; Cidade 2000/Centro; HGF/Papicu/Riomar; Conj Palmeiras/Papicu; Santos Dumont/Perimetral; Cidade 2000/Sargento Hermínio; Parangaba/Papicu/ Aeroporto; Bezerra de Menezes/Santos Dumont; Siqueira/Papicu/Washington Soares; Messejana/Papicu/Washington Soares;Corujão/Grande Circular I; Meireles/Centro
ÁREA EDIFICADA (M2)
Inscrições Residenciais: 2.645
Inscrições Comerciais: 551
Inscrições de Prestação de Serviços: 14
Inscrições Industriais: 10
Assentamentos precários: Favela Luxou

97 REGIONAL 2
DIONÍSIO TORRES
Localizado na zona Norte de Fortaleza, o bairro Dionísio Torres era chamado, no início da sua fundação, de Estância. O ponto em que se encontra é um dos mais altos de Fortaleza.

A história do bairro tem início em 1920 quando o farmacêutico Dionísio Torres comprou as terras onde hoje se encontra o bairro. As terras foram adquiridas dos herdeiros de Gonçalo Baptista Vieira, conhecido como Barão de Aquiraz. Dionísio deu ao local o nome de Estância.
Em 1939, foi criado o Loteamento Terras da Estância Castelo, um empreendimento imobiliário constituído em 58 hectares (ha). Outra ocupação construída foi a Vila Estância, com 60 casas, e a Vila Zoraida, com 48 casas, além de outros prédios residenciais e comerciais.
O farmacêutico Dionísio Torres foi o principal responsável pelo crescimento do bairro Estância que, em parceria com a Prefeitura de Fortaleza, foi crescendo ao longo dos anos.
Dionísio cedeu terreno ao Estado para a construção da caixa d’água de abastecimento do bairro. Além disso, por ser o ponto mais alto de Fortaleza, o bairro foi escolhido para, no final dos anos 1950, ser sede da TV Ceará.
Em 1967, por meio da Lei Municipal nº 3.500, o bairro Estância passou a ser chamado Dionísio Torres, em homenagem ao seu fundador. A sede da Assembleia Legislativa do Estado do Ceará (Alece) está localizada no bairro.
DADOS GERAIS
Localização
Regional: SR2
Território: 10
Bairros limítrofes: Aldeota, São João do Tauape, Cocó e Joaquim Távora

98 NOSSOS BAIRROS | NOSSA FORTALEZA
THAIS MESQUITA
Parque Adahil Barreto foi fundado em 1980 e é hoje opção de lazer de toda população da Capital
População estimada: 15.634
População Feminina: 9.010
População Masculina: 6.624
Densidade (hab/km²): 9.068,45
Área (km²): 1,72
Perímetro (km): 5.759,36
Avenidas Principais: Avenida Antônio Sales, Avenida Pontes Vieira, Avenida Barão de Studart, Avenida Desembargador Moreira e Avenida Senador Virgílio Távora
IDH: 0,860
IGREJAS
Paróquia São Vicente de Paulo; Igreja Batista Manancial; Igreja Bethfagé Comunidade Evangélica; Comunidade
Católica Missionária Um Novo Caminho; Igreja Comunidade das Nações - Fortaleza; Igreja Adventista do Sétimo Dia; Comunidade Católica Face de Cristo
PRAÇA
Praças: Praça da Imprensa
MEIO AMBIENTE
Parque Adahil Barreto - Fundado em 1980 alinhado aos interesses ecológicos de preservação do meio ambiente. Com 10 ha, passou por uma revitalização em 2018 quando deixou de ser gerido pela Prefeitura.
O equipamento foi integrado ao Parque do Cocó em 2018, tornando-se equipamento do Governo do Estado. Com a integração, passou a ser chamado, oficialmente, de Área Adahil Barreto do Parque Estadual do Cocó.
EDUCAÇÃO
Escolas: EEEP Professor Joaquim Antônio Albano (Rua Júlio Siqueira, 390)
CULTURA
Cinemas: Imprensa Cine Drive-In (Imprensa Food
Square - Av. Desembargador Moreira, 2355)
Museus: Museu da Escrita; Memorial da Assembleia Legislativa do Ceará Deputado Pontes Neto
Teatros: Teatro Paurillo Barroso
PATRIMÔNIO HISTÓRICO
Vila Estância Vicentina - tombamento provisório (Av. Nunes Valente, Rua Dom Expedito Lopes; Rua Tibúrcio Cavalcante e Av. Antônio Sales)
SEGURANÇA
Delegacias: 2ª Companhia de Policiamento de Guarda - Assembléia - 2ªCPG (Avenida Desembargador Moreira, S/N)
AIS: 10
TRANSPORTE PÚBLICO
Ônibus: Circular 1/Centro; Corujão/Circular I; Lagoa/ Papicu/Via Expressa; Antônio Bezerra/Unifor; Campus do Pici/Unifor; Antônio Bezerra/Unifor/II; Campus do Pici/Unifor II; Antônio Bezerra/Papicu/Antônio Sales; Antônio Sales/Dionísio Torres/Centro; Paupina/ Pici; Curió/Riomar Kennedy; Circular I/Dom Luiz/IE; 786-Circular I/Abolição/IE; Edson Queiroz/Centro; Bezerra de Menezes/Washington Soares; Parangaba/ Caça e Pesca; Lagoa/Caça e Pesca
Metrô: Estação Antônio Sales (Av. Almirante Henrique Sabóia /Via Expressa com a Av. Antônio Sales) e Estação Pontes Vieira (Av. Almirante Henrique Sabóia (Via Expressa) com R. Vicente Leite)
ÁREA EDIFICADA (M2)
Inscrições Residenciais: 1.061.822,63
Inscrições Comerciais: 496.013,91

Inscrições de Prestação de Serviços: 24.454,60
Inscrições Industriais: 358,53
Assentamentos precários: Favela do Trilho, trecho dom Oscar; Comunidade do Pio XII ou Pau Pelado; Mutirão Conjunto Santa Cecília; e Vila Vicentina
99 REGIONAL 2
JOAQUIM TÁVORA
Fortaleza nem sempre foi recheada de bairros como é hoje. Em meados dos anos 1930, ela estava dividida em sete distritos: Fortaleza, Alto da Balança, Barro Vermelho, Messejana, Mondubim, Parangaba e Pajuçara. O bairro que atualmente conhecemos como Joaquim Távora antes era Piedade.
O novo nome do bairro foi escolhido em homenagem a Joaquim do Nascimento Fernandes Távora, engenheiro e militar, membro de uma família tradicional de políticos e militares do Ceará. Além disso, Joaquim Távora participou de várias revoltas nos anos 1920 contra o governo federal.
No bairro Joaquim Távora, está a Avenida Visconde do Rio Branco, considerada uma das vias mais antigas e que corta outros bairros. No passado, a avenida interligava o centro funcional e o, até então, município de Messejana, que foi rebaixado a distrito de Fortaleza em 1921.
Um dos destaques arquitetônicos do bairro era o Colégio Dorotéias, que possuía uma capela e ficava próximo ao Convento das Carmelitas. A capela, atualmente, foi desativada, e o prédio abriga uma universidade. O bairro é delimitado pelas avenidas Antônio Sales, Pontes Vieira, Barão de Studart e Visconde do Rio Branco.
DADOS GERAIS
Localização
Regional: SR 2
Território: 10

Bairros limítrofes: São João do Tauape, Dionísio Torres e Fátima
População estimada: 23.450
População Feminina: 13.343
População Masculina: 10.107
Densidade (hab/km²): 11.933,84
Área (km²): 1,97
Perímetro (km): 5.815,56
Avenidas Principais: Pontes Vieira, Barão de Studart,
Padre Valdevino e Visconde do Rio Branco
Mercados públicos: Mercado do Joaquim Távora (Avenida Pontes Vieira, entre as ruas Fiscal Vieira e Capitão Gustavo)
IDH: 0,663
ATIVIDADE SOCIAL
Agacc - Associação Grupo de Apoio às Comunidades Carentes Joaquim Távora (Av. Visconde do Rio Branco, 2847)
IGREJAS
Igreja de Nossa Senhora da Piedade; Igreja Batista em Joaquim Távora; Igreja do Nazareno Esperança Fortaleza; Igreja Betesda; Assembleia de Deus Bela Vista; Igreja Batista Renovada Moriá; Igreja Universal; Igreja de São João Batista
EDUCAÇÃO
Escolas: Creche Filippo Smaldone (Rua Adolfo siqueira, 273) e Centro de Atendimento Educacional Especializado Instituto Filippo Smaldone
CULTURA
Teatro: Escola de Atores Marcelino Câmara (R. Soriano Albuquerque, 1107)
Espaços culturais: Mercado do Joaquim Távora (Avenida Pontes Vieira, entre as ruas Fiscal Vieira e Capitão Gustavo)
PATRIMÔNIO HISTÓRICO
Colégio Dorotéias - tombado pelo Município (Av. Visconde do Rio Branco, 2078)
COLÉGIO DOROTÉIAS
Em 1915, o Colégio Dorotéias foi criado para ser uma
100 NOSSOS BAIRROS | NOSSA FORTALEZA
e o prédio foi tombado pelo Conselho de Patrimônio Histórico-Cultural
escola voltada exclusivamente para o público feminino e foi tradicionalmente frequentado pelas moças da classe média. No início, chamava-se Colégio de Nossa Senhora do Sagrado Coração e era dirigido pelas irmãs Dorotéias. Sua estrutura passou por algumas alterações no final da década de 1930, e, em 1980, o padre Gothardo Lemos assumiu a direção da escola.
De 1989 a 1992, o colégio foi arrendado ao grupo Geo Studio, voltando para as irmãs Dorotéias em 1993.
Hoje, o prédio abriga o Centro Universitário Maurício de Nassau (Uninassau). Além disso, faz parte da lista de bens tombados pelo município de Fortaleza.

SEGURANÇA
AIS: 10
TRANSPORTE PÚBLICO
Ônibus: 029 Parangaba / Náutico; 044 Parangaba / Papicu / Montese; 045 Conjunto Ceará / Papicu / Montese; 065 Siqueira / 13 de Maio / Assembleia; 075 Campus do Pici / Unifor; 855 Bezerra de Menezes / Washington Soares
ÁREA EDIFICADA (M2)
Inscrições Residenciais: 1.040.433,08
Inscrições Comerciais: 412.414,42

Inscrições de Prestação de Serviços: 33.363,70
Inscrições Industriais: 1.444,51
Assentamentos precários: Favela São Gabriel; Rua Barão de Aracati e Rua Henrique Rabelo
101 REGIONAL 2
AURÉLIO ALVES
Colégio Dorotéias: fachada tem arquitetura preservada
MEIRELES

Logo depois da construção da Av. Beira Mar, na década 1960, surgiu o Meireles. Atualmente, por ter uma das melhores localizações da Capital, é o bairro com o metro quadado (m²) mais caro de Fortaleza e está entre os que oferece excelente qualidade de vida.
Ao longo da Beira Mar foram construídos muitos prédios residenciais de luxo e, também, muitos hotéis que atraem hóspedes de todo o mundo, tanto para viagens a lazer como para negócios. A locomoção também é facilitada para outros pontos da Cidade.
O Meireles, bairro pertencente à Regional 2, faz divisa com Mucuripe, Varjota, Aldeota, Praia de Iracema e Centro. Suas principais avenidas levam para os quatro cantos da Cidade. E é considerado um dos melhores bairros em relação à infraestrutura.
Com parte da orla ligada ao seu território, o bairro tem movimentação o dia todo. Por causa do nascer do sol na orla, adeptos de práticas esportivas, amadores ou profissionais, utilizam o mar e o calçadão para se exercitarem. Isso prossegue ao longo da tarde e da noite com a ciclofaixa, a quadra esportiva e outros atrativos para o público.
A presença dos quiosques da praia, dos bares e dos restaurantes agita o local. A Feirinha da Beira Mar, ponto turístico da Cidade, recebe tanto moradores da Capital quanto turistas nacionais e internacionais.

Um ponto bastante conhecido pelos moradores de Fortaleza é a Areninha do Campo do América, antigamente chamada apenas de Campo do América. Localizado próximo a uma comunidade local, o campo já recebeu o nome de Vargas Filho, um conhecido time de futsal. Naquela época o campo ficava a cerca de um metro acima do nível da rua.
Atualmente, o Meireles está entre os bairros mais populosos da Cidade e recebe visitantes atraídos por outros locais públicos além dos mencionados acima, como os arrecifes da Volta da Jurema e o Jardim Japonês. Além disso, a região acolhe um dos clubes mais tracionais, Clube do Náutico, que há duas déca-
das de vida mantém-se no melhor estilo greco-romano. E, também, há o Ideal Clube.
O bairro abriga a Casa Civil, sede do Governo do Estado do Ceará, residência oficial do cargo executivo mais alto do Estado, o Palácio da Abolição e o Museu da Imagem e do Som. Com tudo isso, o Meireles é um dos espaços mais populares da Cidade.
102 NOSSOS BAIRROS | NOSSA FORTALEZA
Vista aérea da Avenida Beira Mar
DADOS GERAIS
Localização
Regional: SR 2
Território: 7

Bairros limítrofes: Mucuripe, Aldeota, Varjota, Praia
de Iracema, Centro

População estimada: 36.982
População Feminina: 20.811
População Masculina: 16.171
Densidade (hab/km²): 13.944,95
103 REGIONAL 2
FCO FONTENELE
Área (km²): 2,65
Perímetro (km): 9.126,22
Avenidas principais: Avenida Antônio Justa, Avenida Barão de Studart, Avenida Beira Mar, Avenida da Abolição, Avenida Desembargador Moreira, Avenida Dom Luís, Avenida Historiador Raimundo Girão, Avenida Monsenhor Tabosa, Avenida Rui Barbosa, Avenida Senador Virgílio Távora
Feira Livre:

Feira da Beira Mar (Av. Beira Mar, 2800)
Ecopontos:
Avenida Antônio Justa, esquina com Rua Meruoca
IDH: 0,953
BEIRA MAR
Local de muitos encontros e reencontros, a Beira Mar é um dos principais pontos turísticos da Capital cearense e destino certo para quem quer aproveitar bons momentos regados a sol, mar, estrutura de hotéis, bares e restaurantes.
O local funciona, praticamente, 24 horas, pois seu espaço é cenário para prática de atividades esportivas logo

104
| NOSSA FORTALEZA
NOSSOS BAIRROS
Faixa de areia da Beira Mar costuma sediar shows e eventos gratuitos para a população
AURÉLIO ALVES
ao amanhecer, como canoagem e natação, serve também como um espaço livre para caminhadas e corridas.
Na sua extensão são realizadas muitas atividades culturais, grátis ou não, que resgatam as raízes do povo cearense. Há espaço de compra que é destino certo de quem visita Fortaleza, a Feirinha da Beira Mar. Além de ter um pôr do sol espetacular que encanta a todos.
ESPORTE
Areninhas: Areninha Campo do América
IGREJAS
Paróquia Nossa Senhora do Líbano (Rua Tibúrcio Cavalcante, 509); Paróquia Santa Luzia (Rua João Cordeiro, 679); Igreja de Santa Filomena (R. Joaquim Nabuco, 176)
PRAÇAS
Jardim Japonês - Avenida Beira Mar e Rua José Napoleão
Praça Dr. Antônio Prudente - Av. Historiador Raimundo Girão e Av. Abolição
Praça Dr. Moreira da Rocha - Avenida Abolição e Rua Barbosa de Freitas
Praça Igreja Santa Luzia - Rua Deputado Moreira da Rocha e Rua Tenente Benévolo
EDUCAÇÃO
Escolas: José Dias Macêdo (Rua Nunes Valente, 809); Instituto Pestalozzi do Ceará (Rua Barão De Aracati, 696)
CULTURA
Bibliotecas: Biblioteca do Instituto de Ciências do Mar Dr. Rui Simões de Menezes (Av. da Abolição, 3207)
Museus: Museu da Imagem e do Som do Ceará (MIS) (Avenida Barão de Studart, 410; Mausoléu Castello Branco (Av. Barão de Studart, 500)
Teatro: Teatro do Humor (R. Osvaldo Cruz, 1); Anfiteatro da Beira Mar (Av. Beira Mar, 3620);
Centros culturais: Centro cultural (R. Pereira Valente, 1569); Centro Cultural Mar Alto | Opus Dei (R. Antônio Lima, 150);
PATRIMÔNIO HISTÓRICO
Feira de Artesanato da Beira Mar; Ideal Clube; Náutico Atlético Cearense
SEGURANÇA
Delegacias: 2º Distrito Policial
Juizados: 21ª Unidade Juizado Especial Civel
AIS: 1
TRANSPORTE PÚBLICO
Linha 905 - Meireles
Ciclofaixa
Ciclovia
Ciclorota
Estação Bicicletar Prefeitura
Estação Biciletar Unimed
Estação Vamo
ÁREA EDIFICADA (M2)
Inscrições Residenciais: 21.204
Inscrições Comerciais: 6.020
Inscrições de Prestação de Serviços: 922
Inscrições Industriais: 7

Assentamentos precários:
Favela
Japão
Campo do América
105 REGIONAL 2
MUCURIPE
Para quem aprecia belas paisagens naturais, o bairro do Mucuripe em Fortaleza, criado na década de 1940, é uma excelente opção. Para contemplar o pôr do sol é um dos locais mais indicados da Capital.
Conhecido também como o final da Beira Mar, o espaço abriga pequenas embarcações de pescadores locais, que originaram a criação do bairro, escolas de esportes náuticos e barracas para os visitantes tomarem sol.
O território é habitado por quem vive ainda da pesca. Grande parte do que é capturado segue direto para o Mercado dos Peixes, local que fica ao lado das embarcações.
Por lá ainda existe a igrejinha de São Pedro dos Pescadores, padroeiro dos pescadores. Boa parte da orla foi tomada por hotéis, restaurantes e prédios comerciais. Mesmo sendo um bairro pequeno, sua área possui menos de 1 quilômetro quadrado (km²), mantém as características de cidade praiana.
Um cenário localizado no bairro conta o romance entre a índia Iracema e o colonizador português Peri.

DADOS GERAIS
Localização
Regional: SR 2
Território: 9

Bairros limítrofes: Cais do Porto, Vicente Pinzon, Varjota, Meireles
População estimada: 13.747
População Feminina: 7.508
População Masculina: 6.239
Densidade (hab/km²): 14.523,93
Área (km²): 0,87
Perímetro (km): 8.321,19
Avenidas principais: Avenida Almirante Henrique Sabóia; Avenida Álvaro Correia; Avenida Beira Mar; Avenida da Abolição; Avenida dos Jangadeiros
106 NOSSOS BAIRROS | NOSSA FORTALEZA


107 REGIONAL 2
THAIS MESQUITA
Mercado dos Peixes é o local ideal para comprar ou comer na hora peixes e frutos do mar
Cemitérios: Cemitério São Vicente de Paula, popularmente conhecido como Cemitério do Mucuripe.
IDH: 0,793
ATIVIDADE SOCIAL

Associação Curumim; Associação dos Idosos do Mucuripe Oscar Verçosa; Projeto Enxame; Centro de Inclusão Tecnológica e Social - CITS Mucuripe; Sala de Informática - CITS Mucuripe
IGREJA
Paróquia Nossa Senhora da Saúde; Igreja São Pedro dos Pescadores
MERCADO
Mercado dos Peixes - Inaugurado na década de 1960, o espaço foi criado na intenção de melhorar a comercialização dos peixes e frutos do mar dos pescadores locais. Atualmente, além da possibilidade de comprar as iguarias fresquinhas nos boxes espalhados pelo local, é possível degustar na hora peixes, lagostas e camarões fritos ou cozidos nos restaurantes na parte de trás do Mercado dos Peixes.

SAÚDE
Postos de Saúde: Posto de Saúde Flávio Marcílio
PRAÇAS
Praça Cirenio Cordeiro; Ns. da Saúde e Praça Riacho Maceió
MEIO AMBIENTE
Parques: Parque Arquiteto Otacílio Teixeira Neto (Bisão); Parque Linear Do Riacho Maceió
108 NOSSOS BAIRROS | NOSSA FORTALEZA
Estrutura funciona todos os dias servindo peixes e frutos do mar frescos vendidos nos boxes na beira da praia
EDUCAÇÃO
Escolas: José Ramos Torres De Melo (Av. Da Abolição, 3984); Colônia Z8 (Rua Manuel Jesuíno, 370);
CULTURA
Bibliotecas: ArdaAtesFotografia ( Rua da Paz, 455)
PATRIMÔNIO HISTÓRICO
Igreja de São Pedro dos Pescadores (Av. Beira Mar, S/N)
SEGURANÇA
Capitania dos Portos do Ceará - CPCE
Delegacias: Posto de Apoio da Polícia Militar
Conselho Tutelar II
AIS: 1
TRANSPORTE PÚBLICO
Antônio Bezerra/Mucuripe; Antônio Bezerra/Mucuripe/Papicu; Parangaba/Mucuripe; Parangaba/Mucuripe II; Siqueira/Mucuripe/Barão de Studart; Siqueira/ Mucuripe/Barão de Studart/II; Siqueira/Mucuripe/ED
CICLOFAIXA
Ciclovia
ÁREA EDIFICADA (M2)

Inscrições Residenciais: 5.833
Inscrições Comerciais: 755

Inscrições de Prestação de Serviços: 109
Inscrições Industriais: 0
Assentamentos precários:
Favela Praça do Coqueiro; Terramar; João Arruda; Rua Tereza Kinko; Santa Edwiges; Saporé; Rua João Arruda; Comunidade Riacho Maceió
109 REGIONAL 2
AURÉLIO ALVES
PAPICU
Localizado na região Leste de Fortaleza, o Papicu é um mix de estabelecimentos comerciais e residências. A história do território começou quando o industrial Antônio Diogo de Siqueira adquiriu do genro, Waldemiro Maia, uma grande área de terra que compreendia a área limitada pelo Rio Cocó. Essa área tinha a finalidade de ser agropastoril, destinada à criação de gado e salga de carne para exportação.
Com a queda da comercialização do gado, Siqueira dividiu o espaço em dois loteamentos, o “Moderna Aldeota”, na Avenida Santos Dumont, e o outro junto ao Porto do Mucuripe, chamado “Praia do Futuro”.
Para demarcar a urbanização da região, o empresário Waldyr Diogo Vital Siqueira, filho de Antônio Diogo Siqueira, marcou o início da urbanização com a construção da Estrada Dioguinho, ainda em 1949.
Depois de algumas instalações industriais e comerciais no local, o que alavancou o desenvolvimento foi a ocupação no bairro próximo, Cidade 2000. O Papicu passou a receber igrejas, linhas de ônibus e pequenos comércios.
DADOS GERAIS
Localização
Regional: SR 2
Território: 8

Bairros limítrofes: Cocó, De Lourdes, Vicente Pinzón e Varjota
População estimada: 18.370
População Feminina: 9.786
População Masculina: 8.584
Densidade (hab/km²): 8.726,84
Área (km²): 2,11
Perímetro (km): 6.799,43
Avenidas principais: Av. Almirante Henrique Sabóia, Av. Dolor Barreira, Av. Engenheiro Alberto Sá, Av. Engenheiro Santana Júnior, Avenida Santos Dumont
Feiras livres: Feira do Papicu
Ecopontos: Papicu (Rua Júlio Azevedo, 688)
IDH: 0,530
ESPORTES
Areninhas: Areninha Papicu
ATIVIDADE SOCIAL
Associação dos Idosos do Mucuripe Oscar Verçosa;
IGREJA
Igreja Menino Jesus de Praga; Paróquia São José
SAÚDE
Hospitais: Hospital Geral de Fortaleza (HGF); Hospital São Mateus; Hospital Maternidade Dunas
PRAÇAS
Praça 13 de Rockdales; Praça Estrigas e Nice; Praça Juarez
MEIO AMBIENTE
Parques: Parque Urbano Da Lagoa Do Papicu
EDUCAÇÃO
Escolas: Maria Alice; Professora Maria Gondim Dos Santos; Wilma Maria De Vasconcelos Leopércio; Recanto Psico Pedagógico
CULTURA
Cinemas: Cinépolis RioMar Fortaleza
Teatros: Teatro RioMar Fortaleza
110 NOSSOS BAIRROS | NOSSA FORTALEZA
PATRIMÔNIO HISTÓRICO
Riacho Papicu e suas Margens
SEGURANÇA
AIS: 1
TRANSPORTE PÚBLICO
Ônibus: Antônio Bezerra/Francisco Sá/Papicu; Antônio Bezerra/Francisco Sá/Papicu/II; Antônio Bezerra/Mucuripe/Papicu; Antônio Bezerra/Papicu; Antônio Bezerra/ Papicu/Antônio Sales; Antônio Bezerra/Papicu/Praia de Iracema; Antônio Bezerra/Papicu/Praia de Iracema/II; Av. Borges de Melo/Papicu I; Av. Borges de Melo/ Papicu II; Caça e Pesca/Papicu; Castelo Encantado/Papicu; Cidade 2000/Hospital Geral/Papicu/ED; Cidade 2000/Papicu; Cidade Func/Papicu/Jardim das Oliveiras; Cj Alvorada/ Papicu; Cj Ceará/Aldeota/Papicu; Cj Ceará/Papicu/Montese; Cj Palmeiras/Papicu; Cj. Ceará/Papicu/Montese/ II; Clube dos Diários/Papicu; Corujão/Cj Ceará/Papicu/ Montese; Corujão/Edson Queiróz/Papicu; Corujão/Parangaba/Papicu; Cuca Barra/Papicu; Defensoria/Papicu/Via Câmara; Dom Luís/Papicu/Centro; Edson Queiróz/Papicu Edson Queiróz/Papicu/ED; Especial/Reserva Papicu; Expresso/Antônio Bezerra/Papicu; Expresso/Cj Ceará/ Papicu; Expresso/Messejana/Papicu; Expresso/Parangaba/Papicu; Expresso/Siqueira/Papicu; HGF/Papicu/Riomar;José Walter/Papicu/Cidade Jardim; Lagoa Redonda/ Papicu; Lagoa/Papicu/Via Expressa; Luciano Cavalcante/ Papicu; Messejana/Papicu/Cambeba/LJ; Messejana/ Papicu/Cambeba/TJ; Messejana/Papicu/Cj Tancredo
Neves; Messejana/Papicu/Manibura; Messejana/Papicu/ Washington Soares; Papicu/Arena Castelão; Papicu/Aterro/Abolição; Papicu/Aterro/PFilgueiras; Papicu/Domingos Olímpio; Papicu/Fortal; Papicu/Halleluya/Castelão; Papicu/Iguatemi; Papicu/Parque do Cocó; Papicu/Paulo Sarasate; Parangaba/Oliveira Paiva/Papicu; Parangaba/ Oliveira Paiva/Papicu II; Parangaba/Papicu; Parangaba/ Papicu II; Parangaba/Papicu/Aeroporto; Parangaba/Papicu/Aeroporto II; Parangaba/Papicu/Montese; Parangaba/ Papicu/Montese/II; Praia do Futuro/Papicu; Praia do Futuro/Papicu/ED; Serviluz/Papicu; Siqueira/Papicu/13 de Maio; Siqueira/Papicu/Aeroporto; 1Siqueira/Papicu/Aeroporto/II; Siqueira/Papicu/Washington Soares; Siqueira/ Papicu/Washington Soares II; Vicente Pinzon/Papicu
Ciclofaixa
Ciclovia
ÁREA EDIFICADA (M2)
Inscrições Residenciais: 5.756
Inscrições Comerciais: 4.070

Inscrições de Prestação de Serviços: 59
Inscrições Industriais: 5

Assentamentos precários:
Conjunto habitacional: Conjunto Papicu
Favela: Rio Pardo ou Trilhos 1; Rua André Dall”olio II; Novo Lar/Jardim Nova Esperança; Come Burra; Joaquim Lima; Travessa Pelotas; Rua André Dall”olio;Verdes Mares/ Queremos Viver Melhor; Telemar; Pau Fininho; Santos Dummont/ Areia Grossa/Areia
111 REGIONAL 2
AURÉLIO ALVES
Shopping RioMar Fortaleza movimenta a economia do bairro Papicu
SÃO JOÃO DO TAUAPE
O bairro São João do Tauape é considerado um bairro social que mantém vivo costumes de épocas passadas.
A Igreja São João Batista foi criada por Dom Antônio de Almeida Lustosa, na época Arcebispo de Fortaleza, em 1951. Na ocasião, também foi criada a Paróquia Nossa Senhora da Piedade, resultado do desmembramento e extinção da Paróquia de Santa Teresinha, criada em 1934.
Em 1981, O POVO registrou o momento em que Dom Aloísio Lorscheider “sagra a igreja do São João do Tauape”, que hoje abriga um salão paroquial.
São João do Tauape tem boa localização e fica próximo aos bairros Dionísio Torres, Joaquim Távora e Aldeota, bairros considerados nobres de Fortaleza. O nome da região onde hoje conhecemos como São João do Tauape tem origem no riacho de mesmo nome, que é mais conhecido nos dias atuais como canal do Lagamar.

DADOS GERAIS
Localização
Regional: SR 2
Território: 10

Bairros limítrofes: Dionísio Torres, Joaquim Távora e Aldeota
População estimada: 27.598
População
Feminina: 15.100
População Masculina: 12.498
Densidade (hab/km²): 11.070,20
Área (km²): 2,49
Perímetro (km): 8.308,21
112 NOSSOS BAIRROS | NOSSA FORTALEZA
Parque Rio Branco possui uma área de mais de 77 mil metros quadrados
MESQUITA
THAIS
Avenidas Principais: Pontes Vieira, Governador Raul Barbosa, Almirante Henrique Sabóia, Washington Soares
Feira: uma feira livre
Ecopontos: São João do Tauape (Avenida Visconde do Rio Branco, S/N – anexo ao Parque Rio Branco)
IDH: 0,492
ESPORTES
Areninhas: Tauape
ATIVIDADE SOCIAL
FACC - Frente de Assistência à Criança Carente (R. Carvalho Júnior, 571)
IGREJAS
Paróquia São João Batista; Salão Paroquial São João do Tauape; Assembleia de Deus - Templo Central; Igreja de São Francisco; Igreja Pentecostal Deus É Amor; Capela Nossa Senhora de Fátima; Igreja da Sagrada Família - Pio XII
SAÚDE
Postos de Saúde: Irmã Hercília Aragão e Pio XII
PRAÇAS
Praça São Francisco (Cruzamento da rua Ouro Branco com Travessa Oliveira); Praça Amiga da Criança (R. Manoel Lourenço dos Santos, 130)
MEIO AMBIENTE
Parques Rio Branco - Teve origem na década de 1970 com um decreto que transformou aquela área em Zona de Preservação Paisagística. O local possui uma área de mais de 77 mil metros quadrados e é formado, também, na nascente do Riacho Rio Branco.
Vários equipamentos foram inseridos no parque, transformando-o em uma área de lazer para a população: playground, academia ao ar livre, campo de
futebol, mesa de jogos e anfiteatro.
A área poligonal do Parque Urbano Rio Branco consiste na delimitação da Zona de Preservação Ambiental 1 (ZPA 1), localizada entre as vias: Av. Pontes Vieira, Av. Visconde do Rio Branco, Rua Capitão Gustavo e Rua Castro Alves. O Parque faz parte do Sistema Municipal de Áreas Verdes.
A ZPA 1 é composta por flora predominante dos biomas Caatinga, Cerrado e Mata Atlântica, e diferentes espécies de animais, entre aves, répteis e mamíferos..
EDUCAÇÃO
Escolas: Municipal Almerinda de Albuquerque; Municipal Professora Antonieta Cals; Municipal Nossa Senhora do Sagrado Coração; Creche São Gabriel; Municipal de Tempo Integral Professora Antonieta Cals e Municipal de Tempo Integral Ambiental Dra. Francisca de Assis Canito da Frota
SEGURANÇA
AIS: 10
TRANSPORTE PÚBLICO
Ônibus: 011 Circular I / Centro; 045 Conjunto Ceará / Papicu / Montese; 065 Siqueira / 13 de Maio / Assembleia; 099 Siqueira / Mucuripe / Barão de Studart; 602 Parque Pio XII / Ana Gonçalves / Centro; 755 Curió / Riomar Kennedy; 855 Bezerra de Menezes / Washington Soares
Metrô: Estação São João do Tauape (Rua Capitão Melo, nº 4376 - São João do Tauape)
ÁREA EDIFICADA (M2)
Inscrições Residenciais: 844.833,76
Inscrições Comerciais: 238.816,24

Inscrições de Prestação de Serviços: 22.540,81
Inscrições Industriais: 7.271,45
Assentamentos precários: Conjunto Habitacional Nossa Senhora de Fátima; Favela Padre Cícero; Favela Lagamar; Favela Rua do Trilho Pio XII; Favela Comunidade do Pio XII ou Pau Pelado
113 REGIONAL 2
VARJOTA
O menor bairro da Regional 2 é conhecido como Varjota. Com ruas charmosas, o local atrai visitantes residentes de outros bairros e, também, turistas, pois reúne um número grande de restaurantes, bares, cafés e docerias. Foi assim que se tornou um polo gastronômico de Fortaleza.
Além de proporcionar diversão, esse território abriga outros estabelecimentos como lojas, bancos e residências. Ele é ideal para quem busca bem-estar, rapidez no deslocamento, ampla opção de comércio e fácil acesso às praias.
Muitas ruas oferecem bares, lanchonetes e restaurantes que atendem a todos os gostos e bolsos. A vocação para polo gastronômico possibilitou a aprovação da Lei n° 9.562, de 28 de dezembro de 2009, que estabeleceu o corredor gastronômico da Varjota.
Dentre as ruas que fazem parte desta conquista, estão as Avenidas Santos Dumont, Senador Virgílio Távora e Abolição e a Rua Manoel Jesuíno. Com todo esse potencial turístico e empreendedor, o bairro conseguiu alavancar o desenvolvimento econômico local.
Porém, antes da fama gastronômica reconhecida nacionalmente, a Varjota já foi uma vila de estivadores, em 1912. As ruas de terra batida ficaram apenas na lembrança afetiva dos moradores mais antigos, pois a região abriu espaço para lugares atrativos.
Mas por muitos anos o bairro foi considerado apenas um prolongamento do Mucuripe, com somente uma estrada de terra, onde fica, atualmente, a Rua Manoel Jesuíno, que tinha muita vegetação. Manoel Jesuíno era o proprietário das terras no local.
Na época, Jesuíno resolveu começar a vender os lotes a um valor acessível, o que possibilitou a rápida ocupação do bairro e transformação no que é hoje.
DADOS GERAIS
Localização
Regional: SR 2
Território: 8

Bairros limítrofes: Papicu, Cocó, Vicente Pinzon, Mucuripe, Meireles, Aldeota
População estimada: 8.421
População Feminina: 4.776
População Masculina: 3.645
Densidade (hab/km²): 15.828,95
Área (km²): 0,53
Perímetro (km): 3.260,84
Avenidas principais: Avenida Almirante Henrique Sabóia; Avenida Antônio Justa; Avenida Desembargador Colombo de Sousa; Avenida Júlio Abreu; Avenida Santos Dumont
Ecopontos: Avenida Antônio Justa, esquina com Rua Meruoca
IDH: 0,718
PRAÇAS
Praças: Praça Largo das Ideias - Av. Júlio Abreu e Av. Almirante Henrique Sabóia
EDUCAÇÃO
Escolas: Menino Maluquinho (Rua Doutor José Lino, 980)
CULTURA
Museus: Museu da Fotografia (R. Frederico Borges, 545); Acervo Mucuripe (Av. Álvaro Correia, 69b)
Teatros: Teatro Nadir Papi Saboya (Rua 8 de Setembro, 1331)
SEGURANÇA
Juizados: 21ª Unidade Juizado Especial Civel ( Rua Osório Palmella, 260);
AIS: 1
114 NOSSOS BAIRROS | NOSSA FORTALEZA
Piniquinhos
TRANSPORTE PÚBLICO
903-Varjota/Centro
Ciclofaixa
Ciclovia
ÁREA EDIFICADA (M2)
Inscrições Residenciais: 2.668
Inscrições Comerciais: 723
Inscrições de Prestação de Serviços: 29
Inscrições Industriais: 2

Assentamentos precários:
Favela
Rio Pardo ou Trilhos 1
POLO GASTRONÔMICO
A vocação gastronômica é um legado da Varjota. O território que já foi reduto de estivadores e pescadores, desde os primórdios já oferecia restaurantes locais que eram comandados pelos próprios moradores, que pescavam, e suas esposas.
Dentre os primeiros restaurantes do bairro, estão o Garoto da Varjota; a Agulha Frita; o Zé Luís; e o Osias. E ano após ano, mais e mais restaurantes e outros tipos de espaços gastronômicos foram se instalando.
Atualmente, o bairro abriga desde sorveterias com influência italiana a restaurantes portugueses, alemães e especializados em culinária contemporânea, além da cozinha brasileira e da típica cearense.

115 REGIONAL 2
Polo gastronômico da Varjota oferece variados estilos e nacionalidades de restaurantes, bares e lanchonetes
THAIS MESQUITA
VICENTE PINZÓN
Há quem diga que não foi Pedro Álvares Cabral que descobriu o Brasil e, sim, um navegador espanhol chamado Vicente Yáñez Pinzón, da frota de Cristóvão Colombo, que teria ancorado meses antes nas terras brasileiras e, justamente, no Ceará.
O aporte teria acontecido na Ponta do Mucuripe, em Fortaleza, no dia 26 de janeiro de 1500. Vicente teria batizado o local descoberto de Cabo de Santa Maria de la Consolación. Foi esse mesmo personagem histórico que participou da descoberta da América, em 1492, como capitão da caravela La Niña.
No território sempre predominou a presença de pescadores. Algumas de suas comunidades, entre elas o Conjunto Santa Terezinha, o Conjunto São Pedro, o Serviluz e o Castelo Encantado se confundem com o nome do bairro em homenagem ao espanhol e, também, com comunidades dos bairros vizinhos como Cais do Porto e Mucuripe.
Dentre os pontos com maior circulação, estão a Praia dos Bote, no singular mesmo; a Paróquia Santa Terezinha do Menino Jesus; o Campo do Terra e Mar, fundado em 1938; o Campo Carlos Barros; a Praça da Conquista; e o Mirante, ponto mais alto da Cidade.
DADOS GERAIS
Localização
Regional: SR 2
Território: 9

Bairros limítrofes: Mucuripe, Cais do Porto, Mucuripe, Varjota, Papicu, De Lourdes e Praia do Futuro I
População estimada: 45.518
População Feminina: 23.752
População Masculina: 21.766
Densidade (hab/km²): 14.523,93
Área (km²): 3,13
Perímetro (km): 8.321,19
Avenidas principais: Avenida Clóvis Arrais Maia; Avenida Dioguinho; Avenida Almirante Henrique Sabóia; Avenida Engenheiro Alberto Sá; Avenida Engenheiro Luís Viana; Avenida Dolor Barreira; Avenida Clóvis Matos; Avenida Areia Branca; Avenida César Cals
Feiras livres: Feira Do Vicente Pinzon na Av. Dos Jangadeiros - entre as Ruas Francisco Alves Pereira e São Bernardo Do Campo) ; na Av. Dolor Barreiraentre as Ruas Veneza e ÁLvaro Costa; na Rua Veneza
Ecopontos: Rua Veneza, esquina com Rua Josias Paula de Souza
IDH: 0,331
ATIVIDADE SOCIAL
ONG Sorriso da Criança - CEBS São Pedro; Fundação de Educação e Saúde Mandacaru; Núcleo de Ação Pela Paz (Napaz);
IGREJA
Paróquia Nossa Senhora Aparecida; Paróquia Santa Teresinha do Menino Jesus
SAÚDE
Postos de Saúde: Aida Santos e Silva; Sandra Maria Faustino
PRAÇA
Mirante; Alan Neto; Ayrton Senna, Praça da Conquista; Fateixa; Praça do Céu. Praça do Precipício; Novo Horizonte; Jangadeiros; Joana D’arc; Gid 48 ; Narcisa Borges; Olímpia Meira ; Pilão I; Praça Pilão II; José Lopes da Silva; Professor Belarmino Maia; Olímpia Meira
EDUCAÇÃO
Escolas: Luis ÂNgelo Pereira; Professora Aída Santos
116 NOSSOS BAIRROS | NOSSA FORTALEZA
E Silva; Professora Belarmina Campos; Professora Consuelo Amora; Darcy Ribeiro; Padre José Nilson; Professora Aída Santos E Silva; Professora Belarmina Campos; Casa De Afonso E Maria; Sonho Infantil
CULTURA
Bibliotecas: Biblioteca Comunitária Casa de Afonso e Maria ACAM (R. Dr. Antônio Carneiro, 763)
SEGURANÇA
Delegacias: 9º Distrito Policial
Juizados: 3ª Unidade de Juizado Especial Cível da Comarca de Fortaleza
AIS: 1
TRANSPORTE PÚBLICO
Vicente Pinzon/Papicu; Meireles/Centro; Estação de Metrô/ Superficie Bairro: Mucuripe/ Linha: VLT; Av. Almirante Henrique Sabóia (Via Expressa) com R. Olga Barroso
Ciclofaixa
Ciclovia
Ciclorota ÁREA
EDIFICADA (M2)
Inscrições Residenciais: 6.208

Inscrições Comerciais: 950
Inscrições de Prestação de Serviços: 58
Inscrições Industriais: 1

Assentamentos precários:
Conjunto habitacional Santa Terezinha
Favela: Delmar; Morro das Placas; Morro do Teixeira; Comunidade Aristide Barcelos; Morro da Vitória/ Farol Novo 2; Travessa Gomes de Matos; Joana D´arc; Morro do Sandra; Rua Trajano de Medeiros; Morro do Mirante; Terramar; Comunidade do Buraco/ Morro Santa Terezinha; Casa do Samba; Trilha 2 ou rua do Trilho; Lagoa do Coração; Antônio Carneiro; Bráulio Muniz; Travessa Lemos; Rua Renato Braga; Pintor Antônio Bandeira; Mutirão; Conjunto Trajano de Medeiros; Castelo Encantado; São pedro/Farol Novo
117 REGIONAL 2
FCO FONTENELE
Praça do Mirante é o ponto mais alto de Fortaleza
REGIONAL 3




















Alguns bairros da Regional 3 fazem homenagem a grandes personalidades e têm avenidas que dão acesso à parte central da Cidade, como a Sargento Hermínio. A região também respira muito verde através da Lagoa do Porangabussu e do Parque Rachel de Queiroz












 Igreja de Santo Afonso (Igreja Redonda), em Amadeu Furtado
Igreja de Santo Afonso (Igreja Redonda), em Amadeu Furtado





























GUIA DA REGIONAL 3

Lagoa do Porangabussu no Rodolfo Teófilo
BAIRROS
Amadeu Furtado
Antonio Bezerra
Bairro Ellery
Farias Brito
Monte Castelo
Olavo Oliveira
Padre Andrade
Parque Araxá
Parquelândia

Presidente Kennedy
Quintino Cunha
Rodolfo Teófilo
São Gerardo
120 NOSSOS BAIRROS | NOSSA FORTALEZA
AURÉLIO ALVES
SECRETARIA REGIONAL 3
Endereço: Av. Jovita Feitosa, 1264 - Parquelândia
Fortaleza - CE, 60455-410
Telefone: (85) 3433-2501
Secretário: Michel Lins
E-mail: kellyjscaires@hotmail.com
Publicitário, trabalhou na Secretaria de Trabalho e Desenvolvimento Social (STDS) do Governo do Ceará. Eleito vereador, foi presidente da Comissão de Turismo, Desenvolvimento Econômico e Emprego e Renda na Câmara Municipal e se destacou como presidente da Comissão de Cultura, Esporte e Lazer, além de ser membro efetivo da Comissão de Segurança Pública.
CONTATOS IMPORTANTES
GABINETE DO SECRETÁRIO
Telefone: (85) 3433.6883
OUVIDORIA
Telefone: (85) 3433-2519
E-mail: ouvidoria.ser3@sr3.fortaleza.ce.gov.br
CENTRAL DE ACOLHIMENTO
Telefone: (85) 9 9708.6101
E-mail: centraldeacolhimento.sr3@gmail.com
CONSERVAÇÃO E SERVIÇOS PÚBLICOS
Telefone:
E-mail: alan.ferreira@sr3.fortaleza.ce.gov.br

ORDENAMENTO DE TERRITÓRIO
Telefone: (85) 9 8439.8381
E-mail: paulo.queiroz@sr3.fortaleza.ce.gov.br
SINE MUNICIPAL - REGIONAL 3
WhatsApp (trabalhador): (85) 9 8513.4385
WhatsApp (empregador): (85) 9 8970.3532
COODENAÇÃO DE INFRAESTRUTURA
Telefone: (85) 9 8824.6345
E-mail: fernandofeitosa080@gmail.com
NÚCLEO DE MEDIAÇÃO
E-mail: comednucleosr3@gmail.com

CADASTRO ÚNICO
Telefone: (85) 3433.2517
AGEFIS
Telefone: 156
VIGILÂNCIA SANITÁRIA
Telefones: (85) 9 8513.3754
121 REGIONAL 3
AMADEU FURTADO
O Amadeu Furtado é um bairro que fica entre a parte central e a região Oeste de Fortaleza. Era parte do bairro Coqueirinho até 1952, quando teve a mudança na nomenclatura para homenagear o médico e político que carrega o nome atual do bairro.
Posteriormente, em 1958, dividiu seu território para o surgimento da Parquelândia, bairro que hoje leva a fama por muitos estabelecimentos que na verdade estão no território do Amadeu Furtado, pelo rápido crescimento do vizinho. Entre eles, está a Igreja Redonda, um dos principais cartões postais da região.
Hoje, o Amadeu Furtado está em uma área valorizada da Cidade, com fácil acesso aos bairros mais centrais.
DADOS GERAIS
População estimada: 11.703

População Feminina: 6.492
População Masculina: 5.211
Densidade (hab/km²): 12.516,58
Área total: 0,94 km2
Perímetro (km): 4.574,75
LOCALIZAÇÃO GEOGRÁFICA: Regional III, entre a parte oeste e centro de Fortaleza. Faz divisa com os bairros Parquelândia, Rodolfo Teófilo, Bela Vista e Pici.

Avenidas principais: Avenida Humberto Monte; Avenida Jovita Feitosa
Ecopontos: Ecoponto - Jovita Feitosa (Rua General Bernardo Figueiredo, esquina com a Rua Cruz Saldanha)
IDH: 0,588
ATIVIDADE SOCIAL
Projeto Trampolim - Tem o objetivo de desenvolver o aspecto cognitivo, o exercício da cidadania, a autoestima e contribuir para o fortalecimento dos vínculos familiares
122 NOSSOS BAIRROS | NOSSA FORTALEZA
das crianças e dos adolescentes. Fica na rua Xavier de Oliveira, 52.
IGREJAS
Igreja de Santo Afonso (Igreja Redonda); Igreja Batista da Parquelândia.
PRAÇAS
Praça Ari de Sá; Praça Monsenhor Linhares, Praça Marechal Francês, Praça da Igreja Redonda

EDUCAÇÃO
Escolas: EEMTI Santo Afonso, EMEIF Monsenhor Linhares, EEFM Antônio Sales,
SEGURANÇA
AIS: 6
TRANSPORTE PÚBLICO
Ônibus: Av. Borges de Melo/ Papicu II; Lagoa/Papicu/Via Expressa; Campus do Pici/Unifor; Francisco Sá/Parangaba; Rodolfo Teófilo/José Bastos/Centro; Igreja São Raimundo/Centro; Bela Vista/Lagoa; Bela Vista/Centro; Antônio Bezerra/Jovita Feitosa/Centro; Paupina/Pici
ÁREA EDIFICADA (M2)
Inscrições Residenciais: 3.053
Inscrições Comerciais: 708

Inscrições de Prestação de Serviços: 68
Inscrições Industriais: 3
Assentamentos precários: Rua Amadeu Furtado; Vila João Freitas ou Travessa Maravilha; Bela Vista Nova; Forró da Bala.
123 REGIONAL 3
Igreja de Santo Afonso (Igreja Redonda) é conhecida em toda a região da Regional 3
JULIO CAESAR
ANTÔNIO BEZERRA
O Antônio Bezerra faz fronteira com o município de Caucaia e é um dos principais pontos de acesso à cidade da Região Metropolitana de Fortaleza (RMF) pela Mister Hull.
O Antônio Bezerra possui um grande fluxo de ônibus, tem uma rodoviária própria, um terminal de integração com o nome do bairro (fica localizado no bairro Padre Andrade) e diversos pontos de ônibus para a RMF.
O distrito pertenceu ao município de Parangaba até a década de 1920, quando se emancipou. Seu primeiro nome foi Barro Vermelho em alusão ao solo característico do local, pois era uma região com muitas chácaras e fazendas.
Em 1937, a mudança de nome do bairro para Antônio Bezerra foi homologada, em homenagem ao poeta, historiador, naturalista e escritor de mesmo nome, que também foi um dos líderes abolicionistas no Estado.
A população seguiu chamando o bairro de Barro Vermelho até 1965, quando a Ditadura Militar começou a associar o “vermelho” ao comunismo e exigiu o nome Antônio Bezerra.
DADOS GERAIS
População estimada: 25.846

População Feminina: 13.944
População Masculina: 11.902
Densidade (hab/km²): 11.764,22
Área total: 2,20 km²
Perímetro (km): 6.614,09
Localização geográfica: Regional III, na parte oeste de Fortaleza. Faz divisa com os bairros Quintino Cunha, Olavo Oliveira, Jardim Iracema, Padre Andrade, Pici, Dom Lustosa, Autran Nunes, Genibaú e o município de Caucaia.
Avenidas principais: Avenida Mister Hull.
Feiras livres: Feira do Antônio Bezerra, na rua Vale Costa com José Leite Gondim, aos domingos.
Ecopontos: Rua Dr. João Guilherme
Cemitérios: Cemitério do Antônio Bezerra - (Santo Antônio)
IDH (IBGE): 0,348
ESPORTE
Areninha do Antônio Bezerra; Mini Areninha Edgar Mendes Filho, na Praça Ipiranga
ATIVIDADE SOCIAL
Instituto de Arte e Cidadania do Ceará (IAC-CE)Criado em 1988 como Associação Cultural Beneficente Manoel Jacinto Coelho, quando atendia crianças e adolescentes do Quintino Cunha e arredores. Em 2016, a Associação passou por reformulações que resultaram na mudança do nome e de endereço da sede para o Antônio Bezerra. Agregou novos públicos, Prestando atendimento a idosos, mulheres e comunidade.
IGREJAS
Igreja de Jesus, Maria, José. Rua Rui Monte, 95 - Antônio Bezerra, Fortaleza.
SAÚDE
Posto de Saúde- Humberto Bezerra; posto de Saúde Meton de Alencar; Frotinha do Antônio Bezerra
PRAÇAS
Praça Joaquim Nogueira, Praça Ipiranga, Praça São Francisco das Chagas
MEIO AMBIENTE
Rio Maranguapinho
EDUCAÇÃO
EEMTI Antônio Bezerra; EMEIEF Deputado Gerôncio Bezerra; EEFM José Bezerra de Menezes; EEFM Patronato Sagrada Família; EMEIEF Joaquim Nogueira; EEFM Mário Hugo Cidrack do Vale; EMEIEF Prof. Gerardo Milton de Sá; CEJA Prof. Maria Eudes Veras; EMEIEF Pe. Josefino Cabral.
124 NOSSOS BAIRROS | NOSSA FORTALEZA
Bairro Antônio Bezerra reúne rodoviária e diversas linhas de ônibus para acesso à RMF
CULTURA
Bibliotecas: Biblioteca Comunitária Okupação
Centros culturais: IAC-CE
SEGURANÇA
Juizados: 1ª Unidade do Juizado Especial Cívil de Fortaleza (Rua Dr. João Guilherme, 257)

AIS: 6
TRANSPORTE PÚBLICO
Ônibus: Cj Ceará/Antônio Bezerra I; Antônio Bezerra/Lagoa/Unifor; Antônio Bezerra/Messejana; Antônio Bezerra/ Papicu; Corujão/Av. Paranjana I; Antônio Bezerra/Francisco Sá/Papicu; Grande Circular I; Corujão/Grande Circular I; Corujão/Jardim Iracema; Corujão/Jardim Guanabara/N Assunção II; Antônio Bezerra/Mucuripe; Antônio Bezerra/ Parangaba; Antônio Bezerra/Unifor; Cj Ceará/Aldeota/Papicu; Antônio Bezerra/Náutico; Cj Ceará/Antônio Bezerra II; Antônio Bezerra/Messejana/Perimetral; Bezerra de Menezes/Santos Dumont; Antônio Bezerra/Albert Sabin; Antônio Bezerra/Papicu/Praia de Iracema; Antônio Bezer-
ra/Siqueira; Vila do Mar/Náutico/Antônio Bezerra I; Vila do Mar/Náutico/Antônio Bezerra II/SFS; Antônio Bezerra/Lagoa/Parangaba; Antônio Bezerra/Centro/BRT; Dom Lustosa/Antônio Bezerra; Quintino Cunha/Antônio Bezerra; Vila Velha/Antônio Bezerra; Jardim Guanabara/Cj Nova Assunção II; Estação/Pio Saraiva I; Autran Nunes; Antônio Bezerra; Estação/Pio Saraiva II; Av. Sargento Hermínio; Antônio Bezerra/Papicu/Antônio Sales; João Arruda/ Antônio Bezerra; Antônio Bezerra/Parangaba/Montese; Antônio Bezerra/Jovita Feitosa/Centro; Barra do Ceará/ Antônio Bezerra; Santos Dumont/Perimetral; Vila Velha/ Centro; Bezerra de Menezes/Washington Soares
Trem/Metrô: Estação Antônio Bezerra (linhas oeste)
ÁREA EDIFICADA (M2)
Inscrições Residenciais: 5.903
Inscrições Comerciais: 1.139

Inscrições de Prestação de Serviços: 64
Inscrições Industriais: 17
Assentamentos precários: Conj. Resid.Hipolito Pamplona/ S. vicente de Paula / RFFSA /BR-222; Tupinamba da Frota I; Comunidade Alto do Bode; Rua Pedro Melo; Rua Tenente Viena; Comunidade Travessa Maranguapinho.
125 REGIONAL 3
THAIS MESQUITA
BAIRRO ELLERY
O Ellery é um pequeno bairro localizado entre o Noroeste e o Centro de Fortaleza. Começou a ser habitado na década de 1940, mas se tornou bairro nos anos 1960. O nome foi inspirado por uma parada de ônibus que ia para a região e chamava-se Vila Ellery, em razão do sobrenome da família que ali morava.
O bairro tem origem humilde. Por muito tempo o Ellery teve problemas de alagamento em um trecho erguido em cima de uma lagoa, aterrada pelos primeiros moradores para construírem suas residências. As melhorias vieram com o tempo e por meio de muitas lutas dos moradores por urbanização, transporte, saneamento e outros serviços públicos.
Além das áreas de lazer no próprio território, há espaços nos bairros vizinhos bastante utilizados pela população local, como a praça Manoel Dias Branco, no Monte Castelo, e o shopping RioMar Kennedy, no Presidente Kennedy.
DADOS GERAIS
População estimada: 7.863

População Feminina: 4.319
População Masculina: 3.544
Densidade (hab/km²): 16.982,72
Área total: 0,46
Perímetro (km): 2.747,79
Localização geográfica: Regional III, na parte oeste de Fortaleza. Faz divisa com os bairros Álvaro Weyne, Carlito Pamplona, Monte Castelo, São Gerardo e Presidente Kennedy.
Avenidas principais: Avenida Sargento Hermínio; Avenida Tenente Lisboa.
IDH: 0,416
ATIVIDADE SOCIAL
Instituto Construir (ICON)- É uma organização sem fins lucrativos que incentiva práticas e estilo de vida
saudável com foco no desenvolvimento humano e no respeito, proteção e garantia dos direitos humanos a crianças, adolescentes, jovens e idosos. O Instituto fica localizado na Rua Professor Joaquim Antônio, 45 - casa 85 e traz diversas atividades culturais, além de contar com uma biblioteca com mais de mil livros.
IGREJAS
Ministério Canaã - Monte Castelo (Av. Sargento Hermínio de Sampaio, 2350); Igreja Adventista do Ellery (Rua Capitão Nestor Góis, 60)
PRAÇAS
Praça Edson Emiliano (Rua Capitão Nestor Góis, S/N)
EDUCAÇÃO
Escola EMEIEF Honório Bezerra
SEGURANÇA
AIS: 4
TRANSPORTE PÚBLICO
Ônibus: Antônio Bezerra/Unifor; Santa Maria/Bairro Ellery/Centro; Av. Sargento Hermínio
Trem/Metrô: Estação Álvaro Weyne (Linha oeste)
ÁREA EDIFICADA (M2)
Inscrições Residenciais: 1.899
Inscrições Comerciais: 354
Inscrições de Prestação de Serviços: 13
Inscrições Industriais: 5
Assentamentos precários: -
126 NOSSOS BAIRROS | NOSSA FORTALEZA


127 REGIONAL 3
AURÉLIO ALVES
Praça Edson Emiliano é opção de lazer no Bairro Ellery
FARIAS BRITO
O Farias Brito, mais conhecido pelos moradores como Otávio Bonfim, compõe a Regional 3 e possui uma localização privilegiada, fazendo fronteira com os tradicionais bairros Benfica e Centro.
O local onde o bairro está hoje começou a ser povoado na década de 1920 ao redor da estrada do Soure (hoje Avenida Bezerra de Menezes), que ligava Fortaleza a Caucaia. Passou a ser conhecido como Otávio Bonfim em homena-
gem a um engenheiro da Rede de Viação Cearense, que instalou no local uma estação de ônibus, mesmo que o nome oficial do local sempre tenha sido Farias Brito.

O fluxo de veículos no bairro é bem intenso por conta da grande movimentação pela Avenida Bezerra de Menezes e na Avenida Domingos Olímpio. Também é um local valorizado para se morar. A Igreja de Nossa Senhora das Dores, erguida em 1932, é o grande cartão postal do local.

128 NOSSOS BAIRROS | NOSSA FORTALEZA
Igreja Nossa Senhora das Dores é cartão postal do bairro Farias Brito
AURÉLIO ALVES
DADOS GERAIS
População estimada: 12.063
População Feminina: 6.663
População Masculina: 5.400
Densidade (hab/km²): 12.957,04
Área total (km²): 0,93
Perímetro (km): 4.922,54
Localização geográfica: Regional III, na parte oeste de Fortaleza. Faz divisa com os bairros Centro, Jacarecanga, Monte Castelo, São Gerardo, Parquelândia, Parque Araxá, Rodolfo Teófilo e Benfica.
Avenidas principais: Avenida Bezerra de Menezes, Avenida Domingos Olímpio, Avenida José Jatahy.
IDH: 0,500
ATIVIDADE SOCIAL
Grupo de Interesse Ambiental (GIA) - É uma entidade do terceiro setor, sem fins lucrativos, com qualificação de Organização da Sociedade Civil de Interesse Público (OSCIP). Fica na Rua Justiniano de Serpa, 321.
O GIA tem como missão: contribuir para a conservação e gestão sustentável do meio ambiente, adaptando-se às novas tendências tecnológicas, socioambientais, educacionais, turísticas e culturais para construir uma sociedade comprometida com a defesa do meio ambiente.
IGREJAS
Igreja Nossa Senhora das Dores, Igreja Nossa Senhora das Graças, Igreja Universal do Reino de Deus (Rua Rúbia Sampaio, 1160)
SAÚDE
Policlínicas: Hospital e Maternidade José Martiniano de Alencar
PRAÇAS
Praça Otávio Bonfim, Calçadão Crasa, Bosque dos Ferroviários
EDUCAÇÃO
Escolas: EMEIF Frei Lauro Schwartz, EEM Dr. César Cals, Associação de Cegos do Estado do Ceará (ACEC)
Museus: Instituto Tembetá
SEGURANÇA
Delegacias: Delegacia de Polícia Civil - 3° Distrito Policial AIS: 4
TRANSPORTE PÚBLICO
Ônibus: Circular 1/Centro; Antônio Bezerra/Messejana; Antônio Bezerra/Papicu; Cuca Barra/Parangaba; Antônio Bezerra/Mucuripe; Antônio Bezerra/Unifor; Cj Ceará/Aldeota/Papicu; Parangaba/Mucuripe; Antônio Bezerra/Náutico; Bezerra de Menezes/Santos Dumont; Antônio Bezerra/Albert Sabin; Antônio Bezerra/Centro/ BRT; Antônio Bezerra/Papicu/Antônio Sales; Antônio Bezerra/Parangaba/Montese; Bela Vista/Centro; Itaóca/Jardim América/Centro; Genibaú/Centro; Siqueira/ José Bastos/Centro; Siqueira/João Pessoa/Centro; Parangaba/José Bastos/Centro; Antônio Bezerra/Jovita Feitosa/Centro; Parangaba/João Pessoa/Centro; Parangaba/Expedicionários/Centro; Aeroporto/Benfica/ Rodoviária/Centro; Cj Ceará/Centro; Santos Dumont/ Perimetral; Granja Lisboa/Goiabeiras; Vila Velha/Centro; Bezerra de Menezes/Washington Soares
ÁREA EDIFICADA (M2)
Inscrições Residenciais: 3.140
Inscrições Comerciais: 1.013

Inscrições de Prestação de Serviços: 74
Inscrições Industriais: 3
Assentamentos precários: Comunidade da Rua Larga; Comunidade Beco dos Pintos; Vila Condessa.
129 REGIONAL 3
MONTE CASTELO
O Monte Castelo é mais um bairro majoritariamente residencial da Regional 3, mas também possui intensa atividade comercial, principalmente, nos arredores da Avenida Sargento Hermínio.
O bairro foi fundado em 1945 pelo então prefeito Raimundo Alencar Araripe e recebeu esse nome em homenagem à vitória dos brasileiros na Batalha de Monte Castello, na Itália, durante a Segunda Grande Guerra Mundial.
Hoje o bairro é bem equipado com áreas de lazer e tem fácil acesso à parte central da Cidade, também pela Avenida Sargento Hermínio.
DADOS GERAIS
População estimada: 13.215
População Feminina: 7.097
População Masculina: 6.118
Densidade (hab/km²): 16.985,86
Área total: 0,78 km²
Perímetro (km): 4.781,37
Localização geográfica: Regional III, na parte oeste de Fortaleza. Faz divisa com os bairros Ellery, São Gerardo, Farias Brito, Jacarecanga e Carlito Pamplona
Avenidas principais: Avenida Sargento Hermínio, Avenida José Jatahy
Ecopontos: R. Gonçalo de Lagos, S/N. Em frente ao açude João Lopes
IDH: 0,435
ATIVIDADE SOCIAL

Casa da Infância e da Adolescência - É um equipamento público da rede de proteção social a crianças e adolescentes, que busca contribuir com o psicossocial, motivando esses jovens a possibilidades e oportunidades para um futuro mais digno.
O local, na Rua João Tomé, 261, possui espaço humani-
zado de atendimento, auditório, refeitório e brinquedoteca destinados às crianças. O intuito é auxiliar no resgate pedagógico, psicológico e terapêutico.
IGREJAS
Igreja do Senhor do Bonfim; Igreja Nossa Senhora de Lourdes
PRAÇAS
Praça João Pontes; Praça Manoel Dias Macedo; Calçadão do Açude João Lopes
MEIO AMBIENTE
Rios ou lagoas: Açude João Lopes
EDUCAÇÃO
Escolas (seduc): EEFM Cláudio Martins, EMEIEF Martinz de Aguiar, EMEIEF Faustino de Albuquerque, EEEP Dona Creusa do Carmo Rocha, Emeif Lenira Jurema Magalhães, Creche Conveniada Favo De Mel
CULTURA
Teatros: Teatro Acontece - Escola Livre de Teatro
SEGURANÇA
Delegacias: Delegacia de Polícia Civil | 1° Distrito
Policial
AIS: 4
TRANSPORTE PÚBLICO
Ônibus: Antônio Bezerra/Unifor; Santa Maria/ Bairro Ellery/Centro; Av. Sargento Hermínio; Granja Lisboa/Goiabeiras
130 NOSSOS BAIRROS | NOSSA FORTALEZA
ÁREA EDIFICADA (M2)
Inscrições Residenciais: 3.287
Inscrições Comerciais: 658

Inscrições de Prestação de Serviços: 32
Inscrições Industriais: 0
Assentamentos precários: Vila Caminha; Fernando Weyne; Comunidade do Canal/Açude João Lopes (ou pousada do Socó); Novo Tempo I; Rua S. do Bonfim.

131 REGIONAL 3
Praça Manoel Dias Macedo
AURÉLIO ALVES
OLAVO OLIVEIRA
O Olavo Oliveira é um pequeno bairro, majoritariamente residencial, que fica na parte Oeste de Fortaleza. Foi parte do Grande Antônio Bezerra até 1968, quando foi reconhecido como bairro no local que antes era chamado de Parque de Boatan e, posteriormente, passou a ser uma comunidade dentro do Quintino Cunha.
O nome Olavo Oliveira é uma homenagem ao professor, escritor, advogado e político que faleceu em 1966.
Hoje, o bairro carece de pontos de convivência, mas tem um bom fluxo de transporte público devido à proximidade com o Terminal do Antônio Bezerra.
DADOS GERAIS
População estimada: 47.277

População Feminina: Não registrado pelo censo
População Masculina: Não registrado pelo censo
Densidade (hab/km²): Não registrado pelo censo
Área total: 0,71
Perímetro (km): 3.672,69
Obs: O Censo de 2010 considerou o perímetro da Olavo Oliveira como sendo Quintino Cunha.
Localização geográfica: Regional III, na parte oeste de Fortaleza. Faz divisa com os bairros Quintino Cunha, Vila Velha, Jardim Guanabara, Jardim Iracema, Padre Andrade e Antônio Bezerra
Avenidas principais: Avenida Tenente Lisboa, Avenida Independência.
IDH: Não registrado pelo censo
ATIVIDADE SOCIAL
Comunidade Educacional Padre Anchieta (COPAN-CE)Localizada na Rua Francisco Mendes de Oliveira, 933, é uma entidade filantrópica sem fins lucrativos, de caráter educacional, cultural e assistencial. Tem como objetivo dar condições de estudo e moradia a crianças e jovens carentes da Capital cearense e do interior do Ceará.
A Copan realiza frequentemente ações e programas de cunho social, educativo, ambiental, cultural e esportivo para crianças, adolescentes, jovens e famílias em situação de vulnerabilidade social.
Essas ações e programas desenvolvidos pela entidade têm como eixo principal a sustentabilidade. Em todas as atividades realizadas no local, trabalham-se bastante o resgate da cultura local, a consciência com o meio ambiente e preservação dos recursos naturais.

IGREJA
Igreja de São José
132 NOSSOS BAIRROS | NOSSA FORTALEZA
O bairro Olavo Oliveira é majoritariamente residencial
SAÚDE

Postos de Saúde: Posto de Saúde Hermínia Leitão
PRAÇA
Praça da Independência
EDUCAÇÃO
Escolas (seduc): EMEIEF Prof. Denizard Macêdo de Alcântara.
SEGURANÇA
AIS: 6
TRANSPORTE PÚBLICO
Ônibus: Corujão/Av. Paranjana I; Antônio Bezerra/ Francisco Sá/Papicu; Grande Circular I; Corujão/Gran-
de Circular I; Corujão/Jardim Iracema; Corujão/Jardim Guanabara/N Assunção II; Antônio Bezerra/Papicu/ Praia de Iracema; Vila do Mar/Náutico/Antônio Bezerra I; Vila do Mar/Náutico/Antônio Bezerra II/SFS; Quintino Cunha/Antônio Bezerra; Vila Velha/Antônio Bezerra; Jardim Guanabara/Cj Nova Assunção II; Barra do Ceará/Antônio Bezerra; Barra do Ceará/Cais do Porto
Trem/metrô: Estação Antônio Bezerra (linha oeste)
ÁREA EDIFICADA (M2)
Inscrições Residenciais: Não registrado pelo censo
Inscrições Comerciais: Não registrado pelo censo
Inscrições de Prestação de Serviços: Não registrado pelo censo
Inscrições Industriais: Não registrado pelo censo
Assentamentos precários: Gonçalves / Maranguapinho II; Antenas; Rua Moura da Silva; Rua João Tinoco, Conjunto Mangueiral; José Goiania (Santa Filomena);Transbordo; Emília Gonçalves/ Maranguapinho.

133 REGIONAL 3
FERNANDA BARROS
PADRE ANDRADE
O Padre Andrade é um bairro conhecido pelo seu grande fluxo rodoviário, principalmente por meio do Terminal Antônio Bezerra, que pertence ao distrito, mesmo que carregue o nome do bairro vizinho.
A comunidade era chamada de Cachoeirinha até o ano de 1951, mas mudou de nome em homenagem ao padre Francisco Juvêncio Andrade Filho, que morreu jovem, aos 28 anos, afogado no açude Betsaia. Ele era tão querido na região que a própria população solicitou a transferência de nomenclatura à Câmara Municipal.
Hoje, é um bairro bastante comercial e também é conhecido pelo Colégio da Polícia Militar e pelo clube de futebol Associação Esportiva Tiradentes.
DADOS GERAIS
População estimada: 12.936

População Feminina: 7.024
População Masculina: 5.912
Densidade (hab/km²): 10.234,18
Área total: 1,26
Perímetro (km): 5.464,82
Localização geográfica: Regional III, território 12, na parte oeste de Fortaleza. Faz divisa com os bairros Antônio Bezerra, Olavo Oliveira, Jardim Iracema, Floresta, Presidente Kennedy e Pici
Avenidas principais: Avenida Mister Hull, Avenida Sargento Hermínio, Avenida Tenente Lisboa
IDH (IBGE): 0,361
ATIVIDADE SOCIAL
Instituto Fazendo Acontecer (IFA) - É uma ONG sem fins lucrativos que atua em Fortaleza desde 2007. O projeto trabalha na defesa dos direitos de crianças, pessoas com deficiências, idosos, mulheres vítimas de violência e de quem mais estiver em estado de hi-
possuficiência diante do Estado.
O Instituto busca treinar o olhar das pessoas para a complexidade social, política, emocional e cognitiva, com atividades esportivas, artísticas, dentre outras.
IGREJAS
Igreja Nossa Senhora Mãe da Igreja, Assembléia de Deus Templo Central,
SAÚDE
Postos de Saúde: Posto de Saúde Professor Clodoaldo Pinto
EDUCAÇÃO
Escolas: E.E.F.M. Monsenhor Dourado, EMEIEF Narcisa Borges, Centro De Educação Infantil Professor Clodoaldo Pinto, Centro de Educação Infantil Altamir Fernandes Correa Leite.
SEGURANÇA
AIS: 6
TRANSPORTE PÚBLICO
Ônibus: Ceará/Antônio Bezerra I; Antônio Bezerra/ Lagoa/Unifor; Antônio Bezerra/Messejana; Antônio Bezerra/Papicu; Corujão/Av. Paranjana I; Corujão/Av. Paranjana II; Antônio Bezerra/Francisco Sá/Papicu; Grande Circular I; Grande Circular II; Corujão/Grande Circular I; Corujão/Grande Circular II; Corujão/Jardim Iracema; Corujão/Jardim Guanabara/N Assunção II; Antônio Bezerra/Mucuripe; Antônio Bezerra/Parangaba; Antônio Bezerra/Unifor; Cj Ceará/Aldeota/Papicu; Antônio Bezerra/Náutico; Cj Ceará/Antônio Bezerra II; Antônio Bezerra/Messejana/Perimetral; Bezerra
134 NOSSOS BAIRROS | NOSSA FORTALEZA
de Menezes/Santos Dumont; Antônio Bezerra/Albert Sabin; Expresso/Antônio Bezerra/Parangaba; Antônio Bezerra/Papicu/Praia de Iracema; Antônio Bezerra/ Siqueira; Vila do Mar/Náutico/Antônio Bezerra I; Vila do Mar/Náutico/Antônio Bezerra II/SFS; Antônio Bezerra/Lagoa/Parangaba; Antônio Bezerra/Centro/ BRT; Dom Lustosa/Antônio Bezerra; Padre Andrade/ Antônio Bezerra; Quintino Cunha/Antônio Bezerra; Vila Velha/Antônio Bezerra; Jardim Guanabara/Cj Nova Assunção II; Estação/Pio Saraiva I; Autran Nunes; Antônio Bezerra; Estação/Pio Saraiva II; Av. Sargento Hermínio; Antônio Bezerra/Papicu/Antônio Sales; João Arruda/Antônio Bezerra; Antônio Bezerra/ Parangaba/Montese; Antônio Bezerra/Jovita Feitosa/ Centro; Barra do Ceará/Antônio Bezerra; Santos Du-
mont/Perimetral; Vila Velha/Centro; Bezerra de Menezes/Washington Soares
Trem/metrô: Estação Padre Andrade (linha oeste)

ÁREA EDIFICADA (M2)
Inscrições Residenciais: 2.675
Inscrições Comerciais: 503

Inscrições de Prestação de Serviços: 37
Inscrições Industriais: 9
Assentamentos precários: Unidos Venceremos, Guararapes (CIC), Rua Itamarati, Roguinho, Buraco da Gia, Rua Cetama, Rua Nicaragua.
135 REGIONAL 3
Terminal Antônio Bezerra, apesar do nome, fica no bairro Padre Andrade
FERNANDA BARROS
A Parquelândia é um dos bairros mais tradicionais da Capital, surgiu na década de 1950
PARQUELÂNDIA
A Parquelândia é um dos bairros mais tradicionais de Fortaleza. Surgiu na década de 1950, sendo antes chamada de Coqueirinho em referência à área verde predominante na época.
Posteriormente, a região se tornou Amadeu Furtado, e o território foi dividido para o surgimento da Parquelândia. O nome faz alusão a um grande loteamento conhecido por esse nome e que caiu no gosto popular.

Está localizado na parte Oeste da cidade, mas com fácil acesso ao Centro.
É uma região bastante valorizada e movimentada,
inclusive, com grande fluxo de pessoas na vida noturna por seus bares e restaurantes.
Hoje o bairro é um dos mais prósperos de Fortaleza. Apresenta adensamento populacional, mas, também, uma série de facilidades, como escolas, restaurantes, entre outras programações para todos os gostos.
O bairro se desenvolveu tanto que outros estabelecimentos e equipamentos em territórios vizinhos são atrelados à Parquelândia, como é o caso da Igreja Redonda, no bairro Amadeu Furtado.

136 NOSSOS BAIRROS | NOSSA FORTALEZA
DADOS GERAIS
População estimada: 14.432
População Feminina: 8.149
População Masculina: 6.283
Densidade (hab/km²): 11.666,94
Área total: 1,24
Perímetro (km): 5.756,35
Localização geográfica: Regional III, Território 14, na parte oeste de Fortaleza. Faz divisa com os bairros Amadeu Furtado, Rodolfo Teófilo, Parque Araxá, São Gerardo, Presidente Kennedy e Pici.
Avenidas principais: Avenida Bezerra de Menezes, Avenida Jovita Feitosa, Avenida Humberto Monte.
IDH: 0,628
ATIVIDADE SOCIAL

Fundação Cepema - Foi criada em 1989, com apoio da ONG sueca Framtidsjorden (Terra do Futuro), e hoje funciona na Rua Crateús, 1250.
O espaço trabalha com a divulgação das técnicas da agricultura ecológica, com a realização de cursos, seminários e assistência técnica rural e florestal envolvendo os agricultores familiares e os assentados da reforma agrária.
Além disso, o projeto também atua nas áreas urbanas, com programas que promovem as culturas periféricas com foco no protagonismo juvenil, e na área de cidades sustentáveis com foco na resiliência ambiental dos espaços urbanos. Tudo isso por meio de seminários e colaboração em pesquisas e estudos.

137 REGIONAL 3
FOTOS FERNANDA BARROS


138 NOSSOS BAIRROS | NOSSA FORTALEZA
Avenida Bezerra de Menezes é uma das principais do bairro Parquelândia
IGREJAS
Comunidade Católica Shalom - Parquelândia, Igreja Batista da Graça - IBG Fortaleza.
EDUCAÇÃO
Escolas (seduc): EEEP Joaquim Nogueira
CULTURA
Centros culturais: Galpão Cultural Terreiro Aki de Casa
SEGURANÇA
AIS: 6
TRANSPORTE PÚBLICO
Ônibus: Antônio Bezerra/Messejana; Antônio Bezerra/Papicu; Parquelândia/Parangaba; Antônio Bezerra/Mucuripe; Campus do Pici/Unifor; Cj Ceará/ Aldeota/Papicu; Antônio Bezerra/Náutico; Francisco Sá/Parangaba; Bezerra de Menezes/Santos Dumont; Antônio Bezerra/Albert Sabin; Santa Maria/Bairro Ellery/Centro; Antônio Bezerra/Centro/BRT; Antônio Bezerra/Papicu/Antônio Sales; Antônio Bezerra/ Parangaba/Montese; Rodolfo Teófilo/José Bastos/ Centro; Antônio Bezerra/Jovita Feitosa/Centro; 703 Paupina/Pici; Santos Dumont/Perimetral; Vila Velha/Centro; Bezerra de Menezes/Washington Soares
ÁREA EDIFICADA (M2)
Inscrições Residenciais: 4.619
Inscrições Comerciais: 1.613


Inscrições de Prestação de Serviços: 107
Inscrições Industriais: 8
Assentamentos precários: -
139 REGIONAL 3
PARQUE ARAXÁ
O Parque Araxá é um pequeno bairro entre o lado Oeste e o Centro de Fortaleza. É muito conhecido pela vida noturna por causa dos bares e restaurantes.
O bairro surgiu nos anos 1950 e tem uma história curiosa, porque tem relação com um poço na região que tinha uma água tão limpa que as pessoas acreditavam ter poderes medicinais.
A partir daí, uma imobiliária começou a vender lotes nos arredores do local com o nome “Loteamento Araxá”, fazendo alusão a uma cidade mineira conhecida pelas fontes termais.

Com isso, o nome foi sendo difundido pela comunidade local até o bairro passar a ser conhecido como Parque Araxá.
Hoje, é um bairro bem localizado, com fácil acesso ao Centro, mas que passa despercebido por ser confundido com seus vizinhos gigantes Parquelândia e Rodolfo Teófilo.
DADOS GERAIS
População estimada: 6.715

140 NOSSOS BAIRROS | NOSSA FORTALEZA
Parque Araxá tem intensa vida noturna por causa dos bares e restaurantes no bairro
FERNANDA BARROS
População Feminina: 3.796
População Masculina: 2.919
Densidade (hab/km²): 14.077,57
Área total: 0,48 km2
Perímetro (km): 3.167,65
Localização geográfica: Regional III, Território 14, na parte oeste de Fortaleza. Faz divisa com os bairros Rodolfo Teófilo, Amadeu Furtado, Parquelândia, São

Gerardo e Farias Brito.
Avenidas principais: Avenida Bezerra de Menezes, Avenida Jovita Feitosa, Avenida José Jatahy.
IDH (IBGE): 0,587
ATIVIDADE SOCIAL
Escola Estadual de Educação Profissional Presidente Roosevelt - Foi uma das primeiras escolas de educação profissional do Ceará. Criada em 2009, no local onde existia o Grupo Escolar Presidente Roosevelt, que deu nome à escola. Na Av. Bezerra de Menezes, 435, passou a funcionar com a sistemática de capacitar jovens para o mercado de trabalho.
EDUCAÇÃO
Escolas (seduc): EEEP Presidente Roosevelt.
SEGURANÇA
AIS: 6
TRANSPORTE PÚBLICO
Ônibus: Antônio Bezerra/Messejana; Antônio Bezerra/ Papicu; Antônio Bezerra/Mucuripe; Campus do Pici/ Unifor; Cj Ceará/Aldeota/Papicu; Antônio Bezerra/Náutico; Bezerra de Menezes/Santos Dumont; Antônio Bezerra/Albert Sabin; Santa Maria/Bairro Ellery/Centro; 200 Antônio Bezerra/Centro/BRT; Antônio Bezerra/Papicu/ Antônio Sales; Antônio Bezerra/Parangaba/Montese; Antônio Bezerra/Jovita Feitosa/Centro; Paupina/Pici; Santos Dumont/Perimetral; Vila Velha/Centro; Bezerra de Menezes/Washington Soares
ÁREA EDIFICADA (M2)
Inscrições Residenciais: 1.965
Inscrições Comerciais: 416

Inscrições de Prestação de Serviços: 25
Inscrições Industriais: 2
Assentamentos precários: Parque Araxá.
141 REGIONAL 3
PRESIDENTE KENNEDY
O Presidente Kennedy é um tradicional bairro localizado na parte Oeste de Fortaleza. É uma das regiões mais emergentes da Cidade, principalmente, por seus shoppings e pelo novo Parque Rachel de Queiroz.
O bairro tem sua origem na década de 1950, sendo ponto de ocupação por populações vindas do Interior.
Antes era conhecido como Monte Picuí, mas teve sua nomenclatura oficial mudada como homenagem ao presidente estadunidense John Kennedy, assassinado em 1963, em Dallas (EUA).
É um bairro com grande força comercial, que o tornam autossuficiente, mas que também possui fácil acesso para as regiões mais centrais da Cidade. Em
2016, o Grupo JCPM inaugurou o RioMar Kennedy. O shopping além de ter promovido a valorização imobiliária do entorno, realiza diversas atividades sociais e é uma opção de lazer para o bairro e adjacências.

DADOS GERAIS
População estimada: 23.004

População Feminina: 12.677
População Masculina: 10.327
Densidade (hab/km²): 13.405,59
Área total: 1,72 km²
142 NOSSOS BAIRROS | NOSSA FORTALEZA
Presidente Kennedy tem área verde e empreendimentos comerciais que atendem todo o entorno
AURÉLIO ALVES
Perímetro (km): 5.637,17
Localização geográfica: Regional III, Território 12, na parte oeste de Fortaleza. Faz divisa com os bairros Padre Andrade, Floresta, Álvaro Weyne, Ellery, São Gerardo, Parquelândia e Pici.
Avenidas principais: Avenida Bezerra de Menezes, Avenida Sargento Hermínio, Avenida Governador
Parsifal Barroso
IDH: 0,429
ESPORTE
Areninha Praça Rachel de Queiroz
ATIVIDADE SOCIAL

Projeto Comunitário Sorriso da Criança - É uma entidade de base comunitária e filantrópica, localizada na rua do Planalto, 167. Atende crianças e jovens de 7 a 24 anos com atividades no contraturno escolar, no intuito de contribuir com seu desenvolvimento escolar e pessoal, além de evitar que os mesmos fiquem ociosos e vulneráveis aos “apelos da rua”.
IGREJAS
Igreja de Nossa Senhora de Lourdes, Igreja De Jesus Cristo Dos Santos Dos Ultimos Dias, Igreja Pentecostal Ebenezer.
SAÚDE
Postos de Saúde: Posto de Saúde Ivana de Souza Paes
PRAÇAS
Praça dos Gatos, Pracinha do Riomar Kennedy, Praça Francisca Zélia.
MEIO AMBIENTE
Parques: Parque Rachel de Queiroz
EDUCAÇÃO
Escolas (seduc): EMEIEF Gabriel Cavalcante, EMTI Prof. Joaquim Francisco de Sousa Filho, CEJA Paulo Freire.
CULTURA
Cinemas: Kinoplex North Shopping, Cinépolis RioMar Kennedy
SEGURANÇA
Delegacia: Delegacia da Criança e do Adolescente - DCA
Juizados: 5ª Vara da Infância e da Juventude
AIS: 6
TRANSPORTE PÚBLICO
Ônibus: Antônio Bezerra/Messejana; Antônio Bezerra/ Papicu; Parquelândia/Parangaba; Antônio Bezerra/ Mucuripe; Antônio Bezerra/Unifor; Campus do Pici/ Unifor; Cj Ceará/Aldeota/Papicu; Antônio Bezerra/Náutico; Francisco Sá/Parangaba; Bezerra de Menezes/ Santos Dumont; Antônio Bezerra/Albert Sabin; Santa Maria/Bairro Ellery/Centro; Antônio Bezerra/Centro/ BRT; Av. Sargento Hermínio; Antônio Bezerra/Papicu/ Antônio Sales; Antônio Bezerra/Parangaba/Montese; Antônio Bezerra/Jovita Feitosa/Centro; Paupina/Pici; Barra do Ceará/Antônio Bezerra; Santos Dumont/Perimetral; Vila Velha/Centro; Bezerra de Menezes/Washington Soares
ÁREA EDIFICADA (M2)
Inscrições Residenciais: 6.022
Inscrições Comerciais: 1.579
Inscrições de Prestação de Serviços: 24
Inscrições Industriais: 1
Assentamentos precários: Rua Carlindo Cruz; IMOTIL; Travessa Araújo; São Francisco; Conj. Pres. Castelo Branco; Frei Odilon ou Cajueiro das Velhas; São Sebastião ou Unidos dos Moradores do Presidente Kennedy; Virgília Brígido; Rodolfo; área 2.000 (2.001); Cidade 2.000; Rua Internacional.
143 REGIONAL 3
QUINTINO CUNHA
Localizado também na parte Oeste de Fortaleza, o Quintino Cunha é um bairro dividido em conjuntos habitacionais. Tem uma grande extensão territorial e faz divisa com o município de Caucaia, sendo separado pelo Rio Maranguapinho.


O bairro é majoritariamente residencial, mas, por ser distante da área central da Cidade, é autossustentável, possuindo uma boa quantidade de comércios e
fábricas, principalmente na parte de confecção têxtil.
O nome Quintino Cunha é uma homenagem ao advogado, poeta e escritor cearense que nasceu em Itapajé, mas viveu em Fortaleza.
Bastante conhecido por seu estilo irreverente e carismático, o poeta Quintino Cunha também é lembrado pelas anedotas que contava. Quintino faleceu em 1943, em Fortaleza.
144 NOSSOS BAIRROS | NOSSA FORTALEZA
THAIS MESQUITA
Paróquia São Francisco de Assis fica na rua dos Pescadores, 145
DADOS GERAIS
População estimada: 47.277
População Feminina: 24.806
População Masculina: 22.471
Densidade (hab/km²): 22.143,79
Área total: 2,14
Perímetro (km): 9.195,27
Obs: O Censo de 2010 considerou o perímetro do Olavo Oliveira como sendo Quintino Cunha.
Localização geográfica: Regional III, Território 11, na parte oeste de Fortaleza. Faz divisa com os bairros Antônio Bezerra, Olavo Oliveira, Vila Velha e o município de Caucaia.
Avenidas principais: Avenida Mozart Pinheiro de Lucena, Avenida Independência,
Feiras livres: Feira do Quintino Cunha (às sextas, na Avenida Mozart Lucena)
IDH: 0,223
ATIVIDADE SOCIAL

Centro Comunitário Conjunto São Francisco - Presta serviços à população em situação de vulnerabilidade social com cursos de qualificação profissional, atividades socioeducativas em grupos para famílias e serviço de convivência e fortalecimento de vínculos para crianças, adolescentes e idosos.
IGREJAS
Paróquia São Francisco de Assis; Igreja Nossa Senhora das Graças; Igreja Universal do Reino de Deus - Quintino Cunha
SAÚDE
Postos de Saúde: Posto de Saúde - Quintino Cunha; Posto de Saúde George Benevides de Medeiros
PRAÇAS
Praça Arapuca, Praça Joaquim Nogueira
MEIO AMBIENTE
Rios ou lagoas: Rio Maranguapinho
EDUCAÇÃO
Escolas (seduc): EMEIEF Maria Cardoso, EMEIRF José Carlos da Costa Ribeiro, EEMTI Maria José Santos Ferreira Gomes, EEFJesus Maria José.
CULTURA
Centros culturais: Espaço Cultural Quartifusa
SEGURANÇA (SSPDS)
AIS: 6
TRANSPORTE PÚBLICO
Ônibus: Corujão/Jardim Guanabara/N Assunção II; Quintino Cunha/Antônio Bezerra; Vila Velha/Antônio Bezerra; Estação/Pio Saraiva I; Estação/Pio Saraiva II; Vila Velha/Centro
ÁREA EDIFICADA (M2)
Inscrições Residenciais: 4.296
Inscrições Comerciais: 747
Inscrições de Prestação de Serviços: 45
Inscrições Industriais: 20
Assentamentos precários: Do Cal Bubu, Santa filomena/ rua São Vincente de Paula, Travessa Brasil, Monte Rei, Favela da Muriçoca, Comunidade Sossego / Muriçoca, Conjunto Mangueiral, Conjunto São Francisco I, Malvinas, Do Corrente/Favela do Canal/alto Jerusalém, Sulamita Portela, Conjunto Quintino Cunha/Pontilândia, Baixada dos Milagres, Ilha Dourada, Aldeota Sul, Santa Edwirges e outras duas áreas sem nome.
145 REGIONAL 3
RODOLFO TEÓFILO
O Rodolfo Teófilo ficou conhecido como Porangabussu até a década de 1960 por causa da lagoa de mesmo nome, mas mudou de título para homenagear o sanitarista, que empreendeu, sem apoio governamental, uma campanha de vacinação para extinguir uma epidemia de varíola que se alastrava em Fortaleza.
Hoje, o Rodolfo Teófilo é autossuficiente, com hospitais, areninhas, escolas e várias áreas de lazer. Além disso, fica próximo da parte central da Cidade.
DADOS GERAIS
População estimada: 19.114
População Feminina: 10.539
População Masculina: 8.575
Densidade (hab/km²): 11.217,14
Área total: 1,70 km2
Perímetro (km): 5.828,26
Localização geográfica: Regional III, Território 14, na parte oeste de Fortaleza. Faz divisa com os bairros Amadeu Furtado, Parquelândia, Parque Araxá, Farias Brito, Benfica, Damas e Bela Vista.
Avenidas principais: Avenida José Bastos, Avenida Humberto Monte, Avenida Jovita Feitosa.
Feiras livres: Feira do Rodolfo Teófilo (às terças, na rua Frei Marcelino com Gustavo Braga)
Ecopontos: Ecoponto Rodolfo Teófilo (Rua Coronel Nunes de Melo & Rua Ana Néri).
IDH: 0,482
ESPORTE
Areninha Rodolfo Teófilo; Areninha Campo do Tigrão
ATIVIDADE SOCIAL:

Fundação Educacional Silvestre Gomes - Foi criada em 1999 por um grupo de moradores do bairro com
o propósito de desenvolver ações educativas, sociais, esportivas e culturais, oferecendo oportunidades de melhoria de vida para as populações de baixa renda.
IGREJAS
Igreja de São Raimundo, Igreja São José Operário, Igreja Nossa Senhora de Lourdes, Igreja Batista - Comunidade do Amor, Congregação Cristã no BrasilRodolfo Teófilo
SAÚDE
Postos de Saúde: Posto de Saúde Anastácio Magalhães, Posto de Saúde Santa Liduína.
PRAÇAS
Praça Nossa Senhora Salete, Praça da Areninha Rodolfo Teófilo.
MEIO AMBIENTE
Rios ou lagoas: Lagoa do Porangabussu
EDUCAÇÃO
Escolas: EEFM Félix de Azevedo, Escola Municipal Antônio Sales, EMEIEF São Raimundo, CEI Francisco
Eurivá Matias, Creche Conveniada Aprisco, Creche Conveniada Nossa Senhora Do Líbano, Creche Conveniada Nova Vida.
CULTURA
Museus: Museu do Parto, Arquivo Nirez.
SEGURANÇA
AIS: 6
146 NOSSOS BAIRROS | NOSSA FORTALEZA
TRANSPORTE PÚBLICO
Ônibus: Campus do Pici/Unifor; Lagoa/Aldeota; Siqueira/Centro/Expresso; Rodolfo Teófilo/José Bastos/Centro; Igreja São Raimundo/Centro; Bela Vista/ Lagoa; Bela Vista/Centro; Lagoa/Demócrito Rocha/ Centro; Genibaú/Centro; Siqueira/José Bastos/Centro; Parangaba/José Bastos/Centro; Jardim Jatobá/ Centro; Antônio Bezerra/Jovita Feitosa/Centro; Paupina/Pici; Cj Ceará/Centro; Granja Lisboa/Goiabeiras
Trem/metrô: Estação Padre Cícero (linha Sul)
ÁREA EDIFICADA (M2)
Inscrições Residenciais 4.600

Inscrições Comerciais: 1.244

Inscrições de Prestação de Serviços: 59
Inscrições Industriais: 8
Assentamentos precários: Beco da Samasa; Valdemiro Cavalcante; Rua Dr. Bezerrinha,; Frei Marcelino.
147 REGIONAL 3
AURÉLIO ALVES
Lagoa do Porangabussu fica no bairro Rodolfo Teófilo
SÃO GERARDO
O bairro São Gerardo era conhecido na década de 1920 como Alagadiço Grande, mas, em 1930, herdou o nome da Igreja de São Gerardo.
O bairro foi crescendo no entorno da capela e hoje é uma região bastante valorizada, com grande número de comércios, principalmente, na Avenida Bezerra de Menezes, além de ter fácil acesso ao Centro.
DADOS GERAIS
População estimada: 14.505
População Feminina: 8.129
População Masculina: 6.376
Densidade (hab/km²): 9.827,24
Área total: 1,48 km2
Perímetro (km): 5.421,62
Localização geográfica: Regional III, Território 13, na parte oeste de Fortaleza. Faz divisa com os bairros Presidente Kennedy, Ellery, Monte Castelo, Farias Brito, Parque Araxá e Parquelândia.
Avenidas principais: Avenida Bezerra de Menezes, Avenida Sargento Hermínio.
Feiras livres: Feira da Sargento Hermínio (aos domingos, no Polo de Lazer Sargento Hermínio)
Ecopontos: Ecoponto São Gerardo (Avenida Projetada Canal, 200)
IDH: 0,594
ESPORTE
Areninha Sargento Hermínio
ATIVIDADE SOCIAL

Instituto Doutor Rocha Lima de Proteção e Assistência à Infância - Uma ONG que oferece, de forma gratuita, serviços de convivência e fortalecimento de vínculos para crianças e adolescentes, contribuindo para o bem-
-estar e formação ética por meio da arte e educação.
IGREJAS
Igreja de São Gerardo, Igreja da Mãe Rainha, Igreja de Nossa Senhora das Graças.
PRAÇAS
Praça Rachel de Queiroz.
MEIO AMBIENTE
Parques: Parque de Exposições Governador César Cals, Bosque do Bem, Polo de Lazer Sargento Hermínio.
Rios ou lagoas: Lagoa do São Gerardo
EDUCAÇÃO
Escolas: EMEIEF Gustavo Barroso.
SEGURANÇA
AIS: 4
TRANSPORTE PÚBLICO
Ônibus: Antônio Bezerra/Messejana; Antônio Bezerra/Papicu; Parquelândia/Parangaba; Antônio Bezerra/Mucuripe; Antônio Bezerra/Unifor; Cj Ceará/ Aldeota/Papicu; Antônio Bezerra/Náutico; Bezerra de Menezes/Santos Dumont; Antônio Bezerra/Albert Sabin; Santa Maria/Bairro Ellery/Centro; Antônio Bezerra/Centro/BRT; Av. Sargento Hermínio; Antônio Bezerra/Papicu/Antônio Sales; Antônio Bezerra/Parangaba/Montese; Barra do Ceará/Antônio Bezerra; Santos Dumont/Perimetral; Vila Velha/Centro; Bezerra de Menezes/Washington Soares
148 NOSSOS BAIRROS | NOSSA FORTALEZA
ÁREA EDIFICADA (M2)
Inscrições Residenciais: 5.512

Inscrições Comerciais: 1.315

Inscrições de Prestação de Serviços: 50
Inscrições Industriais: 2
Assentamentos precários: Beco da Hospedaria; Paque Anastácio/Novo tempo II.
149 REGIONAL 3
AURÉLIO ALVES
Polo de Lazer Sargento Hermínio fica dentro dos limites do bairro São Gerardo
REGIONAL 4

















Uma área de passagens, onde ficam grandes avenidas de Fortaleza: Expedicionários, Borges de Melo, General Osório de Paiva, Domingos Olímpio e Aguanambi. Por aqui passam a grande maioria dos fortalezenzes - são dois terminais de ônibus - e também é intenso o fluxo dos turistas que chegam ao Ceará por meio do Aeroporto Internacional de Fortaleza













 Santuário de Nossa Senhora de Fátima no Bairro de Fátima
Santuário de Nossa Senhora de Fátima no Bairro de Fátima































GUIA DA REGIONAL 4

BAIRROS
Aeroporto

Bairro de Fátima
Benfica
Bom Futuro
Damas
Itaoca
Jardim América
José Bonifácio, Montese
Parangaba
Parreão
Vila Peri
Vila União
152 NOSSOS BAIRROS | NOSSA FORTALEZA
AURÉLIO ALVES
O bairro José Bonifácio tem um dos cruzamentos mais movimentados da Cidade
SECRETARIA REGIONAL 4
Endereço: Rua José Felício de Souza, 2600 - Vila União
Fortaleza - CE, 60415-170
Secretário: Adams Gomes

Empresário há mais de dez anos no mercado alimentício e de entretenimento. Concludente do curso de Administração de Empresas, foi superintendente adjunto da Autarquia de Urbanismo e Paisagismo de Fortaleza (UrbFor) de 2017 a 2020. Ocupa a primeira suplência de vereador na legislatura da Câmara Municipal de Fortaleza.
CONTATOS IMPORTANTES
GABINETE
Telefone: (85) 3469.2091
E-mail: viviane.nobrega@sr4.fortaleza.ce.gov.br
CENTRAL DE ACOLHIMENTO
Informações e solicitações de serviços
Telefone: (85) 3433.2860
E-mails: rita.silva@sr4.fortaleza.ce.gov.br e assis.duarte@sr4.fortaleza.ce.gov.br
OUVIDORIA
Telefone: (85) 3433.2862
CONSERVAÇÃO E SERVIÇOS PÚBLICOS
Informações e solicitações de limpeza pública, requalificação de pontos de lixo, pavimentação, tapa buraco, galerias e bocas de lobo
Telefone: (85) 3433.2822
ORDENAMENTO E TERRITÓRIO
Informações e cadastramento de vendedores ambulantes, ordenamento de feiras e espaços públicos
Telefone: (85) 3433.2835
E-mail: fernanda.abreu@sr4.fortaleza.ce.gov.br
ASSISTÊNCIA SOCIAL
Informações e solicitações de cadastro único e encaminhamentos
Telefone: (85) 3433.2857
E-mail: ceben@sdhds.fortaleza.ce.gov.br
AGEFIS
Telefone: 156
Site: denuncia.agefis.fortaleza.ce.gov.br
COORDENAÇÃO DE INFRAESTRUTURA
Informações sobre obras de reforma e manutenção de praças e espaços públicos
Telefone: (85) 3433.2803
E-mail: glauber.fonteles@sr4.fortaleza.ce.gov.br

VIGILÂNCIA SANITÁRIA
Telefone: (85) 3433.2829
SAÚDE – CORES 4
Telefone: (85) 3433.2828
153 REGIONAL 4
AEROPORTO
O bairro Aeroporto é o maior em área na Regional IV. Ao mesmo tempo, é o que possui menor quantidade de moradores. Vizinho de outros oito bairros, faz divisa com Serrinha, Montese, Vila União, Parreão, Fátima, Alto da Balança, Dias Macedo e Aerolândia.
O bairro abriga alguns dos principais equipamentos para o dia a dia da Cidade e do Estado, como é o caso do Quartel do Comando Geral Governador César Cals de Oliveira Filho, Polícia Civil - Complexo de Delegacias Especializadas e do CISP - Centro Integrado de Segurança Pública, além do Aeroporto Internacional Pinto Martins.
É no bairro que também fica localizada a Base Aérea de Fortaleza do Comando da Força Aérea Brasileira, a Coordenadoria Integrada de Operações Aéreas (Ciopaer).
A maior parte da população residente no bairro Aeroporto mora nos arredores da Lagoa do Opaia, além do Conjunto Habitacional Nossa Sra. de Fátima, que é o reassentamento das comunidades Maravilha I, II e III.
DADOS GERAIS
Localização: Regional 4 / Território 18 - Faz divisa com os bairros Serrinha, Montese, Vila União, Parreão, Fátima, Alto da Balança, Dias Macedo e Aerolândia.
População estimada: 8.618
População Feminina: 4.458
População Masculina: 4.160
Densidade (hab/km²): 1.382,64
Área (km²): 6,23
Perímetro (km): 13.270,69
Avenidas Principais: Avenida Eduardo Girão, Avenida Expedicionários, Avenida Borges de Melo.
HISTÓRIA DO BAIRRO
A história do bairro se confunde bastante com a evolução da relação da Cidade com o modal aéreo. Na
década de 1930, houve a inauguração da pista do “Alto da Balança” (hoje Base Aérea), pois durante a II Guerra Mundial Fortaleza servia de apoio para aeronaves norte-americanas.
Naquela época, os engenheiros dos Estados Unidos escolheram a área mais ao sul do Centro, pois aquele espaço seria “mais distante da Cidade”. Em 1953, o Aeroporto de Fortaleza muda seu nome oficial de Salgado Filho para Pinto Martins, em homenagem ao piloto cearense Euclydes Pinto Martins, natural de Camocim, que participou do voo inaugural entre Nova York-EUA e Rio de Janeiro, entre setembro de 1922 e fevereiro de 1923.
Após reformulações em sua estrutura, em 1998, o Aeroporto de Fortaleza inaugurou novo terminal de passageiros no lado oposto do que era utilizado até então, com entrada pela Rodovia Senador Carlos Jereissati.
IDH: 0,177
ATIVIDADE SOCIAL

Zé Testinha - Um dos símbolos da região entre os bairros Vila União e Aeroporto, a sede da Quadrilha Junina Zé Testinha se diferencia dos demais grupos por manter um estilo próprio de homenagens ao sertão e ao cangaço. Hoje, o grupo junino é o mais relevante do Ceará, tendo conquistado vários prêmios, e é um centro de cultura e arte para a vizinhança e toda Cidade.
IGREJAS
Igreja de Santo Expedito (R. Bartolomeu de Gusmão, 237)
Igreja de Nossa Senhora da Assunção (Rua Professor Guilhon)
Igreja Nossa Senhora de Loreto (A, Av. Borges de Melo, 205).
SAÚDE
Postos de Saúde: UBS Dr. Roberto da Silva Bruno (Av. Borges de Melo, 910)
154 NOSSOS BAIRROS | NOSSA FORTALEZA
Aeroporto Internacional de Fortaleza - Pinto Martins teve quase 4 milhões de passageiros de embarque e desembarque em 2021

MEIO AMBIENTE
Parques: Parque da Lagoa do Opaia
Rios ou lagoas: Lagoa do Opaia
EDUCAÇÃO
Escolas: EMEIF Haroldo Jorge Braun Vieira (Rua Jorge Vieira, S/N)
EEMTI Jenny Gomes (Avenida Borges de Melo, 210)
Dom Manoel da Silva Gomes Unidade II (Avenida Aguanambi, 2479)
CULTURA
Centros culturais: Centro Cultural Zé Testinha (Rua Riachuelo, 115)
SEGURANÇA
Delegacias: Posto da Polícia Civil no Aeroporto Internacional Pinto Martins, Quartel do Comando Geral Governador Cesar Cals de Oliveira Filho, Polícia CivilComplexo de Delegacias Especializadas, Delegacia de
Proteção ao Idoso e Pessoa com Deficiência (DPIPD), CISP - Centro Integrado de Segurança Pública.
Bombeiros: 6ª Companhia – 6ª Cia/1º BBM (Av. Lauro Vieira Chaves, s/n)
AIS: 5
TRANSPORTE PÚBLICO
Ônibus: Aeroporto/Benfica/Rodoviária; Paramgaba/ Papicu/Aeroporto; Siqueira/Papicu/Aeroporto

ÁREA EDIFICADA (M2)
Inscrições Residenciais: 1.571
Inscrições Comerciais: 190
Inscrições de Prestação de Serviços: 20
Inscrições Industriais: 5
Assentamentos precários: Conjunto Habitacional Nossa Sra. de Fátima (reassentamento Maravilha I, II e III), Mutirão Moacir Machado, Favela Ouro Verde, Favela Boa Noite, Buraco da Jia, Vila Opaia, Comunidade rua do Guga, Favela Vila Castilho/ Nova Divinéis; Vila Castilho.
155 REGIONAL 4
FCO FONTENELE
BENFICA
Bairro universitário, bairro boêmio, bairro tradicional. As definições para o Benfica são diversas, mas é inegável: é uma das vizinhanças mais charmosas de Fortaleza.
O Benfica faz divisa com os bairros Damas, Jardim América, Fátima, José Bonifácio, Centro, Farias Brito e Rodolfo Teófilo.
Da vibração dos barzinhos à noite ao grande movimento das avenidas durante o dia, o bairro Benfica é sede da Universidade Federal do Ceará (UFC) e sua infraestrutura de educação, ciência e cultura. Também é lar do Estádio Presidente Vargas, o primeiro grande equipamento esportivo dedicado ao futebol no Estado. Naqueles arredores também se encontra a Praça da Gentilândia, lar da feira da Gentilândia, mas de também muita agitação em todo Carnaval.
Benfica é um bairro que preza pela diversidade. Abriga centro de acolhimento para pessoas LGBTQIA+ em situação de vulnerabilidade e também sedia algumas das igrejas mais antigas de Fortaleza, como é o caso da Igreja de Nossa Senhora dos Remédios.
Essa comunidade ainda tem afeto pela cultura e, ao redor da UFC, permite acesso à arte e história. Nessa missão, algumas infraestruturas cumprem papéis importantes, como é o caso do Museu de Arte da Universidade Federal do Ceará (Mauc), o Teatro Chico Anysio e o Teatro Universitário Paschoal de Carlos Magno.

DADOS GERAIS
Localização: Regional 4 / Território 15 - Faz divisa com os bairros Damas, Jardim América, Fátima, José Bonifácio, Centro, Farias Brito e Rodolfo Teófilo
População estimada: 12.954

População Feminina: 7.422
População Masculina: 5.532
Densidade (hab/km²): 8.878,68
Área (km²): 1,46
Perímetro (km): 5.688,47
Avenidas Principais: Avenida da Universidade, Avenida Treze de Maio, Avenida Carapinima
Feira: Feira na Praça da Gentilândia
Ecopontos: *Ecoponto bairro Fátima (Avenida Eduardo Girão, 989 - Benfica)
HISTÓRIA DO BAIRRO
O Benfica passou a ser mais densamente povoado a partir do fim do século XIX. Com a expansão da Cidade
156 NOSSOS BAIRROS | NOSSA FORTALEZA
MAUC reúne cerca de sete mil obras, sendo 1.544 peças da coleção de arte popular e 5.184 de artes plásticas

a partir do Centro, famílias da aristocracia de Fortaleza passaram a morar no bairro, que ainda na época da República Velha era chamado de Sítio Benfica. O primeiro morador notável da nova área foi o empresário José Gentil, que adquiriu uma chácara e ergueu um palacete no local, em 1918. Hoje, o local é a Reitoria da UFC.
IDH: 0,618
ESPORTE
Areninhas: Areninha Benfica
ATIVIDADE SOCIAL

Outra Casa Coletiva - é uma república de acolhimento
para pessoas LGBTQIAP+ em situação de vulnerabilidade em Fortaleza. Atua como centro de acolhimento e cultura, localizado na Rua Instituto do Ceará, 164 - Benfica.
IGREJAS
Igreja de Nossa Senhora dos Remédios, Igreja Santa Rosa de Viterbo
Igreja Adventista do Sétimo Dia
Igreja Presbiteriana Renovada de Fortaleza
SAÚDE
Postos de Saúde: Unidade Básica de Saúde Dr. Luís Costa (Rua Marechal Deodoro, 1501 - Benfica)
157 REGIONAL 4
FERNANDA BARROS
PRAÇAS
Praça Presidente Vargas (Gentilândia)
Praça João Gentil
Praça Paulo Ess
EDUCAÇÃO
Escolas: CEJA Professor Jose Neudson Braga (Avenida Carapinima, 2137)
EEFM Figueiredo Correia (Rua Marechal Deodoro, 733)
EEF Centro dos Retalhistas (Avenida da Universidade, 3304)
Associação de Assistência à Criança Excepcional (Rua Adolfo Herbster, 344)
CULTURA
Cinemas: Cinema do Shopping Benfica

Teatros: Teatro Chico Anysio, Teatro Universitário

Paschoal de Carlos Magno
Museus: Museu de Arte da Universidade Federal do Ceará (MAUC)
MAUC
No coração da avenida da Universidade está o Museu de Arte da Universidade Federal do Ceará (UFC) - o Mauc. O equipamento reúne cerca de sete mil obras, sendo 1.544 peças da coleção de arte popular e 5.184 de artes plásticas. No terreno de uma chácara pertencente ao Coronel Pierre havia uma edificação onde, até 1960, funcionava o Colégio Santa Cecília. Em 1961, no equipamento, passou a funcionar o Mauc. O museu universitário foi lançado aos cearenses em junho daquele ano. Já podemos contar 61 primaveras desde sua inauguração. Em 2022, a conta chega a mais de 600 exposições em sua longa trajetória. O Mauc tem atualmente três tipos de acervos: museológico, arquivístico e bibliográfico.
158 NOSSOS BAIRROS | NOSSA FORTALEZA
“Em seus conjuntos destacam-se a qualidade das coleções de Antonio Bandeira, Aldemir Martins, Chico da Silva, Raimundo Cela, Sérvulo Esmeraldo, Descartes Gadelha, artistas oriundos da Sociedade Cearense de Artes Plásticas (SCAP) e uma coleção de referência da cultura popular nordestina, com destaque para coleção de xilogravura. Conta, ainda, com a biblioteca setorial denominada Biblioteca Floriano Teixeira e com um arquivo institucional e um arquivo histórico”, explica a diretora do Mauc, Graciele Siqueira.
PATRIMÔNIO HISTÓRICO

Cemitérios: Funerária Eternidade (Rua Senador Pompeu, 2062 - Benfica)
SEGURANÇA
AIS: 5
TRANSPORTE PÚBLICO
Ônibus: Parangaba/Náutico; Parangaba/Mucuripe;Conjunto Novo Maracanaú; Siqueira/José Bastos/ Centro; Parangaba/José Bastos/Centro; Granja Lisboa/Goiabeiras; Curió/RioMar Kennedy
Metrô: Estação Benfica - Linha Sul do Metrô de Fortaleza (Avenida Carapinima, 2087)
ÁREA EDIFICADA (M2)
Quantidade de Inscrições Residenciais: 5.458
Quantidade de Inscrições Comerciais: 1.652
Quantidade de Inscrições de Prestação de Serviços: 96
Quantidade de Inscrições Industriais: 4
Assentamentos precários: Canal Eduardo Girão

159 REGIONAL 4
Reitoria da Universidade Federal do Ceará é um palacete que foi construído em 1918
MESQUITA
THAIS
BOM FUTURO
O Bom Futuro é o segundo menor bairro de Fortaleza em área. Faz divisa com bairros Damas, Jardim América e Parreão, além do Montese, seu vizinho mais populoso.

Muitas vezes tendo seus limites confundidos com o Montese, o Bom Futuro tem como suas principais vias de acesso a avenida Professor Gomes de Matos e a rua Alberto Magno.
Majoritariamente residencial, o bairro tem diversos serviços e comércios, com destaque para as muitas opções de bancos.
Um levantamento de 2012, do Instituto de Pesquisa e Estratégia Econômica do Ceará (Ipece), apontou o Bom Futuro como o melhor bairro para se morar em Fortaleza.
O bairro também é sede do Grupo Arte de Viver, companhia de teatro profissional com 21 anos de trabalhos ininterruptos no Estado na formação de artistas.
DADOS GERAIS
Localização: Regional 4 / Território 15 - Faz divisa com os bairros Montese, Damas, Jardim América e Parreão.
ATIVIDADE SOCIAL

População Residente: 6.405
População Feminina: 3.658
População Masculina: 2.747
Densidade (hab/km²): 16.679,69
Área (km²): 0,38
Perímetro (km): 2.558,38
Avenidas Principais: Avenida Professor Gomes de Matos, Rua Alberto Magno.
Feiras: Feira do Jardim América (Rua Aquiraz, entre a rua Afrodísio Gondim e a rua Professor Costa Mendes)
IDH: 0,505
Grupo Arte de Viver - Companhia de teatro profissional com 21 anos de trabalhos ininterruptos no Estado, é uma organização não governamental (ONG) sem fins lucrativos criada em maio de 2000, em Fortaleza. Atua na concepção, promoção, produção e realização de grandes espetáculos, experimentos cênicos e esquetes nas mais diversas estéticas, dentro e fora do Estado, em empresas e organizações, e, da mesma forma, em eventos, mostras e festivais pelo País. Ao longo de toda a sua história tornou-se um centro de formação de novos artistas, recebendo alunos a partir dos 7 anos de idade em cursos e oficinas nos mais diversos direcionamentos, inclusive voltados à profissionalização em teatro no Ceará.
160 NOSSOS BAIRROS | NOSSA FORTALEZA
SAÚDE
Policlínicas: LabPasteus Montese (Avenida Prof. Gomes de Matos, 648), Clínica RadSaúde (Avenida Prof. Gomes de Matos, 778).
EDUCAÇÃO
Escolas: EEFM Estado do Paraná
CULTURA
Centros culturais: Centro Cultural Arte de Viver (Rua
Samuel Uchôa, 395)
SEGURANÇA
AIS: 5
TRANSPORTE PÚBLICO
Ônibus: 044 Parangaba / Papicu / Montese, 045 Conjunto Ceará / Papicu / Montese, 060 Parquelândia / Parangaba, 073 Siqueira / Praia de Iracema, 080 Francisco Sá / Parangaba, 728 José Walter / Centro
ÁREA EDIFICADA (M2)
Inscrições Residenciais: 1.596
Inscrições Comerciais: 724

Inscrições de Prestação de Serviços: 21
Inscrições Industriais: 3
Assentamentos precários: Favela do Trenzinho

161 REGIONAL 4
O Bom Futuro já foi eleito o melhor lugar para se morar em Fortaleza
AURÉLIO ALVES
DAMAS
O bairro Damas é um dos mais importantes da Regional 4 e é vizinho dos bairros Rodolfo Teófilo, Bom Futuro, Montese, Bela Vista, Benfica e Jardim América.
Os dois últimos vizinhos listados remontam à história de fundação do bairro, que ocorreu nos anos 1930. Naquela época aconteceu o maior povoamento daquela área da Cidade, a partir de famílias abastadas que buscavam vizinhanças mais tranquilas do que as do Centro e da Parangaba.
Foi no bairro onde se instalaram grandes chácaras, locais de descanso e grandes áreas verdes das “damas” abastadas da Capital alencarina.
Rico em história, o bairro Damas possui uma parcela importante do patrimônio histórico de Fortaleza: a Casa do Português, o prédio do Imparh, além da Capela do Sagrado Coração de Jesus - o Asilo da Parangaba.
Hoje, o bairro é bem estruturado do ponto de vista da oferta de comércio e serviços, sendo a maior parte localizada na extensão da avenida João Pessoa. No bairro, ainda está a unidade regional do Centro de Referência da Assistência Social (CRAS), está instalado um Ecoponto, além de uma Areninha no Polo de Lazer Gustavo Braga.
DADOS GERAIS
Localização: Regional 4 / Território 16 - Faz divisa com os bairros Benfica, Rodolfo Teófilo, Bom Futuro, Montese, Bela Vista e Jardim América.
População estimada: 10.719
População Feminina: 6.022
População Masculina: 4.697
Densidade (hab/km²): 11.949,83
Área (km²): 0,90
Perímetro (km): 4.532,51
Avenidas Principais: Avenida João Pessoa
Ecopontos: Ecoponto Damas (Rua Júlio César, 1532Entre a Rua Macedo e a Rua Afrodísio Godim)
HISTÓRIA SOBRE O BAIRRO
Casa do Português - Localizada na avenida João Pessoa, a Casa do Português é tombada como Patrimônio Histórico de Fortaleza desde 2012. Inaugurada em 1953, a casa pertencia ao fazendeiro e comerciante português José Maria Cardoso. O prédio possui três andares, 11 quartos e três banheiros apenas no primeiro dos pisos. A notável construção de época ainda possui uma rampa para automóveis que circunda sua estrutura em concreto armado. Uma extravagância para os idos anos 1950.
IDH: 0,511
ESPORTE
Areninhas: Areninha Gustavo Braga (Avenida João Pessoa s/n - Polo de Lazer Gustavo Braga)
ATIVIDADE SOCIAL

Imparh - Dentre os projetos desenvolvidos pelo Instituto Municipal de Desenvolvimento de Recursos Humanos (Imparh), está o Programa Gente de Valor (PVG). O PGV é lei municipal, de 2001, e busca atender os aposentados. Todas as ações do PGV estão concentradas no trabalho biopsicossocial, oportunizando assistência básica de saúde, ensinamentos continuados de informática e línguas. Os cadastrados também participam de feirinhas de artesanato, rodas de terapia comunitária e reuniões mensais.
IGREJAS
Igreja Nossa Senhora Auxiliadora, Igreja do Sagrado Coração de Jesus, Capela de Santa Luzia - Paróquia De São Raimundo, Igreja Evangélica Luterana do Brasil.
SAÚDE
Postos de Saúde: UAPS Dr. Gothardo Peixoto Figueiredo Lima
Policlínicas: ProntoClínica de Fortaleza - Hospital de Olhos e Medicina Avançada (Avenida João Pessoa, 4408)
162 NOSSOS BAIRROS | NOSSA FORTALEZA
PRAÇA
Praça: Praça Frei Galvão
MEIO AMBIENTE
Parques: Polo de Lazer Gustavo Braga

Rios ou lagoas: Lagoa do Polo de Lazer Gustavo Braga
EDUCAÇÃO
Escolas: EEF Educandário Santa Clara (Avenida João Pessoa, 5126), Padre Felice Pistone (Rua Júlio César, 1810).
PATRIMÔNIO HISTÓRICO
Bens tombados: Casa do Português (Avenida João Pessoa, 5094); Imparh (Avenida João Pessoa, 5609); Capela do Sagrado Coração de Jesus - Asilo de Parangaba (Avenida João Pessoa, 6408)
SEGURANÇA
Juizados: Centro de Referência da Assistência Social - CRAS (Avenida João Pessoa, 4474)
AIS: 5
TRANSPORTE PÚBLICO
Ônibus: Parangaba Náutico; Parangaba/Papicu; Cuca Barra/Parangaba; Parangaba/Mucuripe; Pajuçara; Conjunto Novo Maracanaú; Siqueira/João Pessoa/ Centro.
Metrô: Linha Sul Estação Porangabuçu (R. Professor Costa Mendes, 1455)
ÁREA EDIFICADA (M2)
Inscrições Residenciais: 3.478
Inscrições Comerciais: 705

Inscrições de Prestação de Serviços: 41
Inscrições Industriais: 5
Assentamentos precários: Favela Campos Novos; Favela do Canal Eduardo Girão
163 REGIONAL 4
Campo de futebol do polo de lazer Gustavo Braga
THAIS MESQUITA
FÁTIMA
Notabilizado pela presença do Santuário de Nossa Senhora de Fátima, o bairro cresceu em torno da igreja, que se tornou o grande símbolo daquele pedaço de Fortaleza.
Até 1955, ano que marcou a inauguração do Santuário, o bairro de Fátima era chamado de Redenção, mas, por conta da popularização da igreja, a Prefeitura alterou oficialmente o nome do bairro em 1956.
A localização é um ponto relevante, pois Fátima possui algumas das principais avenidas de Fortaleza.
A partir do bairro é possível acessar o Centro da Cidade, e ele tem ligações importantes com outros pontos, através das avenidas Aguanambi, Borges de Melo e Treze de Maio. Essa boa localização tornou o bairro um dos mais valorizados para se morar e investir em negócios. A gama de serviços ofertados é vasta, como é o caso dos serviços de saúde e clínicas médicas.
DADOS GERAIS
Localização: Regional 4 / Território 15 - Faz divisa com os bairros Parreão, Jardim América, Benfica, José Bonifácio, Joaquim Távora, Aeroporto, São João do Tauape
População estimada: 23.309
População Feminina: 13.218
População Masculina: 10.091
Densidade (hab/km²): 8.141,46
Área (km²): 2,86
Perímetro (km): 7.278,22
Avenidas Principais: Avenida Aguanambi, Avenida
Treze de Maio, Avenida Eduardo Girão, Avenida Borges de Melo, Avenida Luciano Carneiro
Feira: Feira do Bairro de Fátima (Rua Carlos Ribeiro, entre a rua Dom Sebastião Leme e a avenida Aguanambi)
Ecopontos: *Ecoponto bairro Fátima, Ecoponto Aguanambi
IDH: 0,695
ATIVIDADE SOCIAL

Casas da Convivência Familiar - CCF Maravilha é um projeto que tem a finalidade de abrigar crianças no horário de contraturno escolar.
IGREJAS
Santuário de Nossa Senhora de Fátima, Comunidade Sagrado Mariano, Capela do Menino Jesus, Comunidade Cristã Logus - Bairro de Fátima
Santuário de Nossa Senhora de Fátima - A ideia de levantar um grande santuário está ligada à visita da imagem peregrina de Nossa Senhora de Fátima, que em 1952 esteve em Fortaleza. A imagem de Nossa Senhora de Fátima, que fica na Praça Pio IX, foi inaugurada em 2008.
SAÚDE
Postos de Saúde: UBS Dr. Roberto da Silva Bruno (Avenida Borges de Melo, 990)
Hospitais: Hospital Antônio Prudente (Avenida Aguanambi, 1827)
Policlínicas: LIV Pronto Atendimento Fortaleza (Rua Barão de Aratanha, 1450), Hospital Oftalmoclínica (Avenida Treze de Maio, 1806), Clínica Salute (Rua General Silva Júnior, 235), Clementino Fraga Patologia Clínica (Avenida Treze de Maio, 1119), Clínica Otomédica (Avenida Treze de Maio, 1189), Emílio Ribas (Avenida Treze de Maio, 1654), Laboratório CAC (Avenida Treze de Maio, 1331), LabPasteurs Unidade Fátima (Rua Bonfim Sobrinho, 660), Laboratório 13 de MaioUnimed Fortaleza (Avenida Treze de Maio, 1383), Vida & Imagem Lobo Filho (Rua João Lôbo Filho, 117)
PRAÇAS
Praças: Praça Manoel Dias Branco, Praça Nossa Senhora de Fátima, Praça Pio IX, Praça Argentina Castelo Branco, Praça do 23ª Batalhão de Caçadores, Praça São Cristóvão, Praça do Radioamador Teobaldo Cesne
164 NOSSOS BAIRROS | NOSSA FORTALEZA
Igreja de Fátima é símbolo da religiosidade católica na Cidade e reúne no seu entorno os festejos de homenagem à santa

MEIO AMBIENTE
Parques: Parque Parreão 1
Rios ou lagoas: Lagoa do Porangabussu
EDUCAÇÃO
Escolas: EEM Governador Adauto Bezerra (Rua Monsenhor Liberato, 1850), EEM São João Piamarta (Avenida Aguanambi, 2479) EEEP Juarez Távota (Rua Joaquim Bastos, 747), Instituto de Educação do Ceará (Graciliano Ramos, 52), Escola Madre Teresa de Calcutá (Rua Guilherme Moreira, 75)
CULTURA
Bibliotecas: Biblioteca Engenheiro Waldyr Diogo de Siqueira - IFCE (Avenida Treze de Maio, 2081)
Teatros: Casa da Esquina - Grupo Bagaceira de Teatro (R. João Lôbo Filho, 62 - Fátima)
PATRIMÔNIO HISTÓRICO
Bens tombados: Antiga Sede do Sport Clube Maguary
SEGURANÇA
Delegacias: Departamento de Homicídios e Proteção
à Pessoa - DHPP (Rua Juvenal de Carvalho, 1125), Divisão de Combate ao Tráfico de Drogas - Denarc (Avenida Deputado Oswaldo Studart, 585)
Juizados: 10ª Unidade do Juizado Especial Cível de Fortaleza (Rua Mário Mamede, 1301)
Bombeiros: -
AIS: 5
TRANSPORTE PÚBLICO
Ônibus: Circular 1/Centro; Circular 2/Centro; Aguanambi/Rodoviária I; Aguanambi/Rodoviária II; Parangaba/Náutico; Siqueira/Papicu/13 de Maio; Corujão/ Circular I; Corujão/Cj Ceará/Papicu/Montese; Parangaba/Papicu/Montese; Cj Ceará/Papicu/Montese; Bezerra de Menezes/Washington Soares; Zona Hoteleira/Arena Castelão;
ÁREA EDIFICADA (M2)
Inscrições Residenciais: 9.041
Inscrições Comerciais: 2.962
Inscrições de Prestação de Serviços: 127
Inscrições Industriais: 1
Assentamentos precários: Comunidade rua do Guga (favela), Conjunto Nossa Sra. de Fátima (reassentamento Maravilha I, II e III).

165 REGIONAL 4
JULIO CAESAR
ITAOCA
O bairro Itaoca fica localizado na Regional IV e é vizinho dos bairros Parangaba, Montese e Serrinha.
Por possuir uma área bem menor que seus vizinhos, muitas vezes é confundido, mas é a área mais central daquela região.
A história do bairro mudou a partir das obras do Metrofor, com a implantação do VLT e da Linha Sul do Metrô de Fortaleza. É na Itaoca que as direções se dividem: VLT segue rumo ao Papicu, enquanto a Linha Sul com destino ao Centro.

Antes de ser chamado Itaoca, essa vizinhança já foi conhecida como Santa Teresa, até meados dos anos 1940. Depois de algum tempo veio a mudança de nome do bairro, que em tupi, significa “casa de pedra”.
DADOS GERAIS
Localização: Regional 4 / Território 17 - Faz divisa com os bairros Serrinha, Montese e Parangaba.
População estimada: 12.477
População Feminina: 6.875
População Masculina: 5.602

Densidade (hab/km²): 16.838,06
Área (km²): 0,74
Perímetro (km): 4.258,59
Avenidas Principais: Rua 15 de Novembro, Rua Almi-
166 NOSSOS BAIRROS | NOSSA FORTALEZA
Estação Montese, de Veículo Leve sobre Trilhos (VLT), na Rua Livino de Carvalho
FERNANDA BARROS
rante Rubim e Rua Barão de Canindé
Feira: Feira da Itaoca (Rua Colômbia, entre a rua Vila Lobos e a rua Livino de Carvalho)
Ecopontos: Ecoponto Itaoca (Rua Barão de Canindé, 410)
HISTÓRIA DO BAIRRO
A história dessa vizinhança remonta aos anos 1940, quando aquele território ainda era chamado de Santa Teresa. Depois de algum tempo veio a mudança de nome do bairro, que em tupi significa “casa de pedra”. A trajetória do bairro é muito ligada ao trilho por onde antes passavam trens de passageiros, mas que atualmente abriga o VLT.
IDH: 0,373
ESPORTE
Areninhas: Areninha da Itaoca (R. Peru, 804)
Areninha da Itaoca - Inaugurado em 2020, o espaço que inicialmente seria voltado ao esporte, especialmente o futebol, tomou maiores proporções para a comunidade. No local, já foram realizadas feiras de moda, de empreendedorismo e até festas juninas do bairro.
SAÚDE
Postos de Saúde: PS Dr. Ocelo Pinheiro (Rua Elcias Lopes, 517).
MEIO AMBIENTE
Parques: Área de Lazer da Rua Parque Ipiranga
EDUCAÇÃO
Escolas: EMTI Carolino Sucupira (Rua Mundica Paula, 670).
SEGURANÇA
AIS: 5
TRANSPORTE PÚBLICO
Ônibus: 307 Itaóca / Jardim América / Centro, 411 Montese / Lagoa / Centro, 025 Opaia / Lagoa, 067 Lagoa / Albert Sabin.
Metrô: VLT Estação Montese (R. Livino de Carvalho)

ÁREA EDIFICADA (M2)
Inscrições Residenciais: 3.316
Inscrições Comerciais: 560

Inscrições de Prestação de Serviços: 34
Inscrições Industriais: 9
Assentamentos precários: Comunidade Rua Diana, Travessa Livino de Carvalho.
167 REGIONAL 4
JARDIM AMÉRICA
O bairro Jardim América está situado entre o Montese, Benfica, Damas, Bom Futuro e Rodolfo Teófilo.
Dentre as principais referências que o identificam, certamente está a Caixa d’Água e a pracinha do Jardim América. Mas há um destaque histórico, de antes de o bairro ser denominado como é hoje: seus canais.
Em determinado momento de sua história, o Jardim América foi chamado de bairro Laguna, por aquela região estar sempre alagada devido aos escoadouros das lagoas. Aquela comunidade era bastante impactada pelas lagoas da Parangaba, do Bessa e do Tauape.
Hoje, o Jardim América é o bairro que sedia a reitoria do Instituto Federal de Educação do Ceará (IFCE).
DADOS GERAIS
Localização: Regional 4 / Território 16 - Faz divisa com os bairros Fátima, Montese, Vila União, Aeroporto, Bom Futuro e Jardim América
População estimada: 12.264
População Feminina: 6.809
População Masculina: 5.455
Densidade (hab/km²): 15.886,01
Área (km²): 0,77
Perímetro (km): 3.545,05
Avenidas Principais: Avenida Eduardo Girão, Avenida Expedicionários, Avenida Borges de Melo.
HISTÓRIA DO BAIRRO
O nome atual do Jardim América foi originado a partir
do processo de expansão das áreas residenciais, no início da década de 1930. Em 1932, foi inaugurada a Praça Presidente Roosevelt. A partir da praça, a comunidade ficou conhecida como Jardim das Américas. Depois veio a oficialização: Jardim América.
IDH: 0,444
ATIVIDADE SOCIAL

Memorial do IFCE - batizado oficialmente como Dr. Raimundo César Gadelha de Alencar Araripe, o Memorial do IFCE é um espaço de cultura, arte e história no bairro Jardim América. No acervo, objetos e artigos que destacam a história da longeva instituição. Além de narrar e preservar a memória do IFCE, o espaço visa integrar a comunidade por meio da extensão e desenvolver exposições temporárias e permanentes.
IGREJAS
Capela Nossa Senhora do Perpétuo Socorro
Igreja Presbiteriana do Brasil
Comunidade Católica Paráclito
SAÚDE
Postos de Saúde: Posto de Saúde Filgueiras Lima
Policlínicas: Clínica San Matheus
PRAÇAS
Praças: Ermílson do Carmo Victor, Praça Delmiro Golveia - pracinha do Jardim América, Praça Padre Elvis Marcelino
168 NOSSOS BAIRROS | NOSSA FORTALEZA
MEIO AMBIENTE
Rios ou lagoas: Canal do Porangabuçu
EDUCAÇÃO
Escolas: EMTI Filgueiras Lima, Filgueiras Lima Unidade II, EEEP Paulo VI, Padre Felice Pistone Unidade II, Mozart Pinto, Dom Manoel da Silva Gomes
CULTURA
Centros culturais: Memorial do IFCE (Rua Jorge Dummar, 1703)
SEGURANÇA
Juizados: CAPS Geral IV (Avenida Borges de Melo, 201)
AIS: 5
TRANSPORTE PÚBLICO
Ônibus: Conjunto Ceará/Papicu/Montese; Cuca Barra/ Parangaba; Siqueira/Praia De Iracema; Lagoa/Aldeota; Pajuçara; Antônio Bezerra/Parangaba/Montese; Bom Jardim/Centro; Conjunto Novo Maracanaú
ÁREA EDIFICADA (M2)

Inscrições Residenciais: 3.177
Inscrições Comerciais: 777

Inscrições de Prestação de Serviços: 49
Inscrições Industriais: 2
Assentamentos precários: Travessa do Mato ou Matadouro, Comunidade Brasília, Favela Salgadinho.
169 REGIONAL 4
Reitoria do IFCE: Instituto é um dos principais para a formação de jovens, com cursos técnicos e superiores gratuitos
FERNANDA BARROS
JOSÉ BONIFÁCIO
José Bonifácio é um dos bairros mais próximos do Centro de Fortaleza. Além de fazer divisa com o Centro, também é próximo do Joaquim Távora, Benfica e Fátima.
O bairro José Bonifácio possui um dos maiores Índice de Desenvolvimento Humano (IDH) dentre os bairros de Fortaleza, com índices parecidos com seus vizinhos Joaquim Távora e Fátima.
Uma das vizinhanças mais antigas e tradicionais da Capital, o José Bonifácio tem uma história de “idas e vindas”. O bairro já chegou a ser anexado ao Centro, anos depois voltou a ser bairro com novos limites geográficos, o que o aproximou ainda mais de seu vizinho bairro de Fátima.

Hoje, é um dos bairros que é passagem obrigatória para milhares de cearenses. Possui algumas das avenidas mais movimentadas de Fortaleza, como é o caso das avenidas Domingos Olímpio e Aguanambi. Também é sede do Grupo de Comunicação O POVO e do Hospital Uniclinic.
DADOS GERAIS
Localização: Regional 4 / Território 15 - Faz divisa com os bairros Centro, Joaquim Távora, Fátima e Benfica

170 NOSSOS BAIRROS | NOSSA FORTALEZA
Vista aérea do cruzamento da Av. Aguanambi com Domingos Olímpio
AURÉLIO ALVES
População Residente: 8.848
População Feminina: 5.006
População Masculina: 3.842
Densidade (hab/km²): 9.952,76
Área (km²): 0,89
Perímetro (km): 4.045,46
Avenidas principais: Avenida Aguanambi, Avenida Domingos Olímpio
HISTÓRIA DO BAIRRO
A história do bairro José Bonifácio remonta ao processo de expansão da Cidade. Aquela região, na década de 1930, foi dividida num grande quadrilátero de bairros que foi incorporado ao Centro. Naquela época, o José Bonifácio compreendia a região no entorno do Quartel da Polícia Militar e a antiga Praça dos Coelhos - hoje chamada de Praça José Bonifácio. Somente anos depois, após várias alterações no desenho dos bairros, o José Bonifácio voltou a ser “independente”, ocupando espaço entre o Quartel da Polícia Militar e criando divisa com o bairro Fátima.
IDH: 0,644
ATIVIDADE SOCIAL

Centro de Convivência e Pousada Social - Localizado na Rua Sólon Pinheiro, 898, o Centro de Convivência e Pousada Social é um equipamento público, mantido pela Prefeitura, que conta com espaço de acolhimento e convivência para atender às necessidades de pessoas adultas que estejam em situação de rua. O local ainda é opção de pernoite com segurança para pessoas de ambos os sexos, acompanhadas ou não de filhos. O acesso acontece por meio de demanda espontânea, encaminhamentos realizados pelo Serviço Especializado em Abordagem Social da Prefeitura, além de outros programas e projetos da rede socioassistencial.
IGREJA
Igreja de Nossa Senhora do Sagrado Coração
SAÚDE
Hospitais: Hospital Uniclinic (Avenida Aguanambi, 332)
Policlínicas: Centro Urólogo Olavo Rodrigues (Rua Sousa Girão, 110), Vincular: Estudos, Pesquisa e Psicoterapia (Rua Lauro Maia, 618)
PRAÇAS
Praça Demócrito Rocha Dummar
Praça 1º de Maio
Praça do Ciclista
SEGURANÇA
Delegacias: Delegacia de Capturas (Rua Conselheiro Tristão, 188)
AIS: 5
TRANSPORTE PÚBLICO
Ônibus: Parangaba / Papicu; Antônio Bezerra / Unifor; Conjunto Ceará / Aldeota / Papicu; Antônio Bezerra / Papicu / Antônio Sales; Antônio Bezerra / Parangaba / Montese; Genibaú / Centro; Conjunto Esperança / Centro; Conjunto Ceará / Centro; Planalto Ayrton Senna / Expedicionários; José Walter / Expedicionários / Centro; Messejana / Centro / Expresso Via BR-116; Paupina / Pici
ÁREA EDIFICADA (M2)
Inscrições Residenciais: 3.465
Inscrições Comerciais: 1.250
Inscrições de Prestação de Serviços: 82
Inscrições Industriais: 1
Assentamentos precários: Favela Coração de Jesus
171 REGIONAL 4
SUGESTÃO DE FOTO: Paróquia Nossa
MONTESE
O Montese é o bairro mais central da Regional 4. Faz divisa com 11 bairros diferentes: Bom Futuro, Damas, Bela Vista, Couto Fernandes, Demócrito Rocha, Parangaba, Itaoca, Aeroporto, Serrinha, Parreão e Vila União.
Atualmente, o Montese é uma das principais regiões comerciais da Cidade, movimentando bastante a região. A oferta de opções variadas no comércio, serviços, bancos e educação são destaques.
O crescimento populacional e econômico do bairro estendeu seus “tentáculos” de influência sobre outros bairros vizinhos aglomerados ao redor. Por isso, há muitos casos de lojas que instalam “unidades Montese” na área de bairros próximos.
DADOS GERAIS
Localização: Regional 4 / Território 16 - Faz divisa com os bairros Bom Futuro, Damas, Bela Vista, Couto Fernandes, Demócrito Rocha, Parangaba, Itaoca, Aeroporto, Serrinha, Parreão e Vila União.
População estimada: 25.970

População Feminina: 14.446
População Masculina: 11.524
Densidade (hab/km²): 13.582,64
Área (km²): 1,91
Perímetro (km): 6.037,19
Avenidas Principais: Avenida Professor Gomes de Matos, Rua Alberto Magno e Rua Barão de Sobral.
HISTÓRIA DO BAIRRO
A história do atual nome do bairro tem sua origem na
Itália, numa cidade de mesmo nome, que foi palco de batalhas da Segunda Guerra Mundial, em 1945. Em 2022, o Montese completou 76 anos de fundação oficial como bairro.
Antes disso, o território era conhecido como Pirocaia, que significa “casa dos pelos queimadas”. O nome perdeu força após o cearense Raimundo Nonato Ximenes, militar em treinamento pela Força Expedicionária Brasileira (FEB), receber a notícia de que a FEB tinha se saído vitoriosa na Batalha do Montese e, por isso, não precisaria mais viajar para guerrear na Itália.
Ximenes recebeu um terreno na Pirocaia, mas, por insistência, passou a chamar a localidade de Montese. E a partir de 1946 a região realmente mudou de nome.
IDH: 0,473
ATIVIDADE SOCIAL
Casa Maria Madalena - Promovido pelo Shalom, por meio do Projeto Volta Israel, a Casa Maria Madalena oferta serviço de combate ao abuso de drogas a partir da evangelização, prevenção, tratamento e promove a reinserção social. Está localizada na rua Raul Cabral - Montese.

172 NOSSOS BAIRROS | NOSSA FORTALEZA
Paróquia Nossa Senhora de Nazaré
de Nazaré IGREJAS
Paróquia Nossa Senhora de Nazaré, Santuário Nossa Senhora Aparecida, Igreja Nossa Senhora Mãe do Divino Salvador - Capela da Irmã Betinha, Assembleia de Deus Canaã Montese, Igreja Adventista do Sétimo Dia - Montese.

SAÚDE
Postos de Saúde: Dr. Gothardo Peixoto Figueiredo Lima
Hospitais: Hospital da Criança (Rua Elvira Pinho, 383), Hapclínica Montese (Av Professor Gomes de Matos, 1737)
Policlínicas: Núcleo de Especialidades MédicasNEMO (Rua Dom Carloto Távora, 570), Clínica SIM Montese (Rua Almirante Rubim, 1400)
PRAÇA
Praça da Paz
MEIO AMBIENTE
Rios ou lagoas: Lagoa da Pirocaia
EDUCAÇÃO
Escolas: EEFM Marechal Humberto de Alencar Castelo Branco (Rua Álvaro Fernandes, 913), EEFM João Matos (Rua Almirante Rubim, 1014), Colégio Estadual Presidente Humberto de Alencar Castelo Branco (Rua Irmã Bazet, 210), EMEIF Vicente Fialho (Rua Irmã Bazet, 193).
CULTURA
Centros culturais: Omì Ateliê de Dança (Rua Edmundo Linhares, 353)
PATRIMÔNIO HISTÓRICO
Bens tombados: Círculo Operário do Montese (Rua Aquiles Boris, 17)
SEGURANÇA
AIS: 5
TRANSPORTE PÚBLICO
Ônibus: Itaóca/Jardim América/Centro; Opaia Lagoa; Parangaba/Papicu/Montese; Conjunto Ceará/Papicu/Montese; Parquelândia/Parangaba; Siqueira/Praia De Iracema; Antônio Bezerra/Parangaba/Montese; Bom Jardim/Montese/Aldeota
ÁREA EDIFICADA (M2)
Inscrições Residenciais: 6.829
Inscrições Comerciais: 2.421

Inscrições de Prestação de Serviços: 141
Inscrições Industriais: 13
Assentamentos precários: Favela Boa Noite; Rua Felipe Camarão; Favela Vila Castilho/Nova Divinéis/Lauro Chaves; Buraco da Jia.
173 REGIONAL 4 Nossa
Senhora
THAIS MESQUITA
PARANGABA
O bairro Parangaba é um verdadeiro patrimônio que conta boa parte da história da Capital. Reconhecida desde os mapas da capitania do Siará, em 1629, a aldeia de índios já era um povoado que foi fundado pela Companhia de Jesus para catequizar os indígenas.
Em 1759 virou vila, sendo batizada de Arronches. Em 1835 foi incorporada a Fortaleza, com o nome Porangaba. Em 1885, voltou a se tornar município independente. Só em 1921 virou distrito da Capital, depois bairro.
No século XVIII, o antigo Arronches era ponto intermediário no transporte de gado. Ligava o Barro Vermelho - hoje Antônio Bezerra - à Messejana pela Estrada da Paranjana.
Anos depois veio a instalação da Estrada de Ferro de Baturité. Hoje a estrutura da estação é tombada e foi rebaixada para a construção da Estação Parangaba da Linha Sul do Metrofor.
A infraestrutura do bairro é das mais completas em comércio e serviços. Além do metrô e VLT, o Terminal de Integração de ônibus é um dos mais movimentados da Capital.
DADOS GERAIS
Localização: Regional 4 / Território 17 - Faz divisa com os bairros Serrinha, Montese, Itaperi, Itaoca, Demócrito Rocha, Jóquei Clube, Vila Peri, Maraponga e Bonsucesso.
População estimada: 30.947
População Feminina: 16.676
População Masculina: 14.271
Densidade (hab/km²): 7.646,90
Área (km²): 4,05
Perímetro (km): 11.400,88
Avenidas Principais: Avenida Godofredo Maciel, Avenida Dr. Silas Munguba, Avenida João Pessoa.
Feira: Feira da Parangaba (Avenida Paisagística Lagoa, entre a avenida Carneiro de Mendonça e a rua Vila Lobos)
Ecopontos: Ecoponto Parangaba (Alameda Oxóssi, 80)
Cemitérios: Cemitério São José
IDH: 0,419
ESPORTES
Areninha Parangaba e Areninha Vila Betânia
ATIVIDADE SOCIAL

Abrigo Tia Julia - orfanato para crianças que fica localizado na Rua Guilherme Perdigão, 305.
IGREJAS
Igreja do Senhor Bom Jesus dos Aflitos, Igreja Nossa Senhora de Fátima, Igreja de São Judas Tadeu, Igreja de Santo Expedito, Igreja Adventista do Sétimo DiaParangaba, Igreja Universal do Reino de Deus.
SAÚDE
Postos de Saúde: PS Prof. José Valdevino de Carvalho (Rua Guará, S/N)
Hospitais: Frotinha da Parangaba (Av. Gen. Osório de Paiva, 1127), Hospital Infantil de Fortaleza Dra. Lúcia de Fátima (Rua Guilherme Perdigão, 299)
PRAÇAS
Praças: Praça da Lagoa da Parangaba, Praça Mano Albano, Praça da Igreja da Parangaba, Praça do Delta, Praça da Montenegro, Praça da Vila Betânia, Praça 1º de Janeiro, Pracinha Isabel Correia, Praça Santa Lígia.
MEIO AMBIENTE
Parques: Parque da Lagoa da Parangaba, Parque Urbano da Lagoa da Maraponga.
Rios ou lagoas: Lagoa da Parangaba
EDUCAÇÃO
Escolas: EEEP Joaquim Moreira de Sousa (Rua Caio Prado, 2), CEJA Professor Moreira Campos (Rua Julio
174 NOSSOS BAIRROS | NOSSA FORTALEZA
Braga, 101), EEFM General Eudoro Corrêa (Rua Julio Braga, 101), EEFM Maria Thomásia (Rua Polônia, 369), CEI Prof. José Valdevino de Carvalho (Rua Guará, S/N), Escola Prof. José Valdevino de Carvalho (Av. Godofredo Maciel, 522) EMEF Cláudio Martins (Av. João Pessoa, 6601), CEI Algodão Doce (Rua José Queiroz Porto, 25).
CULTURA
Cinemas: UCI Cinema Shopping Parangaba
Centros culturais: Ginásio Poliesportivo da Parangaba (Av. Gen. Osório de Paiva)
PATRIMÔNIO HISTÓRICO
Bens tombados: Espelho d’Água da Lagoa de Parangaba, Estação Ferroviária da Parangaba, Paróquia do Senhor do Bom Jesus dos Aflitos - Igreja da Parangaba, Bar Avião, Casa da Câmara da Villa de Arronches e Intendência Municipal da Villa de Porangaba, Imóvel residencial dos Monteiros, Seminário Salvatoriano
SEGURANÇA
Delegacias: 5º Distrito Policial (Av. Júlio Braga c/ Osório de Paiva, 161).
Juizados: 17ª Unidade do Juizado Especial Cível de Fortaleza (Av. Gen. Osório de Paiva, 1220).

AIS: 5
TRANSPORTE PÚBLICO
Ônibus: Antônio Bezerra / Lagoa / Unifor; Parangaba / Papicu / Montese; Cuca Barra / Parangaba; Conjunto Senador Carlos Jereissati - Rota 01; Messejana / Parangaba; Acaracuzinho; Siqueira / João Pessoa / Centro.
Metrô: VLT Estação Parangaba Metrofor Linha Sul Estação Parangaba; Metrofor Linha Sul Estação Vila Pery.
ÁREA EDIFICADA (M2)
Inscrições Residenciais: 7.968
Inscrições Comerciais: 2.288

Inscrições de Prestação de Serviços: 86
Inscrições Industriais: 20
Assentamentos precários: Favela Vila Nova ou Zelinda Cruz, Travessa Santiago, Comunidade Rua Diana, Rua Peru, Travessa Turiaçu, Travessa Livino de Carvalho, Comunidade da Lagoa da Parangaba, Mutirão Sonho Meu
175 REGIONAL 4
Lagoa da Parangaba é a maior lagoa em volume de água de Fortaleza
FERNANDA BARROS
PARREÃO
Um bairro com ótimos vizinhos. Essa é uma boa definição para o bairro Parreão, que faz divisa com Montese, Aeroporto, Bom Futuro, Fátima, além de Vila União e Jardim América.
Os bairros vizinhos ainda permitem acesso rápido a comércio, serviços e transporte, seja saindo por via rodoviária (pela Rodoviária Engenheiro João Tomé) ou aérea (via Aeroporto Internacional Pinto Martins).
Suas vias principais são algumas das mais movimentadas de Fortaleza, como é o caso das avenidas Expedicionários e Borges de Melo. E elas abrigam alguns trunfos que fazem seus moradores amarem o bairro: bancos, supermercados - sejam grandes redes nacionais ou os atacarejos -, além de agência dos Correios. Uma das marcas registradas do bairro é a tranquilidade. Os moradores ainda têm acesso ao grande Parque Urbano do Parreão, fundado oficialmente como área de lazer em 1993. Este parque possui relação direta com a origem do bairro.
Ainda sobre a história do bairro, um dos traços mais importantes é a escolha do nome. Segundo historiadores, Parreão é uma homenagem à família homônima que possuía uma vacaria naquela localidade. Oficialmente, o Parreão virou bairro na década de 1960.
DADOS GERAIS
Localização: Regional 4 / Território 18 - Faz divisa com os bairros Fátima, Montese, Vila União, Aeroporto, Bom Futuro e Jardim América
População estimada: 11.072

População Feminina: 6.095
População Masculina: 4.977
Parque Parreão é cortado pelo Riacho de mesmo nome

Densidade (hab/km²): 10.886,92
Área (km²): 1,02
Perímetro (km): 5.438,32
Avenidas Principais: Avenida Expedicionários, Avenida Luciano Carneiro e Avenida Borges de Melo
Ecopontos: Ecoponto Parreão (Rua André Chaves, esquina com Av. Luciano Carneiro)
HISTÓRIA SOBRE O BAIRRO
A origem do Parque Parreão remonta a meados da década de 1940. Naquela época, no local destinado atualmente ao parque, funcionava uma vacaria que fornecia e distribuía leite para diversas localidades de Fortaleza nos lombos de burros. Além dessa grande
176 NOSSOS BAIRROS | NOSSA FORTALEZA
vacaria, havia no espaço do bairro Parreão outros espaços similares. O riacho que hoje corta o parque servia para matar a sede da criação de gado existente. Com a urbanização do bairro nas décadas seguintes, as propriedades foram vendidas e o cenário mudou. O Parque Parreão foi criado oficialmente como área de lazer em 1993.
IDH: 0,572
ATIVIDADE SOCIAL

Casa Nazaré - A história da Casa de Nazaré tem sua origem no trabalho desenvolvido pela Companhia das Filhas da Caridade de São Vicente de Paulo. Fundada em 1941, a Casa de Nazaré é uma entidade sem fins lucrativos, de caráter assistencial, que atua no aco-
lhimento institucionalizado de idosas em situação de vulnerabilidade social.

IGREJAS
Paróquia Nossa Senhora de Nazaré
Igreja Nossa Senhora da Medalha Milagrosa
PRAÇAS
Praça Amâncio Cavalcante, Praça Rua Santa Luzia
MEIO AMBIENTE
Parques: Parque Parreão
SEGURANÇA
AIS: 5
TRANSPORTE PÚBLICO
Ônibus: Lagoa / Papicu / Via Expressa; Siqueira / Mucuripe / Barão De Studart; Planalto Ayrton Senna / Expedicionários; José Walter / Expedicionários / Centro
Metrô: VLT Estação Borges de Melo (Rua Eng. Edmundo Almeida Filho)
ÁREA EDIFICADA (M2)
Inscrições Residenciais: 2.856
Inscrições Comerciais: 1.074
Inscrições de Prestação de Serviços: 39
Inscrições Industriais: 0
Assentamentos precários: Favela do Parreão
177 REGIONAL 4
FERNANDA BARROS
VILA PERI
O bairro Vila Peri fica localizado na Regional IV e faz divisa com os bairros Parangaba, Vila Manoel Sátiro, Bonsucesso e Parque São José.
É nesta vizinhança que se encontra a Igreja de São
José e o Terminal de Integração do Siqueira, que apesar de ter nome de outro bairro da região fica localizado dentro dos limites do Vila Peri.
A Avenida General Osório de Paiva é a principal via do bairro. É ao longo dessa via que se concentram os principais comércios e serviços, como, por exemplo, grandes redes de supermercados e clínicas médicas. De grande movimentação durante todo o dia, a avenida atravessa vários bairros de Fortaleza e é ligação desde a divisa com Maracanaú até a região mais central da Capital.
O bairro também conta com o trabalho social do Instituto Doando que se Recebe, que, desde 2008, atua com voluntariado em prol de famílias em vulnerabilidade social da região a partir de doações de alimentos, brinquedos e roupas.
DADOS GERAIS
Localização: Regional 4 / Território 17 - Faz divisa com os bairros Parangaba, Vila Manoel Sátiro, Bonsucesso e Parque São José.
População estimada: 20.645
População Feminina: 11.128
População Masculina: 9.517
Densidade (hab/km²): 13.865,01
Área (km²): 1,49
Perímetro (km): 5.615,78
Avenidas Principais: Avenida Dom Henrique, Avenida General Osório de Paiva, Rua Cônego de Castro.
Ecopontos: Ecoponto Vila Peri (Rua Antônio Costa Mendes, 468 - Esquina com a Travessa Augusto Ribeiro)
HISTÓRIA SOBRE O BAIRRO
Terminal de Integração do Siqueira - Apesar de ter nome de outro bairro da região, o Terminal de Integração do Siqueira fica localizado dentro dos limites do Vila Peri. Foi inaugurado em novembro de 1995 e é um dos sete terminais de ônibus de Fortaleza, sendo um dos mais movimentados.
IDH: 0,342
ATIVIDADE SOCIAL

Instituto Doando que se Recebe - Localizado na Rua Einstein, 1322, o Instituto Doando que se Recebe é um projeto social do bairro Vila Peri. Desde 2008 a iniciativa tem como principal finalidade ajudar pessoas em vulnerabilidade social que vivem na região a partir do trabalho voluntário, principalmente com doações de alimentos, brinquedos e roupas.
IGREJA
Igreja de São José.
SAÚDE
Postos de Saúde: PS Doutor Gutemberg Braun
Policlínicas: Clínica MedPop Fortaleza (Av. Gen. Osório de Paiva, 2951), Clínica Viva Dente (Av. Gen. Osório de Paiva, 2450)
178 NOSSOS BAIRROS | NOSSA FORTALEZA
PRAÇA
Praça entre as ruas Cônego de Castro e Fernando Farias de Melo
EDUCAÇÃO
Escolas: EEFM Hermenegildo Firmeza, EM Raimundo Soares de Souza, Creche Paraíso da Criança, EMEIF Catulo da Paixão Cearense.
CULTURA
Centros culturais: Centro de Formação Divino Salvador - Cefords (Av. Gen. Osório de Paiva, 2821 - Vila Peri)
SEGURANÇA
AIS: 5
TRANSPORTE PÚBLICO
Ônibus: Siqueira / Papicu / 13 De Maio; Siqueira / João Pessoa / Centro; Siqueira / Osório De Paiva / Parangaba; Siqueira / Papicu / Aeroporto; Siqueira / Praia De Iracema; Siqueira / Mucuripe / Barão De Studart
ÁREA EDIFICADA (M2)
Inscrições Residenciais: 4.008
Inscrições Comerciais: 879

Inscrições de Prestação de Serviços: 42
Inscrições Industriais: 5
Assentamentos precários: Favela Livreiro Gualter, Cardoso de Barros, Rua Cônego de Castro

179 REGIONAL 4
Apesar do nome, o Terminal do Siqueira fica localizado no bairro Vila Peri
BARROS
FERNANDA
VILA UNIÃO
A história dessa comunidade se inicia em 1940, quando a Prefeitura considerou os loteamentos pertencentes a Manoel Sátiro um bairro. Até então, aquela localidade era conhecida como Barro Preto.
Antes de lotear as terras, em 1938, a propriedade pertencia à Maria de Conceição Jacinto, que era oriunda da cidade de União, hoje chamada Jaguaruana. Por isso, sua propriedade foi chamada de Vila União.
O bairro também tem sua peculiaridade: Abriga o Conjunto Habitacional Planalto Universo. Lá, as ruas têm nomes de planetas e constelações, além da famosa Rua Sol.
A localização privilegiada, como um dos bairros mais ao centro do território de Fortaleza, faz com que a sede de alguns órgãos e empresas estejam no bairro, como é o caso da Companhia de Água e Esgoto do Ceará (Cagece).
O Gabinete do Prefeito já chegou a funcionar no bairro Vila União por iniciativa do então prefeito, Juraci Magalhães, no início da década de 1990. O bairro também foi até 1998 o acesso ao terminal de passageiros do Aeroporto Pinto Martins.
Atualmente, uma das principais âncoras do bairro é o Hospital Albert Sabin, inaugurado em 1952. Por mês, a unidade de saúde especializada no atendimento infantil chega a realizar mais de 20 mil acolhimentos, seja ambulatoriais ou emergenciais.
DADOS GERAIS
Localização: Regional 4 / Território 18 - Faz divisa com os bairros Parreão, Montese e Aeroporto
População estimada: 15.378
População Feminina: 8.288
População Masculina: 7.090
Densidade (hab/km²): 10.984,29
Área (km²): 1,40
Perímetro (km): 5.225,75
Avenidas Principais: Avenida Luciano Carneiro
Feira: Feira do Vila União (Rua Alberto Montezuma, entre a rua Helvécio Monte e a rua Domingos Jaguaribe)
IDH: 0,467
ESPORTES
Areninha Vila União, Mini Areninha Lagoa do Opaia, Mini Areninha Planalto Universo (Rua do Sol S/N)
ATIVIDADE SOCIAL

Lar da Criança Domingos Sávio - instituição filantrópica fundada pela irmã salesiana e missionária italiana Irmã Petronilla Isonni, em março de 1988.
IGREJAS
Capela Santa Luzia, Igreja Jesus Maria José, Assembleia de Deus, Igreja Universal do Reino de Deus, Comunidade Católica Vinde a Mim
SAÚDE
Postos de Saúde: Posto de Saúde Maria José Turbay Barreira
Hospitais: Hospital Infantil Albert Sabin - Principal hospital infantil do Estado, o HIAS foi inaugurado em 1952. Batizado inicialmente de Hospital Infantil de Fortaleza, era uma iniciativa pioneira, pois não existia até então um hospital que atendesse exclusivamente crianças. O nome do equipamento foi alterado após ampliação em 1977.
Policlínicas: CRAS Vila União (Rua do Avião S/N), Clínica Higia, Clínica Saúde e Vida (Rua Armando Monteiro, 170)
PRAÇAS
Praça do Vila União, Praça Brigadeiro Eduardo Gomes e Praça Maria Estela Braga
180 NOSSOS BAIRROS | NOSSA FORTALEZA
Hospital Infantil Albert Sabin (Hias): o pioneiro na Cidade com atendimento exclusivo para crianças
MEIO AMBIENTE
Parques: Parque Urbano da Lagoa do Opaia
Rios ou lagoas: Lagoa do Opaia
EDUCAÇÃO
Escolas: EMEIF General Manoel Cordeiro Neto (Rua Jorge Acúrcio, 900), EM São Domingos Sávio (Rua Helvécio Monte, 165), EM Teodorico Barroso (Rua Helvécio Monte, 751), EEFMTI Professor Coronel Jose Aurelio Camara (Rua Jorge Acurcio, 655), EM Papa João XXIII (Rua Treze de Abril, 595 A), Haroldo Jorge Braun Vieira (Rua Marte S/N)
CULTURA
Bibliotecas: Biblioteca da EMEIF General Manoel Cordeiro Neto (Rua Jorge Acúrcio, 900), Biblioteca da EEFMTI Professor Coronel Jose Aurelio Camara (Rua Jorge Acurcio, 655)
Centros culturais: Centro Juvenil Dom Bosco

SEGURANÇA
Delegacias: 25º Distrito Policial (Avenida Lauro Vieira Chaves, 1080)
AIS: 5
TRANSPORTE PÚBLICO
Ônibus: Lagoa / Papicu / Via Expressa; Planalto Ayrton Senna / Expedicionários; Vila União / Centro
Metrô: VLT Estação Vila União
ÁREA EDIFICADA (M2)
Inscrições Residenciais: 3.410
Inscrições Comerciais: 1.090

Inscrições de Prestação de Serviços: 33
Inscrições Industriais: 19
Assentamentos precários: Conjunto Habitacional Planalto Universo, Favela Ouro Verde, Favela Ambrósio Machado, Favela Livreiro Gualter, Favela Lagoa do Opaia ou Vila Opaia, Travessa Mariana, Travessa Eduardo Angelim, Favela do Carvão, Mutirão Moacir Machado.
181 REGIONAL 4
THAIS MESQUITA
REGIONAL 5














Uma regional de poucos bairros, mas de grande extensão territorial. Reúne duas Granjas, a Portugal e a Lisboa, um efervescente Bom Jardim e até uma pista de pouso no Siqueira, além do Bonsucesso, banhado pelo






Maranguapinho














 Aeródromo Feijó, no Siqueira
Aeródromo Feijó, no Siqueira


























GUIA REGIONAL 5
BAIRROS
Bom Jardim
Bonsucesso
Granja Lisboa
Granja Portugal
Siqueira
SECRETARIA REGIONAL 5
Endereço: Av. Gen. Osório de Paiva, 2466 – Bonsucesso, Fortaleza - CE, 60542-122

Telefone: (85) 3433-2900
Secretário: Moacir Soares
Graduado em Pedagogia pela Universidade Estadual do Ceará (Uece) e em Psicologia pela Universidade de Fortaleza (Unifor). Sanitarista, é mestre em Saúde Pública e especialista em Sistemas Locais de Saúde. Além disso, atualmente é doutorando em saúde coletiva (Unifor). Moacir exerceu ainda o cargo de secretário de Saúde nos municípios de Caucaia, Crateús e Tauá e, em Fortaleza, foi secretário de Turismo.
Presidiu o Conselho dos Secretários de Saúde do Ceará (Cosems-CE) e foi membro titular do Conselho Estadual da Saúde (Cesau) e do Conselho Nacional de Saúde (Conasems) representando o Nordeste. Foi também membro do Conselho Municipal de Cultura
de Fortaleza e diretor-presidente da Agência de Consultoria em Sistemas Locais de Saúde (Consilos).

CONTATOS IMPORTANTES
GABINETE
Telefone: (85) 3433.2919
RECEPÇÃO
Telefone: (85) 3433.2900
CONSERVAÇÃO E SERVIÇOS PÚBLICOS
Informação e solicitações de limpeza pública, requali-
184 NOSSOS BAIRROS | NOSSA FORTALEZA
ficação de pontos de lixo, pavimentação, tapa buraco, galerias e bocas de lobo

Telefone: (85) 9 8189.3943
ACOLHIMENTO
Telefones: (85) 3433.2926 / 3433.2926
E-mail: acolhimento@sr5.fortaleza.ce.gov.br
OUVIDORIA
Telefone: 156 / (85) 9 9155.7127
Email: ouvidoria@sr5.fortaleza.ce.gov.br
AGEFIS
Telefone: (85) 9 8439.2009
E-mail: ouvidoria.agefis@agefis.fortaleza.ce.gov.br
PROCON
Telefones: 151/ (86) 3105-1144/ 9 8970.9101
CADASTRO ÚNICO
(85) 9 8970.3939
SINE
WhatsApp (trabalhador): (85) 9 8513.4385
WhatsApp (empregador): (85) 9 8970.3532
E-mail: vagasine@sde.fortaleza.ce.gov.
AURÉLIO ALVES
185 REGIONAL 5
Aeródromo Feijó, idealizado por Gerardo Feijó funciona no bairro Siqueira
BOM JARDIM
Localizado na região Sudoeste de Fortaleza, o bairro Bom Jardim faz divisa com os vizinhos Granja Portugal, Granja Lisboa, Siqueira e Canindezinho, integrando a terminologia de Grande Bom Jardim quando se trata desta região.
Sua ocupação, segundo relatos dos moradores mais antigos, começou no início da década de 1960 quando chegaram os primeiros moradores ao local. No território, havia anteriormente uma grande fazenda loteada pelo empresário João Gentil, que também havia ocupado outros espaços em Fortaleza.
Segundo relatos históricos, a imobiliária de João Gentil começou a vender os lotes com nomes comerciais como Granja Bom Jardim, Parque Santa Cecília e Parque Santa Rosa. Lá pelos anos 1980, o Bom Jardim já era referência de mobilização social, cultural, econômica e política da Cidade. A primeira via aberta foi a Rua Oscar Araripe que se mantém como o principal corredor do bairro.
O que se justifica pela chegada dos missionários combonianos, em 1987, que mostraram um novo modo de viver da Igreja. Eles uniram tanto os religiosos como os leigos nos trabalhos da Igreja Católica na região, movidos pela Teologia da Libertação e pelo modelo de Comunidades Eclesiais de Base (CEBs).
No Bom Jardim, a área pastoral agregou um conjunto de CEBs que perdeu força nos anos 2000, retornando ao modelo paroquiano tradicional. Mas a missão de ser um local de formação humana que preza tanto pelo individual quanto pelo coletivo continua firme com o Movimento Saúde Mental, instalado pelo padre Rino na comunidade em 1996 e em funcionamento até os dias atuais.

O Bom Jardim já foi escolhido pelo Ministério da Justiça para se tornar um Território da Paz por meio do Programa Nacional de Segurança Pública com Cidadania (Pronasci). Atualmente, muitas instituições exercem trabalho com a comunidade do Grande Bom Jardim para a valorização do ser humano, da vida e da sociedade.
DADOS GERAIS
Localização geográfica: Regional 5 / Território 39Faz divisa com os bairros Bonsucesso, Siqueira, Granja Portugal, Granja Lisboa e Canindezinho
População estimada: 37.758
População Feminina: 19.578
População Masculina: 18.180
Densidade (hab/km²): 15.461,92
Área total (km²): 2,44
Perímetro (km): 7.585,05
Avenidas principais: Avenida Oscar Araripe; Avenida General Osório de Paiva;
186 NOSSOS BAIRROS | NOSSA FORTALEZA
FEIRAS LIVRES: Feira Da Santa Cecília (Av. Virgílio Nogueira); Feira Da Urucutuba I (Rua NE 05); Feira Da Urucutuba II (Rua NE 09)
IDH (IBGE): 0,195
ESPORTE
Mini Areninha Bom Jardim

ATIVIDADE SOCIAL
Casa Ame (Rua Dr. Fernando Augusto, 980); Centro de Defesa da Vida Hebert de Souza (CDVHS) (Rua Dr. Fernando Augusto, 987); Escola de Gastronomia (EGA) (Rua Dr. Fernando Augusto, 980); Palhoça (Rua Dr. Fernando Augusto, 985) ; Comunidade do Marrocos (Rua Reginaldo França Rodrigues, 122) ; Espaço Ma-
O Movimento Saúde Mental, instalado pelo padre Rino na comunidade do Bom Jardim, atua desde 1996
187 REGIONAL 5
FERNANDA BARROS
rio Bonvini (Rua Dr. Fernando Augusto, 987); Centro de Referência do Empreendedor (av. Oscar Araripe, 1030); Cras Bom Jardim (R. Cel. João Correia, 2023); Projeto Bom Jesus (R. Cel. João Correia, 1913)

Movimento Saúde Mental - Com o objetivo de auxiliar a comunidade local no desenvolvimento individual e social e, ainda, ampliar o aumento da consciência de si e da realidade econômica, social e cultural que as envolve, o Movimento Saúde Mental tem sua sede em uma área também chamada de Santo Amaro ou Grande Bom Jardim. Dentre as muitas atividades desenvolvidas pelo Movimento, destacam-se as ações com grupos de terapia comunitária; de autoajuda para o resgate da autoes-
tima; atendimentos de biomagnetismo, massoterapia, reiki e acupuntura.
Além de atendimentos psicológicos individuais; acompanhamento de crianças e adolescentes com as ações do projeto Sim à Vida; resgate da cultura indígena com ações junto a etnias indígenas cearenses, especialmente os Pitaguary, e oficinas de arte-terapia na Casa AME (Arte, Música e Espetáculo).
Esses serviços oferecidos no espaço ajudam no reconhecimento das potencialidades e da dignidade das pessoas, induzindo-as a enfrentarem as problemáticas decorrentes da situação de exclusão. O Movimento Saúde Mental fica na rua Dr. Fernando Augusto, 609.
Vista aérea do bairro Bom Jardim
AURÉLIO ALVES 188 NOSSOS BAIRROS | NOSSA FORTALEZA
PADRE RINO
O idealizador do projeto é o padre Rino Bonvini, que em 1996 reuniu um grupo de lideranças locais e iniciou o Movimento Saúde Mental Comunitária do Bom Jardim (MSMC), hoje chamado apenas de Movimento Saúde Mental.
Ottorino Bonvini, ou padre Rino como é conhecido por todos, é médico, psiquiatra e padre missionário comboniano. Nasceu em Senago, em Milão, na Itália, e seguiu pelo mundo exercendo serviço voltado a pessoas em vulnerabilidade social ou com distúrbios mentais até chegar ao Bom Jardim, em 1996.
Por lá, além das terapias para comunidade, ajudou a formar profissionais para o atendimento em diferentes áreas. Um exemplo é o primeiro grupo de terapeutas comunitários, uma parceria com a Universidade Federal do Ceará (UFC).
Recentemente, Padre Rino liderou a criação do Giardino Buffet, um negócio de impacto social com trabalho para mulheres do Grande Bom Jardim. Serviços de buffet organizado por formandas da Escola de Gastronomia Autossustentável do Movimento de Saúde Mental, com orientação do Programa Gastronomia Social da UFC, que atende eventos em toda a Capital.
IGREJA
Paróquia Santa Cecília (R. Cel. João Correia, 2021), Paróquia São João Batista (R. A)
SAÚDE
Postos de Saúde: Abner Cavalcante Brasil (Rua Joana Batista, 471); Argeu Herbster (Rua Geraldo Barbosa, 1095)
UPAs: UPA BOM JARDIM (Rua João Gentil com Av. Sgt. João Pinheiro)
PRAÇAS
Praça Da Liberdade (Praça Santo Amaro) - Rua Maria Júlia X Rua Santa Luzia; Praça Conjunto Habitacional Raquel de Queiroz - Rua Sublime X Rua Bravura
MEIO AMBIENTE
Rios ou lagoas: Bacia do Rio Maranguapinho
Sub Bacia: C8
Micro Bacias: C8.2.3; C8.3.1; C8.3.2
EDUCAÇÃO
Escolas: Catarina Lima Da Silva (Rua Pedro Martins, 313); Crescer E Aprender (Rua Edson Martins, 64); Herbert De Sousa (Rua Urucutuba, 1599); Professor José Ferreira De Alencar (Rua São Francisco, 557); Santa Isabel (Av. Oscar Araripe, 741); Santos Dumont (Rua Geraldo Barbosa, 240); Sebastião De Abreu (Rua Geraldo Barbosa, 1065); Maria Luiza Barbosa Chaves (Rua Oscar França, 267)
SEGURANÇA
AIS: 2
TRANSPORTE PÚBLICO
Linha de ônibus: Parque Santa Cecília I; Cj Ceará/Bom Jardim/SP1; Cj Ceará/Bom Jardim/SP2; Corujão/Bom Jardim; Parque Santa Cecília I; Cj Ceará/Bom Jardim/ SP1; Cj Ceará/Bom Jardim/SP2;
ÁREA EDIFICADA (M2)
Inscrições Residenciais: 4.793
Inscrições Comerciais: 891
Inscrições de Prestação de Serviços: 34
Inscrições Industriais: 1
Assentamentos Precários:
Favela: Parque Olivândia; Beco da Prefeitura; Rei do Gado; Oscar Bressano (Wlademar Paes) / Rei do Gado; Forró do batinhop / Rei do Gado; Favela Santa Teresinha; Comunidade Parque Santo Amaro; Favela do Pantanal/ Nova Friburgo; Comunidade Lagoa do Mela Mela; Comunidade Canal Leste; Travessa Itú.
Mutirão: 28 - A21; 486 - Mutirão Estrada da Urucutuba; 487 - Veneza / Daniel Castro; 488 - A4/A4/A24/ Nova Vida; 489 - Irmã Dulce I; 498 - A3.
189 REGIONAL 5
BONSUCESSO
No bairro de Bonsucesso está localizada a administração da Secretaria Regional 5. Antes de se tornar o Bonsucesso, o território foi loteamento adquirido e vendido pela família de João Gentil, em meados da década de 1950.

Antes disso, em 1939, o espaço era conhecido como "Pici das Pedreiras" por causa de um morador que extraia pedras para fazer brita. O Bonsucesso foi moradia do compositor e cantor Messias Holanda, autor da música "Pra Tirar Coco".
DADOS GERAIS
Localização geográfica: Regional 5 / Território 39 - Faz divisa com os bairros Bom Sucesso, Granja Portugal, Parque São Jorge, Vila Peri, Parangaba, Jóquei Clube, João XXIII e Genibaú
População Feminina:21.862
População Masculina:19.336
Densidade (hab/km²):16.264,51
Área total km²:2,53
Perímetro (km): 8.014,54
Avenidas principais: Avenida Augusto dos Anjos; Avenida General Osório de Paiva; Avenida Lineu Machado
Feiras livres: Feira do Bonsucesso
Ecopontos: Bonsucesso (Rua Emílio de Menezes, esquina com rua Luiza Moreira)
IDH (IBGE): 0,262
ESPORTE
Mini areninha Bonsucesso
População estimada:41.198
AURÉLIO ALVES 190 NOSSOS BAIRROS | NOSSA FORTALEZA
Visão geral do Bonsucesso a partir da Mini areninha do bairro
ATIVIDADE SOCIAL
ONG Rosa de Saron
Instituto Educa Mais Esporte - O Instituto foi criado pela líder comunitária Raquel de Souza com ajuda de outras duas mulheres periféricas, Cleiviane e Edilene. O Instituto busca gerar para o bairro protagonismo por meio do esporte e da cultura e estimular a qualificação e geração de renda.
IGREJAS
Igreja de São José Operário; Capela de Santa Terezinha do Menino Jesus
SAÚDE
Postos de Saúde: Luís Recamonde Capelo; Mariusa Silva de Sousa
Policlínicas - Dr. José Eloy da Costa Filho
PRAÇAS
Praça Bonsucesso - Fechada temporariamente; Praça Anselmo Nogueira; Praça Do Posto Mariusa De Sousa ; Praça Samambaia
MEIO AMBIENTE
Parques: Parque urbanizado do Rio Maranguapinho
Bacia do Rio Maranguapinho
Sub Bacia: C3;C4;C5
Micro Bacias: C3.1; C3.4; C4.1; C5.1; C5.2
EDUCAÇÃO
Escolas: 15 De Outubro; Antônio Diogo De Siqueira; João Paulo I; José Alcides Pinto; Professor Luiz Re-
camonde Capelo; Francisca Fernandes Magalhães; Maria Do Socorro Alves Carneiro; 15 De Outubro; Antônio Diogo De Siqueira; Francisca Fernandes Magalhães; Mundo Feliz
CULTURA
Centros culturais: Cátia Pedrosa - Espaço de Dança (Rua Emílio de Menezes, 509)
SEGURANÇA
Batalhão de Polícia do Meio Ambiente (R. Verbena, 986-1162)
AIS: 6
TRANSPORTE PÚBLICO
Cj Ceará/Bonsucesso/Centro; Jóquei / Bonsucesso
ÁREA EDIFICADA (M2)
Inscrições Residenciais: 6.439
Inscrições Comerciais: 1.239
Inscrições de Prestação de Serviços: 32
Inscrições Industriais: 6
Assentamentos precários
Favela
Rua Fco. Domingos; Comunidade Carlos Chagas; Menino Deus, Bragança; Margem do Rio I; Belém; Comunidade dos canos; Rua Pomar Carioca; Margem do Rio; Rua das Acácias; Parque São Luiz Pedreira / Rioacho das Pedras
Mutirão
Planaltina; Vital Brasil; Conjunto Santa Edwirges
191 REGIONAL 5
GRANJA LISBOA
Os poucos relatos disponíveis sobre o bairro apontam que a Granja Lisboa surgiu em meados de 1980, a partir do loteamento de áreas do Grande Bom Jardim.
Além de equipamento destinado a lazer e esporte, a Areninha Granja Lisboa possui a Associação Sociocultural Bom Jardim e o Instituto Katiana Pena, uma Organização da Sociedade Civil (OSC) para transformar vidas por meio da arte.
O bairro também abriga o Centro Cultural Bom Jardim (CCBJ), que tem a proposta de centro cultural de base comunitária vinculado à Secretaria da Cultura do Estado do Ceará (Secult). Com gestão da Organização Social Instituto Dragão do Mar (IDM), promove a democratização das artes, das culturas e dos direitos humanos.
DADOS GERAIS
Localização geográfica: Regional 5 / Território 39Faz divisa com os bairros Siqueira, Bom Jardim, Granja Portugal, Conjunto Ceará II.
Areninha Granja Lisboa - O equipamento instalado na Granja Lisboa foi a 22ª Areninha de Fortaleza. Com valor estimado em R$ 1,7 milhão, o equipamento recebeu grama sintética, redes de proteção, alambrado, iluminação, arquibancadas, depósito, vestiários, acessibilidade e paisagismo.
ATIVIDADE SOCIAL
Instituto Katiana Pena; Fundação Érico Mota; ASCBJAssociação Sociocultural do Bom Jardim
IGREJAS
Paróquia Santa Paula Frassinetti; Igreja de São José
SAÚDE
Postos de Saúde: Dom Lustosa (Rua A, s/n); Fco. Edmilson Pinheiro (Av. H, 2191); Guarany Mont’alverne (Rua Geraldo Barbosa, 3230)
População estimada: 52.042
População Feminina: 26.682
População Masculina: 25.360
Densidade (hab/km²): 9.992,70
Área total km²: 5,21
Perímetro (km): 10.848,24
Avenidas principais: Avenida H, Avenida Oscar Araripe, Rua Urucutuba; Rua Oscar França;
Feiras livres: Feira Livre do Palmares
Ecopontos: Ecoponto Granja Lisboaina
IDH (IBGE): 0,170
ESPORTE
Estádio Municipal do Bom Jardim;
PRAÇAS
Praça da UPA; Praça do Cearazinho; Praça Edson Martins ; Praça José Martins; Praça Santa Cecília
MEIO AMBIENTE
Bacia do Rio Maranguapinho
Sub Bacia: C8
Micro Bacias: C8.2.2; C8.2.3
EDUCAÇÃO
Escolas: Doutor Sérvulo Mendes Barroso; Francisco Edmilson Pinheiro ; João Mendes De Andrade ; Manoel Malveira Maia; Maria Dolores Petrola De Melo Jorge; Professora Antônia Maria De Lima; Professora Lireda Facó; Rachel Viana Martins; Raimundo Moreira Sena; Ulysses Guimarães; Dom Antônio De Almeida Lustosa;
192
BAIRROS | NOSSA FORTALEZA
NOSSOS
João Mendes De Andrade; Manoel Malveira Maia; Maria Dolores Petrola De Melo Jorge; Professor Agostinho Gósson; Professora Antônia Maria De Lima; Professora Lireda Facó ; Rachel Viana Martins; Raimundo Moreira Sena; Centro De Desenvolvimento Integrado Da Vida; Tia Helena; Tia Zuleide.
CULTURA
Bibliotecas: Gelateca - Geladeira Literária Granja Lisboa; Biblioteca do Quintal Cultural Bom Jardim, Biblioteca Livro Livre Antonia Mendes; Biblioteca Cristina Poeta
Centros culturais: Centro Cultural Bom Jardim; Associação Zumbi Capoeira AZC / Espaço Cultural AZC
Mestre Lula
SEGURANÇA

Delegacias: Delegacia de Polícia Civil | 32° Distrito Policial
AIS: 2
TRANSPORTE PÚBLICO
Conjunto Ceará / Granja Lisboa; Planalto Granja Lisboa
Ciclovia
Ciclofaixa
ÁREA EDIFICADA (M2)
Inscrições Residenciais: 7.549
Inscrições Comerciais: 910
Inscrições de Prestação de Serviços: 44
Inscrições Industriais: Não tem
Assentamentos precários
Conjunto habitacional
Travessa; Conjunto Oscar Araripe.
Favela: Nova Residência; Sem Nome; Sem Nome; Comunidade Margem do Canal; Sem Nome; João XXIII; Comunidade Canal Leste.
Mutirão: Veneza/Daniel Castro; Nova Vida; rmã Dulce II; Rua Luminosa / Nereide; Alto da Paz.
JULIO CAESAR 193 REGIONAL 5
Areninha Granja Lisboa oferece à população lazer e convivência
GRANJA PORTUGAL
Um dos bairros centenários da Capital cearense, a história da Granja Portugal começou com a compra pela família Gentil dos lotes da região que antes pertenciam ao distrito da Parangaba, do comerciante José Augusto Torres Portugal.
Até o ano de 1970, o local abrigava às margens do rio Maranguapinho três olarias e a pedreira de Pedro Menino.
Dentre as atrações do bairro, estão a Praça da Juventude e a Areninha que leva o nome do território e reúne os moradores locais e a comunidade do Grande Bom Jardim.
DADOS GERAIS
Localização geográfica: Regional 5 / Território 39Faz divisa com os bairros Bom Jardim, Bonsucesso, Granja Lisboa, Conjunto Ceará II
População estimada: 39.651
População Feminina: 20 479
População Masculina: 19.172
Densidade (hab/km²): 15.709,59
Área total km²: 2,52
Perímetro (km): 7.029,10
Avenidas principais: Avenida H; Avenida Emílio de Menezes; Avenida Vital Brasil
Feiras livres: Feira da Granja Portugal (Rua Londrina)
Ecopontos: Container (Rua Duas Nações, 1029)
IDH (IBGE): 0,190
ESPORTE
Areninha Granja Portugal
ATIVIDADE SOCIAL
Associação de Moradores do Parque Ribeirinho; Associação Queira Bem; Organização Solidária De Granja Portugal; Espaço Geração Cidadã de Arte e Cultura; Associação Queira Bem
IGREJAS
Paróquia Santo Antônio
SAÚDE
Postos de Saúde: Fernando Diógenes; Jurandir Picanço; CRAS Granja Portugal
PRAÇA
Praças: Praça da Juventude; Praça da 54;
MEIO AMBIENTE
Parques: Bosque da Avenida H
Rios ou lagoas
Bacia do Rio Maranguapinho
Sub Bacia: C8
Micro Bacias: C8.2.3; C8.3.1; C8.3.2
EDUCAÇÃO
Escolas: Conceição Mourão; Crescer E Aprender
Unid II; Creusa Do Carmo Rocha; Irmã Rocha; Irmã Rocha Unidade II ; Educador Paulo Freire; José Carlos Matos; Professora Lireda Facó Unidade II; Reitor Antônio Martins Filho; Reitor Antônio Martins Filho
Unidade II; Dona Eulália Uchoa Alves; Encantos de Celeste; Pequeno Mundo De Flora; Raio De Luz
194
BAIRROS | NOSSA
NOSSOS
FORTALEZA
CULTURA
Bibliotecas: Biblioteca Comunitária Pastoral do Menor: Raimundo Ribamar do Nascimento
Grupo de Teatro Nóis De Teatro
Centros culturais: Centro cultural dó bom jardim; Espaço Cultural Vereador Glauber Lacerda (Fechado temporariamente); Instituto Celeste Moura; Sociedade cultural Coração Sertanejo
SEGURANÇA
Delegacias: Base Proteger Granja Portugal
AIS: 2
TRANSPORTE PÚBLICO
Corujão/Cj Ceará; Granja Portugal/Cj Ceará/Lagoa
ÁREA EDIFICADA (M2)
Inscrições Residenciais: 4.839
Inscrições Comerciais: 788
Inscrições de Prestação de Serviços: 24
Inscrições Industriais: 6
Assentamentos precários
Favela
Menino Deus Bragança; Boa Esperança; Cachoeira Dourada; 322 - Belém; Lumes / Vila Maria; Parque Olivândia; 325 - Beco Prefeitura; João XXIII; Comunidade Lagoa do Mela Mela; 609 - Rua Londrina; Comunidade Canal leste

JULIO CAESAR 195 REGIONAL 5
Ponte sobre o Rio Maranguapinho que corta a Granja Portugal
SIQUEIRA
Localizado na Zona Oeste de Fortaleza, o Siqueira também empresta seu nome aos bairros próximos que compreendem a região como Grande Siqueira. O bairro fica na divisa entre Fortaleza e Maracanaú.
No Siqueira estão grandes avenidas como a Osório de Paiva e Presidente Costa e Silva, que fazem a ligação do bairro com territórios vizinhos. Além do Aeródromo Feijó

DADOS GERAIS
Localização geográfica: Regional 5 / Território 39Faz divisa com os bairros Bom Jardim, Granja Lisboa e Canindezinho
Densidade (hab/km²): 5.289,92
Área total km²: 6,36
Perímetro (km): 12.759,73
Avenidas principais: Avenida General Osório; Avenida Siqueira Campos;
Feiras livres: Feira de Tebas (Rua Tebas)
Ecopontos: Container (Av. Luis Montenegro, esquina com rua C)
IDH: 0,149
ATIVIDADE SOCIAL
Abrigo São Lázaro; TRANSformar; Instituto S.O.S Periferia; Quintal Cultural Dona Francisca/Siqueira;
População estimada: 33.628
População Feminina: 17.255
População Masculina: 16.373
IGREJA
Igreja de São Sebastião; Igreja São Vicente de Paulo;
AURÉLIO ALVES 196 NOSSOS BAIRROS | NOSSA FORTALEZA
Aeródromo Feijó foi inaugurado em dezembro de 2002 e continua em plena atividade nos dias atuais
SAÚDE
Postos de Saúde: Siqueira; CRAS Canindezinho
PRAÇAS
Praças Rua E; Praça das Mães; Parça do Reggae; Praça do Barco; Praça do Itapuã; Praça Valdemar de Albuquerque; Praça Balneário; Praça Josė Carlos de Oliveira; Praça da Barragem; Praça Conjunto Habitacional Tatumundé; Praça Conjunto Habitacional Tatumundé
PARQUE
Parques: Parque Urbano Lagoa da Viúva
RIOS OU LAGOAS
Bacia do Rio Maranguapinho
Sub Bacia: C8
Micro Bacias: C8.2; C8.2.2; C8.2.3
EDUCAÇÃO
Escolas: Joaquim Alves ; Professor Edilson Brasil Soárez; Professor José Círio Pereira Filho; Tomaz Muniz; Professor Agerson Tabosa Pinto; Professor Alexandre Rodrigues De Albuquerque; Professor Expedito Parente; Chico Anysio; Francisca De Abreu Lima; Nogueira; Professor José Círio Pereira Filho; Professora Maria Luiza Mota Machado; Aliança; Criança Esperança; Novo Mundo Pioneiro
CEMITÉRIO
Cemitério Parque Bom Jardim
SEGURANÇA
AIS: 2
TRANSPORTE PÚBLICO
Siqueira/Papicu/Aeroporto; Siqueira/Papicu/13 de Maio;
Siqueira/Oliveira Paiva/Washington Soares; Siqueira/ Papicu/Washington Soares; Grande Circular I; Grande Circular II; Corujão/Bom Jardim; Siqueira/13 de Maio/ Assembleia; Siqueira/Praia de Iracema; Siqueira/Mucuripe/ED; Siqueira/Messejana/Perimetral; Expresso/ Siqueira/Papicu; Antônio Bezerra/Siqueira; Siqueira/ Mucuripe/Barão de Studart;Siqueira/Centro/Expresso;Aracapé/Siqueira; Miguel Arraes/Tatu Mundé; Parque Santa Rosa/Siqueira; Cj Esperança/Siqueira; Siqueira/ Lagoa; Monte Rey/Siqueira; Bom Jardim I; Parque Santa Cecília I; Jardim Jatobá/Siqueira I; Canindezinho; Parque São Vicente/Siqueira; Cj Ceará/Siqueira; Jardim Fluminense; Siqueira/José Bastos/Centro; Siqueira/João Pessoa/Centro; Siqueira/Osório de Paiva/Parangaba; Siqueira/Vila Manoel Sátiro/Parangaba; Bom Jardim II; Parque Santa Maria/Nova Esperança; Parque Santa Cecília II; Urucutuba/Siqueira; Aracapé/Cj Esperança/ Siqueira; Parque Santa Maria/Siqueira; Parque Jerusalém/Siqueira; Parque São João/Siqueira; Parque Santana; Planalto Granja Lisboa; Cj Tatumundé; Nova Esperança/Siqueira; Miguel Arraes/Siqueira ; Jardim Jatobá/Siqueira II; Osório de Paiva/Siqueira
ÁREA EDIFICADA (M2)
Inscrições Residenciais: 4.408
Inscrições Comerciais: 411
Inscrições de Prestação de Serviços: 19
Inscrições Industriais: 1
Assentamentos precários
Conjunto Habitacional: Comunidade 7 de Setembro (Mutirão); Comunidade 8 de Dezembro; Tatumundê.
Favela: Av. Jardim Fluminense; Comunidade 7 de Setembro (Ocupação); Rua Paraíso Verde; Urucutuba/Rosa de Sarom; Parque São Vicente; Rua Alexandra; Rua Cesarina Batista; Rua General Rabelo; Rua Indara; Rua Francisco Machado; Marrocos / Invasão Urucutuba; Ocupação da Paz; Planalto Canindezinho; Favela do Pantanal / Nova Friburgo; Nova Residência; Comunidade Canal leste.
Loteamento Irregular: Rua Alto do Pimenta; Estrada do Jatobá; Loteamento Walter Machado; Sem nome; Esplanada Sumaré; Paraíso Verde; Parque Nazaré
Mutirão: Futuro do Brasil; Mutirão Estrada da urucutuba; NovaVida .
197 REGIONAL 5
REGIONAL 6


























A Lagoa Redonda está na Regional 6, mas, para além deste importante equipamento, os seus 15 bairros abrigam cultura, comércio e área verde. É também o berço do escritor cearense José de Alencar, cuja casa ainda hoje recebe visitantes para celebrar a memória e obra do autor









 Estátua de Iracema na Lagoa de Messejana
Estátua de Iracema na Lagoa de Messejana


























GUIA REGIONAL 6
As águas da lagoa de Messejana fazem parte da bacia do Rio Cocó
BAIRROS
Aerolândia
Alto da Balança

Cambeba
Cidade dos Funcionários
Curió
Coaçu
Guajeru
Jardim das Oliveiras
José de Alencar
Lagoa Redonda
Messejana
Parque Iracema
Parque Manibura
Paupina
São Bento
FCO FONTENELE
200
| NOSSA
NOSSOS BAIRROS
FORTALEZA
SECRETARIA DA REGIONAL 6
Endereço: R. Padre Pedro de Alencar, 789 – Messejana
Fortaleza - CE, 60840-282
Telefone: (85) 3488 3181/ 3488 3103
INFORMAÇÕES GERAIS / CENTRAL DE ACOLHIMENTO
Telefone: (85) 3452 1811
INFRAESTRUTURA
Informações e solicitações de limpeza pública, requalificação de pontos de lixo, pavimentação, tapa buraco, galerias e bocas de lobo. Manutenção e Reforma de praças e espaços público
Telefone: (85) 3452 4271
ORDENAMENTO DE TERRITÓRIO
Informações e cadastramento de vendedores ambulantes, ordenamento de feiras e espaços públicos
Telefone: (85) 3488 3110
Secretário: Túlio Studart
E-mail: tulio.studart@sr6.fortaleza.ce.gov.br
Bacharel em Segurança Pública e em Direito, com especialização em Políticas Públicas, Gestão de Trânsito e Serviços Urbanos, Gestão e Direito do Trânsito. Mestre em Planejamento e Políticas Públicas pela Universidade Estadual do Ceará (Uece) e doutorando em Políticas Públicas pela mesma instituição. É membro do Conselho Estadual de Trânsito do Ceará (Cetran-CE) e foi membro consultivo da Comissão Especial de Assuntos e Estudos sobre Direito de Trânsito e Tráfego da Ordem dos Advogados do Brasil – Secção Ceará (OAB-CE). Presidiu o Fórum Estadual dos Gestores de Trânsito e Transporte do Estado do Ceará e foi membro do Conselho de Apoio ao Ministério Público do Juizado Especial da Parangaba. Foi secretário de estado chefe da Casa Militar do Governo do Ceará (2015 a 2018).

CONTATOS IMPORTANTES
RECEPÇÃO DO GABINETE
Telefone: (85) 3488.3181
ASSISTÊNCIA SOCIAL
Informações e solicitações de cadastro habitacional, cadastro único e encaminhamentos
Telefone: (85) 99959 5517
AGEFIS
156
VIGILÂNCIA SANITÁRIA
Telefone: (85) 3488 3144
201 REGIONAL 6
AEROLÂNDIA
O bairro surgiu no início da década de 1930 quando ainda se chamava Campo da Aviação. O logradouro fica próximo da BR-116, da Avenida Raul Barbosa e de várias outras vias que dão acesso à Fortaleza.
A origem do nome Aerolândia surgiu por conta da proximidade com a Base Aérea de Fortaleza, que foi criada inicialmente dentro dos seus limites. Hoje, a Base encontra-se no bairro Aeroporto.
O bairro foi se desenvolvendo ao longo dos anos e começou a crescer nos anos 1980, por conta da BR-116 e com a construção da Avenida Raul Barbosa, à margem do Rio Cocó.
Equipamento bastante conhecido é o Mercado da Aerolândia, uma estrutura inaugurada no Século XIX e tombada pelo Município como patrimônio histórico.
DADOS GERAIS
Localização
Regional: SR 6
Território: 26
Bairros limítrofes: Alto da Balança, Salinas, Jardim das Oliveiras, Dias Macêdo e Aeroporto
Perímetro (km): 4.820,93
Avenidas principais: Av. Governador Raul Barbosa; BR-116; e Av. Alberto Craveiro
Mercados públicos: Mercado da Aerolândia
Ecopontos: Aerolândia (Rua Tenente Roma, esquina com a BR-116)
IDH: 0,311
ESPORTE
Areninhas da Aerolândia
ATIVIDADE SOCIAL
Coletivo Associação Grupo de Economia Solidária da Aerolândia (Agesa)
IGREJAS
Igreja Presbiteriana de Aerolândia; Igreja de Deus no Brasil Aerolândia; Igreja de Nossa Senhora de Fátima; Igreja Adventista Do Sétimo Dia da Aerolândia; Igreja Cristã Gileade; Igreja de Santo Antônio; Congregação Cristã no Brasil; Igreja Templo dos Príncipes; Mundial Igreja Do Poder De Deus
População estimada: 11.360
População Feminina: 5.995
População Masculina: 5.365
Densidade (hab/km²): 10.280,54
Área (km²): 1,11
PRAÇAS
Praças: Praça da Aerolândia; Polo de Lazer da Aerolândia
MEIO AMBIENTE
Parques: Pista de Skate do Cocó
EDUCAÇÃO
Escolas: Centro de Educação Infantil e Escola Municipal Professora Edith Braga
202 NOSSOS BAIRROS | NOSSA FORTALEZA
Mercado da Aerolândia foi construído com ferro fundido importado da França no século XIX
PATRIMÔNIO HISTÓRICO
Mercado da Aerolândia - Implantado em 1938, foi construído com ferro fundido (importado da França) que veio do Mercado de Ferro, este construído em 1896 e inaugurado no ano seguinte, na antiga Praça Carolina, hoje Praça Waldemar Falcão.

Toda a matéria-prima utilizada na cobertura do Mercado de Ferro era considerada de extremo valor histórico para o Município, por isso, o material foi dividido e deu origem ao mercado da Aerolândia e Pinhões.
Foi tombado pelo Município em 2008 e atualmente recebe atividades culturais e gastronômicas.
SEGURANÇA
AIS: 7
TRANSPORTE PÚBLICO
Ônibus: Siqueira /Papicu/Aeroporto; Aerolândia/Centro; José Walter/BR-116/Avenida N/Centro; Sítio São
João/Centro; José Walter/Papicu/Cidade Jardim; Parque Santa Maria/Centro Fashion; Parque Santa Maria/Centro Fashion (Topic)
ÁREA EDIFICADA (M²)
Inscrições Residenciais: 168.224,90
Inscrições Comerciais: 233.920,06
Inscrições de Prestação de Serviços: 16.918,86
Inscrições Industriais: 0
Assentamentos precários:
Favela Raul Barbosa; Travessa Flamengo; Rua Teófilo Cordeiro; Mutirão Conjunto BR-116; Conjunto Habitacional Parque Ecológico do Cocó e Conjunto Tancredo Neves
AURÉLIO ALVES 203 REGIONAL 6
ALTO DA BALANÇA
O Alto da Balança é um bairro consideravelmente pequeno de Fortaleza, com 0,90 km² de área. O bairro foi reconhecido oficialmente, em 1961.
Uma curiosidade sobre o bairro é que havia uma balança gigante na entrada da rodovia que, atualmente, é a BR-116. Esta balança era mantida pela Secretaria da Fazenda Municipal e servia para a pesagem de mercadorias que chegavam à Cidade.
DADOS GERAIS
Localização
Regional: SR 6
Território: 26
Bairros limítrofes: São João do Tauape, Salinas, Aerolândia e Aeroporto
ATIVIDADE SOCIAL
Projeto Frente Beneficente para Criança; Instituto Ação e Reação
IGREJAS
Igreja Nossa Senhora do Sagrado Coração; Igreja Adventista do Sétimo; Igreja Universal; Capela São Francisco
SAÚDE
Postos de Saúde César Cals de Oliveira
EDUCAÇÃO
Escolas: Escola Municipal Yolanda Queiroz; Centro de Educação Infantil Airton José Vidal Queiroz
População estimada: 12.814
População Feminina: 6.884
População Masculina: 5.930
Densidade (hab/km²): 14.174,78
Área (km²): 0,90
Perímetro (km): 4.316,89
Avenidas Principais: BR-116; Governador Raul Barbosa; General Murilo Borges
Feira: Feira Livre Alto da Balança
IDH: 0,347
ESPORTE
Areninhas: Alto da Balança
Areninha do Alto da Balança - Inaugurada em dezembro de 2020, faz parte de parceria entre a Prefeitura e o Governo do Estado. Teve um investimento de mais de R$ 870 mil. O campo mede 1.246,89 m².
SEGURANÇA
AIS: 7
TRANSPORTE PÚBLICO
Ônibus: Parangaba/Papicu / Montese; Conjunto Cear /Papicu/Montese; Lagoa/Papicu/Via Expressa; Aerolândia/Centro; Jardim União/Centro; Parque Manibura/Centro
ÁREA EDIFICADA (M²)
Inscrições Residenciais: 259.923,44
Inscrições Comerciais: 97.199,97
Inscrições de Prestação de Serviços: 4.255,67
Inscrições Industriais: 540,39
Assentamentos precários: Favelas Comunidade Pantanal do Lagamar, Raul Barbosa, Comunidade Padre Cícero/Areal ou Raul Barbosa, Travessa do Flamengo, Travessa Santos Dumont, Santo Expedito e Lagamar
204 NOSSOS BAIRROS | NOSSA FORTALEZA

AURÉLIO ALVES 205 REGIONAL 6
Na Areninha do Alto da Balanço, jovens têm acesso ao esporte e lazer
CAMBEBA
O bairro Cambeba surgiu na década de 1980 e abrigava somente a Prefeitura de Fortaleza e o Governo do Estado do Ceará. Junto com o surgimento do bairro, nasceu o Centro Administrativo Governador Virgílio Távora, mais conhecido como Centro Administrativo do Cambeba.
Ali estão algumas secretarias estaduais como, por exemplo, a Secretaria das Cidades (SCidades) e a Secretaria da Educação (Seduc), além das sedes do Tribunal de Justiça (TJ-CE) e do Tribunal de Contas dos Municípios (TCM).
Com o tempo, a região foi criando cada vez mais forma de bairro passando a ter condomínios residenciais, buffets, campos de futebol, shoppings, supermercados e tudo que faz parte do dia a dia da população. O Cambeba é vizinho aos bairros Parque Iracema, Cidade dos Funcionários, Parque Manibura, José de Alencar, Seis Bocas e Messejana.

DADOS GERAIS
Localização
Regional: SR 6
Território: 28
Bairros limítrofes: Parque Manibura, Sapiranga, José de Alencar, Messejana, Parque Iracema e Cidade dos Funcionários
CORREGEDORIA
GERAL DA JUSTIÇA
População estimada: 7.625
População Feminina: 4.029
População Masculina: 3.596
Densidade (hab/km²): 2.784,88
Área (km²): 2,74
Perímetro (km): 8.245,97
Avenidas Principais: Oliveira Paiva; Pedro Lazar; Viena Weyne; Ministro José Américo; Washington Soares
IDH: 0,518
Instituída em 1939 por meio de decreto. Por lei datada de 1979, o cargo de Corregedor Geral da Justiça passa a ser exercido, exclusivamente, por desembargador.
IGREJAS
Igreja Presbiteriana; Igreja Batista Reino; Igreja da Cidade; Comunidade da Fé Cristã Zona Sul
206
BAIRROS | NOSSA FORTALEZA
NOSSOS
MEIO AMBIENTE
Unidades de conservação ambiental: Área de Relevante Interesse Ecológico (Arie) Cambeba

CULTURA
Biblioteca Desembargador Jaime de Alencar Araripe; Memorial do Poder Judiciário do Ceará
SEGURANÇA
Bombeiros: 2ª Cia do Batalhão de Busca e Salvamento (BBS)
AIS: 7
TRANSPORTE PÚBLICO
Ônibus: 004 Messejana / Papicu / Cambeba / TJ
ÁREA EDIFICADA (M²)
Inscrições Residenciais: 411.801,70
Inscrições Comerciais: 198.011,53
Inscrições de Prestação de Serviços: 7.594,74
Inscrições Industriais: 1.659,87
Assentamentos precários: Favelas Amador Bueno; Novo Cambeba; e Novo Alagadiço II
No Cambeba está o Centro Administrativo do Estado do Ceará
THAIS MESQUITA 207 REGIONAL 6
CIDADE DOS FUNCIONÁRIOS
O bairro Cidade dos Funcionários tem esse nome pois foi adquirido há mais de 50 anos pelo Governo do Estado, que loteou e vendeu toda a região para funcionários públicos do Ceará.
A Cidade dos Funcionários está na lista dos bairros mais populosos de Fortaleza.
A Igreja da Glória é um dos símbolos, sendo muito buscada para realizações de casamentos e batizados católicos.
O local mais conhecido pela população, com certeza, é o Lago Jacarey, uma opção de lazer para toda a família.

DADOS GERAIS
Localização
Regional: SR 6
Território: 27
Bairros limítrofes: Luciano Cavalcante, Parque Manibura, Cambeba, Parque Iracema, Cajazeiras e Jardim das Oliveiras
População estimada: 18.256
Lago Jacarey atrai moradores da Cidades dos Funcionários e arredores
THAIS MESQUITA 208 NOSSOS BAIRROS | NOSSA FORTALEZA
População Feminina: 10.000
População Masculina: 8.256
Densidade (hab/km²): 6.545,72
Área (km²): 2,79
Perímetro (km): 8.577,54
Avenidas principais: Viena Weyne; BR-116; José Leon; Oliveira Paiva; Desembargador Gonzaga
Mercados públicos: Mercado da Cidade dos Funcionários (Avenida Oliveira Paiva, 1149)
Ecopontos: Rua Dr. José Plutarco, esquina com Rua Professor Aluísio Barros Leal
IDH: 0,572
ATIVIDADE SOCIAL
Iprede (Rua Professor Carlos Lobo, 15)
IGREJAS
Igreja de Nossa Senhora da Glória; Igreja Cristã Gileade; Igreja Presbiteriana do Brasil; Igreja Batista do Calvário; Igreja Adventista do Sétimo Dia; Assembléia de Deus; Shalom
PRAÇAS
Praça da Glória; Praça dos Ipês; Praça Antônio Ferreira Magalhães (Praça do Iprede)
MEIO AMBIENTE
Parques: Parque das Iguanas
Rios ou lagoas: Lago Jacarey; Lagoa do Ipec
PRAÇA DO LAGO JACAREY
A Praça do Lago Jacarey é um espaço de lazer próximo à natureza onde é possível passear e ainda apreciar as belezas do lago.
No entorno há restaurantes com cardápio e estilos musicais variados, quiosques, feirinhas, bancos e um letreiro gigante, colorido, com o nome Lago Jacarey.
Dentre as melhorias feitas em 2020 no equipamento, estão a ampliação da área da praça; o alargamento do calçadão, troca do piso e calçadas no entorno; reforma da academia na praça; travessias elevadas para pedestres; ciclovia e ciclofaixa.
EDUCAÇÃO
Escola Municipal Maria de Lourdes (Rua Luís Mendes, 174)
SEGURANÇA
Delegacias: Delegacia de Polícia Civil - 13º Distrito Policial (Av. Oliveira Paiva, 535)
Bombeiros: Comando de Engenharia de Prevenção de Incêndio (Cepi), Coordenadoria Estadual de Proteção e Defesa Civil (Cedec) e Coordenadoria de Manutenção, Logística e Patrimônio (Comalp) - (Rua Chico Lemos, 946)
AIS: 7
TRANSPORTE PÚBLICO
Ônibus: Jardim Das Oliveiras/Centro; Antônio Bezerra Lagoa/Unifor; Parangaba/Oliveira Paiva/Papicu; Siqueira/Oliveira Paiva/Washington Soares; Messejana/Papicu/Conjunto Tancredo Neves
ÁREA EDIFICADA (M²)
Inscrições Residenciais: 750.385,68
Inscrições Comerciais: 325.455,37
Inscrições de Prestação de Serviços: 18.018,92
Inscrições Industriais: 2.922,76
Assentamentos precários: Favelas Rua General Castelo Branco e Vila Cazumba
Mutirão: Área 2
209 REGIONAL 6
CURIÓ
O Curió é um bairro com bastante área verde, possui árvores espalhadas nas avenidas, ruas, casas e calçadas.
O bairro Curió, conforme o Censo 2010, do Instituto Brasileiro de Geografia e Estatística (IBGE), possui uma população de 7.636 pessoas, distribuída entre 3.761 homens e 3.875 mulheres.
DADOS GERAIS
Localização
Regional: SR 6
Território: 29
Bairros limítrofes: José de Alencar, Lagoa Redonda, Guajeru e Messejana
Avenidas Principais: Washington Soares; Odilon
Guimarães
IDH: 0,188
ARENINHA
População estimada: 7.636
População Feminina: 3.875
População Masculina: 3.761
Densidade (hab/km²): 11.857,14
Área (km²): 0,64
Perímetro (km): 3.897,18
Areninha do Curió - Localizada na Área de Relevante Interesse Ambiental (ARIE) do Sítio Curió. Mais um espaço de lazer e prática de esportes para a população. A Areninha teve um investimento de R$ 1.365.901,25, e conta com campo society de grama sintética, duas áreas de banco de reserva, urbanização e pavimentação, alambrados e iluminação, distribuídos em quase sete mil metros quadrados. A construção da Areninha do Curió faz parte de um dos compromissos da Secretaria do Meio Ambiente do Estado para melhoria da vida comunitária, acolhimento e bem-estar da população.

210
| NOSSA FORTALEZA
NOSSOS BAIRROS
IGREJAS
Igreja Deus é Amor; Igreja Pentecostal O Rei Está Voltando; Ministério Despertai Remanescentes; Nova Fortaleza
EDUCAÇÃO
Escola Municipal de Tempo Integral Laís Rodrigues de Almeida
CULTURA
Espaços culturais: Ponto de Cultura LGBTQI+ Arte de Amar; Pontinho De Cultura Espaço De Brincar
SEGURANÇA
AIS: 3
TRANSPORTE PÚBLICO
Ônibus: Lagoa Redonda/Papicu; Conjunto Curió
ÁREA EDIFICADA (M²)
Inscrições Residenciais: 80.827,23

Inscrições Comerciais: 50.214,45
Inscrições de Prestação de Serviços: 1.053,66
Inscrições Industriais: 1.280,85
Assentamentos precários: -
Favelas: Ocupação São Miguel, Travessa Elieli e Labirinto ou Ocupação Novo Alagadiço;
Mutirão: São francisco
Areninha do Curió fica na Área de Relevante Interesse Ambiental (ARIE) do Sítio Curió
AURÉLIO ALVES 211 REGIONAL 6
COAÇU
O Coaçu fica na divisa entre Fortaleza e Eusébio e dá acesso à rodovia CE-010, que facilita a integração com outros pontos da região. O Coaçu tem vários condomínios de casas, supermercados como o Atacadão na CE-040 e o Assaí Atacadista.

O bairro possui a Areninha do Coaçu, a Praça Pôr do Sol e o Rio Coaçu. Com pelo menos 25 quilômetros de extensão, as águas do Rio Coaçu percorrem quatro municípios do Estado antes de desaguarem no Rio Cocó: Itaitinga, Aquiraz, Eusébio e Fortaleza.
DADOS GERAIS
Localização
Regional: SR 6
Território: 30
Bairros limítrofes: Messejana, Guajeru, Lagoa Redonda, São Bento e Paupina
AURÉLIO ALVES 212 NOSSOS BAIRROS | NOSSA FORTALEZA
Centro das Tapioqueiras e do Artesanato é opção gastronômica e cultural da região
População estimada: 7.188
População Feminina: 3.747
População Masculina: 3.441
Densidade (hab/km²): 4.198,60
Área (km²): 1,71
Perímetro (km): 6.757,07
Avenidas Principais: Gurgel do Amaral; Washington Soares; Eusébio de Queiroz
IDH: 0,255
ARENINHAS
Areninha do Coaçu
IGREJAS
Igreja Pentecostal Árvore da Vida; Igreja Universal ; Santuário Sede; Capela Nossa Senhora de Fátima
SAÚDE
Posto de Saúde Luís Franklin (Rua Alexandre Vieira, s/n)
PRAÇAS
Praça Luiz Franklin
Praça Pôr do Sol - Foi revitalizada em 2019, por meio do Programa de Requalificação de Praças e Áreas Verdes de Fortaleza. A restauração do equipamento teve investimento de R$ 300 mil.
MEIO AMBIENTE
Rios ou lagoas: Rio Coaçu
EDUCAÇÃO
Escola Municipal João Nogueira Jucá; Creche Parceira
Pôr Do Sol
CUTURA
Biblioteca: Biblioteca Casa Futuro (Rua Nelson Mandela, 269)
SEGURANÇA
AIS: 3
TRANSPORTE PÚBLICO
Ônibus: Fortaleza / Iguape / Barro Preto; Parque Santa Rosa / Messejana
ÁREA EDIFICADA (M²)
Inscrições Residenciais: 125.013,17
Inscrições Comerciais: 57.803,17
Inscrições de Prestação de Serviços: 1.170,36
Inscrições Industriais: 2.022,05
Assentamentos precários: Favelas Rua Itaúna e Rua São Jorge; Mutirão Sítio Coaçu
213 REGIONAL 6
GUAJERU
Guajeru está localizado na Zona Sul da Capital. O bairro tem, aproximadamente, 56 ruas e vias. Na localidade, uma boa área para lazer e passeios é a Praça do Guajeru, que possui iluminação, bancos, paisagismo e uma quadra de esportes, além de uma academia ao ar livre.
A praça possui, também, um parque infantil que faz parte do projeto "Praça Amiga da Criança" e um cachorródromo. A Praça tem ainda uma feirinha com cerca de 20 permissionários que atuam nas áreas de gastronomia, artesanato e variedades.

A Praça do Guajeru fica localizada na Estrada do Guajeru, esquina com a Rua Socorro Gomes.
DADOS GERAIS
Localização
Regional: SR 6
Território: 29
Bairros limítrofes: Messejana, Curió, Lagoa Redonda e Coaçu
Mini Areninha do Guajeru - Teve um investimento de R$ 186.593,56 e é fruto do projeto "Juntos por Fortaleza," parceria entre o Governo do Estado do Ceará e a Prefeitura de Fortaleza.
A Mini Areninha do Guajeru foi inaugurada em 2019 e também conta com o projeto social "Atleta Cidadão", que cede equipamentos e profissionais da educação física à população para o acesso gratuito a aulas regulares dentro das comunidades.
O equipamento esportivo possui campo de grama sintética, alambrado, refletores e entorno com piso intertravado. Fica localizado na Praça do Guajeru.
IGREJAS
População estimada: 6.668
População Feminina: 3.583
População Masculina: 3.085
Densidade (hab/km²): 6.208,57
Área (km²): 1,07
Perímetro (km): 4.547,67
Avenidas Principais: Gurgel do Amaral; Washington
Soares; Professor José Arthur de Carvalho
Feira: Feira Livre do Guajeru
IDH: 0,289
ESPORTES
Areninhas: Areninha;
214 NOSSOS BAIRROS | NOSSA FORTALEZA
Igreja Matriz São João Paulo II; Igreja de Santa Luzia; Salão do Reino
PRAÇAS
Praça do Guajeru (R. Socorro Gomes, s/n); Praça Raimundo de Araújo Cabral
EDUCAÇÃO
Escolas: Centro de Educação Infantil João Saraiva Leão; Centro de Educação Infantil Padre José Maria Cavalcante Costa; Escola Municipal João Saraiva Leão; Creche Parceira Nova Esperança
SEGURANÇA
AIS: 3
TRANSPORTE PÚBLICO
Ônibus: Guajeru / Terminal Messejana
ÁREA EDIFICADA (M²)
Inscrições Residenciais: 126.458,78
Inscrições Comerciais: 81.483,96
Inscrições de Prestação de Serviços: 1.381,81

Inscrições Industriais: 7.014,95
Assentamentos precários: Favelas Beco Francisco Geraldo de Souza (visitada), Ocupação Nova Floresta e Ocupação São Miguel; Mutirões Nova Esperança, Sítio São João, Santa Tereza e Santa Rita
Feirinha da Praça Guajeru tem variedade de frutas e verduras
AURÉLIO ALVES 215 REGIONAL 6
JARDIM DAS OLIVEIRAS
Jardim das Oliveirase era conhecido, em 1910, como Santa Luiza do Cocó. Por volta do ano 1913, foi doado um terreno de propriedade da família de Henrique de Castro Oliveira, onde foi colocado um cruzeiro que significava que ali seria construída uma igreja católica. Assim, o bairro mudou para o nome que tem hoje. A igreja foi entregue à população em 1915. Em outubro de 2021, o bairro ganhou a Areninha da Zeza e a Escola Areninha.

DADOS GERAIS
Localização
Regional: SR 6
Território: 27
Bairros limítrofes: Salinas, Luciano Cavalcante, Cidade dos Funcionários, Dias Macêdo e Aerolândia
População estimada: 29.571
População Feminina: 15.547
População Masculina: 14.024
Densidade (hab/km²): 12.377,98
Área (km²): 2,39
Perímetro (km): 6.767,75
Avenidas principais: Rogaciano Leite; José Leon; Léa Pompeu; Desembargador Faustino de Albuquerque; BR-116; Plácido Castelo
Feira: Feira Livre Tancredo Neves (Av. Plácido Cas-
A igreja de Santa Luzia foi inaugurada em 1915
216 NOSSOS BAIRROS | NOSSA FORTALEZA
telo, S/N)
Ecopontos: Lagoa da Zeza; Ecoponto Tancredo Neves
IDH: 0,270
IGREJAS
Paróquia Nossa Senhora Mãe dos Pobres; Igreja Nossa Senhora Aparecida; Igreja do Evangelho Quadrangular; Igreja Batista El Betel de Fortaleza; Igreja Assembléia de Deus ; Igreja de Santa Luzia
SAÚDE
Postos de Saúde: Manoel Carlos Gouveia; Maria de Lourdes
PRAÇAS
Praça da Capela de Nossa Senhora Aparecida; Praça Vila Verde
MEIO AMBIENTE
Rios ou lagoas: Lagoa da Zeza
EDUCAÇÃO
Centro de Educação Infantil Maria De Lourdes Ribeiro Jereissati; Escola Municipal Ismael Pordeus; Escola Municipal Maria De Lourdes Ribeiro Jereissati; Creche Parceira Bem Estar Comunitário; Creche Parceira Cantinho Feliz II
SEGURANÇA
AIS: 7
TRANSPORTE PÚBLICO
Ônibus: Jardim das Oliveiras/Centro; Parque Manibura /Centro; Cidade dos Funcionários/Papicu/Jardim Das Oliveiras
ÁREA EDIFICADA (M²)
Inscrições Residenciais: 539.393,95
Inscrições Comerciais: 118.564,80
Inscrições de Prestação de Serviços: 7.079,61
Inscrições Industriais: 534,64
Assentamentos precários: Favelas Rua Tangará, Vila Cazumba, Comunidade Lagoa da Zeza, Ismael por Deus, Rua Des. Jucá Filho, Amador Bueno e Lagoa do Tijolo; Mutirões Conjunto Lagoa do Tijolo, Pindorama, Área 2, Tancredo Neves, Vila Verde e Tasso Jereissati

JÚLIO CAESAR 217 REGIONAL 6
JOSÉ DE ALENCAR
José Martiniano de Alencar nasceu no sítio Alagadiço Novo, em Messejana. Conhecido nacionalmente, foi dramaturgo, jornalista, advogado, político e um dos maiores representantes da corrente literária indianista brasileira. Veio ao mundo em 1829 e o deixou, aos 48 anos, em 1877.
O bairro José de Alencar, antes chamado Alagadiço Novo, faz uma homenagem ao artista cearense. Seus romances mais conhecidos são: "O Guarani", "Iracema" e "Senhora".
Hoje, o bairro José de Alencar é uma área em crescimento e tem como destaque a casa em que o escritor nasceu e cresceu.
DADOS GERAIS
Localização
Regional: SR 6
Território: 29
Bairros limítrofes: Sapiranga, Lagoa Redonda, Curió, Messejana e Cambeba
IGREJAS
Igreja São Francisco de Assis; Igreja Evangelica Deus e Espirito; Comunidade Cristã Videira Sul; Igreja Universal
EDUCAÇÃO
Escolas: Centro de Educação Infantil Professora Maria Evan Do Carmo (Rua Mateus Almeida, 71); Creche Parceira Jardim Encantado (Rua Ozélia Pontes, 187); Escola Municipal De Tempo Integral José Carvalho (Rua Clodoaldo Arruda, 1300)
PATRIMÔNIO HISTÓRICO
Casa de José de Alencar (Av. Washington Soares, 6055)
CASA DE JOSÉ DE ALENCAR
A casa onde nasceu o escritor e romancista José de Alencar está situada no Sítio Alagadiço Novo e foi adquirida em 1825 pelo padre José Martiniano de Alencar, pai do escritor.
População estimada: 16.003
População Feminina: 8.351
População Masculina: 7.652
Densidade (hab/km²): 5.139,05
Área (km²): 3,11
Perímetro (km): 7.538,11
Avenidas Principais: Washington Soares; Maestro Lisboa; Odilon Guimarães; Engenheiro Leal Lima Verde; Isabel Maia e Silva de Alencar
IDH: 0,377
José de Alencar viveu por nove anos na casa, que hoje é um ícone da cultura brasileira por guardar a memória e a história do escritor cearense.
A casa de José de Alencar (CJA) foi erguida no ano de 1826. A administração e a guarda do patrimônio histórico pertencem, hoje, à Universidade Federal do Ceará (UFC).
São 9 hectares (ha) de área que compreendem uma pequena casa do conjunto original erguida em 1826, atualmente chamada de “casinha”. As ruínas do primeiro engenho a vapor do Ceará, o Museu Arthur Ramos, a Pinacoteca Floriano Teixeira, a Biblioteca Braga Montenegro e um restaurante também fazem parte do espaço.
Em 1964, o então presidente da república, Marechal Humberto Castelo Branco, providenciou o tombamento da Casa de José de Alencar pelo Instituto do Patrimônio Histórico Nacional (Iphan).
218 NOSSOS BAIRROS | NOSSA FORTALEZA
SEGURANÇA
AIS: 7
TRANSPORTE PÚBLICO
Ônibus: Vila Santo Antônio/Nossa Senhora Graças/ Centro; Antônio Bezerra/Centro/Brt; Bela Vista/Centro; Genibaú/Centro; Acaracuzinho; Parangaba/João Pessoa/Centro; Granja Lisboa/Goiabeiras; Dom Luís/Papicu/Centro
Metrô: Estação José de Alencar - Linha Sul
ÁREA EDIFICADA (M²)
Inscrições Residenciais: 441.705,58
Inscrições Comerciais: 155.144,90
Inscrições de Prestação de Serviços: 5.608,69
Inscrições Industriais: 1.220,00
Assentamentos precários: Favelas Ocupação São
Miguel; Neodélia Mota; Rua Roseno Lopes; Travessa Francisco; Ocupação Pantanal ou Maria Tabosa da Silva; Elieu Olá; Travessa Guimarães Gentil; Ocupação Novo Alagadiço Trecho III ou Aquarius; Ocupação
Novo Alagadiço Trecho II - Fulgêncio Cruz; Ocupação
Novo Alagadiço Trecho I; Rua Dr. Airton Junior; Comunidade Uruca; Labirinto ou Ocupação Novo Alagadiço; Mutirões São Miguel Q85/86; São Miguel Q80; São Miguel Q89; Travessa Getulio Vargas; José de Alencar; São Miguel Q82; São Miguel Q75; Parque São Miguel; Lagoa Redonda I; Lagoa Redonda II
 Casa de José de Alencar guarda memória da vida e obra do autor de "Iracema"
Casa de José de Alencar guarda memória da vida e obra do autor de "Iracema"
AURÉLIO ALVES 219 REGIONAL 6
LAGOA REDONDA
Com uma área preservada de lagoas, mata atlântica e mangues, a Lagoa Redonda possui, em seus limites territoriais, o Parque Urbano da Lagoa Redonda, com área verde em toda a sua extensão e a própria Lagoa Redonda, que dá nome ao bairro.
A Lagoa Redonda faz limite com os bairros: José de Alencar e Sapiranga/Coité, ao Norte; Porto das Dunas e Eusébio,ao Sul; Sabiaguaga, a Leste; e Curió, Guajeru e Coaçu, a Oeste.
O clima do bairro é bem agradável por contas das lagoas que o rodeiam: a própria Lagoa Redonda, a da Precabura e a Muritipuá.
DADOS GERAIS
Localização
Regional: SR 6
Território: 29
Bairros limítrofes: Coaçu, Guajeru, Curió, José de Alencar, Sapiranga e Sabiaguaba
ESPORTES
Areninha Lagoa Redonda
ATIVIDADE SOCIAL
ONG Fonte da Vida (R. José Bonfim Junior, 953)
IGREJAS
Igreja Matriz São José; Igreja Nossa Senhora de Fátima; Igreja São Roque; Igreja Santa Terezinha do Menino Jesus; Igreja Santa Edwiges; Igreja Cristã Gileade; Igreja Batista Plenitude
SAÚDE
Postos de Saúde: Posto de Saúde Terezinha Parente (R. Nelson Coelho, 215); Posto de Saúde Galba de Araújo (Av. Professor José Arthur de Carvalho, 1351)
PRAÇA
População estimada: 27.949
População Feminina: 14.593
População Masculina: 13.356
Densidade (hab/km²): 2.428,66
Área (km²): 11,51
Perímetro (km): 14.264,83
Avenidas Principais: Recreio; CE-025; Maestro Lisboa; Odilon guimarães; Gurgel do Amaral; Professor José Arthur de Carvalho
Ecopontos: Lagoa Redonda (Rua Paulo Coelho, esquina com a Rua Paulo Freire)
IDH: 0,253
Praça da Paróquia São José
MEIO AMBIENTE
Floresta do Curió
Parque Urbano da Lagoa Redonda - Possui uma área poligonal que engloba a via paisagística de todo o seu entorno, passando a ter uma área total de 216.794,7645 m². O Parque Urbano da Lagoa Redonda foi criado por meio do decreto Nº 14.026, de 30/05/2017. O local consiste em uma das maiores áreas regulamentadas dentre as lagoas urbanas do Município. A Lagoa Redonda possui em seu entorno uma parcela de mata atlântica ainda preservada. Os parques urbanos são áreas verdes urbanas, que possuem vegetação nativa e características naturais, consideradas como áreas de proteção especial.
220 NOSSOS BAIRROS | NOSSA FORTALEZA
EDUCAÇÃO
Centros de Educação Infantil Olinda Maria Feitosa Parente; Padre Raimundo Leandro de Araújo; Parque São Miguel; Professora Fernanda Maria Alencar Colares; Professora Terezinha Ferreira Parente

Escolas Municipais: Isabel Ferreira; Moreira da Rocha; Parque São Miguel; Professora Fernanda Maria de Alencar Colares; Professora Terezinha Ferreira Parente
SEGURANÇA
AIS: 3
TRANSPORTE PÚBLICO
Ônibus: Lagoa Redonda / Papicu; Conjunto Curió
ÁREA EDIFICADA (M²)
Inscrições Residenciais: 424.964,82
Inscrições Comerciais: 128.854,17
Inscrições de Prestação de Serviços: 2.005,26
Inscrições Industriais: 17.704,00
Assentamentos precários: -
Favelas: Ocupação Nova Floresta; Ocupação São Miguel; Ocupação São Miguel do Brejo; Ocupação São João; Ocupação Itambé; Rua da Granja; Rua Raquel Florêncio; Rua das Palmeiras; Mutirões Sítio São João; Sítio Curió; Lagoa Redonda II
AURÉLIO ALVES 221 REGIONAL 6
Floresta do Curió é a primeira Área de Relevante Interesse Ecológico (ARIE) do Ceará
MESSEJANA
O bairro Messejana é berço de nascimento do escritor cearense José de Alencar. Uma de suas personagens mais famosas, Iracema tem destaque especial na Lagoa da Messejana. A história conta que a “índia dos lábios de mel” lamentou a partida do seu amado, nas águas da Lagoa.

Em homenagem à obra "Iracema", uma estátua da índia foi inserida no meio da lagoa. O monumento imponente, que virou ponto turístico da Cidade, é tombado como patrimônio cultural de Fortaleza.
Mas a história do bairro Messejana começa lá no início do século XVII, quando ainda era aldeia de Paupina. A urbanização da área começou quando os jesuítas da Companhia de Jesus chegaram ao local, que já era habitado por índios potiguares.
Os jesuítas construíram a primeira capela do bairro, que serviu como base para a construção da atual Igreja Matriz de Nossa Senhora da Conceição, localizada na Rua Coronel Joaquim Bezerra, 235.
Muitos anos depois, chegamos à Messejana atual. A Lagoa da Messejana é o cartão postal do bairro, mas, para além de suas belezas, há também opções gastronômicas e culturais.
Outro símbolo do bairro é a tradicional feira no entorno da igreja Matriz Nossa Senhora da Conceição, além do Hospital de Messejana e do Hospital de Saúde Mental Professor Frota Pinto.
Igreja Matriz de Nossa Senhora da Conceição em Messejana
AURÉLIO ALVES 222
BAIRROS | NOSSA FORTALEZA
NOSSOS
DADOS GERAIS
Localização
Regional: SR 6
Território: 28
Bairros limítrofes: Cajazeiras, Parque Iracema, Cambeba, José de Alencar, Curió, Guajeru, Coaçu, Paupina, Santa Maria, Jangurussu e Barroso
População estimada: 41.689
População Feminina: 22.412
População Masculina: 19.277
Densidade (hab/km²): 6.886,19
Área (km²): 6,05
Perímetro (km): 10.777,47
Avenidas principais: Frei Cirilo; BR-116; Jornalista Tomaz Coelho; Gurgel do Amaral; Washington Soares; Mem de Sá; 24 de Novembro; Frei Cirilo
Feira: da Messejana (Rua Joaquim Felício, S/N)
Ecopontos: Messejana (Rua Nicolau Coelho, esquina com a Avenida 24 de Novembro (próximo à Areninha)); Messejana II (Rua José Hipólito, em frente ao número 819); São Bento II (Rua Oliveira Lemos, em frente ao número 199)
Cemitérios: Cemitério de Messejana (Rua Padre Severiano, 290)
IDH: 0,376
ESPORTES
Areninhas: Areninha do Conjunto São Bernardo (R. Cecília Meireles, 603-631); Areninha Paulo Benevides (R. Aveledo, 132)
ATIVIDADE SOCIAL
Associação Comunitária Amigos do Parque Iracema (R. Araújo Torreão)
IGREJAS
Igreja: do Senhor Jesus (Av. Washington Soares, 7600); Paróquia Nossa Senhora da Imaculada Conceição (R. Joaquim Bezerra, 235); Igreja Nossa Senhora do BrasilSeminário Seráfico (Av. Frei Cirilo, 4454); Igreja de Deus em Messejana (R. Penápolis, 75); Igreja Internacional da Graça de Deus (Estr. Barão de Aquiraz, 440); Igreja São João Batista (R. Pedro Estanislau, 130); Igreja do Sagrado Coração de Maria (Av. Frei Cirilo, 4297); Assembleia de Deus Ministerio Fortaleza (Rua Vicente Nobre Macêdo, 654); Igreja São José (R. Eudes Cardoso, 542)

223 REGIONAL 6
MERCADOS PÚBLICOS
Mercado de Messejana (Rua Dr. Pergentino Maia, s/n)
SAÚDE
Postos de Saúde: Posto Messejana (Rua Guilherme Alencar, s/n)
Hospitais: Hospital Geral Waldemar Alcântara (Rua Dr. Pergentino Maia, 1559); Hospital Jesus Sacramentado (Rua Dr. Pergentino Maia, 813); Hospital de Messejana
Emergência (Av. Frei Cirilo, 3480); Hospital de Saúde Mental Professor Frota Pinto - HSM (Rua Vicente Nobre Macêdo, s/n); Hospital Dr. Edmilson Barros de Oliveira (Frotinha Messejana) (Av. Jornalista Tomaz Coelho, 1578); Hospital Distrital Gonzaga Mota Messejana (Gonzaguinha Messejana) (Av. Washington Soares, 7770)
UPA: UPA 24h - Messejana (R. Miguel Gurgel, s/n)
PRAÇAS
Praças: Praça Forte Iracema; Praça Arthur Braga e Praça Bandeirantes

PARQUES
Parques: Parque Urbano Jornalista Demócrito Dummar (Lagoa da Messejana)
MEIO AMBIENTE
Rios ou lagoas: Lagoa da Messejana
Lagoa de Messejana - Principal ponto turístico do bairro. Suas águas refletem a beleza do lugar, com a presença da estátua de Iracema, que dá boas-vindas aos moradores e visitantes.
Lagoa da Messejana é ponto turístico da Capital e equipamento de lazer da população
AURÉLIO ALVES 224 NOSSOS BAIRROS | NOSSA FORTALEZA
As águas da lagoa fazem parte da bacia do Rio Cocó. Seu espelho d’água possui, aproximadamente, 33,7 hectares (ha) e mais de 865 mil metros cúbicos (m³ ) de volume de água. Em seu entorno, encontram-se o Mercado da Messejana, o Clube da Caixa de Fortaleza e o Terminal Integrado da Messejana.
No meio da lagoa, um símbolo em homenagem à literatura brasileira com a obra “Iracema”, do escritor cearense José de Alencar, nascido em Messejana. A estátua de Iracema tem 12 metros de altura e pesa 16 toneladas. A imagem da índia dos lábios de mel está cercada por um espelho d’água que foi tombado como patrimônio cultural pela Prefeitura de Fortaleza.
EDUCAÇÃO
Escolas: Centro de Educação Infantil Irmã Zeferina Maria (Rua Cel. João De Oliveira, S/N); Escolas
Municipais Angélica Gurgel (Rua Doutor Pergentino Maia, 375); Josefa Barros De Alencar (Rua Doutor Joaquim Bento, 590); Professor Clodomir Teófilo Girão (Travessa Rútilo, 108); Professora Raimunda Félix De Alcântara (Iav. Mem De Sá, 384); Creche Parceira Casinha Dos Sonhos (Rua Frei Henrique, 37); Escola Municipal De Tempo Integral Maria Odete da Silva Colares (Rua Cel. João de Oliveira, 687)
PATRIMÔNIO HISTÓRICO
Espelho d'água da Lagoa de Messejana
SEGURANÇA
Juizados: 6ª Unidade do Juizado Especial Cível de Fortaleza

Bombeiros: 3ª Companhia – 3ª Cia/1º BBM (Quartel de Messejana) (Rua Padre Pedro de Alencar, 1901)
AIS: 3
TRANSPORTE PÚBLICO
Ônibus: Siqueira/Papicu/Washington Soares; Conjunto Palmeiras/Papicu
ÁREA EDIFICADA (M²)
Inscrições Residenciais: 1.363.072,60
Inscrições Comerciais: 523.501,81
Inscrições de Prestação de Serviços: 21.756,69
Inscrições Industriais: 8.680,98
Assentamentos precários: Favelas Travessa Maravila; Ocupação da Granjinha; Rua Inácio Moreira; Antigo Matadouro; Rua Joaquim Bento; Frei Henrique Coelho; Travessa Nicolau Coelho; Nicolau Coelho; Parque Iracema; Praça Parque Iracema; Jardim Violeta ou Ocupação Rua Almeida Rego; Santo Expedito; Travessa Juriti; Rua Monte Alegre; Amador Bueno; Novo Cambeba; Mutirões Casa Coração Imaculado; São Miguel / São Bernardo; Parque Iracema
225 REGIONAL 6
PARQUE MANIBURA
O bairro Parque Manibura possui, aproximadamente, 47 ruas e vias distribuídas em seu 1,27 km² de área total. O Parque Manibura fica próximo aos bairros Engenheiro Luciano Cavalcante, Cidade dos Funcionários e Cambeba.

O bairro encontra-se no território 27, juntamente com a Cidade dos Funcionários e o Jardim das Oliveiras, e possui infraestrutura de lazer, moradia, transporte e educação.
No Parque Manibura também se localizam diversos supermercado, farmácias, restaurantes, pizzarias, hospitais públicos e particulares, parques, hotéis, e postos de combustíveis.
É onde está a organização não governamental que tem como missão promover a conservação das terras, florestas e águas da Caatinga: a Associação Caatinga.
DADOS GERAIS
Localização
Regional: SR 6
Território: 27
Bairros limítrofes: Luciano Cavalcante, Edson Queiroz, Sapiranga, Cambeba e Cidade dos Funcionários
População estimada: 7.529
População Feminina: 4.057
População Masculina: 3.472
Densidade (hab/km²): 5.933,02
Área (km²): 1,27
FCO FONTENELE 226 NOSSOS BAIRROS | NOSSA FORTALEZA
Parque Manibura possui, aproximadamente, 47 ruas e vias distribuídas em seu 1,27 km² de área total
Perímetro (km): 4.639,30
Avenidas principais: Oliveira Paiva; Washington Soares; José Leon; Edilson Brasil Soares
IDH: 0,578
ATIVIDADE SOCIAL
Associação Caatinga - Fundada no Ceará em 1998, com o Fundo Samuel Johnson para a Conservação da Caatinga, a Associação Caatinga (AC) visa promover a conservação das terras, florestas e águas para garantir a permanência de todas as formas de vida.
É uma entidade não governamental, sem fins lucrativos, localizada na Rua Carvalho Pereira, 191. A associação atua há 24 anos na busca pela conservação do bioma da Caatinga, única floresta exclusivamente brasileira, com maior biodiversidade entre as regiões semiáridas do mundo.
A Associação atua diretamente por meio de sete li-
nhas de ação: apoio à criação e gestão de áreas protegidas; restauração florestal; disseminação de tecnologias sustentáveis de convivência com o semiárido; educação ambiental; comunicação para a valorização da Caatinga; apoio ao desenvolvimento de políticas públicas socioambientais e fomento à pesquisa.
IGREJAS
Igreja de São Francisco Xavier (R. Salvador Mendonça, 367); Comunidade Esperança de Fortaleza (Rua Vereador Pedro Paulo, 500); Comunidade Católica Filhos do Deus Vivo (R. Eng. Ronaldo de Castro Barbosa, 705); Assembléia de Deus Água Viva (R. Antenor Rocha Alexandre, 190)
PRAÇA
Praça do Iprede
SEGURANÇA
AIS: 7
TRANSPORTE PÚBLICO
Ônibus: Messejana/Papicu/Cambeba / Tj; Antônio Bezerra/Lagoa/Unifor; Parangaba/Oliveira Paiva/Papicu; Siqueira/Oliveira Paiva/ Washington Soares; Curió / Riomar Kennedy
ÁREA EDIFICADA (M²)

Inscrições Residenciais: 306.192,27
Inscrições Comerciais: 185.436,12
Inscrições de Prestação de Serviços: 4.626,14
Inscrições Industriais: 561,51
Assentamentos precários: Favelas Rua José Plutarco; Rua General Castelo Branco; Riacho Doce; Mutirão Rua Isabel Madeira
227 REGIONAL 6
PARQUE IRACEMA
O bairro Parque Iracema é mais um dos locais de Fortaleza que homenageia o escritor cearense José de Alencar, trazendo em seu nome, Iracema, o romance mais conhecido do dramaturgo.

O Parque Iracema possui em torno de 50 ruas e vias e possui uma área de 1,57 km². É um bairro consideravelmente pequeno, com menos de 10 mil habitantes, segundo o Censo 2010, do Instituto Brasileiro de Geografia e Estatística (IBGE).
Os bairros que fazem limite com o Parque Iracema são: Cidade dos Funcionários, Cambeba, Messejana e Cajazeiras.
DADOS GERAIS
Localização
Regional: SR 6
Território: 28
Bairros limítrofes: Cidade dos Funcionários, Cambeba, Messejana e Cajazeiras
População estimada: 8.409
População Feminina: 4.534
População Masculina: 3.875
Densidade (hab/km²): 5.362,88
Área (km²): 1,57
Perímetro (km): 5.515,84
Avenidas Principais: BR-116; Frei Cirilo; Ministo José Américo; Pedro Lazar; Engenheiro Agrônomo José Guimarães Duque; Desembargador Gonzaga
IDH: 0,505
228
| NOSSA FORTALEZA
Parque Del Sol: contato com a natureza perto de uma área residencial e comercial
NOSSOS BAIRROS
IGREJAS
Igrejas: Casa de Oração da Igreja de Cristo (R. Leão Veloso); Igreja Evangélica Assembléia de Deus Pentecostal Tempo de Vencer (Av. Ministro José Américo)
SEGURANÇA
AIS: 7
TRANSPORTE PÚBLICO
Ônibus: Antônio Bezerra / Messejana; Conjunto Tancredo Neves / Centro; Messejana / Rodoviária; Cidade dos Funcionários / Papicu / Jardim das Oliveiras
ÁREA EDIFICADA (M²)
Inscrições Residenciais: 697.144,65
AURÉLIO ALVES
Inscrições Comerciais: 115.966,69
Inscrições de Prestação de Serviços: 1.562,55
Inscrições Industriais: 2.750,35
Assentamentos precários: Favelas Ocupação Leão Veloso ou Ocupação Veloso; Travessa Alódia; Rua Enfermeiro Joaquim Pinto
PARQUE DEL SOL
O Parque del Sol é um parque urbano constituído por uma área verde de mais de 30 mil metros quadrados, um riacho e uma extensa praça com diversos equipamentos de lazer. Fica localizado entre os bairros Cidade dos Funcionários, Cambeba e Parque Iracema.

Em sua estrutura possui um riacho que cruza o Parque, um complexo esportivo e a Praça do Parque Del Sol. Em sua área possui, também, playgroud, pontes, espaço para eventos, restaurante, área para piquenique, caramanchões, lago com peixes ornamentais, entre outros equipamentos de lazer.
Ao seu redor está situado o “Complexo Parque Del Sol”, um conjunto de dezenas de condomínios de apartamentos, além do Centro Comercial Parque Del Sol, espaço que conta com restaurantes, salas de estudo, lojas de roupas, caixa 24 horas, escritórios etc.
As áreas para piqueniques ficam à sombra de árvores, e uma das áreas fica próxima ao complexo esportivo que recebe, frequentemente, eventos esportivos de ciclismo e corrida.
229 REGIONAL 6
PAUPINA
Na década de 1690, a Aldeia de Paupina era formada e povoada por parte da população que integrava a Aldeia de Parangaba. No Guia Turístico de 1961, o bairro Paupina ainda não estava na lista de bairros de Fortaleza.
O equipamento mais conhecido do bairro é o Mosteiro de São Bento, localizado numa parte elevada no limite entre os bairros Paupina e São Bento. O nome Paupina tem origem indígena, pode significar “lagoa limpa” ou “lagoa descoberta”, ou, ainda, “Pai Pina” em referência a um Padre catequizador do aldeamento indígena.
DADOS GERAIS
Localização
Regional: SR 6
Território: 30
Bairros limítrofes: Messejana, Coaçu, São Bento, Pedras, Ancuri e Santa Maria
População estimada: 14.665
População Feminina: 7.623
População Masculina: 7.042
Densidade (hab/km²): 2.708,72
Área (km²): 5,41
Perímetro (km): 15.141,99
Avenidas Principais: BR-116; Rodovia Santos Dumont; Estrada Barão de Aquiraz; Rodovia 4º Anel Viário
Feira: Feira Livre Paupina (Rua Monte Verde, S/N)
Ecopontos: Paupina - Foi entregue à população em 2018, sendo, à época, o 46º equipamento com este perfil implantado na Cidade. Fica na Rua Primeiro de Abril, esquina com a Rua Shirley.
O Ecoponto da Paupina conta com caçambas para coleta e estrutura administrativa de trabalho para as equipes de limpeza urbana, fiscalização e monitoramento. A iniciativa é operada a partir de uma parceria entre a Autarquia de Regulação, Fiscalização e Con-
trole de Serviços Públicos de Saneamento Ambiental (AcFor) e a Secretaria Municipal da Conservação e Serviços Públicos (SCSP).
IDH: 0,246
ESPORTE
Areninhas: Mini Areninha Paupina
IGREJAS
Capela Mãe Rainha Paupina (R. Mozart Anselmo, 350); Igreja Nossa Senhora de Fátima - Fernando de Noronha (R. A, 36); Igreja Deus é Amor | Paupina (Anexo) (Tv. Maria de Lourdes G Lima, 224); Igreja Adventista do Sétimo Dia Paupina (Rua São Judas Tadeu, 66); Igreja Universal (R. Duarte Coelho, 560) Paz Church Messejana (Estr. Barão de Aquiraz); Capela Santíssima Trindade (R. Duarte Coelho, 606)
SAÚDE
Postos de Saúde: Anísio Teixeira (R. Guarany, 355); Otoni Cardoso do Vale (Rua José Teixeira Costa, 643)
PRAÇAS
Praça do Copacabana; Praça Fernando de Noronha
MEIO AMBIENTE
Rios ou lagoas: Lagoa da Paupina
EDUCAÇÃO
Centro de Educação Infantil Professor Anísio Teixeira; Escolas Municipais Cônego Francisco Pereira da Silva; José Barros de Alencar; Professor Anísio Teixeira; Creche Parceira União da Paupina; Escola Municipal de Tempo Integral Guiomar da Silva Almeida
230
| NOSSA
NOSSOS BAIRROS
FORTALEZA
SEGURANÇA
AIS: 3
TRANSPORTE PÚBLICO
Ônibus: Alto Alegre/Escritores / Messejana; Alto Alegre / Escritores / Messejana (Topic); Conjunto Escritores / Messejana; Corujão / Messejana / Barroso / Pedras; Alto Alegre/José Aragão/Messejana; Planalto Coaçu/Messejana; Paupina/Pici
ÁREA EDIFICADA (M²)
Inscrições Residenciais: 370.320,83
Inscrições Comerciais: 265.272,27
Inscrições de Prestação de Serviços: 4.992,87
Inscrições Industriais: 5.819,84
Assentamentos precários: Conjunto Habitacional Paupina; Favelas Travessa Enoque Falcão; Rua da Paz; Rua Recanto da Saudade; Rua João Saldanha; 25 de Dezembro; Rua Duarte Coelho; Rua Coronel Xavier Chaves; Rua Simão Santos; Rua Monte Verde; Sem Nome; José Aragão; José Aragão II; Lucíola;
Mutirões: Bons Amigos; Sítio São José II; Novo Renascer Paupina

FERNANDA BARROS 231 REGIONAL 6
Paupina tem Ecoponto desde 2018 para a coleta de lixo da população
SÃO BENTO
O bairro São Bento possui uma Zona Especial de Interesse Social 2 (Zeis 2) e o Ecoponto São Bento, localizado na Travessa José Teixeira Costa, S/N - Esquina com a Rua São Benedito.
Um dos pontos mais conhecidos do bairro é o Mosteiro de São Bento, instalado desde 1994 na região. Devido à grande atuação dos monges beneditinos, o Mosteiro é um dos locais mais concorridos para cerimônias de casamento.

DADOS GERAIS
Localização
Regional: SR 6
Território: 30
Bairros limítrofes: Paupina e Coaçu
População estimada: 11.964
População Feminina: 6.193
População Masculina: 5.771
Densidade (hab/km²): 5.455,54
Área (km²): 2,19
Perímetro (km): 7.365,55
Avenidas Principais: Washington Soares; Contorno Sul; Contorno Oeste
Ecopontos: São Bento (Travessa José Teixeira Costa, S/N - Esquina com Rua São Benedito); São Bento II (Rua Oliveira Lemos, em frente ao número 199)
IDH: 0,198
232 NOSSOS
| NOSSA
Mosteiro São Bento é residência dos monges beneditinos na Capital. Tradicional missa com cânticos gregorianos ocorre todo domingo, às 10 horas
AURÉLIO ALVES
BAIRROS
FORTALEZA
ESPORTES
Areninhas: Areninha do Alto Alegre
IGREJAS
Igreja de Cristo no Brasil; Igreja Nossa Senhora do Perpétuo Socorro; Igreja Assembleia de Deus Nascidos do Espírito; Igreja São Sebastião; Assembléia de Deus Bíblica do Brasil - Sede Nacional; Igreja Universal;
Mosteiro de São Bento de Fortaleza - Chegou a Fortaleza em 1993, proveniente do Mosteiro de São Bento de Olinda. Inicialmente instalado na Casa Paroquial da Paróquia de Nossa Senhora da Conceição, o mosteiro foi transferidos para o bairro São Bento em 1994.

São Bento é o fundador da ordem dos beneditinos e escreveu uma Regra para seus monges no Monte
Cassino; em seguida, essa Regra serviu de base para outros mosteiros. Hoje em dia, é possível encontrar vários estilos de vida beneditina, no entanto, todas se esforçam por obedecer à Regra.
EDUCAÇÃO
Centros de Educação Infantil Cônego Francisco Pereira da Silva; Dalila Delmas Montenegro; Dom Beda Pereira de Holanda
CULTURA
Espaços culturais: Espaço de Técnicas Criativas
SEGURANÇA
AIS: 3
TRANSPORTE PÚBLICO
Ônibus: Parque Santa Rosa / Messejana; Paupina / Pici
ÁREA EDIFICADA (M²)
Inscrições Residenciais: 234.261,77
Inscrições Comerciais: 54.540,04
Inscrições de Prestação de Serviços: 4.974,02
Inscrições Industriais: 3.713,91
Assentamentos precários: Conjuntos Habitacionais Paupina; Rosa Luxemburgo; Mutirões Bons Amigos; Sítio São José II; Novo Renascer Paupina
233 REGIONAL 6
REGIONAL 7



Praia, parque e dunas, além de shoppings e o Centro de Eventos do Ceará. Ne regional 7 estão a Praia do Futuro, o shopping mais popular da Cidade, o Iguatemi, o quarto maior parque natural em área urbana da América Latina, o Cocó, e as famosas dunas da Sabiaguaba

























 Parque do Cocó
Parque do Cocó


























GUIA REGIONAL 7
Cidade 2000
Cocó
Edson Queiroz
Guararapes
Luciano Cavalcante

Manoel Dias Branco
Praia Do Futuro I

Praia Do Futuro II
Sabiaguaba
Salinas
Sapiranga/Coité
SECRETARIA REGIONAL 7
Endereço: R. Atilano de Moura, 420 – Guararapes
Fortaleza - CE, 60810-180
Telefone: (85) 3241 4820
CONTATOS IMPORTANTES
RECEPÇÃO GERAL
Telefone: (85) 3241 4820
GABINETE SECRETÁRIO
Telefone: (85) 3241 4751
CENTRAL DE ACOLHIMENTO E ARTICULAÇÃO
Informações e solicitações de serviços realizados pela Regional 7
Telefone:(85) 3241.4822/98879 7097 - Ligação e WhatsApp
E-mail: acolhimentoser7@gmail.com
Secretário: Benigno Júnior
E-mail: secretariaregional.07@gmail.com
Graduado em Direito pela Universidade de Fortaleza (UFC). Integrou a Comissão de Desporto da OAB-Ceará. Entre março de 2008 e abril de 2012, exerceu o cargo de secretário-executivo da Secretaria de Esporte e Lazer de Fortaleza (Secel). Em 2012, foi eleito vereador de Fortaleza, atuando como vice-presidente da Comissão de Turismo.
236 NOSSOS BAIRROS | NOSSA FORTALEZA
OUVIDORIA

Telefone: (85) 3105 1231
CONSERVAÇÃO E SERVIÇOS PÚBLICOS
Informações e solicitações de limpeza pública, requalificação de pontos de lixo, pavimentação, tapa buraco, galerias e bocas de lobo
Telefone: (85) 3241 3015
ORDENAMENTO E TERRITÓRIO
Informações e cadastramento de vendedores ambulantes, ordenamento de feiras e espaços públicos
Telefone: (85) 3105 1231
COORDENAÇÃO DE INFRAESTRUTURA
(Informações sobre obras de reforma e manutenção de praças e espaços públicos)
Telefone: (85) 3241 4850
ASSISTÊNCIA SOCIAL
Informações e solicitações de cadastro único e encaminhamentos
Telefone: (85) 3241 4853
AURÉLIO ALVES 237 REGIONAL 7
Praia do Futuro II concentra maior número de barracas de praia e maior faixa de areia
CIDADE 2000
Construído em 1970, o bairro Cidade 2000, antes chamado Conjunto Habitacional Sítio do Cocó, foi criado para funcionar como uma espécie de cidade dormitório para os trabalhadores do entorno, com várias pequenas casinhas, todas no mesmo padrão.
Hoje, o bairro se desenvolveu e conta com todos os tipos de comércios e serviços, além de ter uma praça central que chama atenção pelas opções gastronômicas.
A Cidade 2000 fica localizada dentro do Cocó e mantém a estrutura de um grande conjunto de casas, sendo dividida em 46 quadras com duas alamedas cada, que levam nomes de flores.

DADOS GERAIS
População estimada: 8.272
População Feminina: 4.696
População Masculina: 3.576
Densidade (hab/km²): 16.610,44
Área total: 0,50
Perímetro (km): 2.869,59
Localização: Regional 7, Território 23, na parte leste de Fortaleza. Faz divisa com os bairros Cocó e Manuel Dias Branco.
Avenidas principais: Avenida das Graviolas, Avenida Central, Avenida Nila Gomes de Soárez, Avenida das Adenanteiras, Avenida dos Flamboyants
Feiras livres: Feira da CIdade 2000 (às sextas-feiras, na Avenida Central, 360-183)
Ecopontos: Ecoponto Cidade 2000 (Rua Giselda Cysne, 92)
IDH (IBGE): 0,562
ESPORTE
Areninha Cidade 2000 (Av. Nila Gomes de Soárez, 155).
ATIVIDADE SOCIAL
Centro de Atenção Psicossocial Álcool e outras Drogas (Caps AD) - Atende pessoas que sofrem com problemas psicossociais ou relacionados ao uso abusivo de álcool e outras drogas, tendo como propósito acolher e acompanhar efetivamente o tratamento do usuário e seus familiares, além de promover estratégias de redução de danos e reinserção social. A sede da Cidade 2000 tem capacidade para realizar cerca de 2 mil atendimentos por mês.
IGREJAS
Igreja do Divino Espírito Santo, Assembléia de Deus Templo Central - Cong. Cidade 2000.
238 NOSSOS BAIRROS | NOSSA FORTALEZA
SAÚDE
Postos de Saúde: UAPS Rigoberto Romero;
PRAÇAS
Praça Cidade 2000, Praça Leonam Onofre, Praça da Maçonaria
EDUCAÇÃO
Escolas: EEFM Arquiteto Rogério Froes.

SEGURANÇA
Delegacias: Delegacia de Polícia Civil | 15º Distrito Policial
AIS: 10
TRANSPORTE PÚBLICO
Praia do Futuro/Papicu; Praia do Futuro/Papicu/ED; Cidade 2000/Hospital Geral/Papicu/ED; Meireles/Centro
ÁREA EDIFICADA (M2)
Inscrições Residenciais: 2.285
Inscrições Comerciais: 450
Inscrições de Prestação de Serviços: 32
Inscrições Industriais: 2
THAIS MESQUITA 239 REGIONAL 7
Cidade 2000: bairro era inicialmente cidade dormitório e até hoje é composto em sua maioria por pequenas casas
COCÓ
O Cocó é um dos bairros nobres de Fortaleza. Era um lugar que possuía diversas propriedades, como sítios que faziam extração de sal através das salinas, mas no final dos anos 1970 essa produção caiu e as salinas foram desativadas, o que impulsionou a construção de residências no local.
O bairro hoje tem como principal atrativo o Parque Estadual do Cocó, maior parque urbano da América Latina, com uma área de 1.575 hectares (ha), é um patrimônio cearense.
O Parque do Cocó nasceu através da luta de ambientalistas, que queriam uma região na Cidade que mantivesse a natureza preservada.

Por isso, quem mora no Cocó está em uma região privilegiada, ao lado de uma imensa área verde que ajuda a manter o clima mais agradável, com fácil acesso à parte mais central da Cidade.
DADOS GERAIS
População estimada: 20.492
População Feminina: 11.357
População Masculina: 9.135
Densidade (hab/km²): 6.260,92
Área total: 3,27
Perímetro (km): 10.367,31
Localização: Regional 7, na parte leste de Fortaleza. Faz divisa com os bairros Cidade 2000, Manuel Dias Branco, Edson Queiroz, Tauape, Dionísio Torres, Aldeota e Papicu.
Avenidas principais: Avenida Engenheiro Santana Júnior, Avenida Padre Antônio Tomás, Avenida Sebastião de Abreu, Avenida Santos Dumont.
240 NOSSOS BAIRROS | NOSSA FORTALEZA
O Parque do Cocó nasceu através da luta de ambientalistas
Ecopontos: Ecoponto Cocó (Avenida Padre Antônio Tomás, S/N)
IDH (IBGE): 0,762
ESPORTE
Areninha Parque do Cocó, Areninha Cidade 2000 II (Av. das Adenanteiras).
ATIVIDADE SOCIAL
Casa de acolhimento Casa de Jeremias - Acolhe crianças em vulnerabilidade social e situação de violação de direitos. A instituição promove a convivência familiar e comunitária dos acolhidos e os prepara para o retorno às suas famílias ou os encaminha para adoção.
IGREJAS
Comunidade Católica Shalom (Projeto Mundo NovoCocó), Igreja Evangélica Assembleia de Deus Betesda, Igreja Apostólica Reconstruir Em Cristo.
PRAÇAS
Praça Deputado Marcelo Linhares, Praça Prof. Otávio Lobo, Praça Martins Dourado.
Parques: Parque Estadual do Cocó

MEIO AMBIENTE
Rios ou lagoas: Rio Cocó
FCO FONTENELE 241 REGIONAL 7

FCO FONTENELE 242 NOSSOS BAIRROS | NOSSA FORTALEZA
Parque do Cocó é o maior parque natural em área urbana do Norte e Nordeste
CULTURA
Teatros: Anfiteatro do Parque do Cocó

SEGURANÇA
AIS: 10
TRANSPORTE PÚBLICO
Ônibus: Messejana/Papicu/Cambeba/TJ; Luciano Cavalcante/Papicu; Siqueira/Papicu/Aeroporto; Antônio Bezerra/Papicu; Siqueira/Papicu/13 de Maio; Corujão/Av. Paranjana I;Corujão/Av. Paranjana II; Parangaba/Papicu; Parangaba/Oliveira Paiva/Papicu; Antônio Bezerra/Francisco Sá/Papicu; Parangaba/Papicu/Montese; 045 - Cj Ceará/Papicu/Montese; Corujão/Parangaba/Papicu; Siqueira/Papicu/Washington Soares; Grande Circular I; Grande Circular II; Messejana/Papicu/Washington Soares; Corujão/Grande Circular I; Corujão/Grande Circular II; Parangaba/Papicu/Aeroporto; Messejana/ Papicu/Cambeba/LJ; Lagoa/Papicu/Via Expressa; Antônio Bezerra/Unifor; Campus do Pici/Unifor; Bezerra de Menezes/Santos Dumont; Antônio Bezerra/Papicu/ Antônio Sales; Lagoa Redonda/Papicu; Paupina/Pici; Cj Palmeiras/Papicu; Santos Dumont/Perimetral; Edson Queiróz/Papicu; Praia do Futuro/Papicu; Praia do Futuro/ Papicu/ED; Messejana/Papicu/Cj Tancredo Neves; Cj Alvorada/Papicu; Bom Jardim/Montese/Aldeota; Cidade Func/Papicu/Jardim das Oliveiras; Cidade 2000/Hospital Geral/Papicu/ED; Defensoria/Papicu/Via Câmara; Bezerra de Menezes/Washington Soares; Dom Luís/Papicu/ Centro; Meireles/Centro
Trem/Metrô: Estação Antônio Sales (VLT)
ÁREA EDIFICADA (M2)
Inscrições Residenciais: 9.475
Inscrições Comerciais: 1.824
Inscrições de Prestação de Serviços: 524
Inscrições Industriais: 6
Assentamentos precários: Telemar
243 REGIONAL 7
EDSON QUEIROZ
Também conhecido como Seis Bocas ou Água Fria, o Edson Queiroz é o maior bairro de Fortaleza e está localizado na parte Oeste da Cidade, com uma grande área verde em seu território.
Está localizado em uma região bastante movimentada, tendo como principais pontos de referência o Fórum Clóvis Beviláqua, a Universidade de Fortaleza (Unifor), o Centro de Eventos e o shopping Iguatemi.

O nome do bairro é uma homenagem ao empresário cearense, um dos grandes responsáveis pelo desenvolvimento da região ao construir a Unifor e abrir caminho para o bairro crescer ao redor dela.
DADOS GERAIS
População estimada: 22.210
População Feminina: 11.624
População Masculina: 10.586
Densidade (hab/km²): 1.603,84
Área total: 13,85
Perímetro (km): 22.583,44
Localização: Regional 7, Território 25, na parte leste de Fortaleza. Faz divisa com os bairros Cocó, Manuel Dias Branco, Praia do Futuro, Sabiaguaba, Sapiranga, Parque Manibura, Luciano Cavalcante, Guararapes e Salinas.
Avenidas principais: Avenida Washington Soares, Avenida Dr. Valmir Pontes, Avenida Edilson Brasil Soares, Avenida Antônio Enéas Vieira, Rua Sabiaguaba.
Feiras livres: Feira do Edson Queiroz (às quartas, na Rua Lucas Francisco Antônio)
Cemitérios: Cemitério Memorial Vale da Saudade: Holding
Ecopontos: Ecoponto Edson Queiroz (Rua Vereador
José Batista Barbosa S/N)
IDH (IBGE): 0,350
AURÉLIO ALVES 244 NOSSOS BAIRROS | NOSSA
Passarela que dá acesso ao Centro de Eventos do Ceará, equipamento inaugurado em junho de 2012
FORTALEZA
ATIVIDADE SOCIAL
Escola de Dança e Integração Social para Criança e Adolescente - EDISCA - É uma ONG sem fins lucrativos que promove o desenvolvimento de crianças, adolescentes e jovens em vulnerabilidade social. O projeto tem como missão promover o desenvolvimento humano através da arte e visando formar cidadãos sensíveis, criativos e éticos.
IGREJAS
Igreja Mãe Rainha, Igreja São Sebastião, Capela São Carlos.
SAÚDE
Posto de Saúde Maurício Matos Dourado.
UPAs: UPA 24h - Edson Queiroz
PRAÇAS
Praça Luciano Magalhães, Praça da Juventude.
MEIO AMBIENTE
Rios ou lagoas: Rio Cocó, Lagoa Seca, Lago do Campus da UNIFOR
EDUCAÇÃO
Escolas: EMEIEF Prof. Francisco Maurício de Mattos Dourado, CEI Deputado Edson Queiroz Filho, EMEIEF Washington Soares, EEFM Dom Antônio de Almeida
Lustosa, CEI Antônia Agostinho de Sousa.
CULTURA
Bibliotecas: Biblioteca Central da Unifor
Cinemas: UCI Iguatemi
Museus: Espaço Cultural Unifor, Ecomuseu Natural do Mangue
Teatros: Teatro Celina Queiroz
Centros culturais: Centro de Eventos do Ceará
SEGURANÇA
Delegacias: Delegacia de Polícia Civil | 26º Distrito Policial
Juizados: Justiça Federal 21ª Vara, Fórum Clóvis Beviláqua, 20ª Unidade do Juizado Especial Criminal, 4° Vara de Família de Fortaleza, 1° Vara de Sucessões de Fortaleza.
AIS: 7
TRANSPORTE PÚBLICO
Ônibus: Messejana/Papicu/Cambeba/TJ; Luciano Cavalcante/Papicu; Antônio Bezerra/Lagoa/Unifor; Corujão/Av. Paranjana I; Parangaba/Oliveira Paiva/Papicu; Siqueira/Papicu/Washington Soares; Grande Circular I; Messejana/Papicu/Washington Soares; Corujão/ Grande Circular I; Parangaba/Papicu/Aeroporto; 068 Messejana/Papicu/Cambeba/LJ; Antônio Bezerra/ Unifor; Campus do Pici/Unifor; Parque Manibura/Centro; Lagoa Redonda/Papicu; Cj Alvorada/Messejana; Messejana/Sabiaguaba/Direita; Messejana/Sabiaguaba/Esquerda; Paupina/Pici; Cj Palmeiras/Papicu; Edson Queiroz/Papicu; Messejana/Papicu/Cj Tancredo Neves; Cj Alvorada/Papicu; Cidade Func/Papicu/ Jardim das Oliveiras; Defensoria/Papicu/Via Câmara; Bezerra de Menezes/Washington Soares
ÁREA EDIFICADA (M2)
Inscrições Residenciais: 4.680
Inscrições Comerciais: 3.145
Inscrições de Prestação de Serviços> 19
Inscrições Industriais: 3
Assentamentos precários: Rua Francisco Dantas, Rocinha, Dendê, Baixada do Dendê, Rua Sabiaguaba, Estrada de Salinas
245 REGIONAL 7
GUARARAPES
Localizado na parte Leste de Fortaleza, o Guararapes é um pequeno bairro, mas bem valorizado devido à proximidade de vários pontos-chaves da Cidade.
A região já foi integrada ao Cocó e era conhecida como Mata do Cocó, mas se emancipou com o desenvolvimento, beneficiando-se da proximidade com o shopping Iguatemi e a Unifor.
Apesar de pequeno, o bairro hoje possui hotéis, universidade e a sede da Organização dos Advogados do Brasil no Ceará (OAB-CE), além de ser uma das áreas mais nobres da Cidade.

DADOS GERAIS
População estimada: 5.266
População Feminina: 2.907
População Masculina: 2.359
Densidade (hab/km²): 3.860,70
Área total: 1,36
Perímetro (km): 4.818,92
Localização: Regional 7, Território 24, na parte leste de Fortaleza. Faz divisa com os bairros Edson Queiroz, Luciano Cavalcante e Salinas.
Avenidas principais: Avenida Rogaciano Leite, Avenida Washington Soares, Avenida Coronel Miguel Dias.
Ecopontos: Ecoponto Bairro Guararapes (R. Paulo Roberto Pinheiro, 01)
IDH (IBGE): 0,768
AURÉLIO
246 NOSSOS BAIRROS | NOSSA FORTALEZA
Sede da OAB-CE fica no bairro Guararapes
ALVES
ATIVIDADE SOCIAL
Instituto para Qualificação e Inserção Profissional (iJOVEM) - É uma Organização da Sociedade Civil sem fins lucrativos, que tem como objetivo desenvolver ações para qualificação profissional e inserção de jovens e adolescentes no mercado de trabalho.

O iJOVEM atua como porta-voz e o meio de facilitar o acesso de jovens e adolescentes à primeira experiência de trabalho, através do cadastro, da seleção, da matrícula, do treinamento em programas de qualificação e acompanhamento.
IGREJAS
Igreja Nossa Senhora do Perpétuo Socorro, Igreja Cristã Vida.
PRAÇA
Praça da OAB CULTURA
Museus: Museu do Automóvel
SEGURANÇA
AIS: 10
TRANSPORTE PÚBLICO
Ônibus: Messejana/Papicu/Cambeba/TJ; Luciano Cavalcante/Papicu; Antônio Bezerra/Lagoa/Unifor; Corujão/Av. Paranjana I; Corujão/Av. Paranjana II; Parangaba/Oliveira Paiva/Papicu; Siqueira/Papicu/Washington Soares; Grande Circular I; Grande Circular II; Messejana/Papicu/Washington Soares; Corujão/ Grande Circular I; Corujão/Grande Circular II; Parangaba/Papicu/Aeroporto; Messejana/Papicu/Cambeba/ LJ; Antônio Bezerra/Unifor; Campus do Pici/Unifor; Lagoa Redonda/Papicu; Paupina/Pici; Cj Palmeiras/ Papicu; Edson Queiróz/Papicu; Messejana/Papicu/Cj Tancredo Neves; Cj Alvorada/Papicu; Cidade Func/ Papicu/Jardim das Oliveiras; Defensoria/Papicu/Via Câmara; Bezerra de Menezes/Washington Soares
ÁREA EDIFICADA (M2)
Inscrições Residenciais: 3.262
Inscrições Comerciais: 775
Inscrições de Prestação de Serviços: 40
Inscrições Industriais: 2
Assentamentos precários: -
247 REGIONAL 7
LUCIANO CAVALCANTE
Um dos bairros criados após a saída das salinas da região do Cocó, o Luciano Cavalcante surgiu em 1968. O nome é uma homenagem ao engenheiro que realizou a primeira obra de infraestrutura da região.
Hoje, o Luciano Cavalcante está em uma área privilegiada da Cidade, com alto fluxo de pessoas através da Avenida Washington Soares.
DADOS GERAIS
População estimada: 15.543
População Feminina: 8.400
População Masculina: 7.143
Densidade (hab/km²): 4.016,28
Área total: 3,87
Perímetro (km): 9.027,95
Localização: Leste de Fortaleza. Faz divisa com os bairros Salinas, Guararapes, Edson Queiroz, Parque Manibura, Cidade dos Funcionários e Jardim das Oliveiras.
Avenidas principais: Avenida Washington Soares, Avenida Rogaciano Leite, Avenida Coronel Miguel Dias.
Ecopontos: Ecoponto Luciano Cavalcante (R. José Guilherme da Costa, S/N)
IDH (IBGE): 0,522
ESPORTE
Areninha Campo do Rio (Avenida Coronel Miguel Dias, S/N)
ATIVIDADE SOCIAL
Associação Voar IGREJAS
Paróquia São João Eudes, Comunidade de Nossa Senhora da Libertação, Igreja Adventista Do Sétimo Dia Luciano Cavalcante, Igreja Batista Filadélfia, Igreja de Santa Luzia.
SAÚDE
Posto de Saúde Benedito Arthur de Carvalho
PRAÇAS
Praça João Ventura Martins, Praça Engenheiro José Waldez Botelho, Praça Salinas.
MEIO AMBIENTE
Parques: Parque da Longevidade Fernando Dias Macêdo
Rios ou lagoas: Açude Fernando Macedo (dentro de propriedade privada)
EDUCAÇÃO
Escolas: EMEIEF Professor Luís Costa, EEEP Jaime Alencar de Oliveira, EMTI Johnson, EMEIEF José Carlos de Pinho.
SEGURANÇA
127ª Promotoria de Justiça, 9ª Unidade de Juizado Especial Cível da Comarca de
AIS: 10
248 NOSSOS BAIRROS | NOSSA FORTALEZA
TRANSPORTE PÚBLICO
Ônibus: Messejana/Papicu/Cambeba/TJ; Luciano Cavalcante/Papicu; Jardim das Oliveiras/Centro; Antônio Bezerra/Lagoa/Unifor; Corujão/Av. Paranjana II; Parangaba/Oliveira Paiva/Papicu; Siqueira/Papicu/Washington Soares; Grande Circular II; Messejana/Papicu/Washington Soares; Corujão/Grande Circular II; Parangaba/Papicu/Aeroporto; Messejana/ Papicu/Cambeba/LJ; Antônio Bezerra/Unifor; Campus do Pici/Unifor; Parque Manibura/Centro; Lagoa Redonda/Papicu; Paupina/Pici; Cj Palmeiras/Papicu; Edson Queiróz/Papicu; Messejana/Papicu/Cj Tancredo Neves; Cj Alvorada/Papicu; Cidade Func/Papicu/ Jardim das Oliveiras; Defensoria/Papicu/Via Câmara; Bezerra de Menezes/Washington Soares
ÁREA EDIFICADA (M2)

Inscrições Residenciais: 7.541
Inscrições Comerciais: 1.563
Inscrições de Prestação de Serviços: 46
Inscrições Industriais: 2
Assentamentos precários: Água Fria Galileia ou Favela da Lagoa, Mariano Pinto Bandeira, Rua Efésio, Rua Francisco Chagas, Muttley (Bucle), rua Petrônio Portela, Comunidade Zumbi, Pindorama, Rua Claudio Brasil, Travessa Dep. Feliciano Ataíde (Vila Feliz),
Câmara Municipal de Fortaleza fica na Rua Dr. Thompson Bulcão
249 REGIONAL 7
FERNANDA BARROS
MANUEL DIAS BRANCO
Dono de uma das vistas mais bonitas de Fortaleza, o bairro Manuel Dias Branco era antes chamado de Dunas porque possui grande área inabitada e cercada por dunas.

Agora, é um bairro com muitos casarões e condomínios fechados, além de ser um dos principais pontos de acesso à Praia do Futuro.
O nome Manuel Dias Branco é uma homenagem ao empresário fundador da Padaria Imperial, que posteriormente passou a ser chamada de M. Dias Branco e, atualmente, está entre as maiores empresas do ramo de massas alimentícias do Brasil.
DADOS GERAIS
População estimada: 1.447
População Feminina: 768
População Masculina: 679
Densidade (hab/km²): 324,80
Área total: 4,46
Perímetro (km): 9.961,16
Localização: Regional 7, na parte leste de Fortaleza. Faz divisa com os bairros Cocó, Cidade 2000, Papicu, De Lourdes, Praia do Futuro II e Edson Queiroz.
250 NOSSOS BAIRROS | NOSSA FORTALEZA
Manuel Dias Branco era antes chamado de bairro Dunas
Avenidas principais: Avenida Dr. Aldy Mentor, Avenida Santos Dumont
IDH (IBGE): 0,337
ATIVIDADE SOCIAL
Associação Beneficente E Educacional Nova Jerusalém (Abenj) - Projeto social voltado para crianças e idealizado pela Igreja Presbiteriana Nova Jerusalém. O projeto contribui com reforço escolar, ensino bíblico e atividades de recreação, jiu-jitsu, música e ballet.
IGREJAS
Igreja Apostólica Reconstruir Em Cristo, Igreja Presbiteriana Nova Jerusalém, Igreja Cristã Maranata.
MEIO AMBIENTE
Rios ou lagoas: Rio Cocó, Lagoa do Gengibre, Lagoa da Cidade Fortal, Lagoa do Pesqueiro Sitio Olho D’água.

EDUCAÇÃO
Escolas (seduc): CEI Profa. Maria Odnilra Cruz Moreira.
SEGURANÇA
Juizados: 24ª Unidade do Juizado Especial Cível e Criminal de Fortaleza
AIS: 10
TRANSPORTE PÚBLICO
Ônibus: Praia do Futuro/Papicu; Praia do Futuro/Papicu/ED; Cidade 2000/Hospital Geral/Papicu/ED; Meireles/Centro
ÁREA EDIFICADA (M2)
Inscrições Residenciais: 1.317
Inscrições Comerciais: 110
Inscrições de Prestação de Serviços: 5
Inscrições Industriais: 0
Assentamentos precários: Reassentamento Farol Novo/Gengibre, Lagoa/Morro do Gengibre.
AURÉLIO
251 REGIONAL 7
ALVES
PRAIA DO FUTURO I
Levando o nome de uma das praias mais conhecidas do Brasil, a Praia do Futuro é um bairro à beira-mar que tem como atrativo o mar e as barracas.
O bairro é dividido em I e II. Eles levam esse nome devido a uma manchete do jornal Correio do Ceará, em 4 de março de 1949, que chamava a região de Praia do Futuro porque, na época, ainda era uma região pouco frequentada. As praias de Iracema e Mucuripe eram as principais da região.
Posteriormente, a área foi se expandindo e passou a servir de ocupação para habitantes de baixa renda, que criaram favelas, e, até hoje, a região enfrenta problemas de infraestrutura.
A Praia do Futuro I é a parte mais desenvolvida das duas. Nela estão localizadas a Unidade de Pronto Atendimento (UPA), os principais clubes, a praça mais importante da região, Praça Dom Hélder Câmara, e a maioria das barracas de praia.

252 NOSSOS BAIRROS | NOSSA
FORTALEZA

AURÉLIO ALVES 253 REGIONAL 7
Pela grande extensão, bairro é dividido em Praia do Futuro I e Praia do Futuro II
DADOS GERAIS
População estimada: 6.630
População Feminina: 3.406
População Masculina: 3.224
Densidade (hab/km²): 3.825,74
Área total: 1,73
Perímetro (km): 6.180,38
Localização: Regional III, Território 22, na parte leste de Fortaleza. Faz divisa com os bairros Vicente Pinzon, De Lourdes e Praia do Futuro II.

Avenidas principais: Avenida Santos Dumont, Avenida Dioguinho, Avenida Clóvis Arrais Maia.
IDH (IBGE): 0,291
ATIVIDADE SOCIAL
Instituto Povo do Mar (IPOM) - É uma organização sem fins lucrativos que atende crianças e adolescentes, de 5 a 17 anos, em situação de vulnerabilidade social. O Instituto busca desenvolver ações que contribuam para a formação humana dos jovens por meio da educação, do esporte, arte e tecnologia.
254 NOSSOS BAIRROS | NOSSA FORTALEZA
Letreiro da Praia do Futuro, no calçadão, tem 13,74 metros de largura e 1,70 de altura
IGREJAS
Igreja Presbiteriana Praia do Futuro, Comunidade Cristã Reino de Deus.
SAÚDE
UPAs: UPA 24h - Praia do Futuro (R. Júlio Silva, 440)

PRAÇA
Praça da Paz Dom Hélder Câmara
EDUCAÇÃO
Escolas: EMEIEF Frei Agostinho Fernandes, EMEIF Dom Aloísio Lorscheider, Escola Especial Centro De Integração Psico-Social Do Ceará, Centro De Educação Infantil Professora Belarmina Campos.
SEGURANÇA
AIS: 10
TRANSPORTE PÚBLICO
Grande Circular I; Grande Circular II; Corujão/Grande Circular I; Corujão/Grande Circular II; Praia do Futuro/Papicu; Praia do Futuro/Papicu/ED; Caça e Pesca/Papicu
ÁREA EDIFICADA (M2)
Inscrições Residenciais: 913
Inscrições Comerciais: 204
Inscrições de Prestação de Serviços: 12
Inscrições Industriais: 0
Assentamentos precários: Pintor Antonio Bandeiras, Luxou.
255 REGIONAL 7
AURÉLIO ALVES
PRAIA DO FUTURO II
A Praia do Futuro II, também à beira-mar, é uma continuação da Praia do Futuro I. Tem um estilo mais despojado do que o outro bairro e costuma ter a faixa de areia mais vazia.

Mesmo assim, o bairro também é bastante movimentado por banhistas e turistas e tem como principais pontos as barracas Chico do Caranguejo e Terra do Sol. Na parte 2 do bairro, também há o encontro do mar com o Rio Coaçu e a região do Caça e Pesca.
DADOS GERAIS
População estimada: 11.957
População Feminina: 6.078
População Masculina: 5.879
Densidade (hab/km²): 3.776,69
Área total: 3,17
Perímetro (km): 9.702,21
Localização: Regional 7, Território 22, na parte leste de Fortaleza. Faz divisa com os bairros Praia do Futuro I, Manuel Dias Branco e Edson Queiroz.
Avenidas principais: Avenida Dr. Aldy Mentor, Avenida Dioguinho, Avenida Clóvis Arrais Maia.
Feiras livres: Feira 31 de Março (às segundas, na Rua Edmundo Falcão); Feira da Frei Tito (Rua José Cláudio Gurgel Costa Lima)
IDH (IBGE): 0,168
256 NOSSOS BAIRROS | NOSSA FORTALEZA
Banhistas passeiam entre as barracas de praia que aos fins de semana estão sempre cheias de clientes
AURÉLIO ALVES
ESPORTE
Areninha Praia do Futuro II (Av. Clóvis Arrais Maia, 6470)
ATIVIDADE SOCIAL
Centro Educacional Sol - É uma ONG sem fins lucrativos que atende crianças de 3 a 7 anos em situação de vulnerabilidade social oriundas da comunidade Caça e Pesca. A creche oferece educação infantil no período da manhã, e, à tarde, são desenvolvidas atividades lúdicas: recreação, coral, dança, estudo na biblioteca, contação de histórias, dança e capoeira.
IGREJA
Capela de Santa Teresinha.
SAÚDE
Postos de Saúde: Posto de Saúde Frei Tito
MEIO AMBIENTE
Rios ou lagoas: Rio Cocó, Rio Coaçu
EDUCAÇÃO
Escolas: EMEIEF Frei Tito de Alencar Lima.
SEGURANÇA
AIS: 10
TRANSPORTE PÚBLICO
Ônibus: Messejana/Sabiaguaba/Direita; Messejana/ Sabiaguaba/Esquerda; Praia do Futuro/Papicu; Praia do Futuro/Papicu/ED; Caça e Pesca/Papicu

ÁREA EDIFICADA (M2)
Inscrições Residenciais: 1.205
Inscrições Comerciais: 111
Inscrições de Prestação de Serviços: 5
Inscrições Industriais: 0
Assentamentos precários: Av. Alberto Monteiro, Caça e Pesca/Barra do Cocó, Colonia / Embratel, Rua Onze, Favela dos Cocos, 31 de Março.
257 REGIONAL 7

FCO FONTENELE 258 NOSSOS BAIRROS | NOSSA FORTALEZA
Vista do pôr do sol na duna da Sabiaguaba é um dos maiores atrativos do bairro
SABIAGUABA
Um dos bairros mais isolados da Cidade, a Sabiaguaba possui grandes belezas naturais com suas praias e o Parque Natural das Dunas da Sabiaguaba.
A ponte e a Rua Sabiaguaba surgiram como um facilitador de acesso ao bairro e, hoje, o local conta com movimentação maior devido aos restaurantes da região, como o Complexo da Sabiaguaba, e ao pôr do sol visto de cima da duna.
DADOS GERAIS
População estimada: 2.117
População Feminina: 1.074
População Masculina: 1.043
Densidade (hab/km²): 209,36
Área total: 10,11
Perímetro (km): 17.368,58
Localização: Regional 7, Território 25, na parte leste de Fortaleza. Faz divisa com os bairros Edson Queiroz, Sapiranga, Lagoa Redonda e os municípios de Aquiraz e Eusébio
Avenidas principais: Rua Sabiaguaba, Avenida Manoel Mavignier
IDH (IBGE): 0,267
ATIVIDADE SOCIAL
Casa de Recuperação Libertação aos Cativos - É uma associação sem fins lucrativos voltada para ajudar na integração social e recuperação de indivíduos com dependência do álcool e outras drogas. O espaço permite ao residente em reabilitação um espaço com apoio terapêutico, igualitário e isento de contenção medicamentosa ou mecânica (isolamento).
IGREJA
Igreja de Deus Profetizando as Nações.
MEIO AMBIENTE
Unidades de conservação ambiental: Parque Natural das Dunas da Sabiaguaba
Parques: Dunas da Sabiaguaba
Rios ou lagoas: Rio Pacoti
EDUCAÇÃO
Escolas: Escola Municipal Professora Josefina Parente De Araújo.
SEGURANÇA
AIS: 7
TRANSPORTE PÚBLICO
Ônibus: Lagoa Redonda I; Lagoa Redonda/Abreulândia/Direita; Lagoa Redonda/Papicu; Lagoa Redonda/Abreulândia/Esquerda; Messejana/Sabiaguaba/Direita; 657 Messejana/Sabiaguaba/Esquerda; Gereberaba/Messejana
ÁREA EDIFICADA (M2)
Inscrições Residenciais: 360
Inscrições Comerciais: 73
Inscrições de Prestação de Serviços: 2
Inscrições Industriais: 1
Assentamentos precários: Novo alagadiço II.
259 REGIONAL 7
SALINAS
O Salinas é mais um bairro que surgiu após o fim da exploração de sal na região do Cocó, inclusive levando no nome essa ligação.
A região é tomada, quase por inteira, pelo manguezal do Parque Ecológico do Cocó, mas começou a ter seus primeiros residentes na década de 1970.
Hoje, tem a Avenida Rogaciano Leite como principal ponto de fluxo e é uma região valorizada pela proximidade de universidades e shoppings, bem como do polo de comércio e serviços que cresce nos arredores do bairro.

DADOS GERAIS
População estimada: 4.298
População Feminina: 2.284
População Masculina: 2.014
Densidade (hab/km²): 1.688,14
Área total: 2,55
Perímetro (km): 7.455,26
Localização: Regional 7, Território 24, na parte leste
de Fortaleza. Faz divisa com os bairros Tauape, Edson Queiroz, Guararapes, Luciano Cavalcante, Jardim das Oliveiras, Aerolândia e Alto da Balança.
Avenidas principais: Avenida General Murilo Borges, Avenida Rogaciano Leite
IDH (IBGE): 0,491
ATIVIDADE SOCIAL
Lar Francisco de Assis - Associação sem fins lucrativos que desenvolve um programa de assistência ao idoso em situação de risco social. Oferta atendimento médico, lazer, reflexões, vivências, resgate da autoestima e confecção de peças que geram trabalho e renda.
IGREJA
260
| NOSSA
Igreja de Cristo Salinas
NOSSOS BAIRROS
FORTALEZA
MEIO AMBIENTE
Rios ou lagoas: Rio Cocó

Escolas (seduc): Centro De Educação Infantil José Carlos De Pinho.
PATRIMÔNIO HISTÓRICO
Bens tombados: Riacho Papicu
SEGURANÇA
AIS: 10
TRANSPORTE PÚBLICO
Ônibus: Parangaba/Papicu/Aeroporto; Parque Manibura/Centro; Messejana/Papicu/Cj Tancredo Neves; Edson Queiroz/Papicu/ED; Defensoria/Papicu/Via Câmara
ÁREA EDIFICADA (M2)
Inscrições Residenciais: 1.528
Inscrições Comerciais: 194
Inscrições de Prestação de Serviços: 3
Inscrições Industriais: 0
Assentamentos precários: Muttley (Bucle), Rua Petrônio Portela, Comunidade Zumbi, Reassentamento Favela do Mangue, Rua Julia Sales.
Avenida General Murilo Borges
261 REGIONAL 7
FERNANDA BARROS
SAPIRANGA
A Sapiranga é um bairro localizado na parte Leste de Fortaleza e é marcado pelo contraste social. Por um lado, há grandes casarões e condomínios de alto padrão, por outro, grande concentração de favelas.
Também conhecido como Coité, o bairro cresceu ao redor da Lagoa da Sapiranga e tem, hoje, como principal ponto de referência o shopping Via Sul, que tornou o local ainda mais autossuficiente.

E mesmo para quem precisa se deslocar para outros locais, a Sapiranga tem acesso facilitado para quase todas as regiões da Cidade pela proximidade com as Avenidas Washington Soares e Oliveira Paiva.
DADOS GERAIS
População estimada: 32.158
População Feminina: 16.880
População Masculina: 15.278
Densidade (hab/km²): 6.738,89
Área total: 4,77
Perímetro (km): 9.875,23
Localização: Regional 7, Território 25, na parte leste de Fortaleza. Faz divisa com os bairros Edson Queiroz, Sabiaguaba, Lagoa Redonda, José de Alencar, Cambeba e Parque Manibura.
Avenidas principais: Avenida Washington Soares, Avenida Maestro Lisboa, Avenida Edilson Brasil Soares.
Feiras livres: Feira da Alvorada (Praça da Alvorada)
Ecopontos: Ecoponto Sapiranga (Av. Edilson Brasil Soares, 1220), Ecoponto Sapiranga II (Rua Dr. Correia Lima com Rua Itamar Espíndola, S/N)
IDH (IBGE): 0,338
AURÉLIO ALVES 262 NOSSOS BAIRROS | NOSSA FORTALEZA
Via Sul Shopping está inserido no bairro Sapiranga
ESPORTE
Areninha Alvorada (Av. Conselheiro Gomes de Freitas, S/N) e Areninha Sapiranga (R. Francisca Bezerra, S/N)
ATIVIDADE SOCIAL
Projeto Cidade Criança - Tem como objetivo proporcionar oportunidades de crescimento que tragam novas perspectivas a crianças e adolescentes que estão inseridos em um ciclo de pobreza.
O atendimento é realizado no contraturno escolar e são desenvolvidas atividades em quatro áreas: sócio emocional, espiritual, física e cognitiva. Na prática, são realizadas aulas de informática, música, atividades físicas, devocional e atendimento médico.
IGREJAS
Igreja Matriz São José, Igreja Apostólica Novidade de Vida Fortaleza, Assembléia de Deus Canaã da Água Fria, A Igreja de Jesus Cristo dos Santos dos Últimos Dias - Sapiranga, Comunidade Servos da Divina Misericórdia e do Imaculado Coração de Maria
SAÚDE
Postos de Saúde: UAPS Hélio Goes Ferreira, Posto de Saúde Prof. Monteiro de Moraes.
PRAÇAS
Praça do Conjunto Alvorada. Praça do Cies
MEIO AMBIENTE
Parques: Parque Ecológico da Sapiranga
Rios ou lagoas: Lagoa da Sapiranga
EDUCAÇÃO
Escolas: Escola Municipal Irmã Simas, Escola Municipal Alvorada, EEMTI João Nogueira Jucá, Escola Municipal Professor Aldaci Barbosa, Escola Municipal De Ensino Fundamental Monteiro De Moraes, EEMTI Profa. Tecla Ferreira.
CULTURA
Cinemas: Centerplex Via Sul
Teatros: Teatro Via Sul
SEGURANÇA
AIS: 7
TRANSPORTE PÚBLICO
Ônibus: Antônio Bezerra/Lagoa/Unifor; Corujão/Av. Paranjana I; Parangaba/Oliveira Paiva/Papicu; Siqueira/Oliveira Paiva/Washington Soares; Siqueira/Papicu/Washington Soares; Grande Circular I; Messejana/ Papicu/Washington Soares; Corujão/Grande Circular I; Cidade Func/Cj Alvorada/Centro; Lagoa Redonda I; Parque Manibura/Centro; Lagoa Redonda II; Lagoa Redonda/Papicu; Lagoa Redonda/Abreulândia/Esquerda; Cj Alvorada/Messejana; Messejana/Sabiaguaba/Direita; Messejana/Sabiaguaba/Esquerda; Gereberaba/ Messejana; Paupina/Pici; Cj Palmeiras/Papicu; Cj Alvorada/Papicu; Bezerra de Menezes/Washington Soares
ÁREA EDIFICADA (M2)
Inscrições Residenciais: 4.931
Inscrições Comerciais: 1.504
Inscrições de Prestação de Serviços: 66
Inscrições Industriais: 5
Assentamentos precários: Conj. Alvorada, Riacho Doce, Lagoa seca ou Alvorada, Favela da Conquista ou Alecrim, Parque Novo Paraíso ou Olindina Moreira, Parque Novo Paraiso trecho II, Dendê (Q.38), Dendê (q.168), Lagoa da Sapiranga, Vila Uruca, Cidade Leste, Cachorro Morto, Rua Marcelino Lopes, Rua Brig. Haroldo Veloso, Rua Afonso Pena, Rua Cons. Gomes de Freitas, Pedro Miguel (Lagoa Seca), Rua Guiomar, Rua Pedro Miguel, Rua da Faice, Afonso Pena, Francisca Bezerra (Barro Duro), Travessa José Pedro, Barro Duro, Nosso Sr. do Bonfim, Rua Cons. Gomes de Freitas, Comunidade Lagoa do Coité, Vitória, Travessa São Lucas.
263 REGIONAL 7
REGIONAL 8






Apesar de abranger bairros com baixos IDH, a Regional 8 tem o campus da maior Universidade Estadual do Ceará, o Parque Dom Aloísio Lorscheider e é cercada por projetos sociais que buscam mudar a vida de crianças e jovens





























 Parque Ecológico do Passaré
Parque Ecológico do Passaré



























GUIA REGIONAL 8
BAIRROS
Boa Vista
Dendê

Dias Macêdo
Itaperi
José Walter
Parque Dois Irmãos
Passaré
Planalto Ayrton Senna
Serrinha
SECRETARIA REGIONAL 8
Endereço: R. H, 313 - Parque Dois Irmãos

Fortaleza - CE, 60533-593
Telefone: (85) 3131-7800

Secretário: Mosiah Torgan
E-mail: mosiahtorgan@gmail.com
Graduado em Direito pelo Centro Universitário de Brasília (UniCEUB) atuou em advocacia, trabalhando em empresas do ramo até 2016 na Capital brasileira. Em 2017, assumiu como Secretário da Secretaria Municipal do Desenvolvimento Econômico de Fortaleza, onde atuou até abril de 2020.

FCO FONTENELE 266
|
NOSSOS BAIRROS
NOSSA FORTALEZA
Parque Ambiental do Passaré é um parque urbano para lazer dos fortalezenses no bairro Passaré

CONTATOS IMPORTANTES
GABINETE
Telefone: (85) 3433 2802
E-mail: elizabete.alves@sr4.fortaleza.ce.gov.br



CENTRAL DE ACOLHIMENTO
Telefone: (85) 3433.2860
E-mail: rita.silva@sr4.fortaleza.ce.gov.br / assis.duarte@sr4.fortaleza.ce.gov.br
OUVIDORIA
Telefone: (85) 3433 2862
CONSERVAÇÃO E SERVIÇOS PÚBLICOS
Informações e solicitações de limpeza pública, requalificação de pontos de lixo, pavimentação, tapa buraco, galerias e bocas de lobo
Telefone: (85) 3433 2822
ORDENAMENTO E TERRITÓRIO
Telefone: (85) 3433 2835
E-mail: fernanda.abreu@sr4.fortaleza.ce.gov.br
ASSISTÊNCIA SOCIAL
Telefone: (85) 3433 2857
E-mail: ceben@sdhds.fortaleza.ce.gov.br
AGEFIS
Telefone: 156
COORDENAÇÃO DE INFRAESTRUTURA
Telefone: (85) 3433 2803
E-mail: romulo.pereira@sr4.fortaleza.ce.gov.br
VIGILÂNCIA SANITÁRIA
Telefone: (85) 3433 2829
SAÚDE – CORES 4
Telefone: (85) 3433 2828
267 REGIONAL 8
FORTALEZA
BOA VISTA
O bairro Boa Vista faz divisa com Cajazeiras, Barroso, Passaré e Dias Macedo. É um dos bairros mais jovens de Fortaleza. Criado em 2009 como a junção dos então bairros Castelão e Mata Galinha, essa comunidade abriga pouco mais de 12 mil moradores.
O Boa Vista é cortado por algumas das principais avenidas de Fortaleza, Avenidas Alberto Craveiro e Deputado Paulino Rocha.
É neste bairro que fica localizada a Arena Castelão, estádio que sediou partidas da Copa do Mundo 2014 e da Copa das Confederações 2013, ambas organizadas pela Federação Internacional de Futebol (Fifa). Fundado em 1973, o equipamento é carinhosamente apelidado de “O Gigante da Boa Vista”.
O Castelão foi batizado inicialmente de Governador Plácido Castelão, e o primeiro evento que inaugurou a praça esportiva, em 11 de novembro de 1973, foi o Clássico-Rei, a partida de futebol entre Ceará e Fortaleza, que terminou com placar de 0 a 0.
O estádio também foi palco da recepção do Papa João Paulo II, em 1980. Modernizado para a Copa do Mundo, hoje possui capacidade para 63.903 espectadores sentados, sendo um dos 60 maiores estádios do mundo.
Só por curiosidade: a população estimada do bairro Boa Vista precisaria ser multiplicada por cinco para lotar o estádio.
Boa Vista ainda é sede do Condomínio Espiritual Uirapuru, que movimenta multidões em tempos de Halleluya. Há ainda no bairro o Centro de Formação Olímpica, espaço para desenvolvimento esportivo e desportivo no Ceará.
DADOS GERAIS
Localização: Regional 8 / Território 19 - Faz divisa com os bairros Parangaba, Serrinha, Dias Macedo, Boa Vista, Passaré, Parque Dois Irmãos, Dendê e Maraponga.
População estimada: 12.247
População Feminina: 6.378
População Masculina: 5.869
Densidade (hab/km²): 4.140,30
Área (km²): 2,96
Perímetro (km): 8.249,36

Avenidas principais: Avenida Alberto Craveiro, Avenida Deputado Paulino Rocha.
IDH: 0,284
ESPORTES
Areninha Castelão, Areninha Boa Vista- 1° de abril (Rua 1º de Abril com rua 2 de abril), Areninha Boa Vista (Rua Humberto Holanda Cassundé)
ATIVIDADE SOCIAL

Instituto Intervalo - Tem como missão promover o desenvolvimento pessoal e social da criança, do adolescente e da família por meio de programas comunitários de assistência social, recreação, cultura, esporte, lazer e iniciação ao mundo do trabalho. A instituição tem como valores primordiais a Eficiência, Humanização, Unidade e Transparência. Uma das atividades desenvolvidas é a Escola Circo Social Respeitável Vida.
IGREJAS
Igreja do Santíssimo Sacramento (Condomínio Espiritual Uirapuru - Av. Alberto Craveiro, 2222), Seminário e Casa de Retiros São José de Teologia (Av. Alberto Craveiro, 2300), Igreja de Santo Expedito (R. Ademar Paula)
SAÚDE
Postos de Saúde: UAPS Edmar Fujita (Av. Alberto Craveiro, 1480).
268
| NOSSA
NOSSOS BAIRROS
MEIO AMBIENTE
Parques: Castelão Skate Plaza (Av. Alberto Craveiro, 1501-1673)


Rios ou lagoas: Rio Cocó, Riacho Martinho, Açude Uirapuru.
EDUCAÇÃO
Escolas: Escola Professora Maria Stella Cochrane
Santiago (Rua Antônio Farias, 121), Odilon Gonzaga Braveza (Rua Maestro Néo Miranda, 220), CEI Teodora
Maria da Silva (Rua Quatro Irmãos, s/n), Creche Renascer (Rua Manuel Rodrigues, 325), CEI Jornalista Ivonete Maia (Rua Manoel de Aguiar Pontes, 1525).
CULTURA
Centros culturais: Centro de Formação Olímpica.

SEGURANÇA
Delegacias: 16º Distrito Policial
Juizados: Conselho Tutelar VIII (Av. Alberto Craveiro, 1500), CRAS Castelão (Av. Alberto Craveiro, 1480).
AIS: 7
TRANSPORTE PÚBLICO
Ônibus: Antônio Bezerra/Lagoa/Unifor; Castelão/Parangaba; Jardim União/Parangaba; José Walter/BR 116/Avenida I/Centro; José Walter/ BR 116/Avenida N/Centro; José Walter/Papicu/Cidade Jardim
ÁREA EDIFICADA (M2)
Inscrições Residenciais: não contabilizado
Inscrições Comerciais: não contabilizado
Inscrições de Prestação de Serviços: não contabilizado
Inscrições Industriais: não contabilizado
Assentamentos precários: Travessa 30 de Abril, Favela 1º de Abril, Favela Gavião, Rua M.
 Centro de Formação Olímpica e Castelão vistos de cima
Centro de Formação Olímpica e Castelão vistos de cima
FCO FONTENELE 269 REGIONAL 8
DENDÊ
.A comunidade do bairro Dendê possui um dos menores Índices de Desenvolvimento Humano (IDH) de Fortaleza (0,181). O Dendê tem parte do seu território intacto - sem construções, com área verde.
O bairro possui uma boa ligação e influência com seu vizinho Itaperi. Tanto que parte do campus Itaperi da Universidade Estadual do Ceará (Uece) se estende pelos limites do bairro Dendê.
Sob essa ótica, é no bairro Dendê que está sendo construído o Hospital Universitário da Uece (HUC), que tem previsão de entrega para 2023. O HUC terá 654 leitos de internação distribuídos em três torres (clínica, cirúrgica e materno-infantil). A unidade ocupará uma área de 79,5 mil m² dentro da Uece.
Outro equipamento entregue recentemente e que busca redesenhar a história dessa comunidade é o Parque Dom Aloísio Lorscheider, na Avenida Bernardo Manuel.
Até há alguns anos, aquele espaço abrigava o Instituto Penal Professor Olavo Oliveira II (IPPOO II), que mar-
cou a história de Fortaleza pelas rebeliões, dentre as quais culminou no sequestro como refém (em 1994) do religioso gaúcho dom Aloísio Lorscheider, que foi arcebispo de Fortaleza de 1973 a 1995.
DADOS GERAIS
Localização: Regional 8 / Território 19 - Faz divisa com os bairros Itaperi, Parque Dois Irmãos, Jardim Cearense, Mondubim e Maraponga.
População estimada: 5.637
População Feminina: 2.822
População Masculina: 2.815

Densidade (hab/km²): 2.862,87
Área (km²): 1,97
Perímetro (km): 6.093,65


Avenidas principais: Avenida Bernardo Manuel.
IDH: 0,188
FERNANDA BARROS 270 NOSSOS BAIRROS | NOSSA FORTALEZA
Parque Dom Aloísio Lorscheider tem rampa de skate e estrutura para outros esportes
ESPORTES
Areninhas: Areninha Unidos do Dendê
IGREJA
Igreja de Santa Clara (Av. dos Eucaliptos - Dendê).
SAÚDE
Postos de Saúde: Posto de Saúde Dr. Francisco Monteiro - Chico Passeata; Posto de Saúde Dom Aloísio Lorscheider
Hospitais: Hospital Universitário do Ceará
Policlínicas: Centro de Controle de Zoonoses (CCZ)
PRAÇAS
Praça das Artes - Praça das Artes Leonilson
MEIO AMBIENTE
Parque Dom Aloísio Lorscheider - Inaugurado no início de 2022, o parque está localizado onde já funcionou o presídio IPPOO. A nova área de lazer e esportes de 27 mil m² inclui um campo de futebol, academia ao ar livre, rampa de skate, quadras poliesportivas, além de anfiteatro, quiosques e biblioteca.

Rios ou lagoas: Lagoa da Uece, Riacho Martinho.
EDUCAÇÃO
Escolas: Escola Municipal Projeto Nascente ; CEI Augusto Pontes; CEI Ana Amélia Bezerra de Menezes e Souza; EMTI de Educação Bilíngue Francisco Suderland Bastos Mota; EEEP Leonel de Moura Brizola; EEFM Professora Diva Cabral
SEGURANÇA
AIS: 5
TRANSPORTE PÚBLICO
Ônibus: Parangaba/Alto Da Paz; Messejana/Parangaba; Conjunto Itaperi; Vila Betânia/Parangaba; José Walter/Expedicionários/Centro.
ÁREA EDIFICADA (M2)
Inscrições Residenciais: 3.554
Inscrições Comerciais: 235



Inscrições de Prestação de Serviços: 2
Inscrições Industriais: 0
Assentamentos precários: Conjunto Habitacional Jana Barroso. Travessa Buarque de Macedo, Assentamento Rua Holanda, Assentamento Arco Iris, Favela da Rua Américo Vespucio, Rua 10, Ocupação Júlio Alcides.
271 REGIONAL 8
DIAS MACEDO
Passam pelos limites do bairro Dias Macedo avenidas importantes como a Alberto Craveiro e Senador Carlos Jereissati. O nome do bairro remete à família Macedo, que possuía fartas áreas de terra na região.
A Igreja de São Francisco de Assis, localizada na avenida Alberto Craveiro, 900, é um símbolo e um portão de entrada para o Dias Macêdo.

Outro ponto importante que caracteriza bastante esta comunidade é a Praça Antônio Dias Macêdo, onde fica também a Escola Municipal Antônio Dias Macedo.
A comunidade já fez parte do território do seu vizinho Boa Vista na época em que ainda era chamada Mata Galinha, virou Dias Macedo na década de 1960. A popularização foi acelerada devido à proximidade com a BR116, mas o bairro ainda enfrenta históricos problemas de falta de urbanização.
Os riachos Itaoca e Martinho, que deságuam no Açude Uirapuru, já foram afetados pelas enchentes durante o período de inverno de Fortaleza. Relatos históricos apontam que, em 2004, a água chegou a quase um metro de altura nas proximidades da Alberto Craveiro.
DADOS GERAIS
Localização: Regional 8 / Território 19 - Faz divisa com os bairros Serrinha, Itaperi, Boa Vista, Cajazeiras e Aerolândia.
População estimada: 12.111
População Feminina: 6.364
População Masculina: 5.747
Densidade (hab/km²): 6.988,46
Área (km²): 1,73
Perímetro (km): 8.726,73


Avenidas principais: Avenida Alberto Craveiro, Avenida Senador Carlos Jereissati, Rua Pedro Dantas.
Feiras livres: Feira do Dias Macêdo (Rua Boa Ventura, entre a rua Pedro Dantas e a rua Bandeira de Melo)
Ecoponto: Ecoponto Dias Macêdo (Rua Marechal Bittencourt, 199 - Esquina com Rua Capitão João Ferreira Lima)
IDH: 0,271
THAIS MESQUITA 272 NOSSOS BAIRROS | NOSSA FORTALEZA
Igreja de São Francisco de Assis, na Alberto Craveiro
ATIVIDADE SOCIAL



Associação Nossa Senhora Rainha da Paz (Anspaz)
- Desenvolve trabalho de inclusão e educação social e espiritual com crianças, adolescentes e adultos em situação de vulnerabilidade social.
IGREJAS
São Francisco de Assis; Igreja Universal do Reino de Deus - Dias Macêdo; Capela Santa Teresinha.
SAÚDE
Postos de Saúde: UAPS João Hipolito
PRAÇAS
Praça Renascer, Praça Antônio Dias Macêdo
MEIO AMBIENTE
Rios ou lagoas: Rio Cocó, Riacho Itaoca, Riacho Martinho, Açude Uirapuru.
EDUCAÇÃO
Escolas: EEFM Padre Guilherme Waessen; EEFM Antônio Dias Macedo; Creche Rainha da Paz; Creche Semente do Amanhã ; CEI Audifaz Rios; Escola de Tempo Integral Professor João Hippólyto de Azevedo e Sá
CULTURA
Centros culturais: Espaço Popular de Artes; Associação de Moradores do Bairro Dias Macedo.

SEGURANÇA
Juizados: Conselho Tutelar VI (Rua Pedro Dantas, 334)
AIS: 7
TRANSPORTE PÚBLICO
Ônibus: Siqueira/Papicu/Aeroporto; Parangaba/Papicu/Aeroporto; Dias Macedo/Parangaba; Dias Macedo/Centro
Metrô: -
ÁREA EDIFICADA (M2)
Inscrições Residenciais: 2.300
Inscrições Comerciais: 400
Inscrições de Prestação de Serviços: 19
Inscrições Industriais: 7
Assentamentos precários: Rua Amsterdã, Favela Papouquinho, Rua Bandeira de Melo, Favela Baxio, Cemitério dos Cachorros, Favela Sidrião, Vila Rolim/ Boa Vista, Carcará, Parque Sydrião. Mutirão Renascer, Nova Primavera/ Conj. Dias Macêdo/ Terra Nossa/ Aqui Fico.
273 REGIONAL 8
Assim como seu vizinho Serrinha, o bairro Itaperi tem sua história ligada à Parangaba. O próprio nome Itaperi deriva do indígena, significa “pequena aldeia no meio da grande floresta”.
O bairro é bastante conhecido também pelo nome de algumas de suas ruas que remetem a países. Por exemplo, no bairro Itaperi temos a rua Equador, Alemanha, Austrália, Suécia e Peru. É nesta parte do bairro que fica localizada a Praça Parque das Nações, que faz referência a esse diferencial.
DADOS GERAIS
Localização: Regional 8 / Território 19 - Faz divisa com os bairros Parangaba, Serrinha, Dias Macedo, Boa Vista, Passaré, Parque Dois Irmãos, Dendê e Maraponga.
População estimada: 22.563
População Feminina: 12.076
População Masculina: 10.487
Densidade (hab/km²): 8.851,71
Área (km²): 2,55
Perímetro (km): 9.763,09
Avenidas principais: Avenida Dr. Silas Munguba e Avenida Bernardo Manuel
Ecoponto: Ecoponto Itaperi (Avenida Doutor Silas Munguba, esquina com rua Paraguaçu)
IDH: 0,368
ATIVIDADE SOCIAL
Instituto Nordeste Cidadania (Inec) - Com sede no bairro Itaperi, mas com atuação em toda a região, o Inec tem por finalidade promover a cidadania por meio de programas socioambientais e de microfinanças com objetivo de fomentar o desenvolvimento sustentável. Em votação do Prêmio Melhores ONGs de 2022, ficou pela quinta vez consecutiva entre as 100 melhores organizações do terceiro setor no País.


IGREJA
Igreja de Jesus Cristo dos Santos dos Últimos Dias
SAÚDE
Policlínicas: Hospital Veterinário Prof. Sylvio Barbosa Cardoso FAVET/UECE, CAPS AD Alto da Coruja SER IV.
UPA: UPA Itaperi (R. Betel, sn).
PRAÇAS
Praça Parque das Nações (R. Peru, 1970), Praça do Triângulo, Praça da Rotatória da UECE, Praça Patativa do Assaré.
MEIO AMBIENTE
Rios ou lagoas: Lagoa da Uece, Rio Cazuza.
EDUCAÇÃO
Escolas: EMEIEF Zaíra Monteiro Gondim (Tv. Pedro Águiar, 315), EMEIEF Maria de Carvalho Martins (Av. Dr. Silas Munguba, 4300), EMEIEF Thomaz Pompeu Sobrinho (R. José Meneleu, 531), CEI Padre Marcelino Zanella (R. Inglaterra, 222), Escola Municipal Projeto Nascente (R. Betel, 1715).
Universidade Estadual do Ceará (Uece) - Fundada em 1975, congrega institutos de ensino superior isolados que existiam em várias regiões do Estado. Dentre as faculdades, a Escola de Administração do Ceará, Faculdade de Veterinária do Ceará, Escola de Serviço Social de Fortaleza, Escola de Enfermagem São Vicente de Paula, Faculdade de Filosofia Dom Aureliano Matos, em Limoeiro do Norte – CE, além da Televisão Educativa Canal 5 (hoje, TV Ceará). A. partir de 1979 a Uece foi expandida e passou a atuar em outras cidades do Estado. Hoje possui 78 cursos de graduação, além de mestrados, doutorados e especializações.
274 NOSSOS BAIRROS | NOSSA FORTALEZA
ITAPERI
Em 2022, a Uece permaneceu classificada entre as melhores estaduais do Brasil pelo The World University Rankings, produzido pela revista Times Higher Education (THE). No ranking desse ano, constam apenas três estaduais nordestinas incluindo a Uece .

CULTURA
Bibliotecas: Biblioteca Central da Universidade Estadual do Ceará - UECE (Av. Dr. Silas Munguba, 1700Campus do Itaperi).
Teatro: Grupo Formosura de Teatro (Rua Hum, casa 96).
Centros culturais: CAIIS - Centro Aquático Integrado Iraci Sobrinho (R. José Meneleu, 34)
SEGURANÇA
Juizados: 19ª Unidade do Juizado Especial Cível de Fortaleza (R. Betel, 1330)
AIS: 5
TRANSPORTE PÚBLICO
Ônibus: Antônio Bezerra/Lagoa/Unifor; Parangaba/ Oliveira Paiva/Papicu; Siqueira/Oliveira Paiva/Washington Soares; Conjunto Sumaré/Parangaba; Castelão/ Parangaba; Parangaba/Veneza I; Conjunto Itaperi.
ÁREA EDIFICADA (M2)
Inscrições Residenciais: 6.528
Inscrições Comerciais: 1.023



Inscrições de Prestação de Serviços: 27
Inscrições Industriais: 5
Assentamentos precários: Favela Rua Joselito Oliveira, Comunidade Itaperi (Favela do Sabonete), Rua Peru, Favela Icomacedo, Favela Campo Real, Vila Betânia, Travessa Turiaçu, Ocupação Pupunha, Parque Dois Irmãos/ Ocupação Campo Ipiranga, Comunidade Garibaldi, Ocupação do Neo, Ocupação Rua Libânia/ Dos Buracos.
FERNANDA BARROS 275 REGIONAL 8
Fachada do campus Itaperi. Uece é uma das mais conceituadas universidades do País
JOSÉ WALTER
O bairro Prefeito José Walter faz divisa com os bairros Planalto Ayrton Senna, Mondubim, Parque Dois Irmãos, Passaré, Barroso, Jangurussu e Conjunto Palmeiras.
Localizado nos limites de Fortaleza, faz também divisa com a cidade de Maracanaú. É um bairro majoritariamente residencial, mas com opções de comércio e serviços. Por ser um bairro planejado, possui boa estrutura de serviços públicos.
A história desse bairro, que inicialmente foi criado para atender à expansão populacional de Fortaleza, tem origem no antigo Núcleo Integrado Habitacional do Mondubim, em 1970.
Essa região era formada prioritariamente por conjuntos habitados por famílias pobres que vinham de diversas regiões de Fortaleza. O José Walter foi idealizado como um modelo de cidade planejada, mas, inicialmente, tinha déficits de infraestrutura urbana.
O bairro foi pensado inicialmente para ter 5.500 moradias, mas, atualmente, após diversas ampliações, abriga mais de 32 mil moradores. No bairro também ficam localizados os conjuntos Cidade Jardim e Loteamento Parque Montenegro.
DADOS GERAIS
Localização: Regional 8 / Território 21 - Faz divisa com os bairros Planalto Ayrton Senna, Mondubim, Parque Dois Irmãos, Passaré, Barroso, Jangurussu e Conjunto Palmeiras.

População estimada: 33.427
População Feminina: 18.026
População Masculina: 15.401
Densidade (hab/km²): 3.958,20
Área (km²): 8,45
Perímetro (km): 13.089,23


Avenidas principais: Avenida D, Avenida João de Araújo Lima, Avenida Presidente Costa e Silva.
Mercado Público: Mercado Municipal José Walter (Cruzamento das Avenidas J e E).
Ecoponto: Ecoponto José Walter (Avenida B, S/N - Esquina com Rua 33), Ecoponto José Walter II (Avenida E, esquina com avenida I) e Ecoponto Cidade Jardim II (Rua 16, Quadra 8).
IDH: 0,395
ESPORTES
Areninhas: Areninha José Walter (Rua 69).
276
BAIRROS | NOSSA FORTALEZA
NOSSOS
HISTÓRIA DO BAIRRO
José Walter - No fim da década de 1960, a Prefeitura de Fortaleza comprou terras da família Montenegro, no bairro Mondubim, e passou a planejar a construção de um grande conjunto habitacional. A ideia era atender à demanda crescente por habitação popular na Capital.
A história do bairro Prefeito José Walter tem origem no antigo Núcleo Integrado Habitacional do Mondubim, que buscava construir uma cidade planejada com 4,2 km² no menor tempo possível, o que ocorreu em 1970.

Longe do Centro, nos limites de Fortaleza com Maracanaú, essa região era formada prioritariamente por conjuntos habitados por famílias pobres que vinham de diversas regiões de Fortaleza.
O bairro foi planejado inicialmente para ter 5.500 moradias. Depois, foi ampliado e recebeu outras três etapas de expansão. Naquela época, há quatro décadas, o Conjunto Prefeito José Walter era considerado o maior conjunto habitacional da América Latina.
ATIVIDADE SOCIAL


Unidade de Acolhimento Dr. Silas Munguba - É uma das Unidades de Acolhimento (UA) que compõem a Rede de Atenção Psicossocial (RAPS) e oferece acolhimento transitório às pessoas de ambos os sexos com necessidades decorrentes do uso de álcool, crack e outras drogas. No espaço, as pessoas atendidas são acompanhadas por uma equipe multiprofissional, como profissionais de enfermagem, psicólogos, assistente social e educador físico.
 Área do José Walter é atendida pelo 8º Distrito Policial (DP)
Área do José Walter é atendida pelo 8º Distrito Policial (DP)
FCO FONTENELE 277 REGIONAL 8



FCO FONTENELE 278 NOSSOS BAIRROS | NOSSA FORTALEZA
Vista aérea do José Walter
IGREJAS
Paróquia Santíssima Trindade - Religiosos Sacramentinos; Igreja de Santo Antônio de Pádua; Comunidade N Sra Da Glória - Cidade Jardim; Comunidade Católica Testemunhas da Ressurreição de Cristo; Capela Cristo Ressuscitado; Igreja Presbiteriana de José Walter ; Igreja Universal do Reino de Deus; Congregação Cristã no Brasil - Prefeito José Walter
SAÚDE
Postos de Saúde: UAPS José Walter (Avenida João de Araújo Lima, 1631)
Hospitais: Hospital Distrital Gonzaga Mota José Walter - Gonzaguinha do José Walter (Avenida D, 440)
Policlínicas: Hapvida Clinica José Walter (Av. João de Araújo Lima, 591), Rede Bioclínica José Walter: Glaucoma, Catarata, Retinopatia Diabética em Fortaleza (Av. João de Araújo Lima, 801), Prontoclinica Arruda (Av. L, 780)
UPA: UPA José Walter (Avenida Presidente Costa e Silva, S/N)
PRAÇAS
Praças: Praça da 3ª Etapa, Praça da Bahia, Praça Santo Amaro, Praça da Juventude - Skate Park, Praça Padre Cícero, Praça da Paróquia Santíssima Trindade.
MEIO AMBIENTE
Parques: Polo de Lazer do José Walter.
Rios ou lagoas: Lagoa do Vinícius, Lagoa Manel do Chaga, Açude Montenegro.
EDUCAÇÃO
Escolas: EEFM Polivalente Modelo de Fortaleza (Avenida A, 482), EEM Professor Otavio Terceiro de Farias (Avenida C, 435), CEJA Jose Walter (Avenida L, 1101), EEEP Professor Onelio Porto (Avenida E, 471), EMEIEF Francisco Nunes Cavalcante (R. Poe. Mário Linhares, 561), EMTI Diogo Vital de Siqueira (Av. L, S/N), EMEIEF Nelson Mandela, EMEIF Rachel de Queiroz (Av. C, s/n), Creche Rachel de Queiroz, EMEF
Vânia Maria Neves (R. 54, 1), EMEIEF Monteiro Lobato (R. 83, 187), EMEIF Minha Vida Meus Amores (2 Etapa, Av. D, 380), CEI Rogaciano Leite (Av. J, 1488), EMEIF Ari de Sá Cavalcante (Av. H, 430), CEI Maria Letícia Mota Moreira (R. Clarice Lispector, 13), CEI Pedro Boca Rica (Rua D, S/N Lot. Parque Montenegro II - Pref. José Walter), CEI Professora Maria Luiza Mota Machado (Residencial Cidade Jardim).
CUCA José Walter (R. 69).
CULTURA
Bibliotecas: Biblioteca Comunitária Coisa de Preto.
Teatros: Calçadão do Polo de Lazer do José WalterAnfiteatro
SEGURANÇA
Delegacias: 8º Distrito Policial
Bombeiros: 4ª Companhia de Bombeiros (Av. L, 1901).
Juizados: CRAS Aracapé (Rua N, 515 - Parque Montenegro II), Núcleo de Mediação Comunitária do José Walter MPCE (Rua Vinte Sete, 10).
AIS: 9
TRANSPORTE PÚBLICO
Ônibus: Planalto Ayrton Senna/Expedicionários, Planalto Ayrton Senna/Parangaba, José Walter/BR 116/ Avenida N/Centro
ÁREA EDIFICADA (M2)
Inscrições Residenciais: 17.319
Inscrições Comerciais: 1.412



Inscrições de Prestação de Serviços: 73
Inscrições Industriais: 3
Assentamentos precários: Comunidade Unidos para lutar pela Paz, Favela Palmeiras II, Comunidade São Francisco da Ribanceira do Cocó, Barracal do Cristo Redentor, Comunidade Lago Azul. Loteamento irregular da Rua nova.
279 REGIONAL 8
PARQUE DOIS IRMÃOS
O território do Parque Dois Irmãos é cortado por dois dos principais corredores urbanos de Fortaleza, a Avenida Bernardo Manuel e a Avenida Presidente Costa e Silva.
Essa comunidade começou a tomar forma há pelo menos 50 anos. Boa parte do espaço hoje habitado no bairro é oriundo de grandes lotes que foram sendo vendidos.
DADOS GERAIS

Localização: Regional 8 / Território 20 - Faz divisa com os bairros Passaré, Itaperi, Dendê, José Walter e Mondubim.
População estimada: 27.236
População Feminina: 14.164
População Masculina: 13.072
Densidade (hab/km²): 6.219,68
Área (km²): 4,38
Perímetro (km): 10.310,98


Avenidas Principais: Avenida Bernardo Manuel, Avenida Presidente Costa e Silva
Feiras livres: Feira do Parque Dois Irmãos (Avenida Norte Sul, entre rua 134 e rua 8).
Ecoponto: Ecoponto Rosalina (R. H, 369-397).
IDH: 0,368
Paróquia Mãe Santíssima, na travessa José Pedra
280 NOSSOS BAIRROS | NOSSA FORTALEZA
FERNANDA BARROS
ESPORTES
Areninhas: Areninha Parque Dois Irmãos; Areninha Campo da Rosalina; Areninha Campo do Palito
ATIVIDADE SOCIAL



Missão Vida em Foco Projeto Rosalina
IGREJAS
Igreja Nossa Senhora das Graças; Paróquia Mãe Santíssima; Igreja Nossa Senhora das Graças; Igreja de Santo Expedito; Capela de São Francisco; Estaca Fortaleza Brasil Sul
SAÚDE
Postos de Saúde: UAPS Vicentina Campos; UAPS Edilmar Norões
Policlínicas: Multiclinic Reabilitação Odonto-Médico
PRAÇAS
Praça das Mangueiras; Praça do Veneza; Praça 1° De Maio
MEIO AMBIENTE
Rios ou lagoas: Açude São Jorge, Açude Walter Peixoto de Alencar, Riacho Passaré.
EDUCAÇÃO
Escolas: EMEIF Infante Rosalina Rodrigues; CEI Infante Rosalina Rodrigues; Escola Vicentina Campos Marinho Lopes; CEI Prof. Erasmo da Silva Pitombeira; CEI Manuel Lima Soares; EMEIEF Santa Terezinha; EMEIEF Abdenago da Rocha Lima; EMEIF Profa. Maria José Macário Coelho
CULTURA
Centros culturais: Espaço Musical J. Ramos - Aulas de Instrumentos Musicais; Centro de Lutas e Dança Macedo
SEGURANÇA
Delegacias: 3ª CIA 19º Batalhão Polícia Militar (Av. Norte Sul, S/N).
AIS: 7
TRANSPORTE PÚBLICO
Ônibus: Parque Dois Irmãos/Expedicionários; Conjunto Itaperi; Parangaba/Veneza II; Planalto Ayrton Senna/Expedicionários; Messejana/Parangaba.
ÁREA EDIFICADA (M2)
Inscrições Residenciais: 5.904
Inscrições Comerciais: 913
Inscrições de Prestação de Serviços: 35
Inscrições Industriais: 6
Assentamentos precários: Conjunto Habitacional Jardim Primavera/Itaperi, Conjunto Rosalina. Travessa Novo Brasil, Favela Castanhola, Pq Dois Irmãos Pahilly, 25 de Março, Rua Joselito Oliveira, Comunidade Itaperi (Favela do Sabonete), Travessa 7 de Setembro, Rua Marcelino de Souza, Jardim União III, Comunidade Rosalina, Riacho Doce, Muriçoca/Tubiacanga. Loteamento Irregular Rua das Olimpíadas. Mutirão Jardim União I e Jardim União II.
281 REGIONAL 8
O Passaré ficou valorizado com a realização da Copa do Mundo, em 2014. Nesse meio tempo, foram construídos muitos condomínios de casas e apartamentos de luxo.
Foi no início da década de 1970 que teve início a construção do Centro Administrativo Presidente Getúlio Vargas, e a partir desse período o nome Passaré - que significa “lagoa do atalho” em tupi-guarani - popularizou-se e virou oficialmente o nome do bairro.
Antes disso, ainda na época da então Vila de Arronches (atual Parangaba) e da Vila de Messejana, ficava entre as duas localidades a Lagoa do Passaré, onde então teve início a Sesmaria da Lagoa do Passaré.
A posse da sede dessa Sesmaria, o Sítio Passaré, pertenceu desde o século XIX à família do lusitano Antônio José Moreira Gomes. Mas, em 1942, foi adquirido pelo historiador Raimundo Girão, ex-prefeito de Fortaleza.
DADOS GERAIS
Localização: Regional 8 / Território 20 - Faz divisa com os bairros Itaperi, Dias Macedo, Boa Vista, Cajazeiras, Barroso, Parque Dois Irmãos e José Walter.
População estimada: 50.940
População Feminina: 26.399
População Masculina: 24.541
Densidade (hab/km²): 7.089,77
Área (km²): 7,19
Perímetro (km): 12.574,78

Avenidas principais: Avenida Juscelino KubitschekAvenida Alberto Craveiro, Avenida Deputado Paulino Rocha, Avenida Doutor Silas Munguba, Avenida Presidente Costa e Silva, Avenida Pompílio Gomes.
Feiras livres: Feira do Jardim Castelão e Feira do Jardim União
Ecoponto: Ecoponto Jardim União (Rua Menor Jerônimo, em frente ao nº 2930)
IDH: 0,225
ESPORTES
Areninhas: Areninha Passaré, Areninha Jardim União.
ATIVIDADE SOCIAL

Central Única das Favelas Ceará (CUFA) - A sede da Cufa no Ceará fica localizada no bairro Passaré, mais precisamente no cruzamento da Rua Regina de Fátima com a Travessa Celso Athayde. Fundada há 20 anos no Rio de Janeiro, a Cufa atua em favelas e comunidades periféricas de todo Brasil e de alguns países do mundo. No Ceará, desenvolve alguns projetos como a Taça das Favelas, o Prêmio Pretos Empreendedores e o projeto Mães da Favela.
IGREJAS
Igreja Universal do Reino de Deus; Igreja Nossa Senhora da Consolação; Igreja São Joaquim e Santa Ana; Paróquia São José; Igreja Nossa Senhora do Perpétuo Socorro; Capela Menino Jesus de Praga; Ministério Canaã - Sede Nacional
SAÚDE
Postos de Saúde: UUAPS Janival de Almeida; UAPS Jangurussu ; UAPS Alarico Leite
Hospitais: Hospital SARAH (
Policlínicas: Policlínica Dr. Luiz Carlos Fontenelle
PRAÇAS
Praça Dr. Nilo Henrique Lassi Lopes; Praça Bosque Orlando Sales; Praça Farias Brito; Praça da Quadrangular; Praça Jardim União, Praça da Av. Moura Matos; Praça Desembargador Otacílio Peixoto; Praça Parque Anhembi; Praça Sargento Prata, Praça Ecológica, Praça Canaã, Praça do Sumaré.
282 NOSSOS BAIRROS | NOSSA FORTALEZA
PASSARÉ
MEIO AMBIENTE
Parques: Horto Municipal Falconete Fialho (Av. dos Paroaras, 100), Bosque do Passaré (Av. Prudente Brasil, 79-185), Parque Ecológico Passaré (Av. Prudente Brasil, 1089-841), Zoológico Municipal Sargento Prata (Av. Prudente Brasil, 685), Parque da Lagoa do Passaré.

Rios ou lagoas: Lagoa do Passaré, Riacho Doce, Rio Cazuza.
EDUCAÇÃO
Escolas: EEFM Deputado Paulino Rocha; Escola Delma Hermínia da Silva Pereira; EMEIF André Luis; EMEIEF Raimundo de Moura Matos; EEMTI Integrada 2 de Maio; EMEIEF Francisco Andrade Teófilo Girão
CULTURA
Centros culturais: Espaço Banco do Nordeste Cultural; Projeto Viva Gente
SEGURANÇA
AIS: 7
TRANSPORTE PÚBLICO
Ônibus: Castelão/ Parangaba; Passaré/Parangaba; Passaré/Centro; Passaré/Messejana; Jardim Castelão/Centro; Parangaba/Oliveira Paiva/Papicu
ÁREA EDIFICADA (M2)
Inscrições Residenciais: 9.508
Inscrições Comerciais: 1.368


Inscrições de Prestação de Serviços: 40
Inscrições Industriais: 2
Assentamentos precários: Conjunto Habitacional Santo Antônio do Castelinho. Favela da Rua Marcelino de Souza, Jardim União III, Comunidade Rosalina, Campo Bangu, Riacho Doce, Muriçoca/ Tubiacanga, Travessa Pacata, Travessa Pequena, Travessa J. Gentil, Itaboraí, Comunidade N. S. Aparecida, Comunidade Unidos Venceremos, Rua Lagoa da Prata, Estrada do Itaperi, Av. Pres. Costa e Silva, Rua São Cristóvão, João Paulo II, Rua Safira, Comunidade do Cal. Mutirão Barroso II, Jardim União II, Jardim União I, Barroso I, Comunidade Unidos Venceremos, Lagoa do Prata II/ Jangurussu, Lagoa do Prata I/ Jangurussu

FCO FONTENELE 283 REGIONAL 8
Sede do Banco do Nordeste é ponto de referência no Passaré, na Avenida Silas Munguba
PLANALTO AYRTON SENNA
O Planalto Ayrton Senna é altamente adensado. Também é reconhecido como um dos bairros com menor Índice de Desenvolvimento Humano (IDH) de Fortaleza, 0,168.
A história do bairro remonta ao início da década de 1990, quando um grupo de famílias ocupou um terreno ao lado do Conjunto Prefeito José Walter e passou a demarcar a área. O movimento cresceu, e, ao fim da demarcação, a área era composta por 100 ruas.
O primeiro nome da comunidade foi Pantanal, e os moradores precisaram conviver com conflitos com o Poder Público, pois ocupavam terrenos privados.
Eram aproximadamente 4 mil famílias morando no espaço, a maioria composta por pessoas que vinham do Interior. Não havia saneamento básico, água, pavimentação ou energia elétrica.
Passados alguns anos, os barracos foram dando lugar às casas de alvenaria. O batismo do bairro com o nome atual, Planalto Ayrton Senna, foi decidido em 2001, após uma votação popular no bairro.

Nos últimos anos, o bairro tem recebido equipamentos e serviços públicos, especialmente de educação. Um dos grandes orgulhos é a Feira Livre do Planalto Ayrton Senna, com décadas de história nessa comunidade.
DADOS GERAIS
Localização: Regional 8 / Território 21 - Faz divisa com os bairros José Walter, Mondubim e Aracapé.
População estimada: 39.446

População Feminina: 20.169
 EEM Liceu Estadual Prof. Domingos Brasileiro é uma das principais escolas do Planalto Ayrton Senna
EEM Liceu Estadual Prof. Domingos Brasileiro é uma das principais escolas do Planalto Ayrton Senna
284 NOSSOS BAIRROS | NOSSA FORTALEZA
FERNANDA BARROS
População Masculina: 19.277
Densidade (hab/km²): 11.653,18
Área (km²): 3,39
Perímetro (km): 7.560,32
Avenidas Principais: Avenida Bernardo Manuel, Avenida Francisca Maria da Conceição.
IDH: 0,168
ESPORTES
Areninhas: Areninha Planalto Ayrton Senna (Rua l com Rua José Augusto de Oliveira S/N)
ATIVIDADE SOCIAL



Coletivo Online Planalto Ayrton Senna - Localizado na Rua Paranaí, 1240, atua em parceria com o Instituto Coca-Cola Brasil e promove cursos profissionalizantes.
IGREJAS
Capela Santa Edwirges (R. Virgílio Neto, 515), Igreja de São Pedro (R. Retiro da Felicidade, 181).
Feiras livres: Feira do Planalto Ayrton Senna (Rua Quixadá, entre rua Joaquim dos Anjos e rua Oscar Romero).
SAÚDE
Postos de Saúde: UAPS Zelia Correia (Rua Antonio Pereira, 1495).
Policlínicas: Centro Integrado de Educação e Saúde CIES - Zélia Correia (Rua Antônio Pereira, 1491 - Pantanal), Clinef Clínica de Enfermagem (R. Amaral Peixoto, 830)
MEIO AMBIENTE
Rios ou lagoas: Lagoa Azul.
EDUCAÇÃO
Escolas: EEFM Deputado Joaci Pereira (Rua Professor Pedro Jorge, 830), Liceu Estadual Professor Domingos Brasileiro (Rua Planaltina, s/n), EMIF Geísa Firmo Gonçalves (Rua Zuleica Pontes, 1260), Escola Maria Zélia Correia de Souza (Rua Antônio Pereira, 1495), Creche Maria Zélia Correia de Souza, CEI Arievaldo Viana (R. Dezenove de Março, 799), EMTI Leonel de Moura Brizola (R. Cel. de Queiroz), EMEIEF Tereza D’Ana (R. Cel. de Queiroz, 750), EMEIF Adalberto Studart Filho (R. Campo, 25), EMEF Prof. Maria Marques Cedro (Rua do Sol 1, 285), EMEIEF Jornalista Durval Aires (Rua do Sol 1, 548), Escola Municipal Heitor Villa Lobos (Av. Nova Fortaleza, 1635), EMEF Maria Rochele da Silva (Av. Nova Fortaleza, 1300), CEI Ari de Sá Cavalcante (Av. Francisca Maria da Conceição, 241), EMTI Edgar Linhares Lima (R. Santa Rita, 300).
CULTURA
Bibliotecas: Biblioteca Infantil Nova Vida (R. Planaltina)
Teatro: Cia Teatro IDE (R. Netuno, 120).
SEGURANÇA
AIS: 9
TRANSPORTE PÚBLICO
Ônibus: Planalto Ayrton Senna/Parangaba; Cidade Nova/ Parangaba; Planalto Ayrton Senna/Expedicionários
ÁREA EDIFICADA (M2)
Inscrições Residenciais: 856
Inscrições Comerciais: 120
Inscrições de Prestação de Serviços: 4
Inscrições Industriais: 2
Assentamentos precários: Favela Zuleide Santos, Rua Santo Amaro, Rua Aurora, Lagoa Azul, Ipaumirim, Parque Aracapé, Ipaumirim, Rua Parque Umari, Comunidade Lago Azul. Loteamento Pantanal e Avenida 1. Mutirão Rua Marajá, Conjunto Ipaumirim, Mutirão Ipaumirim.
285 REGIONAL 8
SERRINHA
A comunidade da Serrinha é cortada por duas das principais e mais movimentadas avenidas desta região de Fortaleza: Avenidas Dr. Silas Munguba e Bernardo Manuel.
É no bairro Serrinha que está o Parque Urbano da Lagoa da Itaperoaba. Mas o ponto que pode ser considerado o símbolo do bairro é a Praça da Cruz Grande, a que se tornou espaço para esporte, cultura e lazer.

A história dessa comunidade está muito ligada ao de sua vizinha, Parangaba, que foi ponto de ligação importante para a economia cearense.
Parte do território da Parangaba, aquela região era o ponto intermediário no transporte de gado. A Parangaba ligava o Barro Vermelho - hoje Antônio Bezerra - à Messejana pela Estrada da Paranjana.
Estrada da Paranjana é o que viria a ser a atual Avenida Dr. Silas Munguba. Que também já foi batizada como Avenida Dedé Brasil e Avenida Paranjana.
DADOS GERAIS
Localização: Regional 8 / Território 19 - Faz divisa com os bairros Parangaba, Itaoca, Itaperi, Aeroporto e Dias Macedo.
População estimada: 28.770

População Feminina: 14.947
População Masculina: 13.823
Densidade (hab/km²): 9.752,54
Área (km²): 2,95
Perímetro (km): 9.263,46

Avenidas principais: Avenida Dr. Silas Munguba e Avenida Bernardo Manuel.
Feiras livres: Feira da Serrinha (Rua Montevidéu com rua Estudante Jucá e rua Santiago).
Ecoponto: Ecoponto Serrinha (Rua Inácio Parente, 70,esquina com a Rua Freire Alemão)
IDH: 0,283
FERNANDA BARROS 286 NOSSOS BAIRROS | NOSSA FORTALEZA
Praça da Cruz Grande é símbolo do bairro Serrinha e ponto de encontro da comunidade
HISTÓRIA DO BAIRRO
Praça da Cruz Grande - O espaço é originalmente batizado como Praça Manoel Soares de Sousa. Boa parte da história do bairro se desenvolveu nos entornos desta praça, que sempre foi reconhecida como principal ponto de encontros da comunidade.
ESPORTES
Areninhas: Areninha Serrinha (Av. Silas Munguba com Rua VI), Areninha Praça da Cruz Grande (Av. Silas Munguba com Rua Américo Vespúcio).
ATIVIDADE SOCIAL



Biblioteca Comunitária Viva a Palavra
IGREJAS
Igreja Nossa Senhora De Guadalupe (R. Santiago, 604), Igreja da Imaculada Conceição (Rua IV, sn), Igreja Nossa Senhora do Perpétuo Socorro (R. Benjamin Franklin, 82).
SAÚDE
Posto de Saúde UAPS Luis Albuquerque Mendes; Policlínicas Fisioterapia Clínica Benefisio
PRAÇAS
Praça da Cruz Grande, Praça da Areninha da Serrinha.
MEIO AMBIENTE
Parques: Parque Urbano da Lagoa da Itaperaoba.
Rios ou lagoas: Riacho da Itaoca e Lagoa da Itaperoaba.
EDUCAÇÃO
Escolas: Instituto Irmã Giuliana Galli; EEM Prof. Jáder Moreira de Carvalho; EMEIEF Waldemar Barroso; EMEIF Marcos Valentim Pereira de Sousa; CEI Profa. Heley de Abreu Silva Batista; Escola Especial Instituto Moreira De Sousa; CEI Maria de Carvalho Martins
CULTURA
Bibliotecas: Biblioteca Comunitária Viva a Palavra (R. Benjamin Franklin, 596)
Centros culturais: Projeto ABC - Serrinha, Qu4rteto & Baile de Ritmos (R. Antônio Simões, 585), Centro Cultual Capoeira Água de Beber (R. Gov. João Carlos, 809), Instituto Irmã Giuliana Galli.
SEGURANÇA
Juizados: CRAS Serrinha (Rua Inácio Parente, 100).
AIS: 5
TRANSPORTE PÚBLICO
Ônibus: Antônio Bezerra/Lagoa/Unifor; Parangaba/ Papicu/Aeroporto; Passaré/Parangaba/Via Conjunto Sumaré; Messejana/Parangaba; Arvoredo/Parangaba; José Walter/Centro.
ÁREA EDIFICADA (M2)
Inscrições Residenciais: 4.804
Inscrições Comerciais: 1.055
Inscrições de Prestação de Serviços: 38
Inscrições Industriais: 14
Assentamentos precários: Ocupação Pupunha, Comunidade Garibalde, Ocupação Garibaldi/ Cruzeiro/ Itaperoaba, Ocupação da Neo, Favela da Rampa/ São Salvador, Ocupação Amor Base, Ocupação Inácio Parente, Comunidade Canal Rosinha, Ocupação Aírton Senna II, Favela Atacadão Sen. Carlos Jereissati, Ocupação Rua Libânia/ Dos Buracos, Parque Sydrião, Ocupação Del Rio. Mutirão Nova Primavera/ Conj Dias Macêdo; Terra Nossa/ Aqui Fico, Mutirão Ayrton Sena.
287 REGIONAL 8
REGIONAL 9
















Um dos maiores bairros da Capital está aqui: o Jangurussu. Esta regional chama atenção pelas ações sociais voltadas a jovens, mas também pela inovação econômica. Isso porque no Conjunto Palmeiras os moradores criaram o primeiro banco comunitário do País













 Biblioteca Comunitária Viva a Palavra, no Barroso
Biblioteca Comunitária Viva a Palavra, no Barroso




























290 NOSSOS BAIRROS | NOSSA FORTALEZA
JULIO CAESAR
Parque Urbano da Lagoa de Maria Vieira é conhecido como a “joia da coroa” do bairro Cajazeiras
GUIA DA REGIONAL 9
BAIRROS
Ancuri
Barroso
Cajazeiras
Conjunto Palmeiras
Jangurussu
Parque Santa Maria
Pedras
SECRETARIA REGIONAL 9
Rua Padre Pedro Alencar, 789 – Messejana
CEP: 60.840-282
Telefone: (85) 3488 3103
federal pelo Ceará em três legislaturas (2007 a 2017), foi presidente do órgão estadual de meio ambiente do Estado do Ceará (Conpam, 2011/2013), secretário das Cidades (2018) e secretário executivo de Saneamento do Governo do Estado do Ceará (2019/2022).
CONTATOS IMPORTANTES
RECEPÇÃO DO GABINETE
Telefone: 3488 3103
INFORMAÇÕES GERAIS/CENTRAL DE ACOLHIMENTO
Telefone: (85) 3452 1811
OUVIDORIA:
Telefone: (85) 3276 1639
INFRAESTRUTURA
Informações e solicitações de limpeza pública, requalificação de pontos de lixo, pavimentação, tapa buraco, galerias e bocas de lobo. Manutenção e Reforma de praças e espaços público
Telefone: (85) 3488 3155
ORDENAMENTO DE TERRITÓRIO
Informações e cadastramento de vendedores ambulantes, ordenamento de feiras e espaços públicos
Telefone: (85) 3488 3109
Secretário: Paulo Henrique Lustosa
Bacharel em Administração de Empresas pelo CEUB (1990), pós-graduado em Administração Financeira pela Fundação Getúlio Vargas, mestre em Política Social pela Universidade de Brasília (2002). Doutor pelo Programa de Desenvolvimento e Meio Ambiente pela Universidade Federal do Ceará (UFC). Foi consultor de organismos internacionais de cooperação multilateral e professor de cursos de pos-graduação latu sensu em instituições como Escola Nacional de Administração Pública (ENAP), Fundação Getúlio Vargas (Ebape-FGV), Fundação João Pinheiro, entre outras. Exerceu o mandato de deputado

ASSISTÊNCIA SOCIAL

Informações e solicitações de cadastro habitacional, cadastro único e encaminhamentos
Telefone: (85) 99959 5517
AGEFIS
Telefone: 156
VIGILÂNCIA SANITÁRIA
Telefone: (85) 3488 3144
291 REGIONAL 9
ANCURI
Localizado na região Sul de Fortaleza, o bairro Ancuri está bem próximo do município de Itaitinga e, muitas vezes, é sinalizado como pertencente a esta região.
A palavra Ancuri vem de aricori, Syagrus coronata, que é uma palmeira bem adaptada às regiões secas e áridas da caatinga. Ela apresenta, ainda, grande potencial alimentício, ornamental e forrageiro.
DADOS GERAIS
Localização
Regional: SR 9
Território: 33
Bairros limítrofes: Jangurussu, Conjunto Palmeiras, Pedras, Parque Santa Maria e Paupina
População estimada: 20.070
População Feminina: 10.247
População Masculina: 9.823
Densidade (hab/km²): 9.202,20
Área (km²): 2,18
Perímetro (km): 6.766,46

Avenidas principais: Avenida do Vaqueiro, Rodovia Anel Viário, Rua A (Lot Portal de Iracema), Rua Ângelina Muniz, Rua Antônio Pita, Rua B (Lot Portal de Iracema), Rua Babilônia, Rua Brejo Santo, Rua C (Lot Portal de Iracema), Rua Campo do Cruzeiro
Ecopontos: Alameda das Palmeiras
Cemitérios: Cemitério Parque Anjo da Guarda
IDH: 0,204
HISTÓRIA DO BAIRRO
Dentre as curiosidades, está a lenda urbana de um antigo conservatório de música abandonado que seria uma “casa mal assombrada” por um homem da capa preta. O espaço foi construído em 1989 e funcionou até 2005 como a Escola de Música do Ancuri.
ESPORTES
Areninha Santa Maria
ATIVIDADE SOCIAL

Associação Santo Dias; Associação Anjos do Céu; Centro de Defesa da Criança e do adolescente (Cedeca)
IGREJA
Paróquia Nossa Senhora das Graças
SAÚDE
Postos de Saúde: Maria Grasiela (Rua Edésio Monteiro, 1450)
292 NOSSOS BAIRROS | NOSSA FORTALEZA
MEIO AMBIENTE
Rios ou lagoas: Rio Cocó
EDUCAÇÃO
Escolas: Francisca Oriá Serpa II; Manoelito Guimarães Domingues; Arca Dos Sonhos; Casa Do João
SEGURANÇA
AIS: 3
TRANSPORTE PÚBLICO
Ônibus: Corujão/Messejana/Barroso/Pedras; Pedras I; Pedras II; Santa Fé; Luiz Gonzaga/Messejana; Parque Santa Maria/Centro Fashion; Sítio São João/Parque Santa Maria; Sítio São João/Centro; Cj Palmeiras/
Parque Santa Maria; Cj Maria Tomásia/Santa Filomena; Maria Tomásia/Luiz Gonzaga; Parque Betânia/ Messejana; Alameda das Palmeiras; Carlos Albuquerque; Itamaraty/Elizabeth II; Pedras/Br 116/Centro; Cidade Nobre/Messejana; Alto Alegre/Escritores/Messejana; Paupina; Planalto Coaçu/Messejana
Ciclovia
ÁREA EDIFICADA (M2)
Inscrições Residenciais: 261
Inscrições Comerciais: 176

Inscrições de Prestação de Serviços:1
Inscrições Industriais:1

Assentamentos precários:
Favela: Rua Jardim Botânico; Rua Brejo Santo; Mutirão; Santa Fé; Chico Mendes I; Chico Mendes III:
293 REGIONAL 9
Nome do Ancuri está relacionado a uma palmeira nativa
AURÉLIO ALVES
BARROSO
Além de fazer divisa com outros dois bairros da sua regional, Cajazeiras e Jangurussu, o Barroso está no limite territorial com a Messejana, da Regional 6, e o Passaré, na Regional 8.
Além das várias praças, tem uma Areninha Campo do Barroso. Já na atividade socioeconômica tem duas feiras livres, a Feira do João Paulo II e a Feira do Barroso II.
Na questão da sustentabilidade, o território tem dois ecopontos, um no Conjunto Jardim Glória e outro no Conjunto João Paulo II.

DADOS GERAIS
Localização
Regional: SR 9
Território: 31
Bairros limítrofes: Jangurussu, Messejana, Cajazeiras, Boa Vista, Passaré
População estimada: 29.847

População Feminina: 15.488
População Masculina: 14.359
Densidade (hab/km²): 8.671,41
Área (km²): 3,44
Perímetro (km): 9.006,02
Avenidas principais: Avenida Capitão Waldemar Paula Lima, Avenida Jornalista Tomaz Coelho, Praça Remo, Rodovia BR, Rua 1 (Cj Antônio Correia), Rua 1 (Cj Jardim Glória), Rua 1 (Cj João Paulo II), Rua 1 (Res Nova Assunção), Rua 10 (Cj João Paulo II), Rua 10 (Lot Fortaleza Sul)
Feiras livres: Feira do João Paulo II (Praça Central); Feira do Barroso II (Rua Eldorado S/N - Barroso)
Ecopontos: Jardim Glória; João Paulo II
IDH: 0,187
294 NOSSOS BAIRROS | NOSSA FORTALEZA
Centro de Referência da Assistência Social do Barroso. Bairro tem limite territorial com a Messejana e o Passaré
FERNANDA BARROS
ESPORTES
Areninha Campo do Barroso
ATIVIDADE SOCIAL
Associação de Caridade Samaritano de Jesus; Associação Dos Moradores Do Conj. João Paulo II; Associação Comunitária do Conjunto Sítio Estrela; Clube Social do IBGE; CRAS Barroso/João Paulo II; CEJACCentro Espírita,Jesus,Amor e Caridade;
IGREJAS
Igreja Nossa Senhora de Fátima; Igreja Nossa Senhora da Abadia
SAÚDE
Postos de Saúde: Waldo Pessoa; Pompeu Vasconcelos
PRAÇAS
Praça Campo Lago Azul; Praça da Capela Violeta; Praça da Creche Regina De Fátima; Praça do Antônio Corrêia; Praça João Paulo II
EDUCAÇÃO
Escolas: Professora Maria Rozani Mendonça Nobre; Professora Olindina Carvalho De Morais; Otávio De Farias; Professora Maria Antonézia Meireles E Sá; Sinó Pinheiro; Sinó Pinheiro Unid II; Núcleo De Vida; São Judas Tadeu
CULTURA
Bibliotecas: Biblioteca Viva - Nesta biblioteca comunitária, constantemente são mobilizados eventos relacionados à leitura. Durante a pandemia, o espaço criou, em parceria com agentes de outras bibliotecas, a publicação “A Biblioteca de Dia”, que já está na sua sexta edição.
SEGURANÇA
AIS: 3
TRANSPORTE PÚBLICO
Ciclofaixa
Ciclovia
Ônibus: Antônio Bezerra/Lagoa/Unifor; Corujão/Av. Paranjana I; Corujão/Av. Paranjana II; Parangaba/Oliveira Paiva/Papicu; Siqueira/Oliveira Paiva/Washington Soares; Siqueira/Papicu/Washington Soares; Grande Circular I; Grande Circular II; Corujão/Grande Circular I; Corujão/ Grande Circular II; Antônio Bezerra/Messejana/Perimetral; Siqueira/Messejana/Perimetral; Messejana/Parangaba; Barroso/Jardim Viôleta/Centro; Corujão/Messejana/Barroso/Pedras; Cj Palmeiras/Perimetral; Carlos Albuquerque; Cj Tamandaré; Cj Maria Tomásia/Santa Filomena; Pedras/Br 116/Centro; Barroso Circular; Cj João Paulo II; Cj São Cristovão; Cidade Nobre/Messejana; Messejana/Centro/Br Nova/Expresso;Passaré/Messejana; Cj Palmeiras/ Centro; Corujão/Messejana/Centro; Maria Tomásia/Luiz Gonzaga; Parque Betânia/Messejana; Alameda das Palmeiras; Cidade Jardim/Messejana; Cj Palmeiras/Papicu
ÁREA EDIFICADA (M2)
Inscrições Residenciais: 3.566
Inscrições Comerciais: 746

Inscrições de Prestação de Serviços: 30
Inscrições Industriais: 10
Assentamentos precários: Conjunto habitacional
Jangurussu (Conjunto João Paulo II); Conjunto Antônio Correia
Favela
João Paulo II; Matadouro; São Francisco; Santa Rita; Rua Máximo Barreto; Monte Verde/ Campo do Remo; Barroso; Comunidade Waldemar de Alcântara; Nossa Senhora de Fátima/ Santana II; Che Guevara; Rua Icaraçu; Rua do Pedestre; Comunidade 1º de Março; Pingo de Luz; Rua Jonas Bezerra; Santa Maria Gorete
Mutirão
Santana I
295 REGIONAL 9
CAJAZEIRAS
Cajazeiras é um bairro que conta com muitos condomínios e casas que se desenvolveram junto à BR-116 e ao Rio Cocó. Além do seu fácil acesso, abrange o Parque Urbano da Lagoa de Maria Vieira.
Dentre as referências do território, estão a sede da Polícia Rodoviária Federal; a vista do estádio Castelão; a igreja de São Diogo; a Praça Ubiratan Aguiar; e o Parque Urbano da Lagoa de Maria Vieira.
DADOS GERAIS
Localização
Regional: SR 9
Território: 31
Bairros limítrofes: Barroso, Messejana, Cajazeiras, Boa Vista, Passaré, Parque Iracema, Cidade dos Funcionários, Jardim das Oliveiras e Dias Macêdo
População estimada: 14.478
População Feminina: 7.657
População Masculina: 6.821
Densidade (hab/km²): 4.244,50
Área (km²): 3,41
Perímetro (km): 10.335,11
Avenidas principais: Avenida Deputado Paulino Rocha, Rodovia BR, Rua A (Cj Res Ubiratan Aguiar), Rua A (Lot Cajazeiras II), Rua Alfa Vile (Mutirão Cajazeiras), Rua Alziria Bento do Nascimento, Rua Andiroba. Rua Angelim, Rua Araucária, Rua Arueira
Feiras livres: Feira do Cajazeiras - Rua Ten. Tito Barros S/N - Cajazeiras
Ecopontos: Cajazeiras Rua Francisco José de Albuquerque Pereira, próximo ao número 414
IDH: 0,305
ATIVIDADE SOCIAL

Associação dos Moradores do Conjunto Ernesto Che Guevara; Canteiro Cajazeiras Abigail; A. A. Grupo Guadalupe - 27; Associação De Moradores Do Vila Verde; Sindicato dos Policiais Rodoviários Federais no Ceará - SINDPRF/CE;
IGREJAS
Paróquia São Diogo (Rua Maria Nogueira França, 5); Igreja Nossa Senhora de Guadalupe (R. Lucia Helena do Nascimento, 193); Santuário Mãe da Divina Providência (Rua Dra. Wanda Sidou, S/N)
PRAÇA
Praça Ubiratan Aguiar -(Rua Jacarandá X Rua Eucalipto)
MEIO AMBIENTE
Rios ou lagoas: Rio Cocó
Parques:
Parque Urbano da Lagoa de Maria Vieira - Com uma área de 50.298,20 m², o Parque Urbano da Lagoa de Maria Vieira é conhecido como a “joia da coroa” do bairro Cajazeiras. Ao seu redor é possível apreciar gansos que embelezam o cenário. A Lagoa integra a Sub-Bacia B-2 do Rio Cocó e é alimentada por um riacho que flui para este reservatório por meio do canal de drenagem sob a Av. Paulino Rocha.
Possui um espelho d’água com profundidade média de um metro e um volume de 29,92m³.
EDUCAÇÃO
Escolas:
José Sobreira De Amorim (Rua Tenente Tito Barros, 330)
Nossa Senhora De Guadalupe (Rua Lúcia Helena Do Nascimento, 207)
296 NOSSOS BAIRROS | NOSSA FORTALEZA
SEGURANÇA
Delegacias:
Superintendência da Polícia Rodoviária Federal no Ceará
Superintendência Regional do DNIT no Estado do Ceará
AIS: 7
TRANSPORTE PÚBLICO
Ciclovia
Ônibus: Jardim das Oliveiras/Centro; Antônio Bezerra/ Lagoa/Unifor; Antônio Bezerra/Messejana; Corujão/Av.
Paranjana I; Corujão/Av. Paranjana II; Parangaba/Oliveira
Paiva/Papicu;Siqueira/Oliveira Paiva/Washington Soares; Messejana/Frei Cirilo/Expresso/Centro; Cidade Func/ Sítio São José/Centro; Cidade Func/Cj Alvorada/Centro; Cidade Func/Cofeco/Lago Jacarey/Centro; Cj Tancredo Neves/Centro; Barroso/Jardim Viôleta/Centro; Corujão/ Messejana/Barroso/Pedras; Pedras/Br 116/Centro; Cidade Func/Sítio São José/CMR/Centro; Messejana/Centro/ Br Nova/Expresso; Cj Palmeiras/Centro; Corujão/Mes-
sejana/Centro; Sítio São João/Centro; Messejana/Rodoviária; Parque Santa Maria/Centro Fashion; Messejana/ Papicu/Cj Tancredo Neves
ÁREA EDIFICADA (M2)
Inscrições Residenciais: 3.794

Inscrições Comerciais: 733

Inscrições de Prestação de Serviços: 19
Inscrições Industriais: 3
Assentamentos precários:
Conjunto habitacional: Suzuki Reassentamento Zeza/Tijolo (Titio Barros)
Favela: Av. Paulino Rocha; Nossa Senhora de Fátima/ Santana II; Che Guevara; Santa Maria; S. D. Cajazeiras; Santa Maria Gorete; Rua Tenete Tito de Barros II; Rua Tenete Tito de Barros I; Via São José de Nazaré; Tamarineiras
297 REGIONAL 9
JULIO CAESAR
O espelho d’água do Parque Urbano da Lagoa de Maria Vieira
CONJUNTO PALMEIRAS
O Conjunto Palmeiras surgiu em 1973 devido a uma transferência de 1.500 famílias da zona costeira da Capital para construção da Avenida Leste-Oeste, que ligava a área industrial ao Mucuripe.

Parte delas se mudou para um distrito do Jangurussu, que posteriormente recebeu o nome de Conjunto Palmeiras. O bairro só foi oficialmente reconhecido em 2007, antes era associado ao Jangurussu.
Os habitantes iniciais se mobilizaram para driblar a falta de saneamento e condições mínimas de saúde. Pelas dificuldades econômicas, resolveram criar a própria moeda local.
DADOS GERAIS
Localização
Regional: SR 9
Território: 32

Bairros limítrofes: Jangurussu, Parque Santa Maria, Ancuri, Pedras, Prefeito José Walter
População estimada: 36.599
População Feminina: 18.792
População Masculina: 17.807
Densidade (hab/km²): 6.659,21
Área (km²): 5,50
Perímetro (km): 11.444,69
Avenidas principais: Avenida Central, Avenida Deputado Castelo de Castro, Rua Água da Prata, Rua Alcides Gerardi, Rua Álvaro Dias, Rua Alves Maia, Rua Amadeu Bueno, Rua Ângela Diniz, Rua Antônio Ivan, Rua Avaré
Feiras livres: Feira do Conjunto Palmeiras (Rua Canguru)
IDH: 0,119
298 NOSSOS BAIRROS | NOSSA FORTALEZA
O Banco Palmas é o primeiro banco comunitário social do Brasil
AURÉLIO ALVES
ESPORTES
Areninha Beira Rio - Conj. Palmeiras
ATIVIDADE SOCIAL
Banco Palmas; CNCP Centro de Nutrição do Conjunto Palmeiras; PrograManas; Bodegão da solidariedade; Associação Emancipadas; PalmasLab
BANCO PALMAS
Com a moeda “Palmas”, nasceu, em 1998, o primeiro banco popular comunitário do Brasil. A iniciativa foi de Joaquim Melo e surgiu para democratizar o acesso a serviços financeiros e bancários da população da periferia. Tem ampla adesão, participação e controle social. A iniciativa é baseada na economia popular e solidária.
IGREJA
Igreja São Francisco de Assis (R. Modesta, 45-99);
SAÚDE
Postos de Saúde: Evandro Ayres de Moura Av. Castelo de Castro, s/n Pedro Sampaio (EM REFORMA) Rua
Iracema 1516
PRAÇAS
Praça do Conjunto Palmeiras; Área Verde Resid. José Euclides - Conjunto Palmeiras
MEIO AMBIENTE
Rios ou lagoas: Barragem do Rio Cocó
EDUCAÇÃO
Escolas: César Cals De Oliveira Neto; João Germano
Da Ponte Neto; Maria Helenilce Cavalcante Leite Martins; Marieta Cals; Professora Bernadete Oriá De Oliveira; Professora Maria Do Socorro Ferreira Virino; Professora Ana Maria Medeiros Da Fonseca
CULTURA
Bibliotecas: Casa do Sanshi;
Cinemas: CineFreud
Centros culturais: Convoque seu Buda; Circo Mirtes; Seven Brothers Circos; Circo Escola Conjunto Palmeiras; Espaço de Reunião para saber o que tá Conteseno; Cia Bate Palmas; PalmArt
SEGURANÇA
AIS: 3
TRANSPORTE PÚBLICO
Ciclovia
Ônibus: Corujão/Messejana/Barroso/Pedras; Cj Palmeiras/Perimetral; Cj Tamandaré; Cj Palmeiras/Parque Santa Maria; Cj São Cristovão; Cj Palmeiras/Centro; Cj Palmeiras/Papicu
ÁREA EDIFICADA (M2)
Inscrições Residenciais: 1.447
Inscrições Comerciais: 178

Inscrições de Prestação de Serviços: 8
Inscrições Industriais: 5
Assentamentos precários: Conjunto habitacional
Conjunto Palmeira; São Cristóvão
Favela: Rua do Coqueiro; Palmeiras II; Do Circo; Real; Comunidade São Francisco da Ribeirinha do Cocó; Rua Cantinho Verde; Rua Catolé
Loteamento Irregular: Nova Fortaleza
Mutirão: Jacatá
299 REGIONAL 9
JANGURUSSU
O bairro Jangurussu, localizado na Região Sul da Capital cearense, surgiu no início dos anos 1990 por meio de políticas públicas federais em relação à habitação pelo País, incluindo o Ceará.
Aos poucos, foi atraindo cada vez mais habitantes e, atualmente, possui uma população estimada de mais de 50 mil pessoas. O território é conhecido pelo amplo número de conjuntos habitacionais, favelas e mutirões.
Com mais de 8 km², é o maior em espaço da Regional 9. São mais de dez praças públicas e amplo leque de opções comerciais, com 1.444 registros; além de mais de 130 serviços e oitos indústrias.
Recentemente, o bairro recebeu três ecopontos espalhados pelo território visando à sustentabilidade local. Já a unidade Cuca no bairro busca a transformação social do local por meio da cultura, do lazer e do esporte.
DADOS GERAIS
Localização
Regional: SR 9
Território: 32
Bairros limítrofes: Barroso, Messejana, Parque Santa Maria, Ancuri, Conjunto Palmeiras, Prefeito José Walter e Passaré
População estimada: 50.479
População Feminina: 26.262
População Masculina: 24.217
Densidade (hab/km²): 6.301,21
Área (km²): 8,01
Perímetro (km): 14.114,99
Avenidas principais: Avenida A, Avenida Aldemir Martins, Avenida B, Avenida Bulevar I, Avenida Bulevar II, Avenida Bulevar III, Avenida C, Avenida Chiquinha Gonzaga, Avenida Cora Coralina, Avenida de Contorno Sul
Feiras livres: Feira do Sítio São João (Av. Valparaíso); Feira do São Cristovão (Av. Castelo de Castro)
Ecopontos: Jangurussu (Avenida Castelo de Castro, esquina com Rua Gergelim); Sítio São João (Rua Verde 42, em frente ao número 287); Santa Filomena( Rua Paraisópolis, esquina com a Rua Domingos Alves Ribeiro)
IDH: 0,172
ATIVIDADE SOCIAL

Instituto Social de Amparo à Vida; Associação De Moradores União Popular; Associação Ebenézer Vida; Casa da Caridade Dr Adolph Fritz; Oca de Saúde Comunitária do São Cristóvão; Associação Vidas; CISR – Centro de Inclusão Social Renascer; Associação Comunitária Sítio São João;
IGREJAS
Igreja de Nossa Sra. de Fátima (Av. Gov. Leonel Brizola, 232-330; Igreja de Santo Antônio (R. São João do Jangurussu, 699-889)
SAÚDE
Postos de Saúde: Osmar Viana (Av. Chiquinha Gonzaga, s/n Jangurussu (Maria Tomásia); Sítio São João (Rua Verde Cinco, 71); Melo Jaborandi (Rua 315, 80) ; Marcus Aurélio Rabelo (Rua Iracema, 1100)
Policlínicas: Policlínica João Pompeu Lopes Randal (Rua Estrada do Itaperi, 146)
UPAs: UPA Jangurussu (Av. Contorno Sul, SN, com Av Castelo de Castro)
PRAÇAS
Praça Cuca Jangurussu (Av. Castelo De Castro X Av. Governador Leonel Brizola); Praça da Igreja Santa Clara (Rua Juá X Rua 5 Loteamento Nova Fortaleza); Praça dos Remanescentes (Travessa Luís X Rua Prosperidade); Praça Jangurussu (Travessa Jair Rodrigues X Rua Santa Luzia); Praça Lagoa São Cristovão (Rua
300 NOSSOS BAIRROS | NOSSA FORTALEZA


301 REGIONAL 9
AURÉLIO ALVES
Cuca Jangurussu, na Av. Governador Leonel Brizola, é importante equipamento cultural do bairro
José Pinto X Rua Lagoa Verde); Praça Parque Betânia (Rua Pedro Camelo X Rua Joselita Parente); Praça Res. Aldemir Martins (Rua G X Rua B); Praça Res. Euclides F. Gomes (Av. Cora Coralina X Av. B); Praça Sítio São João (Rua Verde 41 X Rua Verde 5); Praça Tamandaré (Rua Gergelim X Rua Jurema); Praça Jangurussu (Rua Nilo Firmeza X Rua Vicente Rosal Ferreira Leite)
MEIO AMBIENTE
Rios ou lagoas: Açude Jangurussu
EDUCAÇÃO
Escolas: Jornalista José Blanchard Girão Da Silva (Trav. Missionário Oliveira, 301); Lions Clube Fortaleza Fátima (Tv. Lions Clube, 141); Maria De Jesus Oriá Alencar (Rua 43, S/n (Conjunto São João); Martha Dos Martins Coelho Guilherme (Rua 313, 243 (Conjunto São Cristóvão); Professor Francisco De Melo Jaborandi (Av. Governador Leonel Brizola, 198); Taís Maria Bezerra Nogueira (Av. Governador Leonel Brizola, 710); Vereador José Barros De Alencar (Rua B, 48); EMTI Antônio Girão Barroso (Rua Trinta e Sete,1); Professor Asthon Guilherme Da Silva (Rua B, S/n) ; Humberto Teixeira (Rua Francisco Costa, 162); José De Ribamar Moraes (Rua Catolé, S/n (Conjunto Sítio São João); Manoel Pinheiro Dos Santos (Rua Major Ladislau Lourenço, S/n); Professor Francisco De Melo Jaborandi (Av. Governador Leonel Brizola, 198a); Professor Lauro De Oliveira Lima (Rua 313, S/n); Cuidando e Ensinando (Rua José Dos Reis Carvalho, 64 (Res. Aldemir Martins); Fazendo A Diferença (Rua Mutamba, 175b)
CULTURA
Bibliotecas: Biblioteca da Filó - biblioteca comunitária;

Centros culturais: Centro Comunitário de Arte e Cultura Sítio São João; Centro Urbano de Cultura, Arte, Ciência e Esporte (Cuca) - Jangurussu
CUCAS
Cuca Jangurussu (Av. Gov. Leonel Brizola, s/n)
Centro Urbano de Cultura, Arte, Ciência e Esporte (Cuca) Jangurussu - Conjunto de complexos culturais na Av. Gov. Leonel Brizola, s/n. O espaço recebe jovens da comunidade e adjacências para cursarem atividades de formação em diferentes áreas.
O atendimento ocorre prioritariamente para jovens entre os 15 e 29 anos. A Rede Cuca também promove no território movimentos culturais por meio da realização de eventos, festivais, mostras, exposições e programação de shows, espetáculos e cinema.
SEGURANÇA
Célula De Proteção Comunitária
AIS: 3
TRANSPORTE PÚBLICO
Ciclofaixa
Ciclovia
Ônibus: Siqueira/Papicu/Washington Soares; Grande Circular I; Grande Circular II; Corujão/Grande Circular I; Corujão/Grande Circular II; Antônio Bezerra/Messejana/Perimetral; Siqueira/Messejana/Perimetral; Messejana/Parangaba; Barroso/Jardim Viôleta/Centro;Corujão/Messejana/Barroso/Pedras; Pedras I; Pedras II; Sítio São João/Parque Santa Maria; Cj Palmeiras/Perimetral; Carlos Albuquerque; Cj Tamandaré 4; Cj Palmeiras/Parque Santa Maria; Cj Maria Tomásia/ Santa Filomena; Pedras/Br; 116/Centro; Barroso Circular; Cj João Paulo II; Cj São Cristovão; Luiz Gonzaga/Messejana; Cidade Nobre/Messejana; Messejana/ Centro/Br Nova/Expresso; Passaré/Messejana; Cj Palmeiras/Centro; Corujão/Messejana/Centro; Maria Tomásia/Luiz Gonzaga; Parque Betânia/Messejana; Sítio São João/Centro; Alameda das Palmeiras; Cidade Jardim/Messejana; Cj Palmeiras/Papicu
ÁREA EDIFICADA (M2)
Inscrições Residenciais: 16.833
Inscrições Comerciais: 1.444
302 NOSSOS BAIRROS | NOSSA FORTALEZA
Inscrições de Prestação de Serviços: 138
Inscrições Industriais: 8
Assentamentos precários: -
Conjunto habitacional:

Conjunto Palmeira; São Cristóvão; Conjunto Habitacional Maria Tomásia; Patativa do Assaré

Favela: Real; Comunidade São Francisco da Ribeirinha do Cocó; Terra Nossa; Rua Catolé; Travessa Bicel; Comunidade São Gerônimo; Rua Irmãos Olímpio; Rua Nunes Feijó; Rua Rio Jorsão; Novo Amanhecer; Travessa Jovin Veríssimo; Estrada do Ancuri; Santa Rita; Campo Estrela; Nova Fortaleza
Mutirão: Jacatá; Sítio São Jorge I; Parque Santa Filomena/; Jangurussu I; Jangurussu III; Pq. Portela; Jangurussu II; Barroso/Varginha
303 REGIONAL 9
AURÉLIO ALVES
Vista aérea do Jangurussu
PARQUE SANTA MARIA
O Parque Santa Maria está localizado na região Sul de Fortaleza. Desde a aprovação da Lei 0278/2019, que regularizou a mudança dos bairros da Capital para 12 regionais, ele passou a pertencer à Regional 9.
Ao seu lado, pertencente à mesma organização municipal, estão os bairros Barroso, Cajazeiras, Conjunto Palmeiras e Jangurussu e, ainda, Ancuri e Pedras.
De acordo com o último Censo do IBGE, de 2010, o perímetro do Parque Santa Maria foi considerado como sendo do bairro Ancuri, por isso a população estimada e o IDH ainda aparecem zerados.

Mesmo a população sendo apresentada como zero, ela representa parte da população do Ancuri de 20.070 habitantes.
DADOS GERAIS
Localização
Regional: SR 9
Território: 33
Bairros limítrofes: Messejana, Jangurussu, Ancuri, Conjunto Palmeiras, Paupina

304 NOSSOS BAIRROS | NOSSA FORTALEZA
AURÉLIO ALVES
Igreja Nossa Senhora das Graças fica na Rua Maria Quintino, 650
População estimada: -
População Feminina: -
População Masculina: -
Densidade (hab/km²): -
Área (km²): 1,97
Perímetro (km): 6.116,33

Avenidas principais: Avenida Dionísio Leonel Alencar, Estrada do Ancuri, Rodovia BR-116, Rua 2, Rua 5, Rua Alves Santana, Rua Antonia Barbosa de Lima, Rua Augusta Benevides, Rua Benedito Rosas, Rua Capitão Herminio
Feiras livres: Feira Santa Maria
IDH: 0,000
ESPORTES
Areninha Santa Maria
ATIVIDADE SOCIAL
Instituto Nacional de Desenvolvimento Social e Qualificação Profissional (Idesq)
IGREJA
Igreja Nossa Senhora das Graças - Venerada pela igreja católica, Nossa Senhora das Graças é uma invocação especial da Santíssima Virgem Maria, também invocada com a mesma intenção sob o nome de Nossa Senhora da Medalha Milagrosa e Nossa Senhora Medianeira de Todas as Graças.
Segundo relatos históricos, suas aparições marianas ocorreram em La Salette, em Lourdes, em Fátima e em Campinas. No bairro Parque Santa Maria, a Paróquia Nossa Senhora das Graças fica localizada na Rua Maria Quintino, 650.
SAÚDE
Postos de Saúde: Fausto Freire (Av. Isabel Bezerra, 416)
EDUCAÇÃO
Escolas: José Moreira Leitão (Rua Honorino Maia, 467); Bárbara De Alencar (Rua Capitão Porfírio, 544); Demócrito Rocha (Rua Padre Pedro De Alencar, 2012)
SEGURANÇA
AIS: 3
TRANSPORTE PÚBLICO
Ciclofaixa
Ônibus: Corujão/Messejana/Barroso/Pedras; Pedras I; Pedras II; Sítio São João/Parque Santa Maria; Itamaraty/Elizabeth II; Carlos Albuquerque 60; Cj Palmeiras/ Parque Santa Maria; Cj Maria Tomásia/Santa Filomena; Pedras/Br 116/Centro; Luiz Gonzaga/Messejana; Santa Fé; Maria Tomásia/Luiz Gonzaga; Parque Betânia/Messejana; Sítio São João/Centro; Alameda das Palmeiras; Parque Santa Maria/Centro Fashion
ÁREA EDIFICADA (M2)
Inscrições Residenciais: 1.963
Inscrições Comerciais: 283
Inscrições de Prestação de Serviços: 6
Inscrições Industriais:
Assentamentos precários:
Conjunto habitacional
Rua Honório Maia
Favela: Rua Jurandir Leonel Alencar (Brejo Santo); Vila Nova; Rua Jocélio Monteiro; Rua Brejo Santo; Rua Willys Saraiva; Rua benedito Rosa; Cidade de Deus; Travessa Rio Jordão; Santa Maria; Rua Pedro de Souza; Travessa Mário Quintini; SD; Estrada do Ancuri
305 REGIONAL 9
PEDRAS
Em 2017, um acordo entre os então prefeitos de Fortaleza e de Itaitinga, Roberto Cláudio e Abel Júnior, definiu que o bairro Pedras ficaria pertencendo à Capital cearense.
Hoje, está inserido na Regional 9 ao lado do Cajazeiras, Barroso, Jangurussu, Conjunto Palmeiras, Parque Santa Maria e Ancuri.
Antes mesmo da alteração, o território contava com escolas, unidade de saúde, rotas de ônibus e praças urbanizadas pela Prefeitura de Fortaleza.

Atualmente, tem o maior equilíbrio entre a população feminina e masculina da Capital cearense.
DADOS GERAIS
Localização
Regional: SR 9
Território: 33

Bairros limítrofes: Ancuri, Paupina
População estimada: 1.342
População Feminina: 672
População Masculina: 670
Densidade (hab/km²): 188,30
Área (km²): 7,13
Perímetro (km): 11.108,30
Avenidas principais: Avenida Dionísio Leonel Alencar; Avenida Palmeira dos Índios; Avenida Traíra; Rodovia Anel Viário; Rodovia BR; Rua 1 (Lot Bairro Novo); Rua 11 (Lot Bairro Novo); Rua 12 (Lot Bairro Novo); Rua 13 (Lot Bairro Novo); Rua 14 (Lot Bairro Novo)
IDH: 0,264
306 NOSSOS BAIRROS | NOSSA FORTALEZA
AURÉLIO ALVES
Campo da Areninha Pedras tem 8.418,78 m²
ESPORTES
Areninha Haroldo Abreu Serpa - Inaugurada em novembro de 2021, tem um campo com 8.418,78 m² de grama sintética. Além disso, oferece para a comunidade três arquibancadas, uma quadra poliesportiva, dois vestiários, paisagismo, jardins, bicicletário e caramanchão.
O nome da Areninha é uma homenagem a Haroldo Abreu Serpa, que nasceu no bairro Pedras, em 1969, e morreu em fevereiro de 2021 vítima de complicações da Covid-19. Haroldo era um fervoroso torcedor do Fortaleza e reconhecido desportista e incentivador do esporte na comunidade.
A unidade conta também com um Núcleo do Atleta Cidadão, iniciativa que atende, em toda Fortaleza, cerca de 10.600 jovens, de 8 a 29 anos, em 16 modalidades esportivas.

ATIVIDADE SOCIAL
Associação esporte e vida; CT PFLA JUNIOR’S;

IGREJAS
Paróquia Sagrado Coração de Jesus e Santa Luzia (Rua José Nogueira, 120); Igreja de São Cristóvão (BR-116, 343)
TEMPLO RELIGIOSO
Abassá de Katu Izô; Cruzeiro de Pedras Zé Pelintra das Almas
SAÚDE
Postos de Saúde: Dr. Acrísio Eufrasino de Pinho (Cruzamento das ruas 12 e Palmeiras dos índios)
José Barros de Alencar (R. José Nogueira, 180)
PRAÇAS
Praça Quadra Do Alameda; Praça Santa Luzia; Pracinha da Cultura
EDUCAÇÃO
Escolas: Francisca Oriá Serpa; Tristão De Alencar; ) Professor José Teodoro Soares; Professora Luiza De Teodoro Vieira
SEGURANÇA
AIS: 3
TRANSPORTE PÚBLICO
Ciclovia
Ônibus: Corujão/Messejana/Barroso/Pedras; Pedras I; Pedras II; Itamaraty/Elizabeth II; Carlos Albuquerque; Pedras/Br 116/Centro; Santa Fé; Alameda das Palmeiras
ÁREA EDIFICADA (M2)
Inscrições Residenciais: 5.655
Inscrições Comerciais: 374
Inscrições de Prestação de Serviços: 3
Inscrições Industriail: 0
Assentamentos precários: -
307 REGIONAL 9
REGIONAL 10























Em 11 bairros, a Regional 10 disponibiliza serviços de saúde, comércios, praças públicas e equipamentos de lazer como Areninhas. Além de uma potência do meio ambiente, o Parque Urbano da Lagoa do Mondubim, com cerca de 257 mil m² e a lagoa de mais de 280 mil m³











 Lagoa da Maraponga fica dentro dos limites do bairo de mesmo nome
Lagoa da Maraponga fica dentro dos limites do bairo de mesmo nome










































GUIA REGIONAL 10
BAIRROS
Aracapé



Canindezinho
Conjunto Esperança
Jardim Cearense
Manuel Sátiro
Maraponga
Mondubim
Novo Mondubim
Parque Santa Rosa
Parque São José
Presidente Vargas
SECRETARIA REGIONAL 10
Avenida Augusto dos Anjos, 2466 - Bonsucesso
Fortaleza - CEP: 60.542-164
Telefone: (85) 3433.2925
Secretário: Leonardo Freire

mAntra Brasil – Design de Interiores nos anos 2015 e 2016. Entre os anos de 2008 a 2018, na Capital cearense, foi empresário em iluminação arquitetônica. Desde 2018 dedica-se a novos projetos na área da Arquitetura e Urbanismo.
CONTATOS IMPORTANTES RECEPÇÃO
Telefones: (85) 3433 2915/3433 2925
E-mail: sr10@sr10.fortaleza.ce.gov.br
ASSESSORIA DO GABINETE
E-mails: carine.peixoto@sr10.fortaleza.ce.gov.br / francisco.oliveira@sr10.fortaleza.ce.gov.br / cleiton. silva@sr10.fortaleza.ce.gov.br / francisco.silva@sr10. fortaleza.ce.gov.br
ACOLHIMENTO
Telefone: (85) 3433 2926
E-mail: acolhimento@sr10.fortaleza.ce.gov.br
OUVIDORIA
Telefones: 156/ (85) 9 9430 2946
E-mail: ouvidoria@sr5.fortaleza.ce.gov.br
AGEFIS


Telefone: (85) 9 8439 2009
E-mail: ouvidoria.agefis@agefis.fortaleza.ce.gov.br
PROCON
Telefones: (85) 3105 1144/9 8970 9101
CADASTRO ÚNICO
E-mail: leonardo.freire@sr10.fortaleza.ce.gov.br
Fuzileiro naval da reserva, após experiência acadêmica e profissional nos Estados Unidos e no Canadá, graduou-se em Arquitetura e Urbanismo. Pós-Graduando em Gestão Pública, é especialista em iluminação, tendo sido agraciado pelo Prêmio
Telefone: (85) 9 8970 3939
SINE
Telefone (85) 3105.3712
E-mails: vagasine@sde.fortaleza.ce.gov.br / sinemunicipalfor@sde.fortaleza.ce.gov.br (seguro desemprego)

310 NOSSOS BAIRROS | NOSSA FORTALEZA
OUVIDORIA







Telefone: 9 9430 2946
CONSERVAÇÃO E SERVIÇOS PÚBLICOS
Telefones: 3487 9933

COORDENAÇÃO DE INFRAESTRUTURA


E-mails: beatriz.carneiro@sr10.fortaleza.ce.gov.br / luciano.carvalho@sr10.fortaleza.ce.gov.br
AGÊNCIA DE CÉLULA DE LICENCIAMENTO







Telefone: 9 8439 8198




E-mail: alex.trigueiro@bol.com.br

FCO FONTENELE 311 REGIONAL 10
Lagoa da Maraponga deu origem ao Parque Ecológico da Maraponga
O bairro Aracapé antes fazia parte do Mondubim. Com a alteração nas divisões dos bairros e aumento das Regionais, o Aracapé separou-se do Mondubim.

Alguns equipamentos do bairro ainda estão com endereços e limites do bairro Mondubim, como, por exemplo, a Areninha do Aracapé, que fica na Rua Miguel de Aragão (Aracapé), mas é direcionada ao Mondubim.
A Estação de Metrô do Aracapé, apesar do nome, é localizada no bairro Parque Santa Rosa.
DADOS GERAIS
Localização
Regional: SR 10
Território: 34


Bairros limítrofes: Presidente Vargas, Parque Santa Rosa, Conjunto Esperança, Mondubim e Planalto Ayrton Senna
População estimada: *



População Feminina: *
População Masculina: *
Densidade (hab/km²): *
Área (km²): 2,18
Perímetro (km): 6.110,54
Avenidas principais: Edson Magalhães; Dr. Mendel Steinbruch; Godofredo Maciel; Maria Gomes de Sá
Feira: Aracapé (Av. Miguel Aragão, quadra 04)
Ecopontos: Aracapé (Rua Miguel de Aragão, esquina com Rua Nossa Senhora Aparecida)
* O Aracapé foi considerado bairro após o Censo de 2010, antes disso essa região fazia parte do bairro Mondubim. Por isso, não se tem dados concretos sobre a população, sendo considerada como parte dos habitantes do Mondubim de 76.044 pessoas.
SAÚDE
Postos de Saúde: João Elísio Holanda (Rua Juvêncio Sales, s/n)
EDUCAÇÃO
Escolas: Centros de Educação Infantil João Hildo de Carvalho Furtado (Av. C, S/N - Conjunto Aracapé); João Hildo de Carvalho Furtado Unid II (Rua Poliana, S/N); Escola Municipal João Hildo de Carvalho Furtado (Rua Juvêncio Sales, S/N); Creches Parceiras Pequenos Brilhantes (Rua Otávio Lima, 90); Pequenos Heróis (Rua Dr. Procópio, 205)
Centro de Educação Infantil Maria Félix Rodrigues - Foi inaugurado em 2022 e possui atendimento para crianças do berçário ao Infantil 3, beneficiando cerca de 188 crianças, de 6 meses a 3 anos de idade.
Além do CEI do Aracapé, Fortaleza conta com outros 18 equipamentos espalhados na Cidade: Planalto Ayrton Senna, Bom Jardim (Residencial Miguel Arraes), São Bento, Edson Queiroz, José Walter, Papicu, Itaperi, Vicente Pinzón, Sapiranga, Messejana, Barra do Ceará, Rodolfo Teófilo e Luciano Cavalcante.
A infraestrutura do CEI é composta de berçário, sala de inovação e tecnologias, salas de aula, banheiros com acessibilidade, cozinha, refeitório, despensa, lavanderia com depósito para material de limpeza, fraldário, lactário, secretaria, coordenação e sala de professores. O projeto contempla, ainda, área de lazer com playground e solarium.
SEGURANÇA
AIS: 9
TRANSPORTE PÚBLICO
Ônibus: Aracapé/Parangaba I; Aracapé /Parangaba Ii; Aracapé/Conjunto Esperança/Siqueira
Metrô: Linha Sul
312 NOSSOS BAIRROS | NOSSA FORTALEZA
ARACAPÉ







THAIS MESQUITA 313 REGIONAL 10
Aracapé tem um Centro de Referência de Assistência Social (CRAS)
CANINDEZINHO
O bairro Canindezinho é mais um dos 121 bairros de Fortaleza. Localiza-se na Regional 10, território 34, na divisão territorial das regionais. Segundo o Censo de 2010, do Instituto Brasileiro de Geografia e Estatística (IBGE), o bairro possui 41.202 habitantes.

Em 2015, o bairro recebeu, totalmente reformado, o Centro de Referência de Assistência Social (Cras),


DADOS GERAIS
Localização
Regional: SR 10
Território: 34

Bairros limítrofes: Siqueira, Bom Jardim, Parque São José, Novo Mondubim, Conjunto Esperança, Parque Santa Rosa e Presidente Vargas
População estimada: 41.202


População Feminina: 21.075
População Masculina: 20.127
Densidade (hab/km²): 11.093,70
Área (km²): 3,71
Perímetro (km): 10.341,70
Avenidas principais: General Osório de Paiva; José
Tavares

Feira: Canindezinho
IDH: 0,136
AURÉLIO ALVES 314 NOSSOS BAIRROS | NOSSA FORTALEZA
Igreja Matriz São Francisco de Assis fica na Rua Pitangueiras, 102
SAÚDE
Postos de Saúde: Regina Maria da Silva Severino
UPA: UPA 24 horas do Canindezinho
MEIO AMBIENTE
Parques: Parque Arborizado do Jerusalém
Rios ou lagoas: Rio Maranguapinho
IGREJAS


Igreja Assembleia de Deus; Igreja Batista Shalom Jerusalém; Igreja Nossa Senhora da Imaculada Conceição; Capela Nossa Senhora das Graças; Comunidade Bíblica da Graça; Igreja de Santo Inácio de Loyola; Igreja Adventista do Sétimo Dia;
Igreja Matriz São Francisco de Assis - Área Pastoral São Francisco de Assis foi criada por decreto em 2004 e a Paróquia São Francisco de Assis, em 2012, na Rua Pitangueiras, 102.
ESPORTE
Areninha do Parque Jerusalém
ATIVIDADE SOCIAL

Centro de Defesa da Vida Herbert de Souza
PRAÇAS
Praça do Canindezinho; Praça Parque Jerusalém
EDUCAÇÃO
Escolas: Centros de Educação Infantil Florival Alves Seraine; Jornalista Demócrito Dummar; Zilda Arns Neumann; Escolas Municipais Florival Alves Seraine;Francisca de Abreu Lima; Jornalista Demócrito Dummar; Narciso Pessoa de Araújo; Padre Antônio Monteiro da Cruz; Creche Parceira Maria Pequena
CULTURA
Espaços culturais: Centro Cultural Canindezinho
SEGURANÇA
AIS: 9
TRANSPORTE PÚBLICO
Ônibus: Taquara; Conjunto Senador Carlos JereissatiRota 01; Conjunto Senador Carlos Jereissati - Rota 02; Jardim Jatobá / Siqueira I; Parque Jerusalém / Siqueira
Metrô: Linha Sul
ÁREA EDIFICADA (M²)
Inscrições Residenciais: 354.641,64


Inscrições Comerciais: 124.376,63
Inscrições de Prestação de Serviços: 2.248,81
Inscrições Industriais: 0,00
Assentamentos precários: Conjuntos Habitacionais Comunidade 8 de Dezembro; Conjunto Jardim Fluminense II; Conjunto Cônego de Castro; Favelas Comunidade dos Canos; Parque Santo Antônio; Parque Santa Rosa; Comunidade Jerusalém I e II; Av. Jardim Fluminense; Comunidade Jardim Fluminense; Planalto Canindezinho; Comunidade Parque São José; Loteamentos Irregulares Rua João Ramalho; Parque Alto Alegre

315 REGIONAL 10
CONJUNTO ESPERANÇA
O Conjunto Esperança é consideravelmente pequeno comparado a outros bairros de Fortaleza. Ele fica localizado na Regional 10 e ao seu redor estão os bairros Canindezinho, Novo Mondubim, Mondubim, Aracapé e Parque Santa Rosa.
Antes da mudança na divisão das regionais, o Conjunto Esperança integrava a Regional 5 da Capital. A nova territorialização administrativa de Fortaleza foi aprovada por lei em 2019, dividindo a Capital em 12 Regionais e 39 territórios administrativos. O processo de transição e reestruturação das regiões teve início em janeiro de 2021.
O Conjunto Esperança possui uma população de 16.405 habitantes, segundo o Censo 2010 do Instituto Brasileiro de Geografia e Estatística (IBGE), e tem alguns equipamentos de lazer para a população, como a Areninha. A Paróquia São Francisco Xavier também faz parte do bairro.
DADOS GERAIS
Localização
Regional: SR 10
Território: 34





Bairros limítrofes: Canindezinho, Novo Mondubim, Mondubim, Aracapé e Parque Santa Rosa

População estimada: 16.405
População Feminina: 8.691
População Masculina: 7.714
Densidade (hab/km²): 16.774,03
Área (km²): 0,98
Perímetro (km): 4.349,55

AURÉLIO ALVES 316 NOSSOS BAIRROS | NOSSA FORTALEZA
Areninha do Conjunto Esperança também é conhecida como Campo do Polo de Lazer
Avenidas Principais: Contorno Norte; Contorno Oeste; Contorno sul; Avenida A; Avenida B; Avenida E; Avenida F
Ecopontos: Jardim Cearense (Rua Holanda, esquina com a Rua Cel. Jaime Rolemberg); Conjunto Esperança (R. Marielle Franco)
IDH: 0,288
ESPORTES

Areninha do Conjunto Esperança - A Areninha do Conjunto Esperança foi entregue à população em 2016. O local também é conhecido como Campo do Polo de Lazer e recebeu, à época, investimento de R$ 1,6 milhão para sua construção, segundo a Prefeitura de Fortaleza. Desde então, a população conta com uma área própria para a prática de esporte, lazer e convivência na Av. Penetração Oeste, 2-136) - fica localizada no encontro da Avenida Contorno Norte com a Avenida Penetração Oeste. Em seu entorno, há uma praça, quadra poliesportiva, bancos, lixeiras e iluminação própria para manter o ambiente aconchegante. Além de possuir duas quadras de areia para vôlei, futevôlei e futebol de areia, roda de capoeira, parquinho infantil e academia ao ar livre.
IGREJAS




Igreja de São Francisco Xavier (Av. Contorno Norte, 979); Igreja Evangélica Assembleia de Deus Canaã (R. Lucimar Fernandes, 82); Igreja Universal (Av. Contorno Norte, 1150); Igreja Batista Esperança (R. Cento e Sete, 221); A Igreja de Jesus Cristo dos Santos dos Últimos Dias; Igreja Cristã Gileade (R. Cento Quatorze, 321); Assembleia de Deus Esperança (Rua Raimunda Aristides, 885)
EDUCAÇÃO
Escolas: Centros de Educação Infantil Alaíde Augusto de Oliveira (Rua E, 187 - Conjunto Imperial); Padre Cícero Romão Batista (Rua 106, 377); Escolas Municipais Alaíde Augusto de Oliveira (Rua Setembrina, 525); Padre Cícero Romão Batista (Rua 114, 460)
CULTURA
Espaços culturais: Pólo de Lazer do Conjunto Esperança (Av. Contorno Norte, 981)
SEGURANÇA
Delegacias: Delegacia de Polícia Civil | 19º Distrito Policial (R. 101, 61)
AIS: 9
TRANSPORTE PÚBLICO
Ônibus: 379 Conjunto Esperança / Parangaba; 380 Aracapé / Conjunto Esperança / Siqueira
Metrô: Linha Sul
ÁREA EDIFICADA (M²)
Inscrições Residenciais: 283.421,16

Inscrições Comerciais: 51.411,80
Inscrições de Prestação de Serviços: 3.379,47
Inscrições Industriais: 0,00
Assentamentos precários: Favelas Parque Santa Rosa; Rua das Cajazeiras; Campos Belos; Rua Ari Lobo; Rua Magno; Comunidade Parque São José
317 REGIONAL 10
JARDIM CEARENSE
Dentre os 121 bairros de Fortaleza, está o Jardim Cearense, que fica localizado entre Maraponga, Dendê e Mondubim. O bairro possui uma área de preservação ambiental chamada Zona de Proteção Ambiental (ZPA) 1.

Uma das suas avenidas principais é a Avenida Godofredo Maciel, que também dá acesso a outros bairros. O Jardim Cearense é consideravelmente pequeno, mas possui diversos equipamentos, como escolas, restaurantes, farmácias, mercadinhos, salões de beleza e comércios em geral.
DADOS GERAIS

Localização
Regional: SR 10
Território: 35


Bairros limítrofes: Maraponga, Dendê e Mondubim
População estimada: 10.103
População Feminina: 5.332
População Masculina: 4.771
Densidade (hab/km²): 11.761,35
Área (km²): 0,86
Perímetro (km): 3.656,73
Avenidas principais: Godofredo Maciel
Feira: Jardim Iracema (Rua Arakém entre as Ruas
Astrogildo Fontoura e Florêncio de Alencar)
Ecopontos: Jardim Cearense (Rua Holanda, 1538Esquina com a Rua Cel. Jaime Rolemberg)
IDH: 0,00
ATIVIDADE SOCIAL



Associação Comunitária de Maraponga (R. Vidal de Negreiros, 359)
IGREJAS
Igreja de Jesus Cristo dos Santos dos Últimos Dias - Ala Maraponga (R. Maria Josefina Pessoa, 132); Ministério Canaã (Rua Benjamim Brasil, 654); Igreja Universal (Tv. Iracema, 105); Capela São Marcelino Champagnat (R. Dom Pero Fernandes, 363); Franciscanos Conventuais (R. Maria Josefina Pessoa, 220); Assembleia de Deus Bela Vista - Congregação Antenas (Rua Rubéns Monte, 285)
EDUCAÇÃO
Escolas: Centro de Educação Infantil João Estanislau Façanha (Rua Holanda, 870); Escola Municipal João Estanislau Façanha (Rua 11, S/N - Conjunto Campo Dos Ingleses); Creche Parceira Sonho de Criança (Rua Vidal De Negreiros, 359)
318 NOSSOS BAIRROS | NOSSA FORTALEZA
Ecoponto do Jardim Cearense está em funcionamento desde 2016
SEGURANÇA
AIS: 9
TRANSPORTE PÚBLICO
Ônibus: Pavuna; Pajuçara; Timbó; Conjunto Novo Maracanaú; Sítio Córrego/Parangaba; Cidade Jardim I/ Parangaba
Metrô: Linha Sul
ÁREA EDIFICADA (M²)
Inscrições Residenciais: 279.654,92

Inscrições Comerciais: 81.160,22

Inscrições de Prestação de Serviços: 2.969,23
Inscrições Industriais: 3.719,01
Assentamentos precários: Favelas Rua 10; Rua Leon Gradvohl; Virgínia Smith; Rua Emília Sá; Luxemburgo / Ocupação Junto Maraponga ou Barracal

ECOPONTO JARDIM CEARENSE



Os Ecopontos fazem parte de um programa da Prefeitura de Fortaleza criado em 2015, que tem por objetivo ampliar as possibilidades de coleta seletiva nos bairros, oferecendo benefícios como desconto na conta de energia elétrica.
A troca dos resíduos também gera créditos no Bilhete Único.
O Ecoponto do bairro Jardim Cearense já está em funcionamento desde 2016 e é uma boa opção para realização de descarte de material reciclável de forma correta. Além dos benefícios já citados, a população também contribui com o meio ambiente.
É possível reciclar nos ecopontos: pequenas proporções de entulho, restos de poda, móveis e estofados velhos, além de pneus, óleo de cozinha, papelão, plásticos, vidros, metais, celulares e aparelhos eletroeletrônicos.

THAIS MESQUITA 319 REGIONAL 10
MANUEL SÁTIRO
Manuel Sátiro foi um advogado e político que molda sua história juntamente com o crescimento e instalação do bairro Vila Manuel Sátiro, que leva seu nome. Sobre o nome, podemos ver grafados com a letra “u” (Manuel) ou com a letra “o” (Manoel), não há um padrão.
Em Fortaleza, Manuel adquiriu diversos lotes de terra, inclusive o sítio onde está localizado o bairro. A casa da família ainda existe nos dias de hoje e abriga a sede do clube Floresta Esporte Clube.

Há, também, uma paróquia bastante conhecida no bairro: Nossa Senhora das Graças. A capela dedicada à Santa começou a ser construída em 1953 e, em 1969, passou a fazer parte da Paróquia de Nossa Senhora do Perpétuo Socorro.
Em 2004, a capela Nossa Senhora das Graças foi elevada à condição de matriz da então paróquia criada, incluindo a Vila Manoel Sátiro e o Parque São José. Para além da igreja, em 2015 foi inaugurada no bairro a estação Manoel Sátiro, do metrô de Fortaleza.
DADOS GERAIS

Localização
Regional: SR 10
Território: 35


Bairros limítrofes:
População estimada: 37.952



População Feminina: 20.245
População Masculina: 17.707
Densidade (hab/km²): 26.502,79
Área (km²): 1,43
Sede do Floresta Esporte Clube
AURÉLIO ALVES 320 NOSSOS BAIRROS | NOSSA FORTALEZA
Perímetro (km): 5.772,91
Avenidas principais: Waldir Diogo
Feira: Vila Manoel Sátiro (Rua Uirapuru com Rua Cônego de Castro, S/N)
IDH: 0,292
IGREJAS

Igreja de Cristo no Novo Mondubim (R. Cel. Melquíades, 174); Igreja Cristã Maranata (R. Padre Rodolfo, 123); Assembleia de Deus Templo Central Novo Mondubim (R. Aurélio Bezerra, 237); Igreja Batista Hebrom (R. Mário Filho, 783); Igreja Casa da Bênção (R. Padre Rodolfo, 559); Igreja Nossa Senhora das Graças (R. Fernando Farias de Melo, 830); Igreja Assembléia De Deus Ministério Templo Central Congregação Manuel Sátiro (R. João Areas, 900)
SAÚDE
Postos de Saúde: Luciano Torres de Melo; Viviane Benevides
EDUCAÇÃO
Escolas Municipais Henriqueta Galeno; Maria Viviane Benevides Gouveia; Creche Parceira Projeto Joãozinho; Tia Augusta; Tia Mazé
SEGURANÇA
AIS: 9
TRANSPORTE PÚBLICO
Ônibus: Antônio Bezerra/Messejana/Perimetral; Siqueira/Vila Manoel Sátiro/Parangaba
Metrô: Linha Sul
ÁREA EDIFICADA (M²)
Inscrições Residenciais: 404.020,43
Inscrições Comerciais: 99.507,44
Inscrições de Prestação de Serviços: 2.407,88
Inscrições Industriais: 3.136,40
Assentamentos precários: Favelas Nossa Senhora Aparecida; Santa Liduína; Rua Frankfort; Loteamento Irregular Rua João Ramalho
FLORESTA ESPORTE CLUBE





Foi fundado em 1954 com o nome Ás de Ouro, por Felipe Santiago, esposo de Noelzinha Sátiro Santiago, filha de Manuel Sátiro. Desde sua fundação, tornou-se uma equipe tradicional no bairro e começou a se profissionalizar. Em 2022, de forma inédita, o clube disputou a Copa do Nordeste, após classificação nas eliminatórias.

321 REGIONAL 10
MARAPONGA
Construção de prédios no bairro Maraponga começou na década de 1970
O bairro Maraponga como conhecemos hoje é muito diferente de anos atrás. Até a década de 1940, a Maraponga era uma região com muitos sítios e nenhuma urbanização. Uma de suas principais avenidas é a Godofredo Maciel, que era uma pequena estrada de terra.
Etimologicamente a palavra Maraponga tem origem indígena com a junção de duas outras palavras: Mbará (mar) e Apong ou Pong (soar, emitir som, bater), resultando em algo como “mar agitado”.


Antes da nova divisão administrativa de Fortaleza, o bairro fazia parte da Regional 5. Um dos pontos mais conhecidos do bairro e considerado marco zero da criação da cidade é a lagoa da Maraponga, que era coberta por uma vasta área verde. Atual-


mente, a área onde situa-se a lagoa tornou-se Parque Ecológico da Maraponga.


As transformações no bairro tiveram início pela década de 1970 com a construção de prédios.
A indústria da moda também foi um dos fatores que contribuiu para o avanço e a expansão da Maraponga, com a realização do I Festival da Moda de Fortaleza, em 1980.
No bairro também é possível encontrar lugares para exercer a fé. A capela Santa Rita de Cássia iniciou suas atividades em 1955, sob jurisdição da Paróquia Bom Jesus dos Aflitos, na Parangaba.
Após algumas mudanças, foi desmembrada em 2005, passando a se chamar Santo Antônio de Pádua e a fazer parte oficialmente da Maraponga.

322 NOSSOS BAIRROS | NOSSA FORTALEZA
DADOS GERAIS

Localização
Regional: SR 10
Território: 35





Bairros limítrofes: Vila Manoel Sátiro, Parangaba, Itaperi, Dendê, Jardim Cearense, Mondubim e Novo Mondubim

População estimada: 10.155
População Feminina: 5.435
População Masculina: 4.720
Densidade (hab/km²): 5.977,05
Área (km²): 1,70
Perímetro (km): 6.991,84
Avenidas principais: Godofredo Maciel; Cambará
Feira: Maraponga (Rua 10, S/N – Campo dos Ingleses)
IDH: 0,390
FCO FONTENELE 323 REGIONAL 10
IGREJAS



Igreja Internacional da Graça de Deus (R. Francisco Glicério, s/n); Capela Santa Rita de Cássia (R. Florêncio Coelho Holanda, 482); Igreja de Santo Antônio de Pádua (R. Lourenço Pessoa, 760); Assembleia de Deus - Templo Central (Rua Carlos Juaçaba, 590); Igreja Evangélica Assembleia de Deus Templo Central - Congregação Vila Betânia (R. Carlos Juaçaba)
SAÚDE
Postos de Saúde: Pedro Celestino (Rua Gastão Justo, 215)
PRAÇA
Praça das Artes Leonilson
MEIO AMBIENTE
Unidades de conservação ambiental: Área de Proteção Ambiental (APA) da Lagoa da Maraponga

Parques: Polo de Lazer da Maraponga


Rios ou lagoas: Lagoa da Maraponga
Parque Ecológico da Lagoa da Maraponga - Compreende uma Unidade de Conservação (UC) de aproximadamente 31 hectares. O Parque passou por uma revitalização em 2021.
O Parque Ecológico da Lagoa da Maraponga foi criado por meio do decreto municipal nº 21.349/91, de 3 de maio de 1991. Possui um ecossistema lacustre, que é uma grande concentração de águas suficientemente profundas, rodeadas por terras consideravelmente extensas.
A Lagoa da Maraponga faz parte do Parque e é o principal equipamento de lazer do bairro. Possui aproximadamente 95.000 m², com uma grande área verde ao redor, além da beleza dos espelhos d’água.
A Lagoa da Maraponga foi regulamentada como Parque Urbano por decreto criado em 2014 e fica na altura da Av. Godofredo Maciel com Rua Áustria (limítrofe à faixa de domínio da Via Férrea). A área total do Parque é de 193.697,72 m².
EDUCAÇÃO
Escolas: Escola Municipal Sagrado Coração (Rua Holanda, 477)
SEGURANÇA
Delegacias: Delegacia de Roubos e Furtos de Veículos e Cargas (Av. Godofredo Maciel, 2800)
Juizados: 2ª Unidade do Juizado Especial Cível de Fortaleza (Maraponga-Detran)
Bombeiros: Batalhão de Socorro de Urgência (BSU)(Av. Aristóbulo Quevedo, 3208)
AIS: 9
TRANSPORTE PÚBLICO
Ônibus: Parangaba / Alto da Paz; Cidade Nova / Parangaba; Parangaba / Parque Veras
Metrô: Linha Sul
ÁREA EDIFICADA (M²)
Inscrições Residenciais: 380.732,00
Inscrições Comerciais: 140.705,96
Inscrições de Prestação de Serviços: 3.277,49
Inscrições Industriais: 7.096,48
Assentamentos precários: Favelas Rua São Donato; Rua Benedito; Ocupação Júlio Alcides; Luxemburgo / Ocupação Junto Maraponga ou Barracal; Ocupação Godofredo Maciel / Maraponga
324 NOSSOS BAIRROS | NOSSA FORTALEZA







FCO FONTENELE 325 REGIONAL 10
Lagoa da Maraponga serve de lazer aos moradores
MONDUBIM
A região era ocupada por chácaras e fazendas, com grandes e vastas áreas verdes. Segundo historiadores, o nome Mondubim já era citado no mapa da Expedição de Mathias Beck à Maranguape, quando os holandeses estiveram no Ceará.



Etimologicamente, a palavra Mondubim vem da variação de “mudubim” e refere-se ao amendoim. Significa “estar em montão”, pois é uma corruptela de “ma”, montão, e “ubi”, estar.

DADOS GERAIS
Regional: SR 10
Território: 35

Bairros limítrofes: Novo Mondubim, Maraponga, Jardim Cearense, Dendê, Parque Dois Irmãos, José Walter, Planalto Ayrton Senna, Aracapé, Conjunto Esperança

População estimada: 76.044

População Feminina: 39.489
População Masculina: 36.555
Densidade (hab/km²): 10.665,36
Área (km²): 7,13
Perímetro (km): 11.861,69
AURÉLIO ALVES 326 NOSSOS BAIRROS | NOSSA FORTALEZA
Cuca Mondubim fica na Rua Santa Marlúcia, em frente à Lagoa do Mondubim
Avenidas principais: Presidente Costa e Silva; Godofredo Maciel; Bernardo Manuel;
Ecopontos: Mondubim; Cartier
IDH: 0,233
SAÚDE
Postos de Saúde José Paracampos; Luiza Távora ; Régis Jucá
PRAÇAS
Praça Sítio Córrego; Praça José Airton Texeira; Quadrante da Praça do Rio Negro; Praça do Quadrado
ESPORTE
Areninhas: Mini Areninha do Mondubim; Areninha do Aracapé; Areninha Itaperi; Areninha Alto da Paz
IGREJAS

Igreja de Nossa Senhora do Perpétuo Socorro;Igreja Evangélica Missão Amar Mondubim; Igreja de Santa Edwiges; Paz Church Mondubim; Igreja de São José; Igreja de Santo Inácio de Loyola; Igreja Batista Independente Mondubim; Igreja Batista Comunidade da Vitória; Assembleia de Deus Templo Central Mondubim; Igreja Nossa Senhora do Santíssimo Sacramento
EDUCAÇÃO
Escolas: Centros de Educação Infantil Jonathan da Rocha Alcoforado; Maria Hercília Evangelista Martins; Professor Jacinto Botelho Professor Osmírio de Oliveira Barreto
Escolas Municipais: Casimiro Montenegro; Jonathan da Rocha Alcoforado; Novo Renascer; Professor Jacinto Botelho; Professor Osmírio de Oliveira Barreto; Rosa Amaro Cavalcante Unidade II; Creches Parceiras Alegria de Criança; Cor do Brasil; Coração de Maria II; Criança Feliz 2; Meu Anjo; Tia Leleu; Escola Municipal de Tempo Integral Hildete Brasil de Sá Cavalcante
MEIO AMBIENTE
Lagoa do Catão; Parque Urbano da Lagoa do Mondubim
CULTURA
Museu da Gaivota; Minimuseu Firmeza; Cuca do Mondubim
PATRIMÔNIO HISTÓRICO
Paróquia Nossa Senhora do Perpétuo Socorro
SEGURANÇA
AIS: 9
TRANSPORTE PÚBLICO
Ônibus: Siqueira/Papicu/Washington Soares; Grande Circular II; Antônio Bezerra/Messejana/Perimetral; Pavuna; Timbó



Metrô: Linha Sul
ÁREA EDIFICADA (M²)
Inscrições Residenciais: 1.258.083,97
Inscrições Comerciais: 396.842,77


Inscrições de Prestação de Serviços: 13.163,43
Inscrições Industriais: 21.893,24
Assentamentos precários: Conjuntos Habitacionais Vitória e Conj. Esperança III; Favelas Ipaumirim; Catão/Pequeno Mondubim; Barracal do Cristo Redentor; Rua Pirineus (currupião) e outros.
327 REGIONAL 10
NOVO MONDUBIM
O Novo Mondubim foi criado com o desmembramento de uma área do bairro Manoel Sátiro e seu nome foi determinado por meio de um decreto legislativo criado em 2010 (nº 465, de 30/11/2010).
Segundo o decreto, o bairro ficou com os seguintes limites: inicia ao norte com a Avenida Waldir Diogo, a Avenida Contorno Oeste (continuação) e a Rua Santa Marlúcia, com o contorno da lagoa do Mondubim até encontrar a Rua Manoel Sátiro; ao sul, com a Avenida Contorno Norte do Conjunto Esperança e a Rua Estrada do Siqueira até encontrar a Avenida Cônego de Castro; a leste, com o trilho do Mondubim e, a oeste, com a Avenida Cônego de Castro até encontrar o ponto inicial.
DADOS GERAIS

Localização
Regional: SR 10
Território: 34


Bairros limítrofes: Canindezinho, Parque São José, Vila Manoel Sátiro, Mondubim E Conjunto Esperança
População estimada: *
População Feminina: *
População Masculina: *
Densidade (hab/km²): *
Área (km²): 1,76
Perímetro (km): 6.029,92
Avenidas principais: Waldir Diogo; Contorno Norte
* O Novo Mondubim foi considerado bairro após o Censo de 2010, antes disso essa região fazia parte do bairro Vila Manoel Sátiro. Por isso, não existem dados concretos sobre a população, sendo considerada como parte dos habitantes da Vila Manoel Sátiro, de 37.952 habitantes.
ESPORTES
Areninhas: Areninha Parque Santo Antônio (Av. Waldir Diogo)
IGREJAS



Igreja de São Roque (R. 101, 30); Igreja Cristã Gileade Novo Mondubim (R. 101, 1342); Igreja do Divino Pai Eterno (Av. Waldir Diogo, 1161); Igreja Assembleia de Deus Fortaleza (R. Pôrto Franco, 110)
EDUCAÇÃO
Escolas: Centros de Educação Infantil Hilza Diogo Cals (Rua Silvino, 31); Maria Bezerra Quevedo (Rua 106, 114 - Conjunto Novo Mondubim); Escolas Municipais Hilza Diogo Cals (Av. Waldir Diogo, 850); José Ayrton Teixeira (Rua Alfredo Mamede, S/N); Maria Bezerra Quevedo (Rua 103, 28 - Conjunto Novo Mondubim); Marieta Guedes Martins (Av. Cônego de Castro, 4701); Rosa Amaro Cavalcante (Rua Alfredo Mamede, 1064); Feliz Amanhecer (Rua 106, 100)

328 NOSSOS BAIRROS | NOSSA FORTALEZA
SEGURANÇA
AIS: 9
TRANSPORTE PÚBLICO
Ônibus: Siqueira/Papicu/Washington Soares; Grande Circular II; Antônio Bezerra/Messejana/Perimetral; Siqueira/Messejana/Perimetral; Barra do Ceará/Ceasa; Monte Rey/Siqueira; Conjunto Esperança/Parangaba; Aracapé/Conjunto Esperança/Siqueira
Metrô: Linha Sul
ÁREA EDIFICADA (M²)*
Inscrições Residenciais: -



Inscrições Comerciais: -

Inscrições de Prestação de Serviços: -
Inscrições Industriais: -


Assentamentos precários:
* O Novo Mondubim foi considerado bairro após o Censo de 2010, antes disso essa região fazia parte do bairro Vila Manoel Sátiro. Por isso, não se tem dados concretos sobre a localidade.
VET MÓVEL PÚBLICO
O VetMóvel é um dos serviços disponibilizados pela Prefeitura de Fortaleza. O equipamento realiza serviços gratuitos de castração e consultas, atendendo cães e gatos com tutores de segunda a sexta-feira.
Atualmente, estão operando três unidades do projeto no bairro, sendo duas itinerantes e uma fixa, todas administradas pela Coordenadoria Especial de Proteção e Bem-Estar Animal (Coepa).
Desde o seu lançamento, em junho de 2018, o projeto já possibilitou mais de 168 mil serviços e atividades direcionadas ao bem-estar de cães e gatos em toda a Capital cearense.
atende cães e gatos de
 VetMóvel no Novo Mondubim
moradores do bairro e adjacências
VetMóvel no Novo Mondubim
moradores do bairro e adjacências
329 REGIONAL 10
FERNANDA BARROS
PARQUE SANTA ROSA
O bairro começou a se desenvolver com a chegada das irmãs que faziam parte da congregação do Bom Pastor e, posteriormente, com a vinda dos padres jesuítas, que, na década de 1980, percorriam o território nacional para evangelização.

O então loteamento começou a ganhar força com a chegada de mais moradores. Iniciaram a construção da capela que tem como padroeiro São José de Anchieta.
O Parque Santa Rosa, antes da nova divisão territorial de Fortaleza, era na Regional 5. A localidade fica próxima aos bairros Conjunto Esperança, Parque São José, Canindezinho e Parque Presidente Vargas.
O Parque Santa Rosa possui em sua área o riacho Maranguapinho, que corta toda a sua extensão.
DADOS GERAIS

Localização
Regional: SR 10
Território: 34




Bairros limítrofes: Canindezinho, Conjunto Esperança, Aracapé e Presidente Vargas
 Areninha Parque Santa Rosa foi instalada em 2014
Areninha Parque Santa Rosa foi instalada em 2014
330 NOSSOS BAIRROS | NOSSA FORTALEZA
FERNANDA BARROS
População estimada: 12.790

População Feminina: 6.684
População Masculina: 6.106
Densidade (hab/km²): 12.764,47
Área (km²): 1,00
Perímetro (km): 4.679,01
Feira: Parque Santa Rosa (Rua Aristides, entre as ruas Professor Cabral e das Cerejeiras)
IDH: 0,243
ESPORTES

Areninha Parque Santa Rosa (Avenida E esquina com Rua Ari Lobo)
Areninha Parque Santa Rosa - O projeto Areninhas foi criado em 2014 pela Prefeitura de Fortaleza. O equipamento instalado no bairro Parque Santa Rosa foi o de número 74 desde o início do projeto. Atualmente são cerca de 90.
Um dos objetivos do programa é instalar para a população equipamentos esportivos de convivência, lazer e formação cidadã.
A Areninha Parque Santa Rosa teve um investimento de R$ 1.057.825, segundo a Prefeitura, e foi instalada no bairro em 2020.
O local conta com grama sintética de alto padrão, novo alambrado, refletores, arquibancadas, além de dois vestiários. Em seus arredores, há um calçadão com piso intertravado e acessibilidade, mobiliário urbano e iluminação.
Em cada Areninha é instalado um Núcleo do Atleta Cidadão, projeto realizado por meio da Secretaria Municipal de Esporte e Lazer (Secel) e da Federação de Triathlon do Estado do Ceará (Fetriece).
O programa desenvolve o esporte nas areninhas e praças em comunidades de Fortaleza por meio da democratização e garantia de acesso, dentro de ações práticas e participativas.
IGREJAS



Igreja Batista Nova Aliança (Rua Porto Príncipe, 738); Igreja Universal do Reino de Deus (Av. José Tavares, 905); Igreja Batista Regular Ebenézer (R. Iná Brito, 288); Igreja de Deus no Brasil (R. Luís Guedes, 584); Capela São Francisco de Assis (R. Vitória Régia, 1190); Igreja Adventista do Presidente Vargas (Rua Alcindo Guanabara, 779); Igreja Evangélica Congregacional (R. Iná Brito, 419); Congregação Cristã no Brasil (Rua Tulipa Negra, 1154); Igreja de São José de Anchieta (Rua Dom Xisto Albano, 3559); Ass de Deus Conj. Esperança (R. Raimunda Aristides, 885)
EDUCAÇÃO
Escolas: Escola Municipal Professor José Maria Moreira Campos (Rua Francisco de Almeida, 525); Creche Parceira Meu Mundo Azul (Rua Professor Cabral, 888)
SEGURANÇA
AIS: 9
TRANSPORTE PÚBLICO
Ônibus: Parque Santa Rosa/Siqueira; Jardim Fluminense/Siqueira; Parque Presidente Vargas; Parque Santa Maria/Siqueira
Metrô: Linha Sul
ÁREA EDIFICADA (M²)
Inscrições Residenciais: 248.241,04
Inscrições Comerciais: 54.401,04
Inscrições de Prestação de Serviços: 1.603,64
Inscrições Industriais: 3.932,80
Assentamentos precários: Favelas Parque Santa Rosa; Comunidade Jardim Fluminense; Comunidade Canal Presidente Vargas; Rua Travessa Evandro Junior; Planalto Santa Rosa; Rua das Cajazeiras

331 REGIONAL 10
PARQUE SÃO JOSÉ
O Parque São José é um pequeno bairro de Fortaleza, possuindo uma área de 0,60 km². Sua população, segundo o Censo 2010 do Instituto Brasileiro de Geografia e Estatística (IBGE), é de 10.486 habitantes.
O bairro possui uma Unidade de Atenção Primária em Saúde (UAPS) Parque São José, localizada na Rua Desembargador Frota, s/n, e oferece os serviços de atenção primária: imunização; atenção ao paciente com tuberculose; atenção ao pré-natal, parto e nascimento; atenção integral em hanseníase; controle de tabagismo; diagnóstico por anatomia patológica e/ou citopato; entre outros.
DADOS GERAIS
Localização
Regional: SR 10
Território: 34


Bairros limítrofes: Bonsucesso; Vila Peri; Vila Manoel Sátiro; Canindezinho e Bom Jardim

População estimada: 10.486



População Feminina: 5.479
População Masculina: 5.007
Densidade (hab/km²): 17.593,96
Área (km²): 0,60

Perímetro (km): 3.914,59
Avenidas Principais: Luiz Vieira; General Osório de Paiva
IDH: 0,284
Abemce calcula já ter transformado 4.500 vidas ao longo de quase 50 anos 332 NOSSOS BAIRROS | NOSSA FORTALEZA
FERNANDA BARROS
ATIVIDADE SOCIAL
Conselho Comunitário do Parque São José (CCPSJ )Rua Costa Freire nº 2238;
Associação Beneficente ao Menor Carente do Parque São José Abemce - A Tia Francisca, nome carinhoso de Francisca das Chagas Silva de Souza, moradora do bairro Parque São José, ao perceber a necessidade da comunidade de oportunidades nas áreas de assistência social e, principalmente, educação, iniciou em sua própria casa de 6 m² a Escolinha de Assistência ao Menor Carente, em 1975. Seguiu ampliando o acesso à educação e cidadania para toda a comunidade. Até que no ano de1988, Tia Francisca realiza o registro oficial e é registrada a Associação do Bem Estar Social do Ceará (Abemce), com o antigo nome, Associação Beneficente ao Menor Carente do Parque São José. No estatuto da Associação está descrita a finalidade: a organização político-pedagógica da Comunidade; ações sócio-educativas para crianças e adolescentes; programas na área da saúde; saneamento básico; iniciação ao processo de profissionalização; cidadania; programas de renda; e inclusão social. O projeto hoje se expandiu para Baturité, Pratius, Campos Belos e Caridade. Segundo a Abemce, mais de 4.500 vidas já foram transformadas pelos projetos da associação. O projeto hoje se expandiu para Baturité, Pratius, Campos Belos e Caridade. Segundo a Abemce, mais de 4.500 vidas já foram transformadas pelos projetos da associação.
IGREJAS


Igreja do Sagrado Coração de Jesus (R. Einstein, 1960); Igreja do Evangelho Quadrangular (Av. Luiz Vieira, 578); Igreja Adventista do Sétimo Dia (Rua Des.Frota, 710);
Igreja Universal (R. Cônego de Castro, 3700); Igreja
Cristã Maranata (R. Raimundo Neri, 129); Missão Maanaim (R. Einstein, 1923); 1ª Igreja Presbiteriana Renovada de Fortaleza (Rua Des.Frota, 215); Igreja Universal do Reino de Deus (Av. Gen. Osório de Paiva, 4633)
SAÚDE
Postos de Saúde: Parque São José (Rua Desembargador Frota, s/n)
EDUCAÇÃO
Escolas: Escola Municipal Noelzinda Sátiro Santiago (Rua Dom Xisto Albano, 1298); Creches Parceiras José Ordélio Mendes Alves (Rua Costa Freire, 2472); Santo Antônio (Rua João Ramalho, 475); Santo Antônio II (Rua Comendador Garcia, 1817)
SEGURANÇA
AIS: 9
TRANSPORTE PÚBLICO
Ônibus: 050 Siqueira / Papicu / Washington Soares; 082 Antônio Bezerra / Messejana / Perimetral; 10331
Conjunto Senador Carlos Jereissati - Rota 01; 180 Barra do Ceará / Ceasa; 319 Parque São José / Osório de Paiva / Parangaba; 329 Parque Santa Rosa / Siqueira
Metrô: Linha Sul
ÁREA EDIFICADA (M²)
Inscrições Residenciais: 162.961,15
Inscrições Comerciais: 46.365,94
Inscrições de Prestação de Serviços: 1.683,90
Inscrições Industriais: -



Assentamentos precários: Favelas Comunidade dos Canos; Nossa Senhora Aparecida; Santa Liduína; Comunidade Parque São José; Loteamento Irregular Rua João Ramalho

333 REGIONAL 10
PRESIDENTE VARGAS
O bairro Parque Presidente Vargas possui cerca de 55 ruas e vias e está localizado na Regional 10 de Fortaleza. O logradouro possui a praça Luzia Maria da Conceição, construída em 2018, em frente ao Centro de Educação Infantil (CEI) Henrique Venâncio da Silva.
O local, antes um terreno baldio, tem uma área de 1.784,41 m² urbanizada, com piso intertravado, mobiliários urbanos, gramado, paisagismo e nova iluminação. E tornou-se, desde então, mais uma opção de lazer para a população. A praça fica localizada na Rua Ozório Correia, S/N, entre a Rua Alcíndo Guanabara e a Rua das Cerejeiras.

DADOS GERAIS
Localização
Regional: SR 10
Território: 34


Bairros limítrofes: Canindezinho, Parque Santa Rosa, Aracapé
População estimada: 7.192

População Feminina: 3.632
População Masculina: 3.560
Densidade (hab/km²): 4.655,02
Área (km²): 1,55
Perímetro (km): 5.324,72
IDH: 0,135
ESPORTE
Areninhas: Arena do Pai (R. Cônego de Castro, 9465)
IGREJAS


Igreja Universal (R. Umarizeira, 1560); Comunidade Cristã Videira (R. Osório Correia, 1440); Igreja Pentecostal Deus é Amor (R. Herculano Pena, 656); Assembleia de Deus Celestial Parque Presidente Vargas (Rua Professor Cabral, 1310)
PRAÇAS
Praça Luzia Maria da Conceição
MEIO AMBIENTE
Rios ou lagoas: Rio Maranguapinho
EDUCAÇÃO
Escolas: Centro de Educação Infantil Henrique Venâncio da Silva (Rua Osório Correia, S/N); Escolas Municipais Marilene Lopes Rabelo (Rua Jacarandá, 460); Marilene Lopes Rabelo Unidade II (Rua Martins de Lima, 391); Creches Parceiras Coração de Maria (Rua São Basílio, 979); Tio Cazuza (Rua Vicente Celestino, 1230); Escola Municipal de Tempo Integral Professora Maria José Ferreira Gomes (Rua Cônego De Castro, 8617);
Escola de Ensino Médio Presidente Vargas - Foi fundada em 1988 e integra a Superintendência das Escolas Estaduais de Fortaleza (Sefor) 3. Mas a escola de 1988 foi demolida e reconstruída em 2022. O novo prédio da escola, que permaneceu com o mesmo nome, foi inaugurado em fevereiro de 2022.
Ela é uma escola vertical e possui 12 salas de aula, laboratório, climatização, biblioteca, ginásio, auditório, quadra poliesportiva. A nova unidade de ensino tem capacidade para atender até 540 alunos em cada turno (manhã, tarde e noite), totalizando até 1.620 estudantes.
A Escola teve um investimento de R$ 10 milhões, oriundos de recursos estaduais e federais, utilizados para construir, mobiliar e equipar o novo espaço. A obra foi implementada sob supervisão da Superintendência de Obras Públicas (SOP).
334 NOSSOS BAIRROS | NOSSA FORTALEZA
SEGURANÇA
AIS: 9
TRANSPORTE PÚBLICO
Ônibus: 370 Parque Santa Maria / Nova Esperança; 381 Parque Santa Maria / Siqueira; 392 Nova Esperança / Siqueira
Metrô: Linha Sul

ÁREA EDIFICADA (M²)
Inscrições Residenciais: 99.763,29
Inscrições Comerciais: 16.596,07
Inscrições de Prestação de Serviços: 3.459,71
Inscrições Industriais: -





Assentamentos precários: Favelas Comunidade Jardim Fluminense; Umarizeira; Comunidade Canal Presidente Vargas; Loteamentos Irregulares Parque Alto Alegre; Rua Antônio Moreira

Escola Presidente Vargas foi fundada em 1988 335 REGIONAL 10
FERNANDA BARROS
REGIONAL 11
























Na parte Oeste de Fortaleza, uma comunidade relevante é a do Conjunto Ceará, que se divide em I e II. A Casa da Mulher Brasileira, equipamento de acolhimento a vítimas de violência, o maior campus da UFC e a casa onde cresceu a escritora Rachel de Queiroz ficam aqui




 Campus do Pici da Universidade Federal do Ceará (UFC)
Campus do Pici da Universidade Federal do Ceará (UFC)





























GUIA DA REGIONAL 11
Hospital da Mulher é importante equipamento do Jóquei Clube

BAIRROS
Autran Nunes
Bela Vista
Conjunto Ceará I
Conjunto Ceará II
Couto Fernandes

Demócrito Rocha
Dom Lustosa
Genibaú
Henrique Jorge
João XXIII
Jóquei Clube
Panamericano
Pici
338 NOSSOS BAIRROS | NOSSA FORTALEZA
AURÉLIO ALVES
SECRETARIA REGIONAL 11
Avenida Jovita Feitosa, 1264 - Parquelândia
Fortaleza - CEP: 60455-410
Telefone: (85) 3433-2548
OUVIDORIA
Telefone: (85) 3433 2519
E-mail: ouvidoria.ser3@sr3.fortaleza.ce.gov.br
CENTRAL DE ACOLHIMENTO
E-mail: thiago.vale@sr11.fortaleza.ce.gov.br
CONSERVAÇÃO E SERVIÇOS PÚBLICOS
E-mail: eraguito.passo@sr11.fortaleza.ce.gov.br
ORDENAMENTO DE TERRITÓRIO
E-mail: daniel.freire@sr11.Fortaleza.ce.gov.br

Secretário: Raimundo Filho
E-mail: raimundo.filho@sr11.fortaleza.ce.gov.br
Formado em Psicologia, com especialização em Prevenção à Dependência Química pela Universidade de Fortaleza (Unifor). É servidor da Agência Nacional de Vigilância Sanitária (Anvisa) desde a criação, tendo exercido as funções de responsável pelo posto portuário de Fortaleza, coordenador substituto e coordenador da Vigilância Sanitária de Portos, Aeroportos, Fronteiras e Recintos Alfandegados no Ceará.
Foi diretor de saúde do Sindicato Nacional dos Servidores das Agências Nacionais de Regulação (Sinagências). Foi suplente de vereador em 2012, vereador eleito em 2016, compondo a Mesa Diretora da Câmara Municipal como 2º vice-presidente (2019-2020), e vereador reeleito em 2020.
CONTATOS IMPORTANTES
GABINETE
E-mail: raimundo.filho@sr11.fortaleza.ce.gov.br

SINE MUNICIPAL - REGIONAL 11
WhatsApp (trabalhador): (85) 9 8513 4385
WhatsApp (empregador): (85) 9 8970 3532
COORDENAÇÃO DE INFRAESTRUTURA
E-mail: eraguito.passo@sr11.fortaleza.ce.gov.br
NÚCLEO DE MEDIAÇÃO
E-mail: comednucleosr3@gmail.com
CADASTRO ÚNICO
Telefone: (85) 3433 2517
AGEFIS: 156
VIGILÂNCIA SANITÁRIA
Telefone: (85) 9 8513 3754
LICENCIAMENTO DE ESPAÇOS PÚBLICOS
E-mail: fernando.silva@sr11.fortaleza.ce.gov.br
339 REGIONAL 11
AUTRAN NUNES
Na parte Oeste de Fortaleza, o Autran Nunes é um pequeno bairro localizado mais perto de Caucaia do que do Centro. Já foi chamado de Alto do Bode e Caocá, mas mudou de nome para homenagear um juiz que promoveu algumas ações sociais em benefício dos moradores.
O bairro é rodeado pelo Rio Maranguapinho e tem um baixo fluxo de veículos. Tem variedade de comércios e um calçadão à beira do rio
DADOS GERAIS
População estimada: 21.208
População Feminina: 10.927
População Masculina: 10.281
Densidade (hab/km²): 21.751,79
Área total: 0,98
Perímetro (km): 4.726,45
Localização: Regional 11, Território 37, na parte oeste de Fortaleza. Faz divisa com os bairros Antônio Bezerra, Dom Lustosa, Henrique Jorge e Genibaú.
Avenidas principais: Avenida Senador Fernandes Távora.
Feiras livres: Feira do Autran Nunes (às sextas-feiras, na Rua da Liberdade)
Ecopontos: Ecoponto - Autran Nunes (Av. Senador Fernandes Távora, 2938), Ecoponto Autran Nunes II (R. Hipólito Pamplona, 195).
IDH (IBGE): 0,182
ESPORTE
Areninha Tocantins
IGREJAS
Capela São Luís Gonzaga; Igreja Santa Teresinha; Capela São Vicente de Paulo; Assembleia de Deus Templo Central Autran Nunes.
SAÚDE
Posto de Saúde Eliézer Studart; UPA Autran Nunes
ATIVIDADE SOCIAL

Projeto Cultural Arte e Cor - Instituição sem fins lucrativos, fundada em 1991 com o objetivo de proporcionar uma assistência de qualidade na educação e incentivar e promover a cultura em suas diversas artes. Assim, busca suprir as necessidades das comunidades do bairro Autran Nunes e adjacências, reduzindo os índices de violência, criminalidade e fortalecendo os laços familiares. A ONG atua com crianças, jovens, idosos, pessoas com deficiência e demais grupos em vulnerabilidade social.
PRAÇAS
Praça do Autran Nunes, Praça Antônio Carlos Silva.
MEIO AMBIENTE
Rio Maranguapinho
EDUCAÇÃO
EMEIEF Autran Nunes
SEGURANÇA
AIS: 6
340 NOSSOS BAIRROS | NOSSA FORTALEZA
TRANSPORTE PÚBLICO
Ônibus: Cj Ceará/Antônio Bezerra I; Cj Ceará/Lagoa/ Fernandes Távora; Cj Ceará/Papicu/Montese; Cj Ceará/Aldeota/Papicu; Cj Ceará/Antônio Bezerra II; Autran Nunes; Genibaú/Centro; Genibaú/Lagoa; Cj Ceará/Centro; Granja Lisboa/Goiabeiras
ÁREA EDIFICADA (M2)

Inscrições Residenciais: 2.039
Inscrições Comerciais: 322

Inscrições de Prestação de Serviços: 10
Inscrições Industriais: 2
Assentamentos precários: Comunidade Cuiabá, Favela do Canil, Comunidade Beco do Cal, Rua Daniel de Castro, Travessa Alvorada, Comunidade Beira Rio I e II/ Sem Terra, Parque Maranguapinho, Reassentamento Morro do Ouro, Rua Barão de Cotergipe, Rua Gago Cardoso, Do Cal - Goiania, Goiania, Dom Lustosa, Veneza/ Daniel Castro, Graco Cardoso, Rua Azevedo Perdigão, Rua Curitiba e outra sem nome.
341 REGIONAL 11
Praça Antônio Carlos Silva, na Rua dos Pinhais, é opção de lazer no Autran Nunes MESQUITA
THAIS
BELA VISTA
O bairro da Bela Vista está localizado na parte Oeste de Fortaleza. Surgiu em 1937 com a construção da Capela de Nossa Senhora de Salete, quando a população local foi povoando os arredores.
O bairro começou a se desenvolver depois dos anos 1950 com os primeiros comércios, mas foi na década de 1960, com a criação do Mercado Público, que começou a ter um crescimento habitacional.
Hoje, o bairro ainda carece de pontos de convivência, mas tem a seu favor o fácil e rápido acesso ao Centro da Cidade pelas avenidas José Bastos e João Pessoa.

DADOS GERAIS
População estimada: 16.754

População Feminina: 8.987
População Masculina: 7.767
Densidade (hab/km²): 17.061,10
Área total: 0,98
Perímetro (km): 5.145,27
Localização: Regional 11, Território 36, na parte oeste de Fortaleza. Faz divisa com os bairros Pici, Amadeu Furtado, Rodolfo Teófilo, Damas, Montese, Couto Fernandes e Panamericano.
342 NOSSOS BAIRROS | NOSSA FORTALEZA
Trecho da Avenida José Bastos, no bairro Bela Vista
MESQUITA
THAIS
Avenidas principais: Avenida José Bastos, Avenida João Pessoa.

Mercados públicos: Mercado da Bela Vista
IDH (IBGE): 0,375
ATIVIDADE SOCIAL
Cozinha popular MTD Bela Vista - A cozinha popular do Movimento das Trabalhadoras e Trabalhadores por direitos (MTD) foi inaugurada em 2021 no bairro Bela Vista e tem sido uma saída coletiva para enfrentar a fome na comunidade. A iniciativa, que é uma parceria entre MTD e as pastorais sociais, em especial a Pas-
toral da Criança, funciona com doações de alimentos e com trabalho voluntário de diversas formas: cozinhando, arrecadando alimentos, cortando verduras, lavando panelas, dentre outros serviços.
IGREJA
Capela de Nossa Senhora da Penha.
EDUCAÇÃO
EMTI Prof. José Júlio da Ponte; EEMTI Estado do Amazonas; EMEF Nilson Holanda; Escola Municipal Nauri Braga,
SEGURANÇA
AIS: 6
TRANSPORTE PÚBLICO
Ônibus: Parangaba/Náutico; Siqueira/Papicu/13 de Maio; Parangaba/Papicu; Corujão/Parangaba/Papicu; Cuca Barra/Parangaba; Parangaba/Mucuripe; Lagoa/ Aldeota; Siqueira/Centro/Expresso; Igreja São Raimundo/Centro; Bela Vista/Lagoa; Bela Vista/Centro; Lagoa/ Demócrito Rocha/Centro; Genibaú/Centro; Cj Esperança/Centro; Siqueira/José Bastos/Centro; Siqueira/João Pessoa/Centro; Parangaba/José Bastos/Centro; Aracapé/Centro; Jardim Jatobá/Centro; Parangaba/João Pessoa/Centro; Cj Ceará/Centro; Granja Lisboa/Goiabeiras
Trem/Metrô: Estação Couto Fernandes (linha Sul)
ÁREA EDIFICADA (M2)
Inscrições Residenciais: 4.231

Inscrições Comerciais: 591
Inscrições de Prestação de Serviços: 23
Inscrições Industriais: 4
Assentamentos precários: Beco da Bosta; Riacho do Corrente; 3 de Maio; Copacabana; Vitória do Couto Fernandes; Rua 3 de maio.
343 REGIONAL 11
CONJUNTO CEARÁ I
O Conjunto Ceará I está localizado na Regional 11 e faz divisa com o Conjunto Ceará II e o bairro Genibaú.
É a comunidade mais relevante na parte Oeste de Fortaleza em termos populacionais. É um dos mais densos bairros da Capital, porque juntando todas as etapas são mais de 40 mil moradores e mais de 10 mil residências.
Os moradores de Fortaleza se acostumaram a reconhecer o Conjunto Ceará como uma cidade dentro de outra cidade. O Conjunto Ceará tem vasta oferta de serviços e equipamentos públicos.
O bairro é considerado uma âncora regional, sendo esses diversos serviços atração de moradores de outros bairros vizinhos.
De acordo com dados do Instituto de Pesquisa e Estratégia Econômica do Ceará (Ipece), o Conjunto Ceará possui a terceira melhor condição de infraestrutura domiciliar de Fortaleza.
A história do bairro remete ao período da Ditadura Militar, período em que o Estado passava por uma crise habitacional. No Ceará, foi criada a Companhia de Habitação do Ceará (Cohab-CE), que utilizou recursos do Banco Nacional de Habitação para desenvolver o projeto do Espaço Habitacional do Conjunto Ceará.
A obra foi entregue em 1977, com 996 casas padronizadas, pelo então governador Adauto Bezerra. O bairro possuía seis tipos de imóveis, do tipo A, B, C, D e E. As casas se diferenciavam em tamanho e em números de cômodos e foram divididas entre a população por meio da análise de renda.
Outra particularidade do Conjunto Ceará é que ele foi projetado com 12 Unidades de Vizinhança (UVs). Cada UV equivale a 100 residências. Neste espaço havia sempre um colégio público como referência.
Atualmente, as 12 UVs foram condensadas e divididas em Conjunto Ceará I e Conjunto Ceará II, partindo o conjunto ao meio.
DADOS GERAIS
Localização: Regional 11 / Território 38 - Faz divisa com os bairros Conjunto Ceará II e Genibaú.
População estimada: 19.221
População Feminina: 10.371
População Masculina: 8.850
Densidade (hab/km²): 12.035,69
Área (km²): 1,60
Perímetro (km): 5.643,46
Avenidas principais: Avenida E, Avenida C, Avenida Ministro Albuquerque Lima.
Ecoponto: Ecoponto Conjunto Ceará I (Rua 442, 159Esquina com Rua 432).
IDH: 0,360
HISTÓRIA SOBRE O BAIRRO
Polo de Lazer do Conjunto Ceará - O Polo de Lazer é o local de maior concentração de eventos do bairro Conjunto Ceará. Batizado como Luiz Gonzaga, no espaço são realizados diversos tipos de atividades, incluindo apresentações na época dos festejos juninos, além de congregar diversos estilos, como o Hip-Hop.
No fim de 2021, foram iniciadas obras de revitalização do Polo, que tem cerca de 100 mil metros quadrados (m³), com espaço de três praças. A modernização entregou à comunidade do Conjunto Ceará campo de futebol em grama sintética, quadra poliesportiva, quadra de vôlei de areia, pista de skate, cachorródromo, brinquedopraça, aparelhos de ginástica, pista de dança e um anfiteatro.
ATIVIDADE SOCIAL
Centro Cultural do Conjunto Ceará Prodecom - É um espaço criado para que o morador do bairro seja sujeito de ação, de forma que possa produzir, inovar, criticar e, principalmente, buscar soluções que contribuam para sua formação e construção de uma identidade autônoma. A atuação do Prodecom envolve oferta de serviços, produtos, livros, fotos, espaço de produção, fomento e difusão de informações por meio de biblioteca e laboratório de multimeios.

344 NOSSOS BAIRROS | NOSSA FORTALEZA


345 REGIONAL 11
AURÉLIO ALVES
Igreja de Nossa Senhora da Conceição, paróquia do Conjunto Ceará I
CONJUNTO CEARÁ II
O Conjunto Ceará II é parte da Regional 11 junto de seus vizinhos, Conjunto Ceará I e Genibaú. O bairro ainda faz divisa com Granja Lisboa e Granja Portugal.
Com população estimada em mais de 23,5 mil moradores, é uma das comunidades de maior densidade populacional de Fortaleza.
É neste bairro que fica localizado o Terminal do Conjunto Ceará, que liga a comunidade via ônibus a diversos bairros de Fortaleza. Há ainda como opção de transporte público a Estação Conjunto Ceará da Linha Oeste do Metrô de Fortaleza.
O Conjunto Ceará II possui boa infraestrutura em relação aos serviços públicos, especialmente de educação. Um exemplo é a Biblioteca Infantil Herbênia Gurgel. Outro caso é o do Centro Cearense de Idiomas (CCI), além dos Ecopontos e Areninha.
DADOS GERAIS
Localização: Regional 11 / Território 38 - Faz divisa com os bairros Conjunto Ceará I, Granja Lisboa, Granja Portugal e Genibaú.
População estimada: 23.673

População Feminina: 12.675
População Masculina: 10.998
Densidade (hab/km²): 12.971,51
Área (km²): 1,83
Perímetro (km): 6.942,31
Avenidas principais: Avenida C, Avenida H, Avenida Alanis Maria Laurindo de Oliveira, Avenida Ministro Albuquerque Lima.
Ecoponto: Ecoponto Conjunto Ceará II (Avenida C, 1890 - Esquina com Rua 1001), Ecoponto Conjunto Ceará (Avenida Ministro Albuquerque Lima, 1150 - Esquina com a Rua 721).
IDH: 0,362
ATIVIDADE SOCIAL
Biblioteca Pública Infantil Herbênia Gurgel - Inaugurada em outubro de 2017, a biblioteca é uma iniciativa do Poder Público para garantir um equipamento voltado ao desenvolvimento sociocultural de crianças no Conjunto Ceará. O equipamento faz parte de uma política pública da Secretaria Municipal de Cultura de Fortaleza (Secultfor), em conjunto com o gabinete da primeira-dama, para valorização do livro, da leitura e do incentivo à literatura. A Biblioteca Pública Infantil Herbênia Gurgel funciona de segunda a sexta, das 8 às 18 horas, e o acesso é gratuito.
ESPORTES
Areninha Conjunto Ceará II, Areninha Conjunto Ceará
IGREJAS
Comunidade Católica Shalom Conjunto Ceará; Igreja de Santa Luzia; Gruta Nossa Senhora das Graças; Congregação Cristã no Brasil; Igreja Universal do Reino de Deus
SAÚDE
Postos de Saúde: UAPS Pontes Neto (Rua 541, 150), UAPS Edmilson Pinheiro (Avenida H, 2191), UAPS Maciel de Brito (Avenida A, S/N).
Hospitais: Hospital Distrital Nossa Senhora da Conceição (Rua 1018, 148), Maternidade do Hospital Conjunto Ceará (R. 1092, 6).
Policlínicas: Laboratório Hapvida Vida & Imagem - Conj. Ceará (Av. Ministro Albuquerque Lima, 228), Odonto Sistem Conj. Ceará (R. 541 D, 36b).
PRAÇAS
Praça do Campo CRB, Praça UV3, Praça do Terminal, Praça da Avenida H, Pracinha da UV5, Pracinha UV1, Praça da Esperança (R. 749, s/n), Praça Luiza Távora (Av. Ministro Albuquerque Lima, 202), Praça Da Quarta Etapa.
346 NOSSOS BAIRROS | NOSSA FORTALEZA
EDUCAÇÃO
Escolas: CEI Jornalista Neno Cavalcante; CEI Antônia Nathalia Cristina Chaves Maciel; Escola Edilson Brasil Soárez; Escola João Paulo II; Escola Governador
Faustino de Albuquerque; Creche Irmãos Firmo; EEFM Professor Plácido Aderaldo Castelo; EEEP Professor Cesar Campelo; EEFM Doutor Ubirajara Índio do Ceará; EEFM Professor Edmilson Guimarães de Almeida; EEFM Professora Maria Antonieta Nunes
CULTURA
Bibliotecas: Biblioteca Infantil Herbênia Gurgel (R. 541 E)
Centros culturais: Centro Cearense de Idiomas - CCI Conjunto Ceará; Quadra do Grupo da Paz, Associação
Cearense de Jiu Jitsu
SEGURANÇA
17° Batalhão de Polícia Militar do Ceará; 5ª Unidade do Juizado Especial Cível de Fortaleza
AIS: AIS 2
TRANSPORTE PÚBLICO
Ônibus: Conj. Ceará/Papicu/Montese; Conjunto Ceará/ Aldeota/Papicu; Conj. Ceará/Antônio Bezerra II; Granja Portugal/Conjunto Ceará/Lagoa; Conj. Ceará/Centro
Metrô: Linha Oeste Estação Conjunto Ceará
ÁREA EDIFICADA (M2)

Inscrições Residenciais: 4.675
Inscrições Comerciais: 781

Inscrições de Prestação de Serviços: 22
Inscrições Industriais: 2
Assentamentos precários: Boa Esperança.
347 REGIONAL 11
AURÉLIO ALVES
Biblioteca Infantil Herbênia Gurgel completou cinco anos de funcionamento em outubro de 2022
AURÉLIO ALVES
Há ainda cursos, oficinas e projetos. Com o Centro Cultural do Conjunto Ceará, propõe visibilidade para produção local, sendo ponto de encontro para recreação, shows, teatro e reuniões.
O último eixo está relacionado às redes sociais, criando laços com outras iniciativas locais para desenvolvimento de ações integradas e de apoio.
ESPORTES

Areninha Conjunto Ceará I (Av. B Polo de Lazer)

IGREJAS
Igreja de Nossa Senhora da Conceição ; Ministério Apostólico Efraim; Capela de São Francisco
SAÚDE
Postos de Saúde: C.S.F Maciel de Brito (R. 602, 2).
Policlínicas: IOCE - Instituto de Olhos do Ceará (Rua 444, 42), Hapvida Hapclínica Conjunto Ceará (Av. Ministro Albuquerque Lima, 1421), Ultraclinic (Av. Ministro Albuquerque Lima, 177), Clínica Popular do Ceará (Av. D, número 1143).
UPA: UPA Conjunto Ceará (Rua 860, S/N).
348
BAIRROS | NOSSA FORTALEZA
NOSSOS
Quartel dos bombeiros no Conjunto Ceará
PRAÇAS
Praça Vitória Régia (R. 1155, 17), Pracinha do UV4 (R. 218, 47), Praça do Militão (R. 1111, 25), Praça 448, Praça do UV 2 (R. 448, 113), Praça da Conquista, Praça Jardim (R. 604, 12)
MEIO AMBIENTE
Pólo de Lazer do Conjunto Ceará (Avenida Min Albuquerque Lima, 738), Skatepark Vila Olímpica do Conjunto Ceará, Lago dos Patos (R. 218, 642).
EDUCAÇÃO
Escolas: CEI Antônio Valdinar de Carvalho Custódio; ETI Professor Prisco Bezerra; ETI Professor Ademar Nunes Batista; Creche Nossa Senhora de Fátima; ETP Padre José Arimatéia Diniz; ETP Professor José Militão de Albuquerque; ETP João Nunes Filho; Liceu do Conjunto Ceará; EEFM José Leopoldino da Silva Filho; EEFM Doutor Gentil Barreira; CEJA Adelino Alcantara Filho; EEM Professor José Maria Campos de Oliveira
CULTURA
Teatros: Produçôes (Rua 402, 113).
Centros culturais: Centro Social Urbano CSU do Conjunto Ceará (Av. Alanis Maria Laurindo de Oliveira, s/n), Centro de Inclusão Tecnológica e Social - CITS Conjunto Ceará (R. 1111, 1101), Centro Cultural do Conjunto Ceará.
SEGURANÇA
Delegacias: Delegacia de Polícia Civil | 12° Distrito Policial (R. 602, s/n).
Bombeiros: 5ª Seção de Bombeiros - 5ª SB/1º GBQuartel do Conjunto Ceará (Av. F, 629).
Juizados: CRAS Genibaú (AV. I, 340), Conselho Tutelar (Avenida Alanis Maria Laurindo de Oliveira (antiga Avenida B), 461), CREAS Conjunto Ceará (Av. Alanis Maria Laurindo de Oliveira, 461).
AIS: AIS 2
TRANSPORTE PÚBLICO
Ônibus: Conjunto Ceará/Papicu/Montese; Conjunto Ceará/Aldeota/Papicu; Expresso/Conjunto Ceará/Papicu; Conjunto Ceará/Centro; Conjunto Ceará/Bonsucesso/Centro (Topic)
Metrô: Linha Oeste Estação Parque Albano (Av. F, esquina com a avenida J)
ÁREA EDIFICADA (M2)
Inscrições Residenciais: 3.838
Inscrições Comerciais: 732

Inscrições de Prestação de Serviços: 26
Inscrições Industriais: 0
Assentamentos precários: Favela 184; Dias Monteiro/Olaria e Nova Jerusalém; Área Verde I (Conj. Ceará); Comunidade do Capim.
349 REGIONAL 11
COUTO FERNANDES

O Couto Fernandes é um pequeno bairro que nasceu ao redor da estação ferroviária do km 8, onde hoje está localizada a estação de VLT do Couto Fernandes. O nome do bairro é em homenagem ao engenheiro que foi inspetor de estradas de ferro e administrador da Rede Viação Cearense, de 1915 a 1922.
Devido ao tamanho do bairro, hoje não há muitas opções de lazer na região, mas o acesso à parte central é facilitado.
DADOS GERAIS
População estimada: 5.260
População Feminina: 2.793
População Masculina: 2.467
Densidade (hab/km²): 16.386,29
Área total: 0,32
Perímetro (km): 2.318,21
Localização: Regional 11, Território 36, na parte oeste de Fortaleza. Faz divisa com os bairros Demócrito Rocha, Panamericano, Bela Vista e Montese.
Avenidas principais: Avenida José Bastos, Avenida João Pessoa
IDH (IBGE): 0,361
ATIVIDADE SOCIAL
Casa da Mulher Brasileira do Ceará - Equipamento que atua com rede de proteção e atendimento humanizado às mulheres em situação de violência. A Casa oferece acolhimento e encaminhamento da denúncia de forma ágil e especializada.
O equipamento abriga Delegacia de Defesa da Mulher, Juizado de Violência Doméstica e Familiar contra a Mulher, Ministério Público e Defensoria Pública, além de Centros de Referência municipal e estadual que ofertam atendimento psicossocial.
A Casa também oferta cursos de capacitação profissional dentro da Promoção da Autonomia Econômica, alternativas de abrigamento temporário e espaço infantil para as crianças.
IGREJAS
Igreja de Nossa Senhora do Carmo - Couto Fernandes,
EDUCAÇÃO
Escola Sesc Fortaleza Unidade II.
SEGURANÇA
Delegacias: Delegacia de Defesa da Mulher
AIS: 5
TRANSPORTE PÚBLICO
Ônibus: Parangaba/Náutico; Siqueira/Papicu/13 de Maio; Parangaba/Papicu; Corujão/Parangaba/Papicu; Cuca Barra/Parangaba; Parangaba/Mucuripe; Lagoa/ Aldeota; Siqueira/Centro/Expresso; Genibaú/Centro; Cj Esperança/Centro; Siqueira/José Bastos/Centro; Siqueira/João Pessoa/Centro; Parangaba/José Bastos/Centro; Aracapé/Centro; Jardim Jatobá/Centro; Parangaba/João Pessoa/Centro; Cj Ceará/Centro; Granja Lisboa/Goiabeiras
ÁREA EDIFICADA (M2)
Inscrições Residenciais: 1.042
Inscrições Comerciais: 168
Inscrições de Prestação de Serviços: 4
Inscrições Industriais: 0
Assentamentos precários: Couto Fernandes/Favela do Oito.
350 NOSSOS BAIRROS | NOSSA FORTALEZA


351 REGIONAL 11
THAIS MESQUITA
Casa da Mulher Brasileira: acolhimento às vítimas e encaminhamento de denúncias de violência contra a mulher
DEMÓCRITO ROCHA
Antes conhecido por Marupiara, o Demócrito Rocha é um bairro na parte Leste de Fortaleza. Foi distrito de Parangaba e teve seu nome alterado em 1967 em homenagem ao empresário, poeta e jornalista, falecido em 1943.
Hoje, o Demócrito Rocha é um bairro autossuficiente e com fácil acesso aos principais bairros, seja por via terrestre ou ferroviária pela estação Juscelino Kubitschek.
DADOS GERAIS

População estimada: 10.994

População Feminina: 5.954
População Masculina: 5.040
Densidade (hab/km²): 13.674,13
Área total: 0,80
Perímetro (km): 4.087,60
Localização: Regional 11, Território 36, na parte oeste de Fortaleza. Faz divisa com os bairros Pici, Panamericano, Couto Fernandes, Montese, Parangaba e Jóquei Clube.
Avenidas principais: Avenida João Pessoa, Avenida Américo Barreira
352 NOSSOS BAIRROS | NOSSA FORTALEZA
Antigamente, o bairro era conhecido como Marupiara, atual nome da praça na Rua Alagoas
THAIS MESQUITA
FEIRAS LIVRES: Feira do Demócrito Rocha (às quartas-feiras na rua Minas Gerais, entre a rua Ceará e a rua Alagoas)
IDH (IBGE): 0,369
ATIVIDADE SOCIAL
Projeto Social Amigos Da Comunidade Demócrito Rocha - Coletivo formado por moradores com o objetivo movimentar a comunidade para arrecadação de cestas básicas destinadas às famílias carentes.

SAÚDE
Posto de Saúde Abel Pinto
PRAÇAS
Praça Juscelino Kubitschek, Praça Robson de Sousa, Praça Marupiara.
EDUCAÇÃO
EEFM Joaquim Alves, EEMTI Senador Fernandes Távora, EMEIEF Paulo Sarasate.
SEGURANÇA
AIS: 5
TRANSPORTE PÚBLICO
Ônibus: Parangaba/Náutico; Siqueira/Papicu/13 de Maio; Parangaba/Papicu; Cj Ceará/Papicu/Montese; Corujão/José Bastos/Centro; Corujão/Parangaba/Papicu; Lagoa/Papicu/Via Expressa; Cuca Barra/Parangaba; Parangaba/Mucuripe; Lagoa/Aldeota; Siqueira/ Centro/Expresso; Bela Vista/Lagoa; Lagoa/Demócrito Rocha/Centro; Genibaú/Centro; Cj Esperança/Centro; Siqueira/José Bastos/Centro; Lagoa/Feira; Siqueira/ João Pessoa/Centro; Parangaba/José Bastos/Centro; Aracapé/Centro; Jardim Jatobá/Centro; Parangaba/ João Pessoa/Centro; Parque Universitários/Lagoa; Cj Ceará/Centro; Granja Lisboa/Goiabeiras
Trem/Metrô: Estação Juscelino Kubitschek (Linha Sul)
ÁREA EDIFICADA (M2)
Inscrições Residenciais: 2.676
Inscrições Comerciais: 597

Inscrições de Prestação de Serviços: 14
Inscrições Industriais: 5
Assentamentos precários: Romac; Nova Favela (Rua Paraíba); Comunidade Democrito Rocha; Canal; Rua Rio Grande do Norte I; Rua Rio Grande do Norte II; Novo Democrito Rocha; Trav. Goiais.
353 REGIONAL 11


354 NOSSOS BAIRROS | NOSSA FORTALEZA
MESQUITA
Igreja de Santa Luzia, na Rua Coronel Francisco Bento
THAIS
DOM LUSTOSA
Localizado na parte Oeste de Fortaleza, o Dom Lustosa foi parte do município de Parangaba e era um importante ponto de tráfego entre Parangaba e Barro Vermelho (hoje Antônio Bezerra).
O nome do bairro é uma homenagem ao bispo que fez muito pelas causas sociais, contribuindo, inclusive, com a criação de vários hospitais.
Hoje, o bairro possui uma grande fábrica de tecidos, que fica no centro da região e se destaca pelo comércio e a feira livre que acontece às segundas.
DADOS GERAIS
População estimada: 13.147
População Feminina: 7.038
População Masculina: 6.109

Densidade (hab/km²): 10.974,12
Área total: 1,20
Perímetro (km): 4.780,53
Localização: Regional 11, Território 37, na parte oeste de Fortaleza. Faz divisa com os bairros Antônio Bezerra, Pici, Henrique Jorge e Autran Nunes.
Avenidas principais: Avenida Senador Fernandes Távora, Rua Coronel Matos Dourado
Feiras livres: Feira do Henrique Jorge (às segundas, na Rua Professor Paulo Lopes)
Ecopontos: Ecoponto - Dom Lustosa (R. Cel. Matos Dourado S/N)
IDH (IBGE): 0,320
ATIVIDADE SOCIAL
DL Ação Social - Projeto criado pelo vereador Eudes
Bringel para promover ações sociais no bairro Dom Lustosa. Foi inaugurado em 2022, trazendo festas de São João, Dia das Crianças, além de bazar solidário e escolinha de futsal.
IGREJAS
Igreja de Santa Luzia; Capela Santa Terezinha
MEIO AMBIENTE
Rios ou lagoas: Rio Maranguapinho
EDUCAÇÃO
CAIC Raimundo Gomes de Carvalho; EMEF Murilo Serpa; CEI Bergson Gurjão Farias; EEMTI Ayrton Senna da Silva
SEGURANÇA
AIS: 6
TRANSPORTE PÚBLICO
Ônibus: Antônio Bezerra/Lagoa/Unifor; Corujão/Av. Paranjana I; Cj Ceará/Lagoa/Fernandes Távora; Cj Ceará/Papicu/Montese; Grande Circular I; Grande Circular II; Corujão/Grande Circular I; Corujão/Grande Circular II; Antônio Bezerra/Parangaba; Cj Ceará/Aldeota/Papicu; Cj Ceará/Antônio Bezerra II; Antônio Bezerra/Messejana/Perimetral; Antônio Bezerra/Siqueira; Antônio Bezerra/Lagoa/Parangaba; Dom Lustosa/Antônio Bezerra; Autran Nunes; João Arruda/Antônio Bezerra; Genibaú/Centro; Genibaú/Lagoa; Cj Ceará/Centro; Santos Dumont/Perimetral; Granja Lisboa/Goiabeiras
ÁREA EDIFICADA (M2)
Inscrições Residenciais: 2.568
Inscrições Comerciais: 461
Inscrições de Prestação de Serviços: 11
Inscrições Industriais: 5
Assentamentos precários: Rua Conselheiro Araujo Lima; Dom Lustosa; Travessa Mara; Comunidade da Chesf; Rua Tarcilio Peixoto.
355 REGIONAL 11
Areninha do Genibaú fica no conhecido Campo do Sevilha
GENIBAÚ
O bairro Genibaú fica nos limites de Fortaleza com Caucaia e faz divisa com os bairros Conjunto Ceará I, Conjunto Ceará II, Granja Portugal, Bonsucesso, João XXIII, Henrique Jorge, Autran Nunes e Antônio Bezerra.
Segundo dados levantados pela Prefeitura, em 2018, o Genibaú estava na lista dos dez bairros com menor renda média pessoal entre os moradores.
O Índice de Desenvolvimento Humano (IDH) daquela região não passa de 0,139. Se fosse um país, estaria ocupando a última colocação do ranking formulado pela Organização das Nações Unidas (ONU).
Em combate ao cenário adverso, nos últimos anos a comunidade tem recebido projetos de urbanização de favelas, especialmente das localizadas nas margens do Rio Maranguapinho.
Atualmente, mais de 40 mil pessoas são moradoras do Genibaú. O bairro possui um dos maiores adensamentos populares dentre todos os bairros da Capital.

A origem do Genibaú está ligada às comunidades pobres que se formaram nos arredores do Rio Maranguapinho, na década de 1980.
Após anos lutando por melhor infraestrutura, as famílias do Genibaú receberam o reconhecimento do bairro e a chegada de equipamentos públicos de educação e saúde, mesmo que alguns déficits de infraestrutura persistam.
DADOS GERAIS
Localização: Regional 11 / Território 37 - Faz divisa com os bairros Conjunto Ceará I, Conjunto Ceará II, Granja Portugal, Bonsucesso, João XXIII, Henrique Jorge, Autran Nunes e Antônio Bezerra.
População estimada: 40.336

População Feminina: 20.805
População Masculina: 19.531
Densidade (hab/km²): 18.691,38
Área (km²): 2,16
356 NOSSOS BAIRROS | NOSSA FORTALEZA
AURÉLIO ALVES
Perímetro (km): 9.361,92
Avenidas principais: Avenida Genibaú, Avenida Senador Fernandes Távora, Rua José Mendonça.
Feiras livres: Feira do Genibaú (Avenida Senador Fernandes Távora, entre a rua José mendonça e a rua da Paz), Feira do João XXIII 2 (Rua Waldemar Holanda), Feira do Henrique Jorge 2 (Avenida Genibaú, entre a ponte sobre o Rio Maranguapinho e a rua Moçambique).
IDH: 0,139
ATIVIDADE SOCIAL
Instituto Nabor Genibaú - Entidade de assistência social criada a partir da iniciativa da Convenção das Igrejas Batistas Unidas do Ceará – CIBUC. A Organização sem fins lucrativos atua no bairro Genibaú e tem por objetivo prestar assessoramento a outras entidades e projetos também de assistência social, executar projetos de desenvolvimento de pessoas e comunidades no Ceará e atuar na defesa e garantia de direitos das crianças e adolescentes.
ESPORTES
Areninha Genibaú - Campo do Sevilha (Rua José Mendonça S/N).
IGREJAS
Igreja Universal do Reino de Deus (Rua José Mendonça, 221), Igreja de Jesus Cristo dos Santos dos Últimos Dias - Ala Genibaú (Av. Genibaú, 183), Congregação Cristã no Brasil - Genibaú (Rua das Pedrinhas, 1211), Capela São Francisco de Assis - Genibaú (Av. F, 502), Paróquia Nossa Senhora de Fátima (Rua José Mendonça, 410), Capela de São José (R. Ricardo Pontes, 407), Capela Nossa Senhora Aparecida (R. Quintela, 27).
SAÚDE

Postos de Saúde: UAPS José Galba de Araújo 5 (Avenida Sen. Fernandes Távora, 3161), UAPS Ronaldo de Albuquerque Ribeiro (Avenida I, S/N).
MEIO AMBIENTE
Praças: Praça do Genibaú (Av. Senador Fernandes Távora)
Rios ou lagoas: Rio Maranguapinho.
EDUCAÇÃO
Escolas: Creche Semente da Liberdade; Escola Irmã Maria Evanete; CEI Maria Terezinha de Carvalho Holanda; CEI Murilo Gaspar; Escola Murilo Aguiar; Escola Professor Américo Barreira; Escola Manoel Caetano de Souza; Escola João Frederico Ferreira Gomes.
CULTURA
Centros culturais: Vila Olímpica Genibaú (Rua 30 de Maio, 44), Coletivo Malombe.
SEGURANÇA
AIS: 2
TRANSPORTE PÚBLICO
Ônibus: Conjunto Ceará/Antônio Bezerra I; Conjunto Ceará/Papicu/Montese; Genibaú/Centro; Conjunto Ceará/Centro
Metrô: Linha Oeste Estação São Miguel
ÁREA EDIFICADA (M2)
Inscrições Residenciais: 861
Inscrições Comerciais: 464
Inscrições de Prestação de Serviços: 3
Inscrições Industriais: 1
Assentamentos precários: Conjunto Habitacional no Genibaú; Favela 184; Favela da Mangueira; Boa Esperança; Cachoeira Dourada; Rua Alves Batista (Favela da Mangueira); KM 10; Comunidade Canal da Moçambique; Dias Monteiro/Olaria e Nova Jerusalém; Pantana III; Favela João XXIII (Rua Donzela); Área Verde I (Conj. Ceará); Comunidade do Capim.
357 REGIONAL 11
HENRIQUE JORGE
O Henrique Jorge foi parte do município de Parangaba, sendo antes chamado de Casas Populares, e está localizado onde ficava a estrada que levava ao Barro Vermelho (hoje Antônio Bezerra).
A mudança de nome ocorreu para homenagear o conceituado maestro, que posteriormente fundou a Escola de Música Alberto Nepomuceno. Henrique Jorge também era pai do governador Paulo Sarasate.
A região tinha poucas casas na década de 1950, mas tinha uma moradora especial. Rachel de Queiroz cresceu na região e foi lá que escreveu “O Quinze”. A casa, inclusive, é tombada como patrimônio histórico.

Hoje, o Henrique Jorge é autossuficiente, sendo repleto de espaços de lazer e escolas, além de se destacar pelo comércio e pelas indústrias de tecido e roupas.
DADOS GERAIS
População estimada: 26.994

População Feminina: 14.388
População Masculina: 12.606
Densidade (hab/km²): 13.871,53
Área total: 1,95
358 NOSSOS BAIRROS | NOSSA FORTALEZA
Praça do Henrique Jorge, bairro onde cresceu a escritora Rachel de Queiroz
FERNANDA BARROS
Perímetro (km): 7.114,54
Localização: Regional 11, Território 37, na parte oeste de Fortaleza. Faz divisa com os bairros João XVIII, Jóquei Clube, Pici, Dom Lustosa, Autran Nunes, Genibaú
Avenidas principais: Avenida Senador Fernandes Távora, Avenida Porto Velho.
Feiras livres: Feira do Henrique Jorge (às quintas, na Rua Porto Velho)
IDH (IBGE): 0,341
ATIVIDADE SOCIAL
Instituto Maria da Hora - O Instituto nasceu do trabalho social desenvolvido pela senhora Maria José Paiva da Hora, conhecida como Maria da Hora, uma mulher que, embora sem muito estudo, acreditou no sonho de que podia mudar a realidade de muitas pessoas.
Atualmente, o Instituto Maria da Hora conta com uma equipe multidisciplinar que constrói, desenvolve e gerencia projetos sociais com o propósito de garantir inclusão social para segmentos vulneráveis e/ou em situação de violação de direitos.
IGREJAS
Paróquia Imaculado Coração de Maria; Igreja de Nossa Senhora Aparecida; Igreja Batista; Igreja de São João Bosco.
SAÚDE

Postos de Saúde: Posto de Saúde José Sobreira Amorim; Posto de Saúde Senador Fernandes Távora
PRAÇAS
Praça Dom Bosco, Praça Henrique Jorge.
MEIO AMBIENTE
Rios ou lagoas: Rio Maranguapinho
EDUCAÇÃO
EEFM João Paulo II; E.E.E.M. Mariano Martins; CEI Prof. José Sobreira de Amorim; Escola Especial Centro De Convivência Mão Amiga; EMEIEF Santa Maria.
CULTURA
Patrimônio histórico (bens tombados): Casa Rachel de Queiroz
SEGURANÇA
AIS: 6
TRANSPORTE PÚBLICO
Ônibus: Antônio Bezerra/Lagoa/Unifor; Corujão/Av. Paranjana I; Corujão/Av. Paranjana II; Cj Ceará/Lagoa/ Fernandes Távora; Cj Ceará/Papicu/Montese; Grande Circular I; Grande Circular II; Corujão/Grande Circular I; Corujão/Grande Circular II; Antônio Bezerra/Parangaba; Antônio Bezerra/Messejana/Perimetral; Antônio Bezerra/Siqueira; Antônio Bezerra/Lagoa/Parangaba; João Arruda/Antônio Bezerra; Genibaú/Centro; Av. Lineu Machado/SP1; Jóquei/Bonsucesso; Genibaú/ Lagoa; Parque Universitários/Lagoa; Cj Ceará/Centro; Santos Dumont/Perimetral; Granja Lisboa/Goiabeiras
ÁREA EDIFICADA (M2)
Inscrições Residenciais: 5.797
Inscrições Comerciais: 1.200
Inscrições de Prestação de Serviços: 41
Inscrições Industriais: 9
Assentamentos precários: Resplendor; Liga Centro Esportivo Tocantins (Rua Cidade); Chuí; Rua Porto Alegre, Resplendor; Eurico Medina.
359 REGIONAL 11
JOÃO XXIII
O bairro João XXIII é localizado na parte Oeste de Fortaleza e faz divisa com os bairros Henrique Jorge, Jóquei Clube, Bonsucesso e Genibaú.
A população residente do bairro ultrapassa 18 mil moradores. E a influência do bairro na vizinhança é grande. Por exemplo, a Praça João XXIII não fica nos limites do bairro, assim como o CRAS João XXIII, que ficam no vizinho Jóquei Clube.
Atualmente, funciona no bairro o Centro Universitário da Grande Fortaleza (Unigrande). Evoluções urbanísticas também foram inauguradas nos últimos anos, como um processo de revitalização das proximidades do Rio Maranguapinho, além da inauguração da Areninha e Ecoponto na Praça da Juventude.

A formação do bairro João XXIII remonta ao fim da década de 1950, quando poucas famílias habitavam a comunidade conhecida como Santa Fé. Até aquela época, eram comuns naquela região a presença de sítios, que
com o passar dos anos foram virando loteamentos. A mudança para o nome atual veio numa homenagem ao Papa João XXIII, falecido em 1963.
E essa troca ocorreu de forma a melhorar a imagem de quem morava na região. Moradores antigos contam que, por aquela comunidade ser distante do Centro de Fortaleza e ter poucos moradores, eles ficaram conhecidos como os “índios de Santa Fé”.
O nome do bairro mudou então para João XXIII, que ficou conhecido como o “Papa bom” durante seu curto pontificado de cinco anos.
DADOS GERAIS
Localização: Regional 11 / Território 37 - Faz divisa com os bairros Henrique Jorge, Jóquei Clube, Bonsucesso e Genibaú.
População estimada: 18.398

360 NOSSOS BAIRROS | NOSSA FORTALEZA
Areninha Praça da Juventude João XXIII foi entregue à população em dezembro de 2021
FERNANDA BARROS
População Feminina: 9.737
População Masculina: 8.661

Densidade (hab/km²): 15.631,27
Área (km²): 1,18
Perímetro (km): 5.425,50
Avenidas ´principais: Avenida Lineu Machado, Avenida Porto Velho, Rua Júlio Braga e Rua Professor Heribaldo Costa.
Feiras livres: Feira do João XXIII; Feira do Henrique Jorge 2
Ecoponto: Ecoponto João XXIII
IDH: 0,284
ATIVIDADE SOCIAL
Quadrilha Junina Siará de Tradição - O grupo junino surgiu em 2009 como um festejo junino onde se dançava quadrilha improvisada com músicas do cantor Luiz Gonzaga. Inicialmente, a quadrilha junina era formada por um grupo de amigos movidos pelo desejo de lazer, cultura, arte e dança.
A partir desta brincadeira, formou-se um grupo de cultura junina, denominada de Quadrilha Junina Siará de Tradição do João XXIII, que resiste até hoje em suas atividades juninas com mais de 40 jovens e adolescentes com idades entre 16 a 28 anos.
ESPORTES
Areninha Praça da Juventude
IGREJAS
Igreja de São Francisco de Assis; Discipulado Canaã João XXIII; Congregação Cristã no Brasil; Igreja Adventista Do Sétimo Dia João XXIII
SAÚDE
Postos de Saúde João XXIII; Laboratório Somma
PRAÇAS
Praça da Juventude; Praça José Carlos Gaspar
MEIO AMBIENTE
Rios ou lagoas: Rio Maranguapinho
EDUCAÇÃO
Creche Irmã Fábia; Creche Tia Eurice; ETP Dona Dagmar Gentil; EEF São José do Pici das Pedreiras
CULTURA
Centros culturais: Grupo de Arte e Cultura Parresia; Quadra Poliesportiva Ebenézer
SEGURANÇA
AIS: 6
TRANSPORTE PÚBLICO
Ônibus: Barra Do Ceará/Ceasa; João XXIII/Lagoa; Conjunto Ceará/Bonsucesso/Centro; Conjunto Ceará/ Bonsucesso/Centro (Topic)
ÁREA EDIFICADA (M2)
Inscrições Residenciais: 3.310
Inscrições Comerciais: 509
Inscrições de Prestação de Serviços: 17
Inscrições Industriais: 5
Assentamentos precários: Favela Eurico Medina; Chuí; Dias Monteiro/Olaria e Nova Jerusalém; Travessa Pedro Araujo; Favela João XXIII (Rua Donzela); Parque São Luís; Pedreira/Riacho das Pedras.
361 REGIONAL 11
JÓQUEI CLUBE

O Jóquei Clube concentra atualmente mais de 19 mil moradores e é cortado por avenidas como a Senador Fernandes Távora, Carneiro de Mendonça e Américo Barreira.
O bairro Jóquei Clube tem o maior Índice de Desenvolvimento Humano (IDH) dos bairros da Regional 11, 0,406. Nesta comunidade ficam localizados ainda o North Shopping Jóquei e o Centro Universitário Estácio.

A história dessa comunidade, parecida com a de bairros vizinhos, está relacionada aos grandes sítios que foram sendo ocupados. Acredita-se ainda que naquela região existia, por volta de 1800, um cemitério dos índios Marupiara.
A formação do bairro tem como protagonista, no início da década de 1930, um imigrante alemão, que comprou terras na região da Parangaba, mas que assumiu a hipoteca de um vizinho e trocou de propriedade.
O nome do sítio passou a ser Glück-alf, expressão alemã que quer dizer “Feliz regresso”. Foi essa propriedade que deu origem ao bairro - atualmente é o Centro Universitário Estácio.
Por ser alemão, esse imigrante foi perseguido pelas autoridades militares na Segunda Guerra Mundial e precisou vender a área. Lá, anos depois, foi construído o Jockey Club Cearense.
DADOS GERAIS
Localização: Regional 11 / Território 37 - Faz divisa com os bairros Parangaba, Demócrito Rocha, Pici, Henrique Jorge, João XXIII e Bonsucesso.
População estimada: 19.331
População Feminina: 10.464
362 NOSSOS BAIRROS | NOSSA FORTALEZA
North Shopping Jóquei fica na Avenida Lineu Machado
AURÉLIO ALVES
População Masculina: 8.867

Densidade (hab/km²): 11.364,49
Área (km²): 1,70
Perímetro (km): 5.988,96
Avenidas principais: Avenida Senador Fernandes Távora, Avenida Carneiro de Mendonça, Avenida Américo Barreira.
Ecoponto: Ecoponto Jóquei Clube (Rua Perdigão de Oliveira, 971 - Esquina com a Rua Silveira Filho).
IDH: 0,406
ATIVIDADE SOCIAL
Centro Cearense de Idiomas (CCI) - É uma ação voltada para expandir o universo curricular para além das unidades escolares e proporcionar aprimoramento de novas formas de expressão linguística aos estudantes. A união, de responsabilidade do Governo do Estado, funciona no North Shopping Jóquei e tem o intuito de fortalecer o currículo do ensino médio da rede pública estadual no que concerne à aprendizagem de uma língua estrangeira moderna (Inglês e Espanhol).
SAÚDE
Postos de Saúde: UAPS Waldemar Alcantara (Rua Silveira Filho, 903)
Hospitais: Hospital Infantil de Fortaleza (Rua Lineu Machado, 150), Hospital e Maternidade Dra. Zilda Arns Neumann - Hospital da Mulher (Avenida Lineu Machado, 145).
Policlínicas: Policlínica Dr. Lusmar Veras (Avenida Carneiro de Mendonça, 1583).
MEIO AMBIENTE
Praças: Praça Ney Rebouças - Praça do Fortaleza, Pracinha da Rua Jockey Club com Estrada do Pici, Praça João XXIII.
Parques: ECOPOINT Parque Ambiental e Zoológico (Av. Senador Fernandes Távora, 387)
EDUCAÇÃO
Escolas: Escola de Tempo Parcial Presidente Kennedy (Rua Des. Luís Paulino, 109).
CULTURA
Cinépolis North Shopping Jóquei; Centro Cearense De Idiomas
SEGURANÇA
Juizados: Conselho Tutelar III (Rua Silveira Filho, 935), CRAS João XXIII (Rua Visconde Decauípe, 200).
AIS: AIS 6
TRANSPORTE PÚBLICO
Ônibus: Antônio Bezerra / Lagoa / Unifor; Antônio Bezerra / Parangaba; Av. Lineu Machado / Sp1.
ÁREA EDIFICADA (M2)
Inscrições Residenciais: 5.988
Inscrições Comerciais: 1.203
Inscrições de Prestação de Serviços: 39
Inscrições Industriais: 4
Assentamentos precários: Favela da Fumaça - Planalto Pici; Rua Mozart Firmeza; Rua Paulo Fortim.
363 REGIONAL 11
PANAMERICANO
O Panamericano é um pequeno bairro localizado na parte Leste de Fortaleza. Surgiu durante a Segunda Guerra Mundial, quando os estadunidenses sediados em Fortaleza se estabeleceram no local e construíram um campo de pouso e demais estruturas.

Ao final dos anos 1950, após o fim da guerra, famílias começaram a ocupar o local. O nome Panamericano foi inspirado na base americana instalada nas imediações.
O bairro hoje possui fácil acesso até a parte central da Cidade. Uma curiosidade é que várias ruas do local possuem nomes de estados brasileiros.
DADOS GERAIS
População estimada: 8.815

População Feminina: 4.750
População Masculina: 4.065
Densidade (hab/km²): 15.969,20
Área total: 0,55
Perímetro (km): 3.216,44
Localização: Regional 11, Território 36, na parte oeste de Fortaleza. Faz divisa com os bairros Bela Vista, Couto Fernandes, Demócrito Rocha e Pici
Avenidas principais: Avenida Américo Barreira.
IDH (IBGE): 0,373
364 NOSSOS BAIRROS | NOSSA FORTALEZA
MESQUITA
Praça Mauá tem uma Areninha e a sede da Célula de Proteção Comunitária Panamericano
THAIS
ESPORTE
Areninha Panamericano (Praça Mauá)
ATIVIDADE SOCIAL
Associação Comunitária É tempo de Vencer (ACTV)
- É uma ONG sem fins lucrativos que tem como missão promover uma série de ações voltadas para o progresso social dos moradores das comunidades do bairro Panamericano e adjacências

IGREJA
Igreja de São Pio X;
SAÚDE

Posto de Saúde Oliveira Pombo
PRAÇAS
Praça Mauá, Praça Pio X
EDUCAÇÃO
EEFM Anísio Teixeira, EMEIEF José Batista de Oliveira;
CULTURA
Bibliotecas: Biblioteca Comunitária Papoco de Ideias
SEGURANÇA
Delegacias: Delegacia de Polícia Civil - 11° Distrito Policial; Célula de Proteção Comunitária Panamericano
AIS: 5
TRANPORTE PÚBLICO
Ônibus: Lagoa/Aldeota; Siqueira/Centro/Expresso; Bela Vista/Lagoa; Bela Vista/Centro; Lagoa/Demócrito Rocha/Centro; Genibaú/Centro; Siqueira/José Bastos/ Centro; Parangaba/José Bastos/Centro; Jardim Jatobá/Centro; Cj Ceará/Centro; Granja Lisboa/Goiabeiras
ÁREA EDIFICADA (M2)
Inscrições Residenciais: 2.225
Inscrições Comerciais: 375
Inscrições de Prestação de Serviços: 12
Inscrições Industriais: 7
365 REGIONAL 11
PICI
O Pici sedia o maior campus da Universidade Federal do Ceará (UFC), que ocupa cerca de 50% da área do local. O nome vem de Sítio do Pici, que foi propriedade do pai de Rachel de Queiroz e estava localizado às margens do Rio Cachoeirinha.
O nome do bairro é apelido do Fortaleza Esporte Clube, que é chamado pelos torcedores de Leão do Pici. No entanto, a sede do Tricolor está localizada no bairro ao lado, o Jóquei Clube.
O bairro também tem grande atividade comercial e cultural, tendo inclusive um Cuca.
DADOS GERAIS
População estimada: 42.494
População Feminina: 22.164
População Masculina: 20.330
Densidade (hab/km²): 11.362,03
Área total: 3,74
Perímetro (km): 8.042,00
Localização: Regional 11, Território 36, na parte oeste de Fortaleza. Faz divisa com os bairros Padre Andrade, Presidente Kennedy, Parquelândia, Amadeu Furtado, Bela Vista, Panamericano, Demócrito Rocha, Jóquei Clube, Henrique Jorge e Dom Lustosa.
Avenidas principais: Avenida Mister Hull, Avenida Humberto Monte, Rua Coronel Matos Dourado.
Feiras livres: Feira do Pici (às quartas, na Rua Alagoas com Tenente Lauro)
Ecopontos: Ecoponto Pici (R. Pernambuco, 1622-1716)
IDH (IBGE): 0,219
ESPORTE
Areninha Campo do Pici (Avenida Coronel Matos Dourado com R. Franco Rocha)
ATIVIDADE SOCIAL

Instituto de Cultura, Arte, Ciência e Esporte (Instituto Cuca Pici) - Organização social, sem fins lucrativos, fundada em novembro de 2008 para desenvolver e promover atividades de formação, lazer e entretenimento, prioritariamente, para jovens de 15 a 29 anos.
O Cuca Pici possui área superior a 16 mil m² e conta com piscina, teatro, auditório, coworking, salas temáticas, biblioteca, quadra poliesportiva etc.
IGREJA
Paróquia Santo Antonio de Pádua, Igreja do Evangelho Pleno - IEP PICI, Igreja de São José.
SAÚDE
Postos de Saúde: Posto de Saúde Dr. Gilmário Mourão Teixeira, UAPS Francisco Pereira De Almeida, Posto de Saúde César Cals de Oliveira Filho.
PRAÇAS
Praça Prisco Bezerra; Praça Dr. Raimundo Maciel De Brito.
MEIO AMBIENTE
Rios ou lagoas: Açude da Agronomia
EDUCAÇÃO
Escola Municipal Professora Maria Liduína Corrêa Leite; EEMTI Antonieta Siqueira; EMEIEF José Bonifácio de Sousa; EMEIF Adroaldo Teixeira Castelo; EEEP Júlia Giffoni.
366 NOSSOS BAIRROS | NOSSA FORTALEZA
CULTURA
Biblioteca universitária da UFC; Museu da Boneca de Pano; Instituto de Cultura e Arte - ICA UFC
SEGURANÇA
AIS: 6
TRANSPORTE PÚBLICO
Ônibus: Campus do Pici; Antônio Bezerra/Lagoa/Unifor; Antônio Bezerra/Messejana; Antônio Bezerra/Papicu; Corujão/Av. Paranjana II; Cj Ceará/Papicu/Montese; Grande Circular II; Corujão/Grande Circular II; Siqueira/Papicu/Washington Soares; Antônio Bezerra/Mucuripe; Antônio Bezerra/Parangaba; Campus do Pici/Unifor; Cj Ceará/Aldeota/Papicu; Antônio Bezerra/Náutico; Corujão/Montese; Antônio Bezerra/Papicu/Praia de Iracema; Bezerra de Menezes/Santos Dumont; Antônio Bezerra/Albert Sabin; Antônio Bezerra/
Siqueira; Antônio Bezerra/Lagoa/Parangaba; Antônio Bezerra/Centro/BRT; Antônio Bezerra/Papicu/Antônio Sales; João Arruda/Antônio Bezerra; Antônio Bezerra/Parangaba/Montese; Bela Vista/Lagoa; Bela Vista/Centro; Genibaú/Centro; Antônio Bezerra/Jovita Feitosa/Centro; Parque Universitários/Lagoa; Paupina/Pici; Cj Ceará/Centro; Santos Dumont/Perimetral; Granja Lisboa/Goiabeiras; Vila Velha/Centro; Bezerra de Menezes/Washington Soares
ÁREA EDIFICADA (M2)
Inscrições Residenciais: 4.083
Inscrições Comerciais: 1.303

Inscrições de Prestação de Serviços: 12
Inscrições Industriais: 0
Assentamentos precários: Nossa Senhora da Penha; Papoco; Fumaça - Planalto Pici; Entrada da Lua; Futuro melhor- Planalto Pici; Ocupação da rua Uruguaiana; Rua Cons. Araujo Lima; Conjunto Planalto Pici.

367 REGIONAL 11
AURÉLIO ALVES
O Campus do Pici é o maior da Universidade Federal do Ceará
REGIONAL 12






















A parte mais turística de Fortaleza está nesta regional: os prédios históricos e maior corredor comercial da Cidade no bairro Centro, bem como a orla da Praia de Iracema com a Ponte dos Ingleses e o espigão da João Cordeiro




 Relógio da Praça do Ferreira, no bairro Centro
Relógio da Praça do Ferreira, no bairro Centro



























GUIA DA REGIONAL 12


370 NOSSOS BAIRROS | NOSSA FORTALEZA
FCO FONTENELE
Tradicional relógio da Coluna da Hora, na Praça do Ferreira, é um dos inúmeros pontos turísticos do Centro de Fortaleza
BAIRROS
Centro
Moura Brasil
Praia de Iracema
SECRETARIA REGIONAL 12
Endereço: R. Major Facundo, 907 – Centro
Fortaleza - CE, 60025-100
Telefone: (85) 3254 3427
CONTATOS IMPORTANTES
GABINETE DO SECRETÁRIO
Telefone: (85) 3252.3081
RECEPÇÃO
Telefone: (85) 3254.3427
OUVIDORIA
Telefone: (85) 3226.5059

ACOLHIMENTO
Telefone: (85) 3254.3427
E-mail: acolhimento@sr12.fortaleza.ce.gov.br
AGEFIS
Telefone: (85) 3254 7227
COORDENAÇÃO DE INFRAESTRUTURA
Telefone: (85) 3105 1310
CONSERVAÇÃO E SERVIÇOS PÚBLICOS
Telefone: (85) 3105 1310
Secretário: Júlio Fernandes Santos
Endereço: julio.santos@sr12.fortaleza.ce.gov.br
Formado em Administração de Empresas, pós-graduado em Direito Público e servidor público de carreira. É fiscal de Atividades Urbanas e Vigilância Sanitária desde 2010. De janeiro de 2013 até abril de 2015, passou pelos cargos de assistente técnico de fiscalização, gerente de Controle Urbano e coordenador de Fiscalização Integrada na Secretaria Regional VI.
Compôs a equipe gestora que implantou e consolidou a Agência de Fiscalização de Fortaleza (Agefis), criada em 2014. Exerceu a função de diretor de Operações do órgão e, entre abril de 2018 e dezembro de 2020, foi superintendente da Agefis.

371 REGIONAL 12
CENTRO
Um dos bairros de maior área da Capital, o Centro possui população estimada em mais de 28,5 mil moradores.
Quem vive no bairro tem acesso a diversos serviços, pois o Centro é o principal corredor comercial de Fortaleza com suas lojas de rua, feiras e shoppings. Também ficam nessa região alguns dos principais hospitais da Cidade, além da oferta de educação, lazer e cultura.
Dentre os prédios que compõem o patrimônio histórico de Fortaleza, a maioria fica localizado no Centro, como é o caso da Santa Casa de Misericórdia, do Palacete Ceará - Caixa Econômica Federal e do Cine São Luiz.
Nos últimos anos, o Centro passou por uma revitalização e ganhou novos equipamentos culturais como o Complexo Cultural Estação das Artes.
É no Centro onde as malhas de transporte público se encontram: as linhas Leste e Sul do Metrofor, além de dezenas de linhas de ônibus de grande movimentação de passageiros.
Esse movimento em torno do Centro de Fortaleza remonta a meados do século XVI, com a ocupação holandesa e a fundação do Forte de Schoonemborch, por Matias Beck. Poucos anos depois, os portugueses retomaram o controle do território, que passou a ser chamado de Fortaleza de Nossa Senhora da Assunção, dando origem à vila ao redor do que hoje é a 10ª Região Militar.
O processo de urbanização da vila foi feito naqueles arredores, com a inauguração da Praça General Tibúrcio - Praça dos Leões, da Igreja do Rosário, da Assembleia Provincial (hoje Museu do Ceará) e do Palácio da Luz (atualmente Academia Cearense de Letras).
DADOS GERAIS
Localização: Regional 12 / Território 1 - Faz divisa com os bairros Praia de Iracema, Moura Brasil, Jacarecanga, Farias Brito, Benfica, José Bonifácio, Joaquim Távora, Aldeota e Meireles.
População estimada: 28.538
População Feminina: 15.565

População Masculina: 12.973
Densidade (hab/km²): 5.832,41
Área (km²): 4,89
Perímetro (km): 13.060,46
Avenidas principais: Avenida Dom Manuel, Avenida Imperador, Avenida Santos Dumont, Avenida Monsenhor Tabosa, Avenida Tristão Gonçalves, Rua General Sampaio, Rua São Paulo, Rua Pessoa Anta.
Ecopontos: Ecoponto Centro (Avenida Alberto Nepomuceno, 144 - Esquina com Travessa Icó), Ecoponto Centro II (Guilherme Rocha, 1427), Ecoponto São Sebastião (Rua Clarindo de Queiroz, em frente ao número 1596).
Feiras: Feira do Mercado dos Pinhões (Praça Visconde de Pelotas s/n).
HISTÓRIA DO BAIRRO
Praça General Tibúrcio (Praça dos Leões) - Localizada no cruzamento das ruas São Paulo e Sena Madureira, é um dos patrimônios históricos do Centro de Fortaleza e está ligada diretamente à formação do Município.
Quando foi inaugurada, a praça tinha pouco glamour, sendo um largo areal em frente ao Palácio do Governo e da Igreja do Rosário. Em 1847, após fortes chuvas em Fortaleza, foram necessárias obras no espaço por causa de grandes fendas no largo. Ali então foi construída uma muralha para dar sustentação ao aterro, assim como pilares e escadarias que dão acesso à Rua de Baixo.
O nome General Tibúrcio foi escolhido via resolução da Câmara em homenagem ao general cearense que participou da Guerra do Paraguai. Foi também erguida uma estátua na praça em homenagem à figura heróica, sendo o primeiro monumento do tipo erguido em Fortaleza.
372 NOSSOS BAIRROS | NOSSA FORTALEZA
Nova reforma no início do século XIX permitiu a instalação de jarros bronzeados e as estátuas dos leões. Anos depois também foi instalada uma estátua em tamanho real da escritora Rachel de Queiroz, sentada em um dos bancos da praça.
IDH: 0,557
ATIVIDADE SOCIAL

O Pequeno Nazareno - É uma organização que tem como causa o engajamento e luta por um mundo melhor para crianças e adolescentes em situação de rua e suas famílias. A iniciativa surgiu em Recife, em 1997, a partir de Bernd Josef Rosemeyer, que veio da Alemanha para ingressar na Ordem dos Franciscanos no Nordeste e presenciou o dia a dia de crianças de rua no Brasil.
IGREJAS
Catedral Metropolitana de Fortaleza; Igreja do Pequeno Grande; Santuário Sagrado Coração de Jesus; Igreja do Rosário dos Pretos; Igreja do Patrocínio; Igreja São Bernardo; Igreja de Nossa Senhora do Carmo; Igreja Nossa Senhora dos Navegantes; Santuário Arquidiocesano de Adoração Paróquia São Benedito; ADBVAssembléia de Deus; Igreja Universal - Templo Maior; Igreja Internacional da Graça de Deus; Igreja Adventista Central de Fortaleza; Igreja Evangélica Assembleia de Deus Templo Central; Igreja Mundial do Poder de Deus

MERCADOS PÚBLICOS
Mercado Central de Fortaleza ; Feira do Buraco da Gia; Feira da Madrugada de Fortaleza; Feira da Praça José de Alencar; Mercado São Sebastião
373 REGIONAL 12
FCO FONTENELE
Fachada externa do Theatro José de Alencar
SAÚDE
Postos de Saúde: PS Paulo Marcelo Rodrigues
Hospitais: Instituto Doutor José Frota; Hospital Geral Dr. Cesar Cals ; Santa Casa de Misericórdia de Fortaleza; Hospital São Camilo; Hospital e Maternidade
Eugênia Pinheiro; Hospital Luís França
Policlínicas: Centro de Saúde Dona Libânia ; CEOCentro Especializado de Odontologia
MEIO AMBIENTE
Praças: Praça Capistrano de Abreu; Praça Pajeú - CDL; Praça dos Mártires; Praça José de Alencar; Praça Paula Pessoa; Praça da Estação; Praça Gustavo Barroso; Praça Pelotas - Praça do Mercado dos Pinhões; Largo Dom Lustosa; Praça da Sé; Praça Waldemar Falcão; Praça do Ferreira; Praça General Tibúrcio - Praça dos Leões; Praça dos Voluntários; Praça da Polícia
Parques: Parque da Liberdade Fortaleza - Parque das Crianças; Parque Pajeú - Palácio do Bispo
Rios ou lagoas: Lago do Amor, Riacho Pajeú.
EDUCAÇÃO
Escolas: EEFM Visconde do Rio Branco; EEFM Clóvis Beviláqua; Colégio Estadual Justiniano de Serpa ; CEJA Professor Gilmar Maia de Sousa; Escola Nossa Senhora Aparecida; Colégio Estadual Liceu do Ceará
CULTURA
Bibliotecas: Biblioteca Pública Cearense

Cinemas: Cine São Luiz (Rua Major Facundo, 500)
Museus: Museu da Cultura Cearense
Teatros: Theatro José de Alencar; Teatro Municipal São José; Caixa Cultural Fortaleza; Teatro Carlos Câmara
Centros culturais: Porto Dragão; Centro Cultural Banco do Nordeste; Vila das Artes; Sobrado Dr. José Lourenço; Centro Dragão do Mar de Arte e Cultura, Complexo Cultural Estação das Artes.
PATRIMÔNIO HISTÓRICO
Bens tombados: Teatro São José; Parque da Liberdade - Cidade da Criança; Palácio João Brígido; Bosque do Pajeú; Escola Jesus Maria José; Casa do Barão de Camocim; Mercado dos Pinhões; Santa Casa de Misericórdia; Pavimentação da Rua José Avelino ; Farmácia Oswaldo Cruz; Colégio Marista Cearense; Passeio Público; Cine São Luiz; Edifício Antônio Gomes Guimarães - Prédio da associação comercial; Palacete Carvalho Mota; Assembleia Provincial - Museu do Ceará; Galpões da REFFESA; Sobrado Dr. José Lourenço ; Sociedade União Cearense; Banco Frota Gentil; Antiga Escola Normal; Solar Fernandes Vieira; Praça General Tibúrcio - Praça dos Leões; Caixa Econômica Federal - Palacete Ceará; Estação Ferroviária Dr. João Felipe; Palácio da Luz; Igreja Nossa Senhora do Rosário ; Centro de Turismo - Antiga Cadeia Pública; Secretaria da Fazenda
Cemitérios: Cemitério São João Batista
SEGURANÇA
Delegacias: Delegacia de Roubos e Furtos; 2ª Cia de Motos (BPRAIO); Batalhão de Choque; Delegacia de Acidentes e Delitos de Trânsito (DADT); 34° Distrito Policial; Delegacia Geral da Polícia Civil; Delegacia de Combate aos Crimes Contra a Ordem Tributária; Delegacia de Narcóticos; Divisão de Proteção ao Estudante (Dipre)
Bombeiros: Quartel Central do Corpo de Bombeiros Militar do Estado do Ceará
Juizados: Conselho Tutelar I; CRAS Jacarecanga; Plantão do Conselho Tutelar de Fortaleza; 13ª Unidade do Juizado Especial de Fortaleza; Justiça Federal no Ceará - Fórum Presidente Castello Branco
AIS: AIS 4
TRANSPORTE PÚBLICO
Ônibus: Aguanambi/ Rodoviária Ii; Antônio Bezerra/ Francisco Sá/Papicu; Bezerra De Menezes/Santos Dumont; Siqueira/Centro/Expresso; Siqueira/José Bastos/Centro; Conjunto Ceará/Centro; Parangaba/ João Pessoa/Centro; Messejana/Centro/Expresso BR
374 NOSSOS BAIRROS | NOSSA FORTALEZA
116; Cidade 2000/Centro; Dom Luís/Papicu/Centro; Varjota/Centro; Meireles/Centro; Caça E Pesca/Serviluz/Centro; Castelo Encantado/Centro.
Metrô: Linha Sul Estação Subterrânea Chico da Silva; Linha Sul Estação São Benedito; Linha Sul Estação Subterrânea José de Alencar ; Linha Oeste Estação Moura Brasil
ÁREA EDIFICADA (M2)
Inscrições Residenciais: 11.895
Inscrições Comerciais: 19.014

Inscrições de Prestação de Serviços: 800
Inscrições Industriais: 21
Assentamentos precários: Cortiços nas ruas Itatira, 27; Antônio Pompeu, 424; Agapito dos Santos, 622; Padre Ibiapina, 1313 e 1323; Conselheira Estelita, 255; Tereza Cristina, 253 e 261; Tereza Cristina, 348; Tereza Cristina, 37; Tereza Cristina, 542; Tereza Cristina, 658; Padre Nazaré, 1021 e 1029; São Paulo, 956, 968, 1029 e 117’; Senador Alencar, 902, 903 e 907; Guilherme Rocha, 1052’, Oto de Alencar, 27; Agapito dos Santos, 195; Padre Mororó, 666; Liberato Barroso, 1312 e 1320; Princesa Isabel, 570 e 571; 25 de Março, 307, 461, 483 e 895; Rodrigues Júnior, 66, Teresa Cristina, 58; Avenida Imperador, 104, 112, 646 e 660; Avenida Visconde do Rio Branco, 1332. Favela da Graviola, Comunidade Padre Cícero (Rua Padre Mororó), Poço da Draga, Arraial Moura Brasil, Favela São Pedro.

375 REGIONAL 12
Catedral Metropolitana de Fortaleza
FCO FONTENELE
MOURA BRASIL
A origem do Moura Brasil está muito ligada à grande seca de 1932, que obrigou milhares de sertanejos a migrarem para a Capital. A formação dessa comunidade se deu através do esforço das autoridades da época em alojar num só espaço esses chamados retirantes.
Foi assim que se formou um grande “campo de concentração” chamado Arraial Moura Brasil, que era pejorativamente chamado de “curral”. Esse local era vigiado por soldados armados, que impediam que qualquer pessoa pudesse sair do “curral”.
Para os habitantes do local, o governo fornecia alimentação, água e promessas de soluções que demoraram a chegar. Na década seguinte, a situação foi se deteriorando, e a marginalização do bairro piorou, ficando conhecido como ponto de prostituição e considerado um local ermo.
Por muito tempo, a comunidade foi considerada um dos bairros mais pobres de Fortaleza. A história do então Arraial Moura Brasil começou a mudar a partir do processo de urbanização daquela zona da Cidade, com a inauguração da Avenida Presidente Castelo Branco - Leste Oeste, em 1975.
O objetivo desse plano de urbanização era ligar a zona industrial formada na Barra do Ceará até a zona portuária do Mucuripe. A partir desse momento, o agora Moura Brasil recebeu status de bairro.
Atualmente, a comunidade ainda sofre com a pobreza, mas segue como um importante ponto de ligação de Fortaleza, sendo cortado pela linha Oeste do Metrofor.
O bairro abriga o Marina Park Hotel, atualmente palco de grandes festas privadas da Capital. O Moura Brasil ainda sedia a Escola de Gastronomia e Hotelaria do Ceará.
DADOS GERAIS
Localização: Regional 12 / Território 1 - Faz divisa com os bairros Centro e Jacarecanga.
População estimada: 3.765

População Feminina: 1.969
População Masculina: 1.796
Densidade (hab/km²): 8.879,72
Área (km²): 0,42
Perímetro (km): 5.166,13
Avenidas principais: Avenida Pres. Castelo BrancoLeste Oeste.
IDH: 0,285
HISTÓRIA DO BAIRRO
Capela de Santa Teresinha - É considerada a mais antiga construção do bairro. As obras foram iniciadas em 1926 por pescadores que moravam na área até ser inaugurada em 1928. Tombada como patrimônio em 1986 pela Prefeitura de Fortaleza, a construção ficou abandonada entre as décadas de 1990 e 2010 e sofreu com tentativas de demolição. Mas foi abraçada pela comunidade do Moura Brasil, que lutou para que permanecesse de pé e colaborou para a revitalização do espaço.
ATIVIDADE SOCIAL
Projeto Corre pra Vida
IGREJAS
Igreja São Francisco de Assis; Igreja de Santa Edwiges;Capela Patrimonial Santa Terezinha
SAÚDE
Postos de Saúde: UAPS Maria Cirino Souza
376 NOSSOS BAIRROS | NOSSA FORTALEZA
MEIO AMBIENTE
Praças: Praça Santa Edwiges
EDUCAÇÃO
EMEIF Moura Brasil; Centro De Educação Infantil Moura Brasil
CULTURA
Centros culturais: Escola Beneficente de Surf Moura Brasil

PATRIMÔNIO HISTÓRICO
Bens tombados: Capela de Santa Teresinha; Igreja de Santa Edwiges e a Estátua de Santa Edwiges
SEGURANÇA
Perícia Forense do Estado do Ceará; 1ª Companhia de Busca e Salvamento; Centro de Treinamento e Desenvolvimento Humano - CTDH
AIS: AIS 4
TRANSPORTE PÚBLICO
Ônibus: Circular II/Centro; Conjunto Nova Assunção/ Francisco Sá; Jurema; Caça e Pesca/Centro; Vila Velha/Centro
ÁREA EDIFICADA (M2)
Inscrições Residenciais: 984
Inscrições Comerciais: 214

Inscrições de Prestação de Serviços: 4
Inscrições Industriais: 0
Assentamentos precários: Arraial Moura Brasil - Comunidade do Oitão Preto
377 REGIONAL 12
AURÉLIO ALVES
Moura Brasil também forma atletas e praticantes de surf em escolinhas no bairro
PRAIA DE IRACEMA
O bairro Praia de Iracema é um dos mais antigos de Fortaleza e está ligado diretamente à formação da Capital. É vizinho dos bairros Meireles e Centro.
Vizinhança com um dos maiores Índices de Desenvolvimento Humano (IDH) da Capital - 0,720, é um dos bairros com o metro quadrado (m²) mais valorizado de Fortaleza.
Iracema é ainda uma mistura de história e modernidade, uma renovação constante a partir do fervilhar cultural característico.
É no bairro onde ocorrem as grandes celebrações da Cidade, tal qual os shows e queimas de fogos do Réveillon e a festa popular promovida pelos blocos de Carnaval.
O patrimônio cultural do bairro e de Fortaleza está guardado em alguns prédios localizados na Praia de Iracema, como é o caso do Estoril e do Centro Cultural Belchior. Existe ainda a Casa da Cultura Digital de Fortaleza.
Esses espaços fazem parte do grande esforço de revitalização daquela área da Cidade, relembrando seu apelo histórico, como é exemplo do Bar do Mincharia ou o Pirata Bar, que com décadas de Praia de Iracema se mantêm como ícones.
A Ponte dos Ingleses é tombada como patrimônio histórico e sua história se confunde com a do bairro. Muito ligado às suas tradições jangadeiras, o local, habitado por famílias de pescadores, era conhecido como Praia do Peixe.
Somente em 1930 ganhou o atual nome depois da realização de concurso popular promovido por Demócrito Rocha. Praia de Iracema foi o nome escolhido em homenagem à obra de José de Alencar. Com o desenvolvimento de Fortaleza, expansão da periferia
e crescimento populacional, o local passou a ser utilizado para construção de casas de veraneio.

O palacete que hoje é o Estoril é um exemplo claro dessa mudança urbanística. O local foi construído pela família Magalhães Porto e marcou a chegada de grandes famílias burguesas na área.
Na década de 1940, o bairro passou a ser conhecido como reduto da boemia fortalezense e o Estoril foi utilizado como cassino. A Praia de Iracema hoje é um “Bem de Relevante Interesse Cultural” fortalezense, instituído pelo Patrimônio Histórico e Cultural da Secretaria da Cultura de Fortaleza.
A “praia dos amores” sofreu com o avanço do mar decorrente da construção do Porto do Mucuripe. E foi a partir daquela época que a paisagem passou a mudar. Nos idos anos 1950, ainda houve a revitalização da antiga Área Portuária de Fortaleza no que é hoje o Centro Dragão do Mar de Arte e Cultura.
Nos anos 1960 veio o impulso modernista na região com a construção de novos prédios. A mais relevante dessas novas construções foi o Edifício São Pedro, até hoje presente na paisagem do bairro. Funcionava como hotel e residência.
A estreita ligação daquela região da Cidade com a obra indianista é notável. A história conta que quando os holandeses chegaram ao Ceará, pela Praia de Iracema, foram recebidos por indígenas. Potiguares foram os primeiros a terem contato com a frota liderada por Matias Beck, em 1649.
A tradição indígena está marcada na Praia de Iracema com o nome de algumas das principais ruas do bairro, como a Tabajaras, Cariris e Potiguaras.
378 NOSSOS BAIRROS | NOSSA FORTALEZA


379 REGIONAL 12
AURÉLIO ALVES
Espigão da João Cordeiro, na Praia de Iracema
DADOS GERAIS
Localização: Regional 12 / Território 1 - Faz divisa com os bairros Centro e Meireles.
População estimada: 3.130
População Feminina: 1.693
População Masculina: 1.437
Densidade (hab/km²): 5.861,42
Área (km²): 0,53
Perímetro (km): 4.772,18
Avenidas principais: Avenida Almirante Barroso, Avenida Historiador Raimundo Girão, Avenida Beira Mar, Avenida Monsenhor Tabosa, Rua João Cordeiro, Rua dos Tabajaras
IDH: 0,720
HISTÓRIA DO BAIRRO
Ponte dos Ingleses - A história da Ponte dos Ingleses se inicia pelo projeto de Lucas Bicalho, que buscava tornar aquele espaço uma extensão do cais do Porto de Fortaleza, uma espécie de porto-ilha proposto pelo engenheiro Manuel Carneiro de Sousa Bandeira.
A construção começou em 1921 pela empresa inglesa Norton Griffiths Co., para servir de porto para a Cidade em substituição à antiga Ponte Metálica, que ficava ao lado, na altura da Avenida Almirante Tamandaré. A construção deveria se estender por 800 metros ao longo do mar e serviria como porto de embarque e desembarque de pessoas e mercadorias.
As obras, porém, nunca foram concluídas e permaneceram paralisadas desde o governo de Artur Benevides. Somente em 1994, um projeto de recuperação e urbanização da ponte foi aprovado e realizado pelo Governo do Estado. O projeto, dos arquitetos Fausto Nilo e Delberg Ponce de Leon, incluiu uma armação de madeira sobre parte do viaduto.
Nos seus 130 metros ainda foi levantada uma pequena galeria de arte e um observatório marinho da Universidade Federal do Ceará (UFC). Nos últimos anos, a ponte sofreu com o desgaste natural e passou por novas reformas.
ATIVIDADE SOCIAL

Praia Acessível - É um programa da Prefeitura que oferece espaço de lazer com esteira de acesso e cadeiras anfíbias, que possibilitam o banho de mar de pessoas com deficiência física e/ou motora ou dificuldade de locomoção. Para participar do Praia Acessível, é preciso entrar em contato pelo e-mail acessibilidade@setfor.fortaleza.ce.gov.br ou ir até a Estação de Fortaleza, na Avenida Beira Mar, 848, de quarta-feira a sábado, das 9 às 13 horas.
IGREJAS
Igreja de Nossa Senhora da Conceição da Prainha (Av. Monsenhor Tabosa, S/N); Igreja de São Pedro (Av. Almirante Barroso, 1091); Igreja Universal do Reino de Deus (R. Dragão do Mar, 486); Centro Espírita Pedro O Apóstolo de Jesus (Rua dos Arariús, 245)
Mercados públicos: Calçadão da Praia de Iracema
SAÚDE
Policlínicas: Clínica de Oftalmologia em FortalezaClínica Da Praia (Av. Almirante Barroso, 817)
MEIO AMBIENTE
Praças: Largo dos Tremembés (R. dos Tabajaras, 451); Largo do Mincharia (R. dos Pacajús, 6-97); Praça do Priquito (R. João Cordeiro, 570)
EDUCAÇÃO
Escolas: Creche São Rafael (Rua dos Tabajaras, 480); Escola São Rafael (Rua dos Tabajaras, 244).
CULTURA
Bibliotecas: Coração Selvagem - Café e Livros (R. dos Tabajaras, 450)
Museus: Casa da Cultura Digital de Fortaleza (R. dos Pacajús)
Teatros: Teatro da Boca Rica, Teatro das Marias, Teatro da Praia
380 NOSSOS BAIRROS | NOSSA FORTALEZA
Centros culturais: Estoril, Centro Cultural Belchior, Instituto Cultural Iracema (Av. Monsenhor Tabosa, 435).
PATRIMÔNIO HISTÓRICO
Bens tombados: Estoril (Rua Tabajaras, 397), Ponte dos Ingleses (Rua dos Cariris).
SEGURANÇA
AIS: AIS 4
TRANSPORTE PÚBLICO
Ônibus: Antônio Bezerra/Mucuripe; Siqueira/Praia De Iracema; Parangaba/Mucuripe; Antônio Bezerra/Papicu/Praia De Iracema; Caça E Pesca/Serviluz/Centro
ÁREA EDIFICADA (M2)

Inscrições Residenciais: 2.052
Inscrições Comerciais: 1.121

Inscrições de Prestação de Serviços: 45
Inscrições Industriais: 6
Assentamentos precários: Favela Baixa Pau; Beco Potiguaras
381 REGIONAL 12
AURÉLIO ALVES
Orla da Praia da Iracema, na altura do Estoril
ÍNDICE REMISSIVO


REGIONAL 1

GUIA DA REGIONAL 1 – 64








ÁLVARO WEYNE - 66




BARRA DO CEARÁ - 68
CARLITO PAMPLONA - 72
CRISTO REDENTOR - 74

JARDIM IRACEMA - 82
PIRAMBU - 84
VILA VELHA - 86
JACARECANGA - 78
JARDIM GUANABARA - 80
382 NOSSOS BAIRROS | NOSSA FORTALEZA
REGIONAL 2



GUIA DA REGIONAL 2 - 90




ALDEOTA - 92
CAIS DO PORTO - 94
DE LOURDES - 96
DIONÍSIO TORRES - 98
JOAQUIM TÁVORA - 100
MEIRELES - 102






MUCURIPE – 106




PAPICU - 110
SÃO JOÃO DO TAUAPE - 112
VARJOTA - 114
VICENTE PINZON - 116

383 ÍNDICE REMISSIVO
REGIONAL 3

GUIA DA REGIONAL 3 – 120



AMADEU FURTADO - 122
ANTONIO BEZERRA - 124
BAIRRO ELLERY - 126




FARIAS BRITO - 128
MONTE CASTELO - 130
OLAVO OLIVEIRA - 132
PADRE ANDRADE - 134
PARQUE ARAXÁ - 136
PARQUELÂNDIA - 138


PRESIDENTE KENNEDY - 142


QUINTINO CUNHA - 144

RODOLFO TEÓFILO - 146
SÃO GERARDO - 148
384 NOSSOS BAIRROS | NOSSA FORTALEZA
REGIONAL 4

GUIA DA REGIONAL 4 - 152



AEROPORTO - 154
BAIRRO DE FÁTIMA - 156




BENFICA - 158
BOM FUTURO - 162


DAMAS - 164
ITAOCA - 166
JARDIM AMÉRICA - 168

JOSÉ BONIFÁCIO - 170





MONTESE - 172

PARANGABA - 174
PARREÃO - 176
VILA PERI - 178
VILA UNIÃO - 180
385 ÍNDICE REMISSIVO
REGIONAL 5
GUIA DA REGIONAL 5 - 184








BOM JARDIM - 186

BONSUCESSO - 190

GRANJA LISBOA - 192
GRANJA PORTUGAL - 194
SIQUEIRA - 196

386 NOSSOS BAIRROS | NOSSA FORTALEZA
REGIONAL 6
GUIA DA REGIONAL 6 - 200


AEROLÂNDIA - 202
ALTO DA BALANÇA - 204
CAMBEBA - 206
CIDADE DOS FUNCIONÁRIOS - 208
CURIÓ - 210



COAÇU - 212
GUAJERU - 214
JARDIM DAS OLIVEIRAS - 216
JOSÉ DE ALENCAR - 218

LAGOA REDONDA - 220
MESSEJANA - 222
PARQUE IRACEMA - 226
PARQUE MANIBURA - 228

PAUPINA - 230
SÃO BENTO - 232
387 ÍNDICE REMISSIVO
REGIONAL 7

GUIA DA REGIONAL 7 - 236
CIDADE 2000 - 238

COCÓ - 240
EDSON QUEIROZ - 244
GUARARAPES - 246





LUCIANO CAVALCANTE - 248
MANUEL DIAS BRANCO - 250
PRAIA DO FUTURO I - 252
PRAIA DO FUTURO II - 256
SABIAGUABA - 258
SALINAS - 260
SAPIRANGA - 262
388 NOSSOS
|
FORTALEZA
BAIRROS
NOSSA
REGIONAL 8
GUIA DA REGIONAL 8 - 266
BOA VISTA - 268
DENDÊ - 270

DIAS MACEDO - 272
ITAPERI - 274


JOSÉ WALTER - 276
PARQUE DOIS IRMÃOS - 280
PASSARÉ - 282




PLANALTO AYRTON SENNA - 284
SERRINHA - 286
389 ÍNDICE REMISSIVO
REGIONAL 9

GUIA DA REGIONAL 9 - 290









ANCURI - 292

BARROSO - 294






CAJAZEIRAS - 296
CONJUNTO PALMEIRAS - 298
JANGURUSSU - 302
PARQUE SANTA MARIA - 304
PEDRAS - 306


390 NOSSOS BAIRROS | NOSSA FORTALEZA
REGIONAL 10






GUIA DA REGIONAL 10 - 310




ARACAPÉ - 312

























CANINDEZINHO - 314
CONJUNTO ESPERANÇA - 316
JARDIM CEARENSE - 318


MANUEL SÁTIRO - 320
MARAPONGA - 322
MONDUBIM - 326
NOVO MONDUBIM - 328
PARQUE SANTA ROSA - 330
PARQUE SÃO JOSÉ - 332
PRESIDENTE VARGAS - 334

391 ÍNDICE REMISSIVO
REGIONAL 11
GUIA DA REGIONAL 11 - 338

AUTRAN NUNES - 340
BELA VISTA - 342
CONJUNTO CEARÁ I - 344
CONJUNTO CEARÁ II - 348
COUTO FERNANDES - 350

DEMÓCRITO ROCHA - 352
DOM LUSTOSA - 354
GENIBAÚ - 356

HENRIQUE JORGE - 358

JOÃO XXIII - 360
JÓQUEI CLUBE - 362







PANAMERICANO - 364


PICI - 366

392 NOSSOS BAIRROS | NOSSA FORTALEZA
REGIONAL 12


















372 MOURA BRASIL
376 PRAIA DE IRACEMA
378 393 ÍNDICE REMISSIVO
GUIA DA REGIONAL 12 - 370 CENTRO -
-
-
AGRADECIMENTOS

Arquidiocese



Biblioteca Comunitária Livro Livre Curió
Bruno Xavier
Câmara Municipal de Fortaleza
Clara Dourado
Eduardo Fidelis
Etufor
Francisco Hilton dos Santos (Piqqueno)
Fortaleza em Fotos e Fatos
Fortaleza Nobre
Instituto de Arte e Cidadania do Ceará
Joao Belo Santos
Joelma Leal
Jocélio Leal
Junina Amor Quadrilheiro
Leila Nobre
Liduina Rodrigues
Luis Augusto Melo
Marta Andrade
Preto Zezé


Roger Pires
Ronaldo Oliveira
Secultfor
Secretarias Executivas das Regionais
Uyara Sena

Vandecy Dourado
Yargo Gurjão
394 AGRADECIMENTOS
NA WEB













NO SITE DO PROJETO NOSSOS BAIRROS, NOSSA FORTALEZA É POSSÍVEL TER ACESSO A OUTROS CONTEÚDOS COMO UMA SÉRIE DE 12 CADERNOS SOBRE CADA UMA DAS REGIONAIS DE FORTALEZA. VOCÊ TAMBÉM ASSISTE A 12 LIVES E TRÊS PROGRAMAS DE TV. CONFIRA: fdr.org.br/nossafortaleza



























































































978-6-55-383040-0






















PARCERIA
REALIZAÇÃO

Fachada do Theatro José de Alencar no Centro
Fachada do Theatro José de Alencar no Centro

Sede da Câmara Municipal de Fortaleza está localizada no bairro Luciano Cavalcante
Sede da Câmara Municipal de Fortaleza está localizada no bairro Luciano Cavalcante






































































































































 Ponte sobre o Rio Ceará na Barra do Ceará
Ponte sobre o Rio Ceará na Barra do Ceará














































































 Antigo Farol do Mucuripe no Cais do Porto
Antigo Farol do Mucuripe no Cais do Porto






















































































 Igreja de Santo Afonso (Igreja Redonda), em Amadeu Furtado
Igreja de Santo Afonso (Igreja Redonda), em Amadeu Furtado




















































































 Santuário de Nossa Senhora de Fátima no Bairro de Fátima
Santuário de Nossa Senhora de Fátima no Bairro de Fátima




















































































 Aeródromo Feijó, no Siqueira
Aeródromo Feijó, no Siqueira






































































































 Casa de José de Alencar guarda memória da vida e obra do autor de "Iracema"
Casa de José de Alencar guarda memória da vida e obra do autor de "Iracema"



































































































































 Centro de Formação Olímpica e Castelão vistos de cima
Centro de Formação Olímpica e Castelão vistos de cima




























































































































































































 VetMóvel no Novo Mondubim
moradores do bairro e adjacências
VetMóvel no Novo Mondubim
moradores do bairro e adjacências





















 Campus do Pici da Universidade Federal do Ceará (UFC)
Campus do Pici da Universidade Federal do Ceará (UFC)













































































 Relógio da Praça do Ferreira, no bairro Centro
Relógio da Praça do Ferreira, no bairro Centro














































































































































































































































































































































